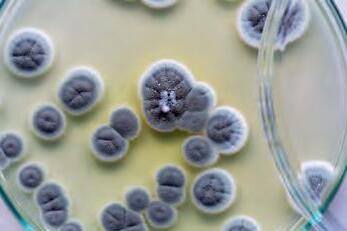
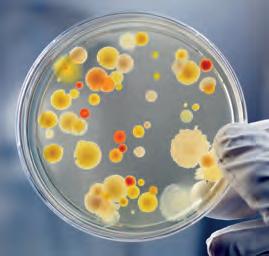
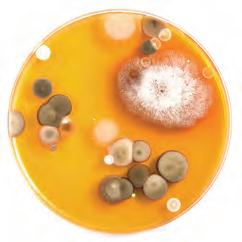

BIOLOGIE FÜR ALLE
2. KLASSE





Drechsler, Grössing, Hellerschmidt, Hagenauer, Monyk bearbeitet von Reich

![]()





Drechsler, Grössing, Hellerschmidt, Hagenauer, Monyk bearbeitet von Reich

Margit Drexler, Helga Grössing, Brigitta Hellerschmidt, Elke Hagenauer, Christian Monyk bearbeitet von Alexander Reich

Lade die eSquirrel Lern-App auf dein Smartphone, wähle dieses Buch aus, gib den Code ein und los geht’s!
Dieses Buch ist laut Bescheid der Bundesministeriums für Bildung, Wissenschaft und Forschung vom 24. Mai 2024 (GZ: 2023-0.161.191) gemäß § 14 Abs. 2 und 5 des Schulunterrichtsgesetzes, BGBL. Nr. 472/86 und gemäß den geltenden Lehrplänen als für den Unterrichtsgebrauch für die 2. Klasse an Mittelschulen und für die 2. Klassen an allgemein bildenden höheren Schulen - Unterstufe im Unterrichtsgegenstand Biologie und Umweltbildung (Lehrplan 2023) geeignet erklärt.

Deine Übungs-App: Auf eSquirrel findest du zu jedem Kapitel viele Übungen.
Kopierverbot:
Dieses Werk ist für den Einsatz im Schulunterricht bestimmt. Laut Urheberrecht in der gültigen Fassung des Urheberrechtsgesetzes (§ 42 (6)) darf es weder ganz noch in Teilen auch für den Einsatz im Schulunterricht nicht kopiert oder vervielfältigt werden.
Umschlagbilder: istockphotoscom: (MrPants, amriphoto, fotojagodka, Zinkevych, tanukiphoto) Schulbuchnummer: 215 997 © Olympe Verlag GmbH, Oberwaltersdorf, 2024
Alle Rechte vorbehalten Vervielfältigungen jeder Art gesetzlich verboten 11. Auflage (2024)
Lektorat: Marion Ramell, BA Umschlaggestaltung, Satz, Layout: Raoul Krischanitz, Wien, transmitterdesign.com Grafik: Raoul Krischanitz, transmitterdesign.com Sprecher der Hörbeispiele: Clemens Matzka Druck, Bindung: Druckerei Berger, Horn Bildrechte: © Bildrecht/Wien, 2024 ISBN: 978-3-903328-31-0

WIRBELLOSE LANDLEBENDE TIERE
1. Merkmale wirbelloser Tiere
2. Leben im Boden: Der Gemeine Regenwurm 11
M1 Lernen durch Probieren – Beobachtung und Versuch 15
M2 Ein Experiment planen, durchführen und auswerten 16
M3 Ein Protokoll erstellen
3. Die Schnecken
Die Sinne der Weinbergschnecke
4. Die Biene – ein Insekt 24
5. Staatenbildende Insekten
6. Schmetterlinge
7. Käfer – eine große Insektenordnung
8. Andere landlebende Gliederfüßer 37

9. Wirbeltiere und Wirbellose: Der Unterschied
Ein Herbarium anfertigen
1. Die Organe der Pflanzen
Pflanzenwachstum
Pflanzen verdunsten Wasser
2. Energie in der Nahrungskette
3. Geschlechtliche und ungeschlechtliche Vermehrung
4. Moose bilden Moore
EINE BIOLOGIN, WIE EIN BIOLOGE

1. Pilze – Merkmale und Vermehrung
2. Artenreichtum bei Ständerpilzen
3. Lebensweise von Pilzen

1. Der Wald – ein Ökosystem 90
2. Pflanzen des Waldes 95
3. Säugetiere des Waldes 101
4. Fressen und gefressen werden 105
UNTERSUCHUNG: im Wald 107
5. Gefahren für den Wald 108
M8 Ein Ökosystem untersuchen 114
M5
6. Bedeutung des Waldes für den Menschen 115
7. Lebensräume unterscheiden sich sehr 119
WIE EINE BIOLOGIN, WIE EIN BIOLOGE 129 KOMPETENZCHECK 130
1. Die Zelle: Baustein des Lebens 131
M5 Richtiges Mikroskopieren 135
M6

M6 Richtiges Präparieren 136
M7
M7 Anfertigen einer mikroskopischen Zeichnung 136
2. Mikroorganismen 137
3. Der Mensch als Lebensraum 139
4. Infektionskrankheiten 140
5. Bakterien als Krankheitserreger 142
6. Viren als Krankheitserreger 144
7. Krankheiten können viele Ursachen haben 146
8. Hygiene gegen Infektionen 149
9. Mikroorganismen in der Biotechnologie 151
10. Lebensmittel verderben leicht 152
UNTERSUCHUNG: Bakterien und andere Mikroorganismen 156
WIE EINE BIOLOGIN, WIE EIN BIOLOGE 158 KOMPETENZ-CHECK 159
1. Das Gehirn und das Nervensystem 160

M8 Arbeiten mit Modellen 163
M9
2. Das Auge: Der Sehsinn 164
3. Das Ohr: Der Gehör- und Gleichgewichtssinn 170
4. Geruchs- und Geschmackssinn 174
5. Die Haut: Tast- und Temperatursinn 177
6. Die Schaltzentrale 181
7. Bewege dich gesund! 186
WIE EINE BIOLOGIN, WIE EIN BIOLOGE 189 KOMPETENZ-CHECK 190 ANHANG Sachregister 191
Damit du dein neues Buch besser kennenlernst, haben wir 10 Aufgaben für dich zusammengestellt. Nach ihrer Lösung wirst du dich bestens in deinem Buch zurechtfinden.
1. INHALTSVERZEICHNIS: Schlage das Inhaltsverzeichnis in deinem Buch auf! Welches Großkapitel und welches Unterkapitel interessieren dich am meisten? Schreibe sie auf!
Großkapitel:
Unterkapitel:


2. FLIEßTEXT: Auf den Textseiten erfährst du alles, was du zu den verschiedenen Themen wissen solltest. Gehe auf S. 106 und beschrifte mit Hilfe der Abb. 1 die Teile des Regenwurms!

3. SEITENSPALTEN: Dort findest du...
ERKLÄRUNGEN für die im Fließtext orange markierten Wörter. Suche die Erklärung für „abiotisch“ im 2. Großkapitel und schreibe sie auf!
... AUFGABEN, die mit Farben für die unterschiedlichen Anforderungsbereiche gekennzeichnet sind.

stillen: ein Baby mit Muttermilch füttern
das ist zu tun
Erörtere, was es für die berufliche Zukunft einer Frau bedeutet, wenn sie eine längere Zeit nicht arbeiten kann!

Verwende was du an Wissen erlernt hast, um zu verstehen, zu erklären und Fragen zu beantworten. Beobachte, untersuche, probiere aus, um dein Wissen zu vertiefen und zu erweitern. Wie hängt das, was ich gelernt habe mit meinem Leben, meinen Vorstellungen und Handlungen zusammen? Lerne deine Gedanken auszudrücken und zu begründen.
Orientiere dich an den Farben und suche in den Seitenspalten für jeden Bereich nach einer Aufgabe! Notiere das Verb, das angibt was in der jeweiligen Aufgabe zu tun ist, in der zum Aufgabenbereich gehörenden Spalte!
Fachwissen erlernen und kommunizieren
Erkenntnisse gewinnen über Gelerntes nachdenken und Probleme lösen
benennen, markieren, ... analysieren, interpretieren, erörtern, ...


4. INFORMATION: In den Seitenspalten findest du immer wieder Postits, die mit ihren zusätzlichen Informationen dein Wissen erweitern. Gib den Titel der Zusatzinformation auf S. 60 an!
5. FOTOS und ILLUSTRATIONEN: Im Buch gibt es auch viele Fotos und Illustrationen. Sie sind nummeriert (Abb. 1, Abb. 2...) und sehr oft beziehen sich Aufgaben in der Seitenspalte auf sie! Gehe auf S. 85 und schreibe die Bildlegende der Illustration hier auf!
6. AUFGABEN: Fast jedes Unterkapitel endet mit der oder den Seite(n) „Nun geht’s los – Aufgaben für schlaue Köpfe“ . Hier kannst du dein Wissen und Können testen und die neu erworbenen Kompetenzen (gekennzeichnet durch die drei Farben) anwenden. Gehe auf S. 84 und schreibe auf, um welches Thema es bei Aufgabe 2 geht!
7. METHODENSEITEN: Sie zeigen dir Schritt für Schritt, wie du arbeiten sollst! Suche die Methodenseite „Herbarium – sammeln und bestimmen“ und schreibe auf, was du in Schritt 2 tun sollst!
8. AUSPROBIEREN: Hier wirst du selbst aktiv! Du findest Anleitungen dazu sowohl in der Seitenspalte als auch als ganze Seiten! Schreibe den Titel der Untersuchung auf S. 58 auf!





9. KOMPETENZ-CHECK: Am Ende jedes Großkapitels kannst du selbst einschätzen, was du kannst. Hier findest du auch Buchtipps zum Vertiefen deiner Kenntnisse! Gehe zum Kompetenzcheck „DIE KLEINSTEN LEBEWESEN“ und gib an, wie der Buchtitel aus der Reihe WAS ist WAS lautet!
10. Personen- und Sachregister: Es hilft dir schnell, wichtige Inhalte mit alphabetisch geordneten Stichwörtern im Buch zu finden! Schreibe mit Hilfe des Registers auf, wo folgendes Wort im Buch zu finden ist!
RASPELZUNGE: __________________________
Biologie ist eine sehr vielseitige und spannende Fachrichtung. Es gibt eine Vielzahl an ganz unterschiedlichen Berufen, die Biologinnen und Biologen ausüben. Viele sind in der Forschung tätig, viele im Bereich des Umwelt- und Tierschutzes und dort, wo es um den Umgang mit Lebensräumen und ihren Lebewesen geht.
Aber auch in der Medizin und der Entwicklung von Medikamenten sind Biologen tätig, da die Natur von sich aus viele Wirkstoffe bereitstellt.


Viele Biologinnen und Biologen vermitteln Wissen weiter, wie auch deine Lehrerin, oder dein Lehrer. Auf diesen Seiten des Buches wirst du ein wenig über die Tätigkeitsfelder von Biologinnen und Biologen erfahren. Außerdem findest du passend zum jeweiligen Kapitel Aufgabenstellungen, die auch Biologinnen und Biologen so ähnlich beschäftigt haben.
Wie in allen Tätigkeitsfeldern gibt es auch in der Biologie gewisse Ausrüstungsgegenstände, die in vielen Situationen hilfreich sind. Was sollte in keinem Ausrüstungsset der Biologie fehlen?
Lupe – damit kannst du Dinge genauer betrachten und Details feststellen, die dir sonst entgangen wären.
Notizbuch und Bleistift – In der Forschung ist es wichtig, möglichst alles zu dokumentieren. Notiere was du beobachtest, fertige Skizzen an und halte Ideen fest. Wenn du zu deinen Einträgen Datum und Ort einträgst fällt es dir leichter alles zu ordnen.
Pinzette und kleine Gefäße – oft ist es praktisch kleine Proben zu sammeln und für genauere Untersuchungen mitzunehmen. Mit einer Pinzette kannst du kleine Dinge besser greifen. Beschrifte deine Proben, damit du sie auch später noch zuordnen kannst. Achtung: Nimm keine lebenden Tiere mit! Du würdest dich auch nicht freuen am Heimweg geschnappt zu werden, um dann einer Begutachtung unterzogen zu werden.
Optional Kamera und Tonaufnahmegerät – damit kannst du deine Beobachtungen leichter festhalten und auch später noch begutachten. Falls du ein Smartphone hast, kannst du dieses benutzen.







Wiederhole, wie die Lebewesen in der Biologie eingeteilt werden! Erkläre auch in diesem Zusammenhang, was ein „Stamm“ ist!
Was bedeutet es, dass das Außenskelett die Gliederfüßer „von außen“ stützt?
Beurteile die Bedeutung des Außenskeletts für Gliederfüßer!
In der ersten Klasse hast du bereits die Wirbeltiere kennengelernt. Sie besitzen eine Wirbelsäule, in der die Nerven vom Gehirn zu den Körperteilen verlaufen sowie ein Skelett , das den Körper stützt. Alle Tiere, die keine Wirbeltiere sind, werden als wirbellose Tiere bezeichnet.
Zahlreiche Tierstämme werden von Biologinnen und Biologen zu den wirbellosen Tieren gezählt. Von einigen davon wirst du jetzt die wichtigsten Merkmale erfahren.
...Gliederfüßer
Die Gliederfüßer besitzen ein Außenskelett. Seine Struktur schützt die inneren Organe und stützt die Tiere von außen. Zu den Gliederfüßern zählen unter anderem die Insekten, die Spinnentiere die Krebstiere und die Tausendfüßer.


Abb. 3: Seeigel und Seegurke
Wirbeltiere
Fische Amphibien
Reptilien
Säugetiere
Vögel
wirbellose Tiere
Gliederfüßer
Weichtiere
Stachelhäuter
Nesseltiere
Schwämme
Ringelwürmer
Abb. 5: vereinfachte Systematik der Tiere

Zu diesem Tierstamm zählt man die Klassen der Schnecken, der Muscheln und der Kopffüßer. Die meisten dieser Tiere haben eine harte Schale aus Kalk, die den Körper von außen umgibt und schützt.



Die Tiere, die du bisher kennengelernt hast, weisen eine zweiseitige Symmetrie auf. Das heißt, dass sie zwei Körperhälften haben, die spiegelbildlich aufgebaut sind. Die Stachelhäuter haben eine fünfstrahlige Symmetrie. Sie ist bei Seesternen besonders gut zu erkennen, bei anderen Stachelhäutern wie Seeigel oder Seegurke erkennt man diese Symmetrie an ihrem inneren Aufbau.

Abb. 4: Seestern mit fünfstrahliger Symmetrie
Diese Tiere haben im Laufe ihrer Evolution Nesselzellen entwickelt, die Nesselfäden mit giftigen Stoffen enthalten. Bei Berührung werden die Nesselfäden explosionsartig ausgestoßen und in das Opfer injiziert. Es wird dadurch gelähmt oder sogar getötet. Manche Quallenarten, die zu den Nesseltieren zählen, sind auch für den Menschen gefährlich. Kommt man beim Schwimmen mit ihnen in Berührung, können schmerzhafte Wunden die Folge sein.
Zu den Nesseltieren zählen auch die Korallen. Sie sind meist nur wenige Millimeter groß, sesshaft und leben in großen Kolonien zusammen. Manche Korallenarten bilden Kalkskelette, aus denen nach dem Absterben der Tiere Korallenriffe entstehen. Durch die Veränderung des Klimas steigen jedoch die Wassertemperaturen immer mehr an. Dadurch sterben die Korallen in vielen Meeren ab.


Riff

Abb. 6: Leuchtqualle im Mittelmeer
...der Schwämme
Auch Schwämme leben im Wasser. Sie sind ebenso sesshafte Tiere, die sich durch Nahrungspartikel ernähren, die sie gemeinsam mit dem Wasser einstrudeln.
Abb. 9: Schwamm im Meer
...der Ringelwürmer

Diese Würmer sind aus zahlreichen Abschnitten aufgebaut, die von außen wie Ringe aussehen und die man früher als „Ringel“ bezeichnet hat. Der bekannteste Vertreter dieses Tierstammes ist der Regenwurm.
Viele Egel, wie der in Süßgewässern Europas heimische Medizinische Blutegel, sind Parasiten, die sich an anderen Tieren festsetzen und deren Blut aussaugen. Ihre Beute nehmen sie über Tastorgane auf der Hautoberfläche wahr. Egel können sowohl im Wasser als auch an Land vorkommen.
Viele wirbellose Tiere weisen – so wie die Korallen, Schwämme oder Nesseltiere – einen sehr einfachen Aufbau auf. Aber sie sind perfekt an ihren Lebensraum angepasst. Kommt es zu Veränderungen des Lebensraumes, so ist das Überleben dieser Tiere gefährdet.
Viele Stämme der wirbellosen Tiere kommen nur im Wasser vor, manche finden sich sowohl im Wasser als auch am Land. In diesem Schuljahr wirst du vor allem die landlebenden Tiere kennenlernen.

injizieren: eine Flüssigkeit mit einer Nadel hineinspritzen
sesshaft: sich nicht bewegend; immer am selben Ort


Die Korallenbleiche Manche Korallen leben in Symbiose mit Algen, die die Koralle mit Nährstoffen versorgen. Die Algen sorgen auch für die bunten Farben der Korallen. Wird das Wasser zu warm, erzeugen die Algen Giftstoffe und werden von den Korallen abgestoßen. Dadurch verlieren die Korallen ihre Farbe.
Abb. 7 + 8: Vergleiche zuerst die beiden Bilder! Was fällt dir auf? Verfasse dann einen Text, in dem du die Auswirkung des Klimawandels auf Korallen beschreibst!
einstrudeln: einen Wasserstrom nach innen erzeugen
Parasit, der: erhält seine Nahrung von einem Wirt, der dadurch geschädigt wird
Wirt, der: Organismus, der einen weiteren Organismus ernährt
Abb. 10: Medizinische Blutegel werden bis zu 15 cm lang. Charakteristisch sind die sechs Streifen am Rücken, die oft rot gefärbt sind.
Bei diesem Text über das Great Barrier Reef sind bei einigen Wörtern die Buchstaben verkehrt geschrieben. Versuche, den Text trotzdem zu lesen!
Australiens
Das Great Barrier Reef liegt an der Nordostküste Australiens und ist das größte Korallenriff der Welt. Es ist etwa 2 300 km lang und hat eine Fläche von 347 800 km2. Das Riff besteht aus über 2 900 Einzelriffen, ca. 1 000 Inseln und unzähligen Sandbänken. Es ist eines der sieben Weltwunder der Natur und kann mit freiem Auge vom Weltraum aus gesehen werden. Das Great Barrier Reef wurde im Jahr 1770 vom bekannten britischen Seefahrer James Cook entdeckt. Eine Vielzahl verschiedener Arten von Lebewesen findet hier ihren Lebensraum. Rund 400 Korallenarten, 1 500 Fischarten, 500 Arten von Weichtieren, 800 Arten von Stachelhäutern (Seesterne), 500 Arten von Seetang und über 200 Vogelarten finden dort ihr Zuhause. Durch die globale Erwärmung ist das Riff sehr gefährdet. Steigt die Wassertemperatur an, werden die Korallen geschädigt und sterben schließlich ab.
2 900 James Cook
Erwärmung globale 1 000

Beantworte nun die Quizfragen!

Bei welchem Kontinent liegt das Great Barrier Reef?
Wie groß ist seine Fläche und über welche Länge erstreckt es sich?
Aus wie vielen Einzelriffen und aus wie vielen Inseln besteht es?
Wann wurde das Great Barrier Reef entdeckt?

Wie viele Tier- und Pflanzenarten finden insgesamt ihren Lebensraum dort?
Was gefährdet das Great Barrier Reef?
Was geschieht, wenn die Wassertemperatur ansteigt?
2 3
Tierarten Pflanzenarten
Zu den wirbellosen Tieren zählt nicht... – Kreuze jenes Tier an, das nicht dazugehört!








Der Körperbau des Regenwurms
Hinterende

Kopf
Gürtel
Der Gemeine Regenwurm gehört zum Stamm der Ringelwürmer. Wenn du ihn betrachtest, fallen dir die einzelnen Ringe auf, aus denen sein Körper besteht. Man nennt sie Segmente . Diese waren eine evolutionäre Neuerung im Vergleich zu den einfacher gebauten Faden- oder Plattwürmern.
Jedes Segment ist vom Darm, den Blutgefäßen und dem Nervensystem durchzogen. Im ersten Segment befinden sich eine Mundöffnung, der Schlund, und ein Nervenknoten. Am Hinterende des Wurms befindet sich der After.
Ausscheidungsorgan

Abb. 2: Körperbau des Regenwurms
Der Regenwurm lebt im Boden und frisst pflanzliche und tierische Abfallstoffe sowie Bestandteile des Bodens. Er packt Blätter mit seiner Mundöffnung und zieht sie in den Boden. Dort vermodern sie. Erst dann frisst sie der Regenwurm. Er hat keine Zähne und nimmt seine Nahrung mit saugenden und pumpenden Bewegungen seiner Mundöffnung auf. Die organischen Bestandteile werden verdaut, die unverdaulichen Bodenbestandteile scheidet er als Kothäufchen am Ende seiner Gänge wieder aus. So wird der Boden gedüngt und erhält eine krümelige Struktur.

Gürtel, der: hier R eine verdickte Stelle bei erwachsenen
Regenwürmern, die bei der Paarung und Eiablage wichtig ist
Abb. 4: mehrere cm hohe Kothäufchen werden an der Oberfläche abgegeben.
Im Herbst hört der Regenwurm auf zu fressen und zieht sich in tiefere Bodenschichten zurück. Er entleert seinen Darm und wickelt sich zu einem Knäuel zusammen. Alle Lebensvorgänge wie Atmung, Blutkreislauf und Verdauung werden reduziert. Dadurch verbraucht er auch wenig Energie und Sauerstoff. Er fällt in Winterstarre.
Der Regenwurm hat keine Augen. Er besitzt aber lichtempfindliche Zellen, mit denen er Helligkeit und Dunkelheit unterscheiden kann. Der Regenwurm atmet durch seine Haut, man nennt das Hautatmung. Seine Haut ist mit einer Schleimschicht bedeckt. Diese darf nie austrocknen, weil die Feuchtigkeit für seine Atmung notwendig ist.
Beschreibe, wie der Körperbau des Regenwurms an seinen Lebensraum angepasst ist! Denke daran: In der Natur ist es allgemein so, dass sich Struktur und Form der Lebewesen an die Anforderungen ihrer Umgebung anpassen.

Abb. 3: Der Regenwurm hat an jedem Segment vier Borsten, damit er sich besser fortbewegen und auch festhalten kann.
Sieh dir folgendes Video an:

Beobachte einen Regenwurm!
Vergleiche nun die Fortbewegung des Regenwurms mit der einer Schlange! Wie unterscheiden sie sich?
reduzieren: verringern, verkleinern
Ton-Humus-Komplex, der: Verbindung von Humusteilchen und mineralischen Bestandteilen des Bodens
Humus, der: durch die Aktivität von Bodenorganismen entstehende zersetzte Reste abgestorbener Lebewesen im Boden
Sieh dich in deiner Umgebung bewusst um! Beobachte und liste auf, wo in deiner Umgebung durch Bautätigkeiten Boden verloren geht! Was bedeutet das für die Regenwürmer, die dort leben?
Beurteilt die Gefahr, die vom Verlust von Boden in Österreich ausgeht! Wie kann er verhindert werden?
Zwitter, der: Lebewesen, das gleichzeitig männliche und weibliche Geschlechtsorgane hat
Kokon, der: Behälter für die Larven vieler wirbelloser Tiere, oft ein Gespinst, hier: eine Kapsel

Die vielen Gänge, die der Regenwurm bis zu zwei Meter tief gräbt, durchlüften den Boden, und erleichtern Pflanzenwurzeln, die Gänge entlangzuwachsen. Im Darm der Regenwürmer befinden sich Bakterien. Diese helfen, die pflanzlichen Rückstände zu verdauen. Dabei werden Ton-Humus-Komplexe gebildet, die mit dem Kot ausgeschieden werden und die Fruchtbarkeit des Bodens erhöhen.
Die Zahl der Regenwürmer wird durch die Siedlungstätigkeit des Menschen gesenkt, da dadurch Boden zerstört wird. Regenwürmer reagieren auch sehr empfindlich auf Umweltgifte. Chemische Düngemittel, Unkraut- und Insektenvernichtungsmittel töten diese nützlichen Bodenbewohner.
Regenwürmer sind sehr wichtig für den Boden, denn sie…
2 … reichern in ihrem Kot die von Pflanzen benötigten Mineralstoffe an und machen diese für die Pflanzen lebenswichtigen Stoffe leichter verfügbar.
2 … belüften und lockern den Boden durch ihre Gänge. Der Boden kann durch die zahlreichen Poren wie ein Schwamm das Wasser besser halten.
2 … fördern durch ihre Gänge das Wachstum feiner Pflanzenwurzeln.
2 … transportieren Mineralstoffe aus tieferen Schichten zu den Pflanzenwurzeln
Regenwürmer sind Zwitter. Nach der Paarung legen beide Würmer befruchtete Eier und sorgen so für genügend Nachwuchs. Als Zwitter bildet jedes Tier Eizellen und Samenzellen aus. Bei der Paarung legen sich die Tiere aneinander und tauschen die Samenzellen aus. Dann trennen sie sich. Im Gürtel, einem Schleimring, befinden sich die befruchteten Eier. Den Gürtel streift der Wurm über den Kopf ab. Im Kokon entwickeln sich dann junge Regenwürmer.
Abb. 6: Regenwurm-Kokons


Regenwürmer sind ein wichtiges Glied in der Nahrungskette. Sie selbst sind Nahrung für viele Vögel (Amsel, Drossel, Krähen), Säugetiere (Igel, Dachs, Fuchs, Maulwurf), Reptilien (Nattern, Blindschleichen), Amphibien (Molche, Salamander, Kröten), Tausendfüßer, Steinkriecher und Insekten (Laufkäfer).
Was ist was beim Regenwurm? Auf dieser Abbildung eines Regenwurms ist die Beschriftung nicht mehr zu sehen. Als Expertin oder Experte für Regenwürmer bekommst du die Aufgabe, sie wiederherzustellen:


Regenwurmrätsel – Welche Begriffe haben sich hier versteckt? Die Hinweise des Regenwurms helfen dir bei deiner Suche.


Die Zahlen neben einigen Wörtern zeigen dir, welchen Buchstaben du aus dem jeweiligen Wort nehmen musst, um das Lösungswort zu erhalten.

a) anderes Wort für Körperabschnitt (7)
b) bodenbewohnendes Säugetier, das viele Regenwürmer frisst (2)
c) wichtiger Körperteil des Regenwurms, der nach einem Kleidungsstück benannt ist
d) Die Haut des Regenwurms muss immer … sein. (3)
e) Zustand des Regenwurms im Winter (1)
f) Tiere wie der Regenwurm, die sowohl Eizellen als auch Samenzellen produzieren
g) Atmung des Regenwurms (3)
h) Mit ihnen kann sich der Regenwurm im Boden festhalten. (3)
i) Reptil, das Regenwürmer frisst
j) Eibehälter des Regenwurms
k) Verbindung von Humusteilchen mit mineralischen Bestandteilen (6)

LÖSUNGSWORT: Eine der häufigsten Regenwurmarten ist der
Etwa 95 % aller bekannten Tierarten gehören zu den Wirbellosen. Das wichtigste Merkmal ist die fehlende Wirbelsäule. Außerdem haben sie kein Skelett aus Knochen, sondern andere Körperteile übernehmen die Stützfunktion. In den einzelnen Stämmen findet man allerdings wieder besondere Merkmale. Benenne die Tiere und ordne sie den Tierstämmen zu, indem du die Zahlen der Bilder in die richtige Tabellenspalte schreibst!











Weichtiere:
• muskulöser Fuß
• Mantel
• feste Kalkschale
















• fünfstrahliger Körper 1 3 2 4 6 5 7 9 10 8 11 12 13







Gliederfüßer:
• festes Außenskelett
• gegliederte Beine
• offener Blutkreislauf
Ein Tier lässt sich nicht einordnen. Welches ist es?











Ringelwürmer:
• Körper aus Segmenten
• geschlossener Blutkreislauf









Stachelhäuter:
• Kalkskelett
Wie findet man in der Wissenschaft eigentlich Dinge heraus? Am Anfang steht in der Regel eine Beobachtung. Wir sehen etwas und denken uns: „Das ist ja interessant.“ Beobachten heißt bewusst wahrnehmen, auch auf Details zu achten. Um eine Beobachtung wiederholen zu können führt man in der Wissenschaft Versuche durch. Dabei werden bewusst die Voraussetzungen geschaffen, die eine bestimmte Beobachtung erlauben. Meist versucht man dabei die Beobachtung genauer und detailreicher zu gestalten. Bedenke: Oft gibt es viele verschiedene Einflüsse auf Vorgänge. Gleiche Versuche können daher verschieden ausgehen.
Was brauchst du? Regenwurm
Zu Ergebnissen lassen sich Fragen und Vermutungen aufstellen, die weiter überprüft werden können. Wie das genau funktioniert, erfährst du am Beispiel des Regenwurms.
ACHTUNG: Bei Versuchen mit Tieren musst du unbedingt darauf achten, dass du sie auf KEINEN Fall verletzt und ihnen Schmerzen zufügst! Denn du bist für das Wohl des Tieres verantwortlich!

Beobachte zuerst das zu untersuchende Tier! Was fällt dir auf? Beim Regenwurm rutscht das gerade vorgestreckte Vorderende kaum zurück, wenn er den Rest seines Körpers nachzieht.
Ist das zufällig so? Stelle erste Vermutungen für die Gründe deiner Beobachtung an und notiere Argumente, weshalb deine Vermutungen zutreffen könnten. Profitipp: Eine Wissenschaftlerin oder ein Wissenschaftler wird an diesem Punkt nun in der Fachliteratur nachsehen, um Ideen zu sammeln, oder ob jemand bereits eine Erklärung gefunden und überprüft hat.
Wir wollen das nun genauer untersuchen. Konstruiere dazu eine Versuchsanordnung, mit der du deine Beobachtung wiederholen kannst und mehr dazu erfährst!
2. SCHRITT: Versuch
Was brauchst du? Regenwurm % Becherlupe
Lege dazu den Regenwurm in eine Becherlupe und betrachte ihn genau!
Wiederholt sich deine Beobachtung?
Kannst du zusätzliche Details erkennen?
Der Regenwurm ist mit Borsten besetzt.
3. SCHRITT: Dokumentation, Schlussfolgerungen und Fragen

Dokumentiere deine Beobachtungen möglichst genau! In vielen Fällen helfen Skizzen.
Haben sich Vermutungen bestätigt, oder als falsch herausgestellt? Notiere das und deine Gedanken dazu! Formuliere eine Frage zu deinen Erkenntnissen und eine mögliche Antwort!
FRAGE: Welche Aufgaben haben die Borsten?
VERMUTUNG: Die Borsten sollen verhindern, dass der Wurm bei seiner Fortbewegung zurückrutscht, wenn er einen Körperabschnitt nachzieht.
Um Vermutungen zu äußern, braucht es in der Regel Vorwissen und Recherche. Überlege immer gut was für und was gegen eine Vermutung spricht. Wir wollen unsere Vermutung nun überprüfen. Wie man das in der Wissenschaft macht, erfährst du auf der nächsten Seite.
Bei einem Experiment will man herausfinden, ob tatsächlich ein Zusammenhang zwischen einer vorher vermuteten Ursache und einer beobachteten Wirkung besteht. Dafür führt man Versuche unter gezielt veränderten Bedingungen durch. Wie du ein
Experiment planen und durchführen kannst, erfährst du hier am Beispiel des Regenwurms.
1. SCHRITT: Fragestellung und Planung des Experiments
Was ist die Fragestellung und die vermutete Antwort.
FRAGE: Welche Aufgaben haben die Borsten?

VERMUTUNG: Die Borsten sollen verhindern, dass der Wurm bei seiner Fortbewegung zurückrutscht, wenn er einen Körperabschnitt nachzieht.
Überlege wie du Bedingungen gezielt so ändern kannst, dass sich deine Vermutung überprüfen lässt! Überlege was passieren sollte, wenn deine Vermutung stimmt!
Auf einer glatten Oberfläche sollten die Borsten nicht so gut haften. Dadurch müsste ein kriechender Regenwurm weniger weit kommen als auf einer rauen Oberfläche.
Konstruiere einen Versuch und überlege, was du alles dafür brauchst.
Wir lassen den Regenwurm auf Millimeterpapier (rau) und Glas (glatt) kriechen. Wir messen die Fortbewegung des Regenwurms mit dem Millimeterpapier.
Was brauchst du? Regenwurm % Becherlupe % Millimeterpapier % Glasplatte
DURCHFÜHRUNG A: Setze den Regenwurm auf das Millimeterpapier! Dann miss 3 Minuten lang, den Weg, den das hintere Ende des Regenwurms in je einer Minute zurücklegt!
Verändere gezielt die Bedingungen unter denen dein Versuch abläuft.
DURCHFÜHRUNG B: Lege eine Glasplatte auf das Millimeterpapier und führe den Versuch nochmals durch!
Wenn du besonders genau sein möchtest, führe den gesamten Versuch öfters durch um sicher zu sein, dass deine ersten Ergebnisse nicht nur zufällig entstanden sind.
Notiere deine Versuchsergebnisse in einem Protokoll! Wie du das erstellen kannst, erfährst du bei M3. Tipp: Bei deinen Ergebnissen des Regenwurm-Experimentes solltest du eine Tabelle anfertigen!
Überprüfe deine Vermutung! Stimmt das Versuchsergebnis mit deiner Vermutung überein, hattest du recht. Widerspricht das Versuchsergebnis aber deiner Vermutung, lagst du falsch.
ACHTUNG beim Fangen von Regenwürmern: Regenwürmer fängst du am besten im Frühling oder im Sommer. Die beste Zeit dafür ist nachts und wenn es regnet. Verwende dazu eine Taschenlampe und ein Gefäß, in das du Erde füllst!
Wenn du ihn aus dem Boden ziehst, ziehe nur leicht an! Du wirst sehen, er lässt nach kurzer Zeit von selbst los und du kannst ihn einfach herausziehen und in deinen Behälter stecken.

pro Min. zurückgelegter Weg (in Millimeter) raue Unterlage glatte Unterlage
Messung mm mm
Auf rauer Unterlage legt..., während er bei glatter Unterlage... Das bestätigt meine...
Alle Schritte eines Experiments – also von der Fragestellung bis zur Auswertung werden in einem Protokoll vermerkt. Auch für Versuche werden Protokolle angefertigt. Die Fragestellung ist dann von der Form „Was geschieht, wenn…“. So könnte dein Protokoll aussehen:
1. SCHRITT: Protokollkopf und Einleitung

Vermerke ganz oben deinen Namen, das Datum und die Klasse!
Gib an, um was es bei deinem Versuch geht!
Wie lautet die Fragestellung?
Welche Vermutung habe ich?
2. SCHRITT: Material und Sicherheit
D D
Liste alle Materialen stichwortartig genau auf!
Weise auch darauf hin, welche Sicherheitsvorkehrungen für diesen speziellen Versuch gemacht wurden!
3. SCHRITT: Durchführung
Beschreibe genau, wie du den Versuch durchführst!
Gib auch Hinweise, auf was du bei der Durchführung geachtet hast!
Fertige auch z. B. eine Skizze mit der Anordnung deines Versuchs an!
4. SCHRITT: Dokumentation und Erklärung

Hypothese
Material
Sicherheit
Durchführung
Skizze
Beobachtung
Erklärung
Notiere was du beobachtet hast! Wichtig ist hier nicht zu bewerten, oder zu deuten! Liefere nur eine genaue Dokumentation der Vorgänge! Dann erst denke darüber nach und beurteile!
Hat sich deine Vermutung bestätigt?
Welche Erklärung hast du gefunden?
D D D D D 1 D
Führe die Versuche durch und fertige dabei Protokolle an!
Was brauchst du? Regenwurm % Pipette
Versuch 1: Der Hörsinn des Regenwurms
Durchführung: Klatsche unmittelbar neben dem Wurm kräftig in die Hände!
Was geschieht? Notiere deine Beobachtungen!
Versuch 2: Der Temperatursinn des Regenwurms
Behandle mich vorsichtig und mit Respekt!
Durchführung: Tropfe vorsichtig mit einer Pipette etwas Eiswasser auf den Wurm!
Was geschieht? Notiere deine Beobachtungen!


Abb. 2: Nacktschnecke (hier Rote Wegschnecke): Schnecke ohne Gehäuse
asymmetrisch: hier R an beiden Hälften unterschiedlich

Abb. 3: Auch Menschen bauen in Bögen.

Abb. 4: Lauffläche einer Hain-Bänderschnecke auf einer Glasplatte.

Abb. 5: Schnecken können sogar über Rasierklingen kriechen.
Setze eine Nacktschnecke auf eine Glasplatte! Beschreibe genau, wie sie sich fortbewegt! Ergänze, was du schon vom Buch weißt!
Schnecken gehören zu den Weichtieren. Neben den Landschnecken wie den Schnirkelschnecken oder den Nacktschnecken gibt es auch Wasserschnecken. Diese sind sehr wichtig für die Gewässer, weil sie abgestorbene Pflanzen fressen. In Österreich sind mehr als 400 Schneckenarten heimisch.

Die Schnirkelschnecken sind die artenreichste Schneckenfamilie in Europa. Sie besitzen ein Gehäuse – das Schneckenhaus – in das sie sich zum Schutz zurückziehen können. Seine Form hat sich so entwickelt, dass mit möglichst wenig Material ein möglichst stabiles Gebilde entsteht.
Das Schneckenhaus besteht aus Kalk und hat eine asymmetrisch spiralige Windung. Die feinen Streifen des Gehäuses sind ein Zeichen dafür, dass es schichtweise gebildet wird.
In Abbildung 1 kannst du erkennen, dass das Schneckenhaus eine gewundene Röhre ist, die von der ersten Windung an immer weiter wird. Das Schneckenhaus wächst also mit der Schnecke mit.

Spindel (Achse des Schneckenhauses)
Abb. 1: Schnitt durch ein Gehäuse
Mit Hilfe des Spindelmuskels kann sich die Schnecke vollständig ins Gehäuse zurückziehen. Es bietet so Schutz vor dem Austrocknen, aber auch vor Fressfeinden. Ist es längere Zeit trocken, bildet die Schnecke an der Öffnung einen wasserdichten Deckel aus einer feinen Schleimschicht, die an der Luft fest wird. Dann verfällt sie in Trockenstarre
Fortbewegung
Schnecken bewegen sich sehr langsam auf besondere Weise fort: Sie schieben sich durch wellenförmige Bewegungen ihres Fußes langsam vorwärts. Schleimdrüsen sondern dabei einen zähen Schleim ab, auf dem die Schnecke dahingleitet. Er hilft der Schnecke, auf dem Untergrund besser zu haften und schützt sie auch vor scharfkantigen Untergründen.
Die meisten Schnecken sind Zwitter. Das heißt, sie besitzen weibliche und männliche Geschlechtsorgane. Bei der Paarung tauschen die Schnecken ihre Samenzellen aus, die erst später ein Ei befruchten. So wird Erbgut ausgetauscht und Selbstbefruchtung vermieden, was die Anpassungsfähigkeit der Art fördert. Dann werden die befruchteten Eier von etwa 1mm Durchmesser an einem sicheren Ort abgelegt.

1mm
Abb. 6: Schneckeneier
Wasserschnecken legen ihre befruchteten Eier häufig auf den Blättern von Unterwasserpflanzen ab, während Landschnecken ein ca. 10 cm tiefes Loch graben, um ihre Eier abzulegen. Nach einigen Wochen schlüpfen die Jungen. Ihr Haus besteht nur aus einer Windung und ist noch durchsichtig.
Der Körper der Weinbergschnecke zeigt besonders gut die Gliederung in Kopf, Fuß, Mantel und Eingeweidesack.
Geschlechtsorgane
Verdauungsorgane
Rückziehmuskel
Sieh dir folgendes Video an:
Blutgefäßsystem

Abb. 7: Körperbau der Weinbergschnecke
Ausscheidungsorgane
Lunge
Nervensystem Auge

Beobachte, wie sich eine Schnecke bewegt! Welche Unterschiede und Gemeinsamkeiten siehst du zur Fortbewegung des Regenwurms?
Raspelzunge
Der Eingeweidesack enthält die inneren Organe der Schnecke. Er ist vom Mantel umgeben, der nach außen das Gehäuse bildet. Die Lunge liegt in der Mantelhöhle, in die auch die Ausgänge von Verdauungs-, Ausscheidungs- und Geschlechtsorganen münden.
Am Kopf hat die Schnecke zwei Paar Fühler. Diese zieht sie sofort ein, wenn sie berührt wird oder sogar dann, wenn ein Schatten auf sie fällt. Am Ende des längeren Fühlerpaares sitzen zwei schwarze punktförmige Augen, mit denen die Schnecke Hell und Dunkel unterscheiden kann. Unter den Fühlern befindet sich der Mund mit einem verhornten Oberkiefer und einer Raspelzunge. Diese ist ein gutes Beispiel dafür, wie in der Natur die Form der Funktion folgt. Sie ist so aufgebaut, dass die Schnecke damit ihre Nahrung – das sind meist Blätter – abraspeln kann.
Lebensraum und Lebensweise der Weinbergschnecke
Die Weinbergschnecke kommt an warmen Orten mit feuchtem Boden vor. Das sind bei uns vor allem lichte Wälder, Gebüsche aber auch offene Lebensräume wie Gärten oder Parks.
Schnecken stammen von anderen Weichtieren ab, die ursprünglich ausschließlich im Wasser lebten. Auch heute gibt es noch zahlreiche Schneckenarten, deren Lebensraum Gewässer sind. Diese Arten atmen vorwiegend wie die Fische mit Kiemen. Die landlebenden Schnecken wie die Weinbergschnecke haben sich jedoch perfekt an das Landleben angepasst. So entwickelten sie zum Atmen eine Lunge.

Die Weinbergschnecke ist keine gefährdete Tierart, viele andere Schneckenarten jedoch schon. Etwa 40 % der Arten sind in ihrem Bestand bedroht. Das betrifft vor allem Schneckenarten, die nur in Feuchtgebieten vorkommen. Durch die vom Menschen hervorgerufenen Eingriffe in diese Ökosysteme sind auch die dort lebenden Schnecken bedroht.

Abb. 8: Funktion der Raspelzunge. Die scharfen Kanten reißen Stücke der Nahrung ab und transportieren sie in den Mund der Schnecke.
abraspeln: mit einer rauen Oberfläche Teile abschaben

0,05mm
Abb. 9: Raspelzunge unter dem Elektronenmikroskop
Suche Schnecken in deiner Nähe und beschreibe kurz ihren Lebensraum!
Analysiere, wie die Schnecken jeweils an ihren Lebensraum angepasst sind!
Kreuze an, ob die Aussagen richtig oder falsch sind! Bei „falsch“ stelle die Aussage richtig!
Die Schnecke besitzt ein Innenskelett.
richtig falsch ______________________________________________________________________
Das Gehäuse besteht aus Kalk und Hornhäutchen. ________________________________________________
richtig falsch ______________________________________________________________________
Durch das Gehäuse verläuft ein Muskel, durch den sich die Schnecke einziehen kann.
richtig falsch ______________________________________________________________________
Das Gehäuse dient als Stütze.
richtig falsch ______________________________________________________________________
Die Schnecke zieht sich bei Gefahr, im Winter und bei Trockenheit ein.
richtig falsch ______________________________________________________________________
Bei Trockenheit bildet die Schnecke einen Kalkdeckel.
richtig falsch ______________________________________________________________________
Begründe, warum Schnecken zu den Weichtieren gehören! Kreise dazu die Buchstaben der 4 richtigen Antworten ein! Ob du richtigliegst, siehst du am Lösungswort!
A Wie bei allen Weichtieren ist der Körper mehrstrahlig.
Z Der Körper besteht aus Kopf, Fuß und Eingeweidesack.
C Der Fuß ist gegliedert.
W Das Schneckenhaus besteht so wie bei anderen Schalenweichtieren aus Kalk.
E Der Körper besteht aus 3 Abschnitten: Kopf, Brust und Hinterleib.
T Der Eingeweidesack wird von der Schicht des Mantels geschützt.
E Nacktschnecken haben kein Gehäuse. Es hat sich im Laufe der Evolution zurückgebildet.
H Alle Weichtiere besitzen ein festes Außenskelett.

LÖSUNGSWORT: . . T . . R
Informiere dich im Internet über die abgebildeten Schneckenarten. Erstelle jeweils einen Steckbrief!



Suche, skizziere und fotografiere Schnecken in deiner Umgebung. Informiere dich, welche in deinem Bundesland vorkommen! Findest du Übereinstimmungen?
Auch die Weinbergschnecke nimmt ihre Umgebung mit Hilfe ihrer Sinnesorgane wahr. Mittels einfacher Versuche kannst du herausfinden, wie die Schnecke auf unterschiedliche Reize reagiert. Finde anhand der Versuche passende experimentelle Fragestellungen. Triff eine Vermutung über das Ergebnis. Wiederhole Versuche um Ergebnisse besser beurteilen zu können.
ACHTUNG: Ich stehe auf der Roten Liste und darf nur aus einer Zucht stammen!!

Abb. 11 Weinbergschnecke
ACHTUNG: Auch hier gilt, achte bei Versuchen mit lebenden Tieren darauf, dass du die Tiere NICHT verletzt oder ihnen Schmerzen zufügst. Behandle sie vorsichtig!

Du brauchst: Weinbergschnecke (aus einer Zucht) % Glasplatte % Apfelspalte % Essig (verdünnt) % Wattestäbchen % Glasreiniger
FRAGE: Kann die Weinbergschnecke zwischen
VERMUTUNG:
VERSUCH: DURCHFÜHRUNG A. Ziehe mit der Apfelspalte einen Streifen auf der Glasplatte! Dann setze die Schnecke neben diesen Streifen!
DOKUMENTATION 1: Was geschieht? Was kannst du beobachten?
Die Schnecke
DURCHFÜHRUNG B. Reinige die Glasplatte mit dem Reinigungsmittel! Dann tauche das Wattestäbchen in den verdünnten Essig und ziehe einen Streifen über die Glasplatte! Nun setze die Schnecke ca. 10 cm neben den Essigstreifen!
DOKUMENTATION 2: Was geschieht? Was kannst du beobachten?
Die Schnecke
AUSWERTUNG: Wie lautet deine Schlussfolgerung? Was waren die entscheidenden Einflüsse?
Überlege: Könnte es weitere Einflüsse geben? Reicht es, eine einzelne Schnecke zu untersuchen?
Suche mit einer Suchmaschine unter den Stichwörtern „Schnecken im Garten“ Tipps zur Abwehr von Schnecken! Wähle dann einen Tipp aus, der das Ergebnis des Experiments bestätigt!


Experiment 2: Dem Tastsinn der Weinbergschnecke auf der Spur
Du brauchst: Weinbergschnecke (aus einer Zucht) % Glasplatte % kleiner Pinsel
FRAGE: Kann die Weinbergschnecke
VERMUTUNG:
VERSUCH: DURCHFÜHRUNG A. Setze die Schnecke auf die Glasplatte. Bewege den Pinsel langsam in ein bis zwei cm Abstand an der Schnecke vorbei. Zunächst am Fühler (1), dann seitlich an der Mitte des Fußes (2) und schließlich am Ende des Fußes (3)!
Beobachte bei (2) und (3) die Schnecke von unten durch die Glasplatte!
DOKUMENTATION 1: Was geschieht? Was kannst du beobachten?

DURCHFÜHRUNG B. Berühre die Schnecke nun vorsichtig mit dem Pinsel. Zunächst am Fühler (1), dann seitlich an der Mitte des Fußes (2) und schließlich am Ende des Fußes (3)!
Beobachte bei (2) und (3) die Schnecke von unten durch die Glasplatte!
DOKUMENTATION 1: Was geschieht? Was kannst du beobachten?
AUSWERTUNG: Wie lautet deine Schlussfolgerung? Finde Gründe für mögliche Auffälligkeiten!

Du brauchst: Weinbergschnecke (aus einer Zucht) % Schuhkarton % Taschenlampe
FRAGE: Kann die Weinbergschnecke
VERMUTUNG:
VERSUCH DURCHFÜHRUNG A: Setze die Schnecke in einem hellen Raum auf den Karton und lass ihr etwas Zeit! Dann nimm die Taschenlampe und lass den Lichtschein in Richtung des Kartons ein wenig umherschweifen, so dass die Schnecke davon überstrichen wird! Verändere die Entfernung der Lampe zum Karton!
ACHTUNG: Moderne LED Taschenlampen sind teilweise sehr hell! Verwende einen schwächeren Leuchtmodus, oder eine nicht so leistungsstarke Lampe. Halte die Lampe nicht zu nahe an die Schnecke!
DOKUMENTATION: Was geschieht? Was kannst du beobachten?

VERSUCH DURCHFÜHRUNG B: Setze die Schnecke in den Karton und verschließe ihn mit dem Deckel!
Warte etwa 20 Minuten! Dann öffne den Karton einen Spalt und leuchte mit der Taschenlampe hinein!
DOKUMENTATION: Was geschieht? Was kannst du beobachten?
AUSWERTUNG: Wie lautet deine Schlussfolgerung?

UNTERSUCHUNGSERGEBNISSE: Fasse nun zusammen, was du über die Sinnesorgane der Schnecke herausfinden konntest! Notiere insbesondere auch Dinge, die eventuell noch nicht ganz ins Bild passen. Vielleicht war deine Beobachtung beim Versuch zum Tastsinn im Falle des Fühlers etwas anders als beim Fuß. Manchmal unterscheiden sich Ergebnisse auch bei der Wiederholung eines Versuchs. Solche Abweichungen und Ungereimtheiten sind wichtig, da sie oft auf etwas hinweisen, das man noch nicht bedacht hat. Stelle Vermutungen an, wie sich Abweichungen in den Ergebnissen erklären lassen!
2
Begründe aufgrund deines Versuches, weshalb Schnecken nur bei Dämmerung und nachts auf Nahrungssuche sind!
3
4
Erstelle zu einem der vorgestellten Experimente ein Protokoll!
Vergleiche deine Ergebnisse mit denen von Mitschülerinnen und Mitschülern! Besprecht und vergleicht eure Vorgehensweisen und Erfahrungen! Austausch unter Forschenden ist wichtig, so lernt man voneinander.
Falls ihr zu unterschiedlichen Ergebnissen gekommen seid, findet mögliche Gründe dafür! Müssen Versuche immer gleich ausgehen?


Abb. 2: Biene auf einer Blüte
Chitin, das: fester Stoff; ähnlich dem Horn
Abb. 1: Der Tierstamm, zu dem auch die Insekten gehören, heißt „Gliederfüßer“.
Überlege: Woher kommt diese Bezeichnung?
Beobachte Insekten beim Bewegen! Sind ihre Beine gut dafür geeignet? Wie wäre es, wenn ihre sechs Beine wie die des Menschen geformt wären?
Tipp: Im Internet findest du viele Videos, um die Bewegung von Insekten zu betrachten. Suche danach! Sieh nach, wer das jeweilige Video hochgeladen hat!
Beurteile die Quelle!
Stelle fest, welche Tiergruppen aufgrund des Aussehens ihrer Beine noch zu den Gliederfüßern gezählt werden können!
Erörtere die Vorund Nachteile eines Außenskeletts!
Vergleiche dazu die Beine von Insekten und Säugetieren!

Beobachte eine Biene im Flug!
Insekten sind die artenreichste Tierklasse. Etwa 1 Million Arten wurden von Biologinnen und Biologen bis jetzt entdeckt und beschrieben. Die ältesten Insekten, die man kennt, haben vor ungefähr 400 Millionen Jahren gelebt. Seit damals hat sich aus den ersten Insekten eine unglaubliche Vielzahl an unterschiedlichen Tieren entwickelt.
Insekten können sehr unterschiedlich aussehen, Trotzdem haben sie einige wichtige Merkmale gemeinsam, die sich bei ihren gemeinsamen Vorfahren entwickelt und seither bewährt haben.
2 So verfügen alle Insekten anstelle eines Skeletts aus Knochen über ein Außenskelett aus Chitin.
2 Die Beine bestehen aus mehreren Gliedern, die miteinander beweglich verbunden sind.
Der Körper von Insekten – und damit auch der Biene – ist in drei Abschnitte gegliedert. Diese sind der Kopf, die Brust und der Hinterleib.
Kopf Brust Hinterleib

Schenkelring
Punktaugen
Fassettenaugen
Mundöffnung
2 Fühler
Honigmagen
Zunge
3: Körperbau und innere Organe der Biene

2 Paar häutige Flügel
offener Blutkreislauf (Herz)
Darm
Giftstachel mit Giftapparat
3 Beinpaare
(Hinterbeine: Sammelbeine)
Am Kopf der Biene befinden sich 3 Punktaugen, mit denen sie Hell und Dunkel unterscheidet. Die Netz- oder Fassettenaugen bestehen aus 5 000 Einzelaugen. Bienen sehen Farben, können aber Rot und Schwarz nicht unterscheiden. Die beiden Fühler sind die Organe für den Tast- und Geruchssinn. Die Biene leckt oder saugt mit ihren Mundwerkzeugen – vor allem mit der Zunge – den Nektar auf.
Am Brustabschnitt befinden sich zwei Paar häutige Flügel und drei Beinpaare. Im Hinterleib befindet sich der Giftapparat mit dem Stachel.
Bienen haben – wie alle Insekten – einen offenen Kreislauf. Das Herz hat Öffnungen, durch die es die Körperflüssigkeit ansaugt. Diese wird dann aus dem Herzen herausgepresst und fließt frei durch den Körper.
Jedes Insekt besitzt Netz- oder Fassettenaugen, die aus vielen Einzelaugen bestehen. Jedes Einzelauge liefert einen Bildpunkt, alle zusammen ermöglichen dem Tier das Sehen.


Alle Insekten atmen durch ein Tracheensystem. Es besteht aus Röhren, die durch Chitinspiralen verstärkt sind. Diese Röhren sind im ganzen Körper verzweigt und versorgen ihn mit Sauerstoff. Durch Atemlöcher am Hinterleib (Stigmen) strömt die Luft in die Röhren.
Abb. 6: Tracheensystem mit Chitinspirale

Abb. 5: Fassettenaugen der Biene

Abb. 7: Lila gezeichnet, das Tracheensystem bei Insekten.







Abb. 8: Entwicklung der Biene



Bei der unvollständigen Verwandlung sieht die Larve nach dem Schlüpfen dem erwachsenen Tier schon sehr ähnlich. Durch mehrmaliges Häuten entwickelt sie sich zum Vollinsekt.







Die Bienenkönigin legt Eier, die nur 1,5 mm lang sind. Nach 3 Tagen schlüpft aus dem Ei eine beinlose Larve, die Made. Diese wird gefüttert, wächst, häutet sich mehrmals und spinnt sich schließlich in ihrer etwa 6 mm breiten und 12 mm tiefen Wabe ein. Sie wird zur 1 cm langen Puppe. Innerhalb von 12 Tagen verwandelt sich die Puppe, die in dieser Zeit ohne Nahrung auskommt, in eine Biene. Diese Entwicklung – EI R LARVE R PUPPE R VOLLINSEKT – nennt man eine vollkommene Verwandlung.
Beschreibe, wie die Atmung bei Wirbeltieren funktioniert!
Erkläre die Atmung von Insekten mit eigenen Worten!
Erörtere die Unterschiede der beiden Arten von Atmung! Welche Vor- und Nachteile haben beide Methoden? Denke dabei an die Größe von Säugetieren und Insekten!
Abb. 9: Unvollständige Verwandlung bei der Heuschrecke

Waben: kleine Gebilde aus Wachs mit sechseckigem Querschnitt, in denen Bienen ihren Honig aufbewahren oder ihren Nachwuchs heranziehen

Beobachte das Leben in einem Bienenstock!
Hier fehlt ja einiges! Beschrifte die fehlenden Teile der Biene! Welche Aufgaben haben diese?





Brust




Giftstachel mit Giftapparat

Nenne drei Merkmale, an denen du erkennst, dass die Honigbiene ein Insekt ist!
Lies den Informationstext aufmerksam durch!
Rätselhaftes Bienensterben
Weltweit sterben Bienenvölker. Die Zahlen geben Grund zur Sorge. So müssen sich Imker mittlerweile darauf einstellen, innerhalb eines Winters fast ein Drittel ihrer Schützlinge zu verlieren.
Unter anderem ist die aus Asien eingeschleppte Varroamilbe dafür verantwortlich. Sie zehrt am Blut ihrer Opfer und überträgt so Krankheitsmilben. Wird ein Bienenvolk nicht behandelt, kann es an dem Milbenbefall zugrunde gehen. Auch Pflanzenschutzmittel können den



Bienen schaden. Die Tiere verlieren ihre Orientierung und finden nicht mehr in ihren Bienenstock zurück. Dass Honigbienen heute offenbar generell anfälliger gegenüber Krankheiten und Parasiten sind, deutet auch auf ein geschwächtes Immunsystem hin. Schon seit längerer Zeit untersuchen Forscherinnen und Forscher verschiedene Faktoren, wie den weltweit gestiegenen Anbau von Monokulturen und den Transportstress der Völker. bearbeitet nach: planet-wissen.de (11. 2. 2023)

Diskutiert in Kleingruppen, welchen Bedrohungen Bienen ausgesetzt sind! Erörtert, weshalb es beim Bienensterben um mehr als den Verlust von Honig geht! Präsentiert eure Ergebnisse!
Schutz der Bienen – Informiere dich über Bienenschutzprogramme in Österreich!
A Gehe dazu auf die Seite des Naturschutzbundes Österreichs unter naturschutzbund.at!
B Notiere Projekte, die dich interessieren würden und bei denen du mitmachen möchtest!
C Erstelle eine Liste an Aktivitäten, wie du Bienen helfen kannst!
Gestaltet zu zweit einen Aufkleber oder Button zum Bienenschutz!

Bienen leben nicht allein, sondern in großen Gemeinschaften, in denen jedes Tier ganz bestimmte Aufgaben zu erfüllen hat. Solche Insekten nennt man Staatenbildende Insekten

Bienen sind in der Lage, aus Nektar Honig herzustellen. Nektar ist ein zuckerhaltiger Saft, den die Blüten von Pflanzen abgeben, um Insekten anzulocken. Schon in der Steinzeit aß der Mensch den Honig der wild lebenden Bienenvölker. Im Alten Ägypten begann der Mensch dann bereits vor 6 000 Jahren, Bienen zu züchten. Honig war lange Zeit das einzig bekannte Süßungsmittel.
Der ursprüngliche Lebensraum der Bienen ist der Wald. Dort bauen sie ihre Waben in Baumhöhlen. Die Honigbiene hat als natürlicher Bestandteil der heimischen Tierwelt eine wichtige ökologische Bedeutung. So bestäuben Honigbienen einen großen Teil der Blütenpflanzen in unseren Breiten und garantieren dadurch den Fortbestand dieser Pflanzen.
Arbeitsteilung im Bienenstaat
Bienen bilden einen Dauerstaat. Dieser umfasst im Sommer 40 000 bis 80 000 Bienen. In diesem Bienenstaat gibt es Arbeiterinnen, Drohnen (männliche Bienen) und eine einzige Königin.
BIENENKÖNIGIN: Sie ist die größte Biene und kann als einziges Weibchen die Waben mit Eiern bestiften. Dabei legt sie ihre Eier in die Waben. Eine Königin wird ca. 5 Jahre alt. Zwei Mal in ihrem Leben verlässt sie mit einem Teil des Volkes den Bienenstock:
Als junge Königin fliegt sie auf Hochzeitsflug. Dabei paart sie sich mit den Drohnen anderer Bienenvölker. Dies ist wichtig, um die genetische Vielfalt zu erhalten. Für den Rest ihres Lebens legt sie täglich bis zu 3 000 Eier. Gegen Ende ihres Lebens legt sie immer mehr unbefruchtete Eier, aus denen sich ausschließlich Drohnen entwickeln. Schlüpft eine junge Königin, verlässt die ältere Königin ungefähr eine Woche vorher mit einem Teil des Bienenvolkes den Stock, um einen neuen Staat zu gründen.
Da die Königin keine gute Fliegerin ist, lässt sie sich bald irgendwo nieder. Die Bienen bilden eine Schwarmtraube um sie. Die Imkerin oder der Imker (Bienenzüchterin oder Bienenzüchter) fängt den Schwarm wieder ein und gibt ihn in einen neuen Stock.
ARBEITERINNEN: Die meisten Bienen im Bienenstock sind unfruchtbare Weibchen. Sie verrichten alle Arbeiten. Eine Arbeiterin lebt im Sommer etwa 6 Wochen. In dieser Zeit übernimmt sie unterschiedliche Aufgaben: Zunächst putzt sie die Waben, dann pflegt sie als Amme die Brut. Haben sich ihre Wachsdrüsen entwickelt, scheidet sie Wachs aus, aus dem sie die Waben baut. Später wird sie zur Wächterin vor dem Bienenstock. Die zweite Hälfte ihres Lebens verbringt die Arbeiterin als Trachtbiene, die Nektar sammelt. Nektar wird dann zu Honig umgewandelt und ist vor allem im Winter die Nahrung der Bienen.


Dauerstaat, der: Die Tiere überleben den Winter im Bienenstock.


Abb. 4: Wespe und Hummel – Verwandte der Biene
Amme, die: hier R Arbeiterin bei den Bienen, die Eier und Larven betreut
Wachs, das: weiche knetbare Masse; wird als Brennmaterial in Kerzen verwendet
kneten: durcharbeiten, formen
DROHNEN: Das Leben der Männchen ist kurz. Sie paaren sich beim Hochzeitsflug mit der Königin. Danach, bei der Drohnenschlacht, werden sie von Arbeiterinnen aus dem Stock geworfen und sterben.
Argumentiere, weshalb es von Vorteil ist, dass die Arbeiterinnen erst in ihrer zweiten Lebenshälfte den Stock verlassen, um Nektar zu sammeln! †
Erinnere dich an das Schneeglöckchen!
Wie tragen die Ameisen zu dessen Verbreitung bei?


Ameisen Viehzucht!
Ameisen leben mit Blattläusen in Symbiose. Die Ameisen schützen die Blattläuse und erhalten von ihnen dafür süßen Pflanzensaft, den die Blattläuse aus Pflanzen saugen. Um an diesen Saft zu kommen, „melken“ die Ameisen die Blattläuse, indem sie ihnen auf den Hinterleib klopfen.

Begründe, warum Ameisenhaufen im Wald nicht zerstört werden dürfen!
häuten: aus der alten Haut schlüpfen

Königin nach Abwurf der Flügel
Der Ameisenstaat
Ameisen kommen in allen Schichten des Waldes vor. Die Ernährung von Ameisen kann sehr unterschiedlich sein. Manche Arten ernähren sich von pflanzlichem Material, andere sind Aasfresser oder Räuber. Ameisenstaaten können aus mehreren Millionen Tieren bestehen.
Diese Tiere haben einen großen Einfluss auf den Stoffkreislauf ihrer Umwelt. Sie graben unterirdische Nester und durchmischen so den Boden. Auch spielen sie eine große Rolle beim Abbau von toten Pflanzen und verbreiten Pflanzensamen. Als Räuber regulieren sie ebenso den Bestand an anderen Insekten und Bodenbewohnern. Sie selbst sind aber auch Nahrung für andere Tiere. So werden sie von anderen Insekten und von verschiedenen Vogelarten gefressen. Sogar Wildschweine graben ihre Nester aus und fressen die nahrhaften Larven.
Die Große Rote Waldameise – der Ameisenhaufen Alle Waldameisen brauchen die Wärme des Sonnenlichtes. So kannst du auf Waldlichtungen, vor allem im Nadelwald, den Bau der Roten Waldameisen finden. Aus Ästchen, Blättern, Nadeln und Steinchen bauen sie Haufen, die über der Erde bis zu 2 m hoch sind und genau so tief in den Boden reichen. Im Ameisenbau leben zwischen 200 000 und 2 Mio. Ameisen. Im Sommer spielt sich das Leben im gesamten Ameisenbau ab. Im Winter aber ziehen sich die Tiere in den unterirdischen Teil zurück.

Der Ameisenstaat ist ein Dauerstaat. In ihm leben Königinnen, Arbeiterinnen und Männchen. Es gibt mehrere Königinnen und hunderttausende unfruchtbare Arbeiterinnen. Wie bei den Bienen hat auch bei den Ameisen jedes Tier eine bestimmte Aufgabe. Die Königinnen haben die Aufgabe, den Staat zu erhalten und Eier zu legen. Sie fliegen einmal in ihrem Leben auf Hochzeitsflug und paaren sich mit den geflügelten Männchen. Nur zur Zeit des Hochzeitsfluges besitzen Ameisen häutige Flügel. Danach werden die Flügel abgeworfen.
Ende März beginnen die Königinnen mit der Eiablage. Arbeiterinnen halten die Eier sauber und lecken sie immer wieder ab, damit sie nicht austrocknen. Nach 13 Tagen schlüpfen kleine Maden aus den Eiern. Sie werden von den Arbeiterinnen versorgt, häuten sich einige Male und verpuppen sich. Ihre Puppen tragen die Ameisen bei Sonnenschein aus dem Bau, da Wärme für diese wichtig ist. Oft werden die Puppen fälschlicherweise als Ameiseneier bezeichnet, doch die Eier bleiben immer im Bau. Aus den Puppen schlüpfen schließlich junge Ameisen. Auch Ameisen machen eine vollkommene Verwandlung durch.


1 2
Wabenrätsel: In den Waben haben sich Silben versteckt, die du als Fachwörter brauchst. Setze sie zusammen und ordne sie den Erklärungen zu!

-SET- -TAR -TEN- WA- -WIE- -YALE WEI-
kleine sechseckige Zellen: _____________________ Augen der Biene: _____________________________ männliche Bienen: __________________________ Futter für die Königin: _________________________ pflegt die Brut: ______________________________ Waben der Königinnen: _______________________ zuckerreiche Flüssigkeit: ______________________ Bienenzüchter: ______________________________
Verwandte der Biene: ________________________ beinlose Larve: ______________________________

Eine Arbeiterin lebt ungefähr 6 Wochen. In dieser Zeit verrichtet sie im Bienenstaat alle anfallenden Arbeiten. Ihre Aufgaben verändern sich aber, wenn sie älter wird. Lies zuerst den Lebenslauf einer Biene und ordne dann die Bilder den Textteilen zu, indem du die richtigen Buchstaben einsetzt!
A 1. bis 3. Tag:
Die Biene säubert die Waben und richtet sie für die Eiablage her.
B 4. bis 5. Tag:
Sie bereitet die Pollennahrung für die älteren Larven vor.
C 6. bis 13. Tag:
Die Biene versorgt junge Larven und die Königin mit Futtersaft.
D 14. bis 16. Tag:
Die Biene scheidet Wachs aus, das sie für den Bau von Waben benötigt.
E 17. bis 19. Tag:
Sie bewacht den Eingang des Bienenstocks.
F ab dem 20. Tag:
Die Biene sammelt Nektar, Pollen und Wasser.
G nach etwa 40 Tagen:
Die Biene stirbt.

Wie heißen diese Insekten? Wer wohnt in welchem Staat? Benenne zuerst die Tiere und ihre „Wohnungen“! Dann schreibe die passenden Buchstaben zu der jeweiligen Wohnung dazu!




B C


WaldameisenAmeisenhaufenHonigbiene BienenstockWespennestWespe









Wer ist wer? Der Text im Kästchen hilft dir, dieses Rätsel zu lösen.
Sie sind die Arbeiterinnen im Ameisenbau und eher klein. Sie haben Flügel, da sie mit der Königin auf Hochzeitsflug gehen und sie dabei besamen. Sie hat einen großen Hinterleib und ist die Einzige, die Eier legen kann.



Name:
Name:
Name:
Aufgaben:
Aufgaben:
Aufgaben:
Lerne die Ameisen deiner Umgebung besser kennen! Wähle Orte mit viel Grün in deiner Umgebung aus und halte dort nach Ameisen Ausschau! Wenn du einen Ort mit zahlreichen Ameisen gefunden hast, führe folgende Schritte durch:
1. Zeichne oder fotografiere einzelne Tiere, so dass sie gut zu erkennen sind!
2. Versuche den Bau zu finden! Notiere und skizziere, was davon zu sehen ist!
3. Beobachte und notiere, mit was die Ameisen beschäftigt sind! Kannst du eine Aufgabenteilung erkennen?

Abb. 8: Eingang eines Ameisenbaus
Ameisen sind wehrhaft! Ameisen haben unterschiedliche Strategien, um sich zu verteidigen. Die in Österreich heimische Rote Waldameise kann beispielsweise Ameisensäure verspritzen. Beobachte das Verteidigungsverhalten von Ameisen!

Abb. 9: Rote Waldameise gibt Säure ab
Du brauchst: Wattestäbchen. Halte das Wattestäbchen an einen Ameisenbau und berühre die Ameisen leicht! Beobachte, wie sie auf die Störung reagieren! Tipp: Mit einer Lupe kannst du alles besser beobachten, mit einer Handykamera mitfilmen und das Geschehen später weiter begutachten.
Falls die Ameisen Säure versprühen, wird diese vom Wattestäbchen aufgesaugt und man kann sie riechen! Bei einem größeren Bau funktioniert das auch gut mit einem Taschentuch!
Ameisenstraße! Beobachte das Transportsystem von Ameisen!
Du brauchst: ein Stück überreifes Obst.
Finde einen Ort, wo sich viele Ameisen tummeln! Lege das Obststück so, dass die Ameisen es leicht finden! Beobachte ihr Verhalten! Lass etwas Zeit vergehen und sieh dann nach, was sich getan hat!
Du kannst auch versuchen, eine bestehende Ameisenstraße auf das Obststück auszuweiten. Dokumentiere deine Beobachtungen!

Abb. 10: Ameisenstraße
Recherchiere: Wie finden Ameisen ihren Weg zum Obststück zurück?
8
Vergleicht und besprecht eure Beobachtungen in Kleingruppen!
Diskutiert: Unter welchen Umständen werden Ameisen von Menschen als störend, oder sogar als Schädlinge empfunden!

Tagfalter, der: Bezeichnung für Schmetterlinge aus unterschiedlichen Familien, die vorwiegend tagsüber aktiv sind

Abb. 2: die unauffällige Unterseite der Flügel des Tagpfauenauges

Abb. 3: Schuppen auf einem Schmetterlingsflügel

Abb. 4: eingerollter Rüssel
Abb. 5: Beschrifte die Raupe mit den Zahlen aus dem Fließtext!

In allen Schichten des Mischwaldes finden Schmetterlinge und ihre Raupen ausreichend Nahrung und Lebensraum.
Das Tagpfauenauge gehört zu den Tagfaltern. Wie die meisten Tagfalter hat es bunt gefärbte Flügel. Auf diesen befinden sich Zeichnungen, die wie Tieraugen aussehen. Diese falschen Augen erschrecken Feinde oder verwirren sie und lassen sie an der falschen Stelle zuschnappen. Sitzen Tagfalter längere Zeit still, dann klappen sie ihre Flügel nach oben. Da ihre Flügelunterseite unauffällig ist, werden sie von Feinden nicht so schnell entdeckt.
Das Tagpfauenauge überwintert als Falter an geschützten Stellen, beispielsweise in Dachböden oder Baumhöhlen. Im Frühjahr legt das besamte Weibchen Eier an die Unterseite von Brennnesselblättern. Aus den Eiern schlüpfen die Larven, die bei den Schmetterlingen Raupen genannt werden.
Die Raupen ernähren sich von den Blättern der Brennnessel. Sie häuten sich mehrmals und wachsen, bis sie groß genug sind, um sich zu verpuppen. Aus der Puppe schlüpft der Falter. Schmetterlinge durchlaufen eine vollkommene Verwandlung
Körperbau des Falters und der Raupe
Tagpfauenaugen gehören zu den Insekten und haben wie alle Insekten die typische Kopf, Brust und Hinterleib.
KOPF: Am Kopf sitzen zwei Fassettenaugen und zwei Fühler. Die Mundwerkzeuge sind zu einem langen Rüssel geformt, mit dem der Schmetterling Nektar saugen kann. Wird er nicht gebraucht, so ist der Rüssel eingerollt.

Abb. 1: Körperbau des Tagpfauenauges
BRUST: Die beiden Flügelpaare am Brustabschnitt sind mit bunten Schuppen besetzt. Jede Schmetterlingsart hat eine typische Farbe und Zeichnung. Die 6 Beine haben an den Fußgliedern empfindliche Geschmacksorgane und kleine Dornen aus Chitin. Mit ihnen reinigt der Falter seinen behaarten Körper.





Die Raupe hat einen völlig anderen Körperbau. Du erkennst rechts den Kopf (1), 3 Brustbeinpaare (2) und 4 Bauchbeinpaare (3).

Das Tagpfauenauge atmet – wie alle Insekten – durch ein Tracheensystem. Es besteht aus Röhren, die durch Chitinspiralen verstärkt sind. Diese Röhren sind im ganzen Körper verzweigt und versorgen ihn mit Sauerstoff. Durch Atemlöcher am Hinterleib (Stigmen) strömt die Luft in die Röhren.
Abb. 6: Tracheensystem
Art Flügelhaltung im Sitzen

Tagfalter


Schwärmer

Echte Spinner
Eulenfalter








nackt mit Horn

meist behaart

meist nur vereinzelte kurze Haare




Birkenspanner


1 Paar Bauchfüße

Schmetterlinge und ihre Lebensräume sind bedroht Als Pflanzenfresser und Blütenbestäuber sind Schmetterlinge eng mit den Pflanzen ihres Lebensraumes verbunden. Jede einzelne Art braucht bestimmte Umweltbedingungen und Pflanzenarten zum Überleben. In Europa werden durch das Trockenlegen von Feuchtgebieten, intensive Landwirtschaft mit ihrem Einsatz von Dünger und Giftstoffen und Verbauung die Lebensräume der Schmetterlinge zerstört. Mehr als die Hälfte aller Tagfalter Österreichs und rund 40% der Nachtfalterarten gelten als gefährdet. Einige der Arten sind bereits ausgestorben.




Abb. 7: von oben nach unten: Zitronenfalter, Ligusterschwärmer, Seidenspinner (Echte Spinner), Rotes Ordensband (Eulenfalter), Kiefernspanner
Erörtert gemeinsam, wie es in eurer Umgebung zur Gefährdung von Schmetterlingen und ihrem Lebensraum kommt! Welche Maßnahmen müssten ergriffen werden, um Schmetterlinge zu schützen!

Beobachte einen Käfer im Flug!
vermodern: verfaulen, sich zersetzen


Käfer sind wichtig für die Ökologie!
Manche Käferarten wie der Mistkäfer ernähren sich von Kot. Andere wie der Gemeine Totengräber ernähren sich vorwiegend von Aas. So tragen diese Käfer dazu bei, dass der Stoffkreislauf in der Natur funktioniert.
Kot, der: Ausscheidung von Tieren
Aas, das: toter Körper eines Tieres


Abb. 4: Gemeiner Totengräber
verwesen: sich nach dem Absterben zersetzen
Kopf
Erörtert, wie die Maikäferpopulation durch Gifte und Düngemittel in Landwirtschaft und Garten beeinflusst wird!
Borke: äußere Schicht eines Baumstammes
Derzeit kennt man weltweit etwa 380 000 Käferarten. Rund 7 500 davon kommen auch in Österreich vor. Die ersten Käfer sind vor ungefähr 270 Millionen Jahren entstanden. Seitdem haben sich daraus viele unterschiedliche Käferarten entwickelt, die sich auf bestimmte Nahrungsquellen oder Lebensräume spezialisiert haben. Dementsprechend vielfältig sind auch Aussehen und Verhalten von Käfern.
Käfer haben im Laufe ihrer Evolution einen Chitinpanzer ausgebildet. Auch die Deckflügel bestehen aus Chitin. Die häutigen Hinterflügel braucht der Käfer, um zu fliegen. Sie werden im Ruhezustand von den harten Deckflügeln geschützt.
Halsschild
Deckflügel
Hinterflügel

Käfer durchlaufen eine vollkommene Verwandlung. Die meisten Insekten verbringen einen Großteil ihres Lebens im Larvenstadium. So lebt die Larve des Hirschkäfers bis zu acht Jahre in vermoderndem Holz. Das erwachsene Tier lebt nach dem Schlüpfen nur wenige Wochen. In dieser Zeit paart es sich und die Weibchen legen die Eier für die nächste Generation.


Die Ernährung von Larven und erwachsenen Tieren ist oft sehr unterschiedlich. Die Larve des Maikäfers, die Engerling genannt wird, lebt etwa vier Jahre lang im Boden und ernährt sich dort von Pflanzenwurzeln. Als erwachsenes Tier frisst es die Blätter von Laubbäumen.
Die meisten Käfer sind Pflanzenfresser, die sehr unterschiedliche Teile der Pflanzen fressen. Meist ernähren sie sich von Blättern, Blüten, Samen, Wurzeln oder Stängeln von Pflanzen. Manche Käferarten fressen jedoch auch Holz oder verwesende Pflanzenteile.
Es gibt auch räuberische Käfer, die sich von anderen Insekten, Würmern oder Schnecken ernähren. Sogar kleine Wirbeltiere wie Kaulquappen oder kleine Fische können zur Beute dieser Insekten werden.
Wie viel Nahrung Käfer finden, hängt sehr von den Umweltbedingungen ab. Der Borkenkäfer legt seine Eier unter die Borke von Fichten, wo die Larven schlüpfen und Gänge in die Rinde fressen. Da in forstwirtschaftlich genutzten Wäldern häufig Fichten eng beieinanderstehen, können sich diese Käfer dort sehr stark vermehren und richten großen Schaden an.
Manche Käferarten haben sich auf wenige Pflanzenarten spezialisiert oder können nur unter ganz besonderen Umweltbedingungen existieren. Durch den Eingriff des Menschen oder durch die Klimaveränderung ändern sich die Lebensbedingungen, so dass diese Käfer bedroht sind.
Achtung Fehlertext! Lisa hat beim Abschreiben aus dem Buch vier Fehler gemacht. Streiche sie durch und stelle sie darüber richtig! Zum Schluss überlege dir noch eine passende Überschrift!

Auf der Erde gibt es über 180 verschiedene Schmetterlingsarten. Viele von ihnen zählen zu den gefährlichen Tierarten. Ihre Lebensräume werden vom Menschen geschützt. Das Verschwinden von Kräutern und der Einsatz von Insektengiften nützen den Schmetterlingen ganz besonders.


Welche Larve gehört zu welchem Insekt? Verbinde die Fotos mit Hilfe des Lineals mit Pfeilen! Wie heißen die Insekten und ihre Larven?



3 2 1
Welche Abbildung ist richtig? Kreuze an!



Insekt:
Larve:
Insekt:
Larve:
Insekt:
Larve:



















Es handelt sich hier um eine Verwandlung.
Diese Abbildung braucht Farbe – Male sie zuerst an, dann verfasse eine kurze Information zur Entwicklung des Tagpfauenauges und eine Bildlegende!





1 Das Weibchen legt seine Eier (bis zu 200) auf einer Brennnesselpflanze ab.


Abbildung: ___________________________________

Führe folgenden Versuch durch und erfülle die Aufgaben!

Mehlwürmer heißen so, weil sie wie Würmer aussehen. Tatsächlich sind es aber die Larven des Mehlkäfers. Mit diesem Experiment kannst du die vollkommene Verwandlung bei Insekten beobachten.
Du brauchst: Mehlwürmer (aus der Zoohandlung) % Klarsichtbox % Weizenkleie oder Mehl % getrocknetes Brot oder Semmeln % Äpfel
Durchführung:
2 Fülle die Weizenkleie oder das Mehl 1 – 2 cm hoch in die Klarsichtbox und setze die Mehlwürmer in die Box!
2 Füttere die Mehlwürmer mit Stücken von getrocknetem Brot/Semmeln und mit Apfelstücken! Entferne auch jeden Tag die Obstreste und ersetze sie durch neue, um Schimmelbildung zu vermeiden!
A. Beobachte und beschreibe, wie die Mehlwürmer fressen!
B. Beschreibe, wie sich die Mehlwürmer häuten!

Abb. 5: Mehlkäferlarven (Mehlwürmer)
2 Sobald sich einer der Mehlwürmer verpuppt hat, nimm die Puppe heraus und gib sie in ein separates Gefäß, sonst besteht die Gefahr, dass die Puppe von den Mehlwürmern gefressen wird. In diesem separaten Gefäß brauchst du kein Futter!
2 Beobachte die Puppen weiter!
C. Beschreibe, wie die Käfer schlüpfen!
2 Wenn ein Käfer geschlüpft ist, musst du ihn aus dem Gefäß nehmen, da er sonst die Puppen anfressen könnte!
2 Lass die geschlüpften Käfer auf einer Wiese frei!
Fertige ein Protokoll deines Versuchs an!


Abb. 6: Erwachsener Mehlkäfer
Spinnen gehören – so wie Weberknechte, Skorpione und Milben – zur Klasse der Spinnentiere. Spinnentiere haben Punktaugen und ein Außenskelett aus Chitin. Ihr Körper ist in zwei Abschnitte, das Kopfbruststück und den Hinterleib, gegliedert. In Österreich gibt es ca. 1 000 verschiedene Spinnenarten.
Ökologische Bedeutung der Spinnen

Spinnen werden aufgrund ihrer Artenvielfalt und ihres Vorkommens in vielen Lebensräumen als Bioindikatoren gesehen.
Spinnen leben in einer eng begrenzten Umwelt. Sie stellen auch eng begrenzte Nahrungsansprüche. Für das Vorkommen und die Verteilung von Spinnen in Waldökosystemen spielen das Totholz und die Laubstreu eine wichtige Rolle, da sie Lebensraum vieler Beutetiere der Spinnen sind.
Spinnen sind Beutegreifer. Sie haben eine wichtige regulierende Funktion im Nahrungsnetz. So wird in den Wäldern unserer Breiten beinahe die Hälfte aller Insekten von Spinnen gefressen.
Abb. 1: Gartenkreuzspinne
Spinnentiere, die Seidenfäden herstellen können, gehören zur Ordnung der Webspinnen. Auch die Kreuzspinne ist eine Webspinne. Sie baut ein radförmiges Netz. In einem nahen Versteck oder in der Mitte des Netzes lauert sie auf ihre Beute.

Bioindikator, der: Lebewesen, das auf bestimmte Umwelteinflüsse besonders empfindlich reagiert


Warum sind Spinnen Bioindikatoren?
Spinnen benötigen Beutetiere. Nur wenn diese geeignete Lebensbedingungen vorfinden, können auch die Beute greifenden Spinnen überleben. Das Vorkommen verschiedener Spinnenarten zeigt daher einen funktionierenden Lebensraum an.
Erörtere, warum Spinnen geschützt werden sollen! Argumentiere mit der Bedeutung von Spinnen im ökologischen Gleichgewicht!






Abb. 2: Entstehung eines Spinnennetzes

Zappelt ein Insekt im Netz, spürt die Kreuzspinne die Bewegung und läuft zu dem Tier. Sie spinnt ihr Opfer mit einem Spinnfaden ein. Dann erst tötet sie das Insekt mit ihren Giftklauen. Mit ihrem Biss fließt ein Verdauungssaft in ihr Opfer. Die inneren Organe des Insektes werden flüssig und die Spinne saugt ihr Opfer aus. Man nennt das eine äußere Verdauung. Wird das Insekt nicht gleich gefressen, wird es vollständig umwickelt und als Paket aufgehängt.


Speichen und Rahmen entstehen Hilfsspirale wird gesponnen Fangspirale entsteht



Suche dir ein totes Insekt, z.B. eine Fliege! Setze dieses dann vorsichtig in ein Spinnennetz! In der Regel wird die Spinne sich nicht über diese leichte Beute hermachen. Erkläre weshalb!
Abb. 3: Spinnennetze


Wie wachsen Spinnen? Spinnen schlüpfen schon als fertige Tiere aus dem Ei. Sie müssen sich während des Wachsens mehrmals häuten, bis sie ihre endgültige Größe erreicht haben.
Finde ein Spinnennetz, das du regelmäßig besuchen kannst. Wenn sich die Spinne häutet kannst du ihre leere Haut im Netz hängen sehen!
Abb. 4 Vergleiche den Körperbau der Spinne mit dem der Biene! Was haben die Tiere gemeinsam? Wo gibt es Unterschiede?

Abb. 5: Weberknecht, beachte den ungeteilten Körper.
Baumstrunk, der: unterer Teil eines Baumstamms, der in der Erde bleibt, nachdem der Baum gefällt wurde
Alge, die: einfach gebautes Lebewesen
FSME, die: FrühsommerMeningoenzephalitis (Entzündung von Gehirn und Gehirnhaut)
Körperbau der Kreuzspinne
Der Körper besteht aus dem Kopfbruststück und dem Hinterleib. Am Kopf befinden sich 8 Punktaugen.
Kopfbruststück
offener Blutkreislauf
8 Punktaugen
Saugmagen
Darm
Herz
Hinterleib
Ausscheidungsorgane
Eierstock
Borreliose, die: Infektionskrankheit, die das Nervensystem, Gelenke und jedes Organ befallen kann

2 Kiefertaster 2 Giftklauen 4 Beinpaare
Abb. 4: Körperbau der Kreuzspinne
Tracheen Spinndrüsen Spinnwarzen
Am Kopfbruststück befinden sich 4 Paar gegliederte Beine. Das letzte Beinpaar besitzt Webklauen, mit denen die feinen Fäden aus dem Saft der Spinndrüsen zu einem Spinnfaden verwoben werden.
Im Hinterleib liegen die Verdauungsorgane, das Herz, die Atmungsorgane, die Geschlechtsorgane und die Spinndrüsen.
Der Weberknecht gehört zwar zu den Spinnentieren, ist aber keine Spinne. Wichtigste Unterscheidung ist die Verwachsung von Vorder- und Hinterkörper. Der Weberknecht baut kein Netz. Er hat keine Spinndrüsen und keine Giftdrüsen. Er sucht in der Dämmerung nach toten Insekten und frisst auch vermoderte Pflanzenteile. Der Weberknecht kann bei Gefahr ein Bein abwerfen. Da sich sein Bein weiterbewegt, lenkt es so den Feind ab und der Weberknecht läuft auf sieben Beinen davon.
Milben sind eine eigene Unterart der Spinnentiere. Sie haben sich an viele Lebensräume angepasst. Die Hornmilben besiedeln die oberste Bodenschicht, Moospolster und Baumstrünke. Milben sind keine ausschließlichen Beutegreifer, sondern fressen auch Algen, Pilze, Sporen, vermoderte Pflanzen und Laubstreu. Sie tragen zur Humusbildung bei. Einige sind auch Parasiten

Abb. 6: Zeckenkarte 2022
Eine bei uns heimische Milbenart ist die Waldzecke, die auch Gemeiner Holzbock genannt wird. Das weibliche Tier wird von Körperwärme und Schweißgeruch angelockt. Sie beißt sich an Säugetieren fest und saugt deren Blut. Dabei können die Erreger gefährlicher Krankheiten – wie FSME – übertragen werden. Bei dieser Erkrankung kommt es zur Gehirnhaut- und Gehirnentzündung. Sie kann tödlich enden. Auch Borreliose kann übertragen werden.
Skorpione
Auch Skorpionen gehören zu den Spinnentieren. Sie leben auf sandigen oder steinigen Böden in warmen Gebieten. Der Deutsche Skorpion und der Karpaten Skorpion kommen auch in Österreich vor. Man kann sie im südlichen gebirgigen Kärnten finden.
Auffallend am Skorpion sind die Scheren sowie der Giftstachel. Die Scheren sind nicht aus einem Beinpaar entstanden, sondern entsprechen den Kiefertastern bei Spinnen. Der Giftstachel sitzt am Hinterleib des Tieres, das aus beweglichen Segmenten besteht. Mit ihm tötet er größere Beutetiere. Wie alle Spinnentiere hat auch der Skorpion vier Beinpaare.
Tausendfüßer

Tausendfüßer gehören wie die Insekten und die Spinnentiere zu den Gliederfüßern Ihr Rumpf ist aus zahlreichen gleichartigen Segmenten aufgebaut, die jeweils ein Beinpaar tragen. Diese Tiere besiedeln die obere Bodenschicht oder die Streuschicht. Die pflanzenfressenden Arten ernähren sich von abgestorbenen Pflanzenteilen und sind daher wichtige Abfallbeseitiger in der Natur. Die räuberischen Arten jagen hier kleinere Insekten, deren Larven, Schnecken oder Spinnen.

8: Schwarzer Schnurfüßer – ein bei uns heimischer Tausendfüßer
Auch wenn sie Tausendfüßer heißen, kennt man nur eine Art, die tatsächlich so viele Beine hat. Die meisten Arten haben viel weniger Beine. So gibt es Arten, die nur 12 Beinpaare haben, bei manchen Arten kann die Anzahl der Beinpaare von Tier zu Tier unterschiedlich sein.
Abb. 7: a) Vergleiche den Körperbau des Skorpions mit denen der Spinne und des Weberknechts! Notiere Gemeinsamkeiten und Unterschiede! Ist es einleuchtend, dass sie alle Gliederfüßler sind?

Die Scheren des Skorpions
Skorpione verwenden ihre Scheren zum Graben von Erdlöchern. Außerdem fangen sie damit ihre Beute und halten sie fest.

Die Asseln zählen zu den Krebstieren, die vor allem im Wasser leben. Eine Gruppe von Asseln, die Landasseln, haben das Wasser verlassen und leben ausschließlich an Land. Wie die Krebse atmen sie aber nach wie vor mit Kiemen. Da diese ständig feucht sein müssen, damit das Tier atmen kann, kommen Landasseln vor allem in feuchten Lebensräumen vor.
Eine Landasselart, die in Österreich vorkommt, ist die Kellerassel. Wie der Name schon sagt, kommt sie auch in feuchten Kellern vor und ernährt sich von abgestorbenen organischen Substanzen. Im Freien findet man sie vor allem in der Streuschicht von feuchten Laubwäldern, aber auch in Gärten und in Komposthaufen.

b) Benenne die Teile der Beine des Skorpions in der Abbildung!
Spinnen haben Kiefertaster, Skorpione Scheren. Weberknechte und Milben haben ähnliche Werkzeuge hervorgebracht. Suche auf Wikipedia.org nach diesen Tierarten und siehe bei „Systematik“ nach, zu welchem „Unterstamm“ sie gehören. Begründe diese Zuteilung! Gehören auch Tausendfüßer dazu?
Nenne andere wirbellose Tiere, die auch noch aus gleichartigen Segmenten aufgebaut sind!
Analysiere, welche Funktion Abfallbeseitiger für das ökologische Gleichgewicht in einem Lebensraum haben!
organische Substanz, die: Material, aus dem Lebewesen bestehen
Mundwerkzeuge! Betrachte die Bilder genau! Stelle jeweils eine Hypothese zur Art der Nahrung und Funktionsweise der Nahrungsaufnahme auf! Findest du Ähnlichkeiten zu Werkzeugen und Gerätschaften, die Menschen benutzen? Denke dir Versuche aus, mit denen du deine Hypothesen überprüfen könntest!








Betrachte zuerst die Abbildung der Webspinne und studiere sie genau! Dann lies die Anweisungen und erfülle die Aufgaben!
1. Der Körper ist in ein Kopfbruststück und in einen Hinterleib gegliedert. Bemale das Kopfbruststück rot und den Hinterleib grün!
2. Wie viele Beine hat die Spinne? __________
3. An den Hinterbeinen hat diese Webspinne Webklauen, die sie zum Herstellen des Netzes braucht. Kreise sie ein!
4. Die Spinne hat 2 Paar Kiefer. Die längeren Kiefer heißen Kiefertaster und dienen zum Tasten. Das kürzere Paar besitzt 2 einklappbare Giftklauen zum Halten und Lähmen der Beute. Bemale diese blau!
5. Am Hinterleib befinden sich mehrere Spinnwarzen mit Spinndrüsen, in denen Spinnfäden produziert werden. Bemale sie gelb!
Nenne drei Merkmale von Spinnentieren!

Erstelle einen Steckbrief zur Kreuzspinne! Suche dazu nach mehr Information im Internet! Vergleiche die Qualität deiner Quellen! Begründe auch, warum sie für ein Ökosystem wichtig sind!
In der ersten Klasse hast du die Wirbeltiere kennengelernt. In diesem Schuljahr hast du wiederum viel über Insekten und andere wirbellose Tiere erfahren. Beide können nebeneinander im selben Lebensraum existieren. Für dasselbe Problem haben sie aber häufig ganz unterschiedliche Lösungen entwickelt. Betrachte den Vogel und vergleiche ihn mit dem Schmetterling. Beide können fliegen. Dennoch sind sie völlig unterschiedlich aufgebaut.
VÖGEL

Abb.1: Kohlmeise

INSEKTEN

Körperstütze
Wirbeltiere (WT): Der Grundlegende Aufbau der Skelette der verschiedenen Wirbeltieren ist recht ähnlich gestaltet. Neben der Wirbelsäule ist auch der Schädel, also die knöcherne Kapsel, die das Gehirn schützt, ein gemeinsames Merkmal.
Knochen (lebendes Material)

Streckmuskel
Beugemuskel
Gelenk
Abb. 2: Tigerschwalbenschwanz
Wirbellose (WL): Die Skelettstrukturen der verschiedenen Stämme der Wirbellosen unterschieden sich deutlich. Neben den Chitinhüllen der Insekten finden sich die Rückenschilde und Ringpanzer der Tausendfüßer, Schalen von Muscheln und Krebstieren, Gehäuse von Schnecken bis hin zum Schulp, einer Kalkplatte im Inneren des Körpers von Tintenfischen.
Gelenkhaut

Chitin (totes Material)
Streckmuskel
Beugemuskel
Körperbau
Vögel haben einen Rumpf, durch den die Wirbelsäule verläuft, auf dem ein Kopf sitzt. Dieser Bauplan ist auch bei allen anderen Wirbeltieren zu finden. Alle Wirbeltiere außer den Fischen haben vier Gliedmaßen. Diese können ganz unterschiedlich ausgebildet sein, da sie sich im Laufe der Evolution an sehr unterschiedliche Aufgaben angepasst haben. Bei Vögeln sind zwei davon Flügel, bei den Walen sehen sie wie Flossen aus, der Maulwurf verfügt über schaufelartige Vorderglieder.
Der Körper von Insekten ist in Kopf, Brust und Hinterleib gegliedert. Die sechs Gliedmaßen setzen an der Brust an.
Die Flügel von Insekten sind keine umgebildeten Gliedmaßen, sondern sind zusätzliche Organe. Da die Wirbellosen unterschiedliche Tierstämme mit sehr unterschiedlicher Entwicklungsgeschichte umfassen, ist auch ihr Körperbau sehr unterschiedlich. Ein Großteil verfügt über einen vom Rest des Körpers unterscheidbaren Kopf. Bei den Stachelhäutern, Muscheln oder Nesseltieren ist der Aufbau jedoch deutlich anders.
Vögel haben Schnäbel unterschiedlicher Form, die an die Lebensweise der Tiere und die Art, ihre Nahrung zu gewinnen, angepasst sind.
Rabenvögel nutzen vielfältige Nahrungsquellen und verfolgen ganz unterschiedliche, oft sehr intelligente Strategien zur Nahrungsbeschaffung. Ihr Schnabel ist ein Allroundwerkzeug mit dem sie gut greifen können.
Tukane nutzen ihre großen aber leichten Schnäbel dazu, um große Früchte zu zerquetschen und deren Saft zu trinken. Durch die Regelung des Blutflusses im Schnabel können die Vögel auch ihren Wärmehaushalt regulieren.
Hakenschnäbel, wie Adler sie tragen, dienen Greifvögeln dazu, ihre Beute zu zerteilen. Zum Töten der Beute nutzen die Vögel vorwiegend ihre Klauen.
Als Mundwerkzeuge werden die zur Nahrungsaufnahme benutzten Organe der Gliederfüßer bezeichnet. Sie haben sich im Laufe der Evolution aus Gliedmaßen der zum Kopf verschmolzenen vordersten Körpersegmente gebildet. Je nach den von den verschiedenen Ernährungsformen vorgegebenen Anforderungen an ihre Funktion, haben sich dabei sehr unterschiedliche und hochspezialisierte


Abb. 3: Der Schnabel der Rabenkrähe ist groß und robust.


Abb. 4: Die Farbenpracht des Schnabels des Riesentukans dient auch der Partnersuche.


Abb. 5: Der Schnabel des Weißkopfseeadlers zeigt die für Greifvögel typische Form mit scharfer Spitze.
Andere Schnabelformen und die Gebisse von Pflanzenfressern, Allesfressern, Nagetieren und Beutegreifern hast du bereits in der ersten Klasse kennen gelernt. Sieh sie dir nocheinmal an und betrachte deinen eigenen Mund im Spiegel. Auch Reptilien und Amphibien verfügen über die für Wirbeltiere (außer den Rundmäulern) typischen Wirbeltiermäuler.



Abb. 6: Aldabra Riesenschildkröte. Achte auf den für die meisten Wirbeltiere typischen beweglichen Unterkiefer und den fix am Schädel liegenden Oberkiefer.

Abb. 7: Rotäugiger Baumfrosch

Formen herausgebildet. Gemeinsam ist Mundwerkzeugen, dass sie vor der Mundöffnung gelagert sind. Hummeln haben wie Bienen Zungen entwickelt, um Nektar aus Blüten aufzunehmen. Bei weiblichen Stechmücken bilden die Mundwerkzeuge einen feinen Stechrüssel aus Stechborsten. Damit können sie die Haut von Wirtstieren durchdringen und Blut saugen. Dieses brauchen sie einmalig, um ihre Eier zu bilden. Auch bei Bremsen saugen nur die Weibchen Blut, Männchen ernähren sich von Nektar. Die Mundwerkzeuge der Weibchen reißen eine Wunde in die Haut ihres Wirts. Das austretende Blut wird vom Insekt aufgenommen. Ameisen haben kräftige Beißwerkzeuge (Mandibel). Ihre anderen Mundwerkzeuge lassen noch gut die evolutionäre Entwicklung aus Beinen erkennen. Sie sind unscheinbarer, aber wichtig zum Tasten und Riechen. Auch viele Käfer haben ausgeprägte, oft wie Zangen geformte, Mandibel und weitere Mundwerkzeuge, die Sinnesorgane beherbergen. Spinnentiere verfügen über paarige Kieferklauen und Kiefertaster als Mundwerkzeuge. Die Kieferklauen der Spinnen verfügen über Kanäle, die Gift von Giftdrüsen in ihre Beute abgeben. Die Kiefertaster dienen zum Halten und Wenden der Beute und verfügen über Sinnesorgane. Einige Spinnen nutzen sie auch zur Fortbewegung.




Abb. 8: Hummel: Achte auf die verschiedenen Teile und die in der Mitte liegende Zunge.

Abb. 10: Der Stich von Bremsen schmerzt im Gegensatz zu dem der Stechmücken.
Abb. 9: Anopheles Mücke: Die dünnen stilettförmigen Stechborsten dringen leicht durch die Haut. Die stark gegliederten, außen liegenden Antennen beherbergen Sinnesorgane.


Abb. 11: Rote Gartenameise: Achte auf die kleineren, Beinen ähnlichen Mundwerkzeuge.

Abb. 12: Schwarzer Moderkäfer: Unterscheide Antennen, Mandibel und kleinere Mundwerkzeuge.



Abb. 13: Delena Spinnen: Die weiter vorne und innen liegenden Kieferklauen tragen Gift. Weiter hinten und außen liegen die Kiefertaster.

Vögel pflanzen sich geschlechtlich fort. Das heißt, dass es männliche und weibliche Tiere gibt, die sich paaren. Das Weibchen legt Eier. In ihnen reifen die Jungen heran.
Wenn sie schlüpfen, sehen sie bereits wie Vögel aus. Sie wachsen und entwickeln sich langsam zum erwachsenen Tier. Die Entwicklung verläuft bei anderen Wirbeltieren ähnlich.
Viele Wirbeltiere legen Eier, so auch Amphibien, Reptilien und die allermeisten Fische. Eine Besonderheit hat sich bei Säugetieren und einigen Hai- und Rochenarten entwickelt. Sie gebären ihre Jungen lebend.


Auch Insekten pflanzen sich geschlechtlich fort, jedoch schlüpfen bei den meisten Insekten aus den Eiern Larven, die gänzlich anders aussehen als das erwachsene Tier. Im Larvenstadium wachsen sie heran, bevor sie sich verpuppen. Erst danach schlüpft das fertige Insekt.
Arten, die eine unvollkommene Verwandlung durchmachen, sehen schon nach dem Schlüpfen aus dem Ei ähnlich aus wie das erwachsene Tier.
Die geschlechtliche Vermehrung mittels Ei und Samenzelle, über ein oder mehrere Larvenstadien, findet sich ganz allgemein bei den Wirbellosen. Landschnecken schlüpfen allerdings schon vollständig entwickelt aus ihren Eiern. Manche Seesterne können sich durch Regeneration abgetrennter Körperteile ungeschlechtlich vermehren.

Wirbeltiere haben ein Zentralnervensystem, das aus einem Gehirn und dem Rückenmark besteht. Das Gehirn übernimmt die Rolle einer zentralen Informationsverarbeitungs- und Steuereinheit.
Im Rückenmark werden Reflexe durch aufgenommene Reize ausgelöst. Wie vielschichtig das Gehirn von Wirbeltieren aufgebaut ist, hängt stark von der jeweiligen Art ab und steht in engem Zusammenhang mit Intelligenzleistungen.
Abb. 15: Entwicklungsstufen des Maikäfers
Das Nervensystem von Insekten besteht aus mehreren Nervenknoten. Auf der Bauchseite verlaufen zwei parallele Nervenbahnen.
Diese einfache Form des Nervensystems findet sich in den meisten Wirbellosen wieder. Kopffüßer nehmen eine Sonderstellung ein. Bei ihnen sind große Nervenknoten zusammengewachsen und bilden ein Organ ähnlich dem Gehirn der Wirbeltiere. Besonders Kraken sind damit zu außerordentlichen Intelligenzleistungen fähig.
Vögel sind, wie Säugetiere, gleichwarme Tiere. Sie können ihre Körpertemperatur regeln. Die Energie, die sie dazu benötigen, gewinnen sie aus der Nahrung.
Die Körpertemperatur von Insekten passt sich an die Umgebungstemperatur an. Wird es kalt, verfallen die meisten in Kältestarre.
Vögel atmen, wie die meisten anderen Wirbeltiere auch, mit Lungen. In den Lungen wird das Blut mit Sauerstoff angereichert. Das Blut wird vom Herzen in Blutgefäßen durch den gesamten Körper gepumpt und versorgt alle Organe mit Sauerstoff.
Der Aufbau des Herzens unterscheidet sich je nach Wirbeltiergruppe. Von den Organen nimmt das Blut Kohlenstoffdioxid auf, das in der Lunge wieder abgegeben und ausgeatmet wird.
Diesen Transport des Bluts durch ein System aus Blutgefäßen nennt man geschlossenen Blutkreislauf. In der dritten Klasse wirst du wesentlich mehr über die Atmung und das Funktionieren des Blutkreislaufes lernen.

Die Atmung der Wirbellosen geschieht recht unterschiedlich. Insekten atmen durch Tracheen, kleine Röhren aus Chitin. Sie durchziehen den gesamten Körper, versorgen alle Organe mit Sauerstoff und transportieren Kohlenstoffdioxid ab.
Schnecken verfügen über Kiemen, oder Lungen. Würmer atmen über ihre Haut. Auch sehr kleine Krebstiere atmen über ihre Körperoberfläche, während größere Krebse, so wie auch Muscheln über Kiemen verfügen.
Herz Lunge Körper
Abb. 16: Schematische Darstellung des Kreislaufsystems der Säugetiere und Vögel
Insekten verfügen zwar über ein Herz, dieses ist jedoch im Vergleich zum Herz der Wirbeltiere, insbesondere der Säugetiere und Vögel, sehr einfach aufgebaut. Es pumpt das Blut nur über eine gewisse Strecke in Blutgefäßen. Danach kann es sich frei im Körper bewegen. Man nennt dies offenen Blutkreislauf. Auch bei vielen anderen Wirbellosen findet sich ein offener Blutkreislauf. Ringelwürmer und auch Kopffüßer verfügen über einen (fast) geschlossenen Kreislauf.

Abb. 17: Tracheensystem (lila) einer Fliege
Blutgefäße

Blutgefäße
Abb. 18: Offener Blutkreislauf einer Zecke
Wirbellose Tiere finden sich in allen Lebensräumen der Erde. Sie besetzen viele biologische Nischen und sind in großer Zahl als unabdingbarer Teil in allen Ökosystemen der Erde vertreten. Einzelne Arten haben die Fähigkeit entwickelt, selbst unter extremsten Umweltbedingungen, wie enormem Druck und sehr hohen oder tiefen Temperaturen zu überleben, die für die meisten anderen Lebewesen tödlich wären. Wirbellose wurden in den tiefsten Regionen der Meere als auch den höchsten Bergregionen gefunden. Sie vollführen dafür herausragende Anpassungsleistungen, wobei ihnen ihr oft kurzer Lebenszyklus hilft. Die im Laufe der Evolution von Wirbellosen entwickelten Lösungen für die Anforderungen, die ihre Lebensweisen an sie stellen, sind oft faszinierend und werden vom Menschen, in verschiedenen Bereichen der Technik, immer wieder kopiert.
Wieso haben nicht alle Wirbeltiere vier Gliedmaßen? Lies diesen Informationstext und beantworte dann die Fragen!
Die meisten Fische haben sieben Flossen: Eine Rückenflosse, eine Schwanzflosse, eine Afterflosse sowie paarige Brust- und Bauchflossen. Als vor etwa 400 Millionen Jahren die ersten Vorfahren der heutigen Fische gelegentlich an Land gingen, stützten sie sich mit diesen paarigen Flossen ab. Im Laufe der Zeit entwickelten sich daraus die vier Gliedmaßen der meisten Wirbeltiere.

a) Aus welchen Flossen entwickelten sich die Gliedmaßen? aus den Brust- und Bauchflossen aus der Schwanzflosse aus der Afterflosse
b) Was ist das Besondere an diesen Flossen? sie sind besser durchblutet mit ihnen können Fische atmen sie sind paarweise vorhanden
c) Wieso wurden die Flossen umgebildet? damit sie schneller schwimmen konnten um sich an Land abstützen zu können um beim Fressen Pflanzen festhalten zu können

Abb. 19: Landgang der Wirbeltiere
Ordne die Erklärungen den Fachbegriffen richtig zu, indem du sie mit einem Lineal verbindest!
Körper ohne Kopf und Gliedmaßen
Atmungsorgane von Insekten hornartiger Stoff, aus dem der Insektenpanzer besteht
Jugendstadium eines Insekts
Atmungsorgan von Vögeln besteht aus Gehirn und Rückenmark
Chitin

Rumpf

Larve

Tracheen

Zentralnervensystem

Lunge

Argumentiere, warum wirbellose Tiere an Land nicht so groß werden wie Wirbeltiere im Wasser!
Das kommt meiner Meinung nach daher, dass
Was gehört zu wem? Gib an, ob die Aussagen auf Vögel oder auf Insekten zutreffen! Kreise dazu den passenden Buchstaben ein! Tipp: Die Buchstaben ergeben von unten nach oben gelesen einen Lösungsbegriff, den du im letzten Schuljahr kennengelernt hast und der zu diesem Kapitel passt!
Vögel Insekten
Die Flügel sind umgebildete Gliedmaßen.
F Sie haben ein Zentralnervensystem.
Sie atmen mit Tracheen.
L
A Sie haben ein Außenskelett.
G Sie atmen mit Lungen.
J
Sie haben 6 Gliedmaßen.
Bei Verletzungen kann der Stützapparat heilen.
Z Sie machen meist eine vollkommene Verwandlung durch.
Die Flügel sind zusätzlich zu den Gliedmaßen vorhanden.
G
O Sie haben ein innenliegendes Skelett.
R Sie haben mehrere Nervenknoten.
Sie haben 4 Gliedmaßen.
I Der Stützapparat besteht aus Chitin.


Abb. 20: Bienenfresser
Lösungsbegriff:
Zähle die wichtigsten Unterschiede und Gemeinsamkeiten von Vögeln und von Insekten auf!
Unterschiede
Gemeinsamkeiten
Die meisten Tierarten gehören den wirbellosen Tieren an. Entsprechend vielseitig ist auch die Erforschung und Beobachtung dieser Tiere durch Biologinnen und Biologen. Einerseits untersuchen sie die einzelnen Tiere selbst – also Aufbau und Funktion ihrer Körper, wie sie auf Reize reagieren und wie sie sich ernähren. Techniker nutzen dieses Wissen beispielsweise, um Roboter zu bauen, die Tiere kopieren, Fachleute der Biologie sind an der Entwicklung beteiligt. Andererseits ist es auch spannend, wie die Tiere Informationen austauschen, sich organisieren und welche Rolle sie in ihren Lebensräumen spielen. Dafür beobachten Biologinnen und Biologen sie in der freien Natur und in Experimenten. Insekten an einem Tatort können Hinweise geben, dafür braucht es biologische Fachkräfte, die das entsprechende Wissen haben. Wirbellose sind wesentlich für die Bodenqualität, also können Biologinnen und Biologen beratend unterstützen.


Taufliegenfalle! Du kennst sie sicher, die kleinen Fliegen, die oft um altes Obst herumschwirren. Im Alltag werden sie meist Frucht- oder Obstfliegen genannt. Ihre eigentliche Bezeichnung ist Taufliege oder Drosophilidae. Unter Biologen ist eine bestimmte Unterart sowas wie ein Star, da sie einer der am besten untersuchten Organismen der Welt ist.
Du brauchst: Ein größeres Glas % ein Blatt Papier % Klebeband % Obst- und Gemüsereste.
Baue eine Falle!

Lege die Obst- und Gemüsereste in das Glas! Rolle aus dem Papier einen Trichter und fixiere ihn mit dem Klebeband! Der Trichter sollte so geformt sein, dass seine untere Öffnung recht schmal ist, er bis über die Hälfte ins Glas hinein reicht und die Öffnung des Glases voll ausfüllt.
Sobald du einige Fliegen gefangen hast, beginne mit deinen Beobachtungen!
Welche Nahrung bevorzugen die Fliegen? Kannst du erklären weshalb?
Kannst du erkennen, ab wann es Fliegen mit dicken Bäuchen gibt? Sie tragen Eier.
Nach welcher Zeitspanne kannst du die ersten Larven beobachten?
Nach welcher Zeit die ersten Puppen? Sie sind länglich, braun und starr.
Achte darauf, dass deine Fliegenkolonie genug Nahrung hat!
Für besonders gute Beobachter:
Kannst du erkennen, wenn sich Fliegen paaren? Beschreibe den Vorgang!
Betrachte deine Kolonie unter der Lupe und notiere Details!
Wenn du stark zuckerhaltiges Obst als Nahrung verwendest und es nicht zu trocken ist, gärt das Obst. Es bildet sich Alkohol, den die Fliegen zu sich nehmen. Sie reagieren dann sehr träge und plumpsen herunter, wenn du das Glas bewegst.



Entlasse die Fliegen in die Freiheit, wenn du mit deinen Beobachtungen fertig bist!


So schätze ich mich nach dem Großkapitel WIRBELLOSE LANDLEBENDE TIERE selbst ein: Kreuze jenen Daumen an, der für dich am ehesten zutreffend ist!
Ich kann…
…erklären, was wirbellose Tiere sind.
…einige Stämme der wirbellosen Tiere aufzählen.
…den Aufbau des Regenwurms in Hinsicht auf seine Lebensweise analysieren und Zusammenhänge mittels Versuchen aufzeigen.
…die Bedeutung des Regenwurms in seinem Lebensraum erklären.
…beschreiben, wie sich Schnecken fortbewegen.
…den Körperbau von Schnecken wiedergeben.
…das Verhalten einer Weinschnecke unter verschiedenen, bewusst herbeigeführten, Bedingungen beobachten und dokumentieren.
…die Eigenschaften von Insekten erklären.
…wiedergeben, wie Insekten aufgebaut sind.
…die vollständige und unvollständige Verwandlung vergleichen und unterscheiden.
…erklären, wie Insektenstaaten gegliedert sind.
…die Bedeutung von Bienen für die Ökologie der Blütenpflanzen beurteilen.
…die ökologische Bedeutung der Ameisen erklären.
…die Besonderheiten von Schmetterlingen und ihre Verwandlung beschreiben.
…Insekten und Spinnentiere vergleichen und unterscheiden.
…die ökologische Bedeutung der Spinnen erkennen.
…die Gefahr beschreiben, die von Zeckenbissen ausgehen kann.
…über landlebende Gliederfüßer wie Skorpione, Tausendfüßer oder Asseln sprechen.
…Unterschiede von Vögeln und Insekten erklären.
Um deine Kompetenzen noch mehr zu steigern, hier unsere Buchtipps:
Michael Laumann, Christian Schmitt, Max Fiedler: Die coolsten und giftigsten Krabbeltiere der Welt (Ravensburger Verlag, 2015).
Rainar Nitzsche, Elke Bouché, Bastian Rast: Spinnen lieben lernen: Biologie – Heimische Arten –Rekorde (Nitzsche R., 2013).







Die Bezeichnung „Herbarium“ stammt vom lateinischen Wort Herba für Kraut. Wenn du ein Herbarium erstellst, legst du eine Sammlung von gepressten und getrockneten Pflanzen an, die aufgeklebt und beschriftet werden. Bei der Sammlung und Gestaltung brauchst du Geduld und Fingerfertigkeit. Mit unseren Tipps gelingt es dir sicher!
Du brauchst: gesammelte Pflanzen % Lösch- oder Backpapier % Zeitungspapier % Pappkarton % dicke Bücher % Schere % selbstklebende Etiketten % Locher % Bindfaden oder einen Hefter % Bestimmungsbuch % Frischhaltebeutel
1. SCHRITT: sammeln und bestimmen
Bevor du die Pflanze pflückst, stelle mit dem Bestimmungsbuch ihren Namen fest! So vermeidest du, dass du aus Versehen eine geschützte Pflanze pflückst.
Transportiere deine Pflanzen getrennt in Frischhaltebeuteln. Gib auch jeweils einen Zettel hinein, auf dem du den Artnamen, den Fundort und das Funddatum vermerkst!
2. SCHRITT: pressen und trocknen

Lege die Pflanze im Ganzen auf ein Stück Backpapier oder Löschpapier und bedecke sie dann mit einem zweiten Stück!
Staple sie abwechselnd mit Zwischenlagen aus mehreren Bögen Zeitungspapier. Lege oben und unten einen starken Pappkarton auf den Stapel und beschwere ihn mit dicken Büchern!
Füge ein Etikett dazu, auf dem der Artname der Pflanze, die Familie, der Fundort und das Funddatum vermerkt sind!
Warte ca. 1 Woche, dann sollte die Pflanze vollkommen trocken sein!
3. SCHRITT: Pflanzen einkleben
D D
Fülle das Deckblatt aus und beschrifte auch zuerst die Pflanzenseiten (Vorlagen im Anhang), bevor du die Pflanzen einklebst! Klebe die trockenen Pflanzen vorsichtig auf ein etwas festeres Papier (eventuell Zeichenpapier)! Verwende dazu Streifen, die du aus den selbstklebenden Etiketten hergestellt hast!
4. SCHRITT: Herbarium zusammenfügen
5 D
Füge zum Schluss das Deckblatt und die von dir gefertigten Seiten zusammen. Dazu musst du jede Seite mittig lochen und dann mit einem Bindfaden zusammenbinden! Fertig ist dein Herbarium!
Prüfe die Fotos! Was stimmt hier nicht?











Mein Herbarium Pflanzensammlung

Spore, die: einzellige Fortpflanzungseinheiten von niederen Lebewesen wie Bakterien, Pilzen, Algen, Moosen oder Farnen. Sie dienen der Ausbreitung.
Beobachte Pflanzen, die du in deiner Umgebung und in der Natur findest. Analysiere ihren Standort und dessen Bedingungen. Vergleiche dies mit der Art, wie die Pflanze gewachsen ist. Leite Zusammenhänge her. Könnten Pflanzen, die sich nicht verzweigen, genauso flexibel damit umgehen?
Begründe, weshalb es für Pflanzen von Vorteil sein kann, wenn sie hoch wachsen! Gibt es auch Nachteile?
Gewebe, das: Ansammlung spezialisierter Zellen, die gemeinsam eine bestimmte Aufgabe erfüllen.
Mark, das: weiches Zellgewebe im Inneren des Stängels.

Abb. 3: Samen des Fenchels (hell) und der Sonnenblume (dunkel)

Pflanzen blicken auf eine sehr lange Entwicklungsgeschichte zurück. Die heutige Vielfalt der Landpflanzen hat sich über viele Millionen Jahre aus einfachen Grünalgen entwickelt. Form und Bestandteile der Pflanzen haben sich dabei beständig an neue Gegebenheiten und Herausforderungen angepasst. Das Leben an Land bietet Pflanzen einige Vorteile. Sonnenstrahlen werden nicht durch Wasser abgeschwächt, die Luft der Atmosphäre liefert mehr Kohlendioxid als Wasser und die Böden sind reich an Nährstoffen. Dafür ist Wasser vergleichsweise knapp und Luft kann größere Pflanzen nicht so wie Wasser stützen.

Gefäßpflanzen
Blütenpflanzen
Die ersten Landpflanzen waren Moose Moose sind vergleichsweise einfach aufgebaut. Sie bringen keine Blätter hervor und anstelle von Wurzeln haben sie feine fadenförmige Gebilde. Zur Verbreitung nutzen Moose Sporen, die von Wind oder Wasser transportiert werden.
Abb. 4: Äpfel sind Früchte, die ihre Samen umhüllen.
Abb. 1: Evolution der Landpflanzen
Ein wichtiger evolutionärer Fortschritt war die Fähigkeit von Pflanzen, sich zu verzweigen sowie große und hochwüchsige Pflanzenkörper auszubilden. Dazu brauchten sie ein System aus Gefäßen, die, ähnlich den Blutgefäßen bei Tieren, Nährstoffe und Wasser zu allen Teilen der Pflanze transportieren konnten. Zur Stützung der Gefäße und Pflanze braucht es stabile Strukturen, die durch verholztes Gewebe entstehen. Auch im Boden sind durch Verholzung stabilere Gefäße ein Vorteil. Sie können tiefer in den Boden vordringen, um Wasser und Nährstoffe aufzunehmen und die Pflanze gleichzeitig im Boden verankern. So entwickelten sich Wurzeln. Die so entstandenen Gefäßpflanzen brachten auch eine weitere Neuerung hervor, Blätter.
Ein bedeutender Evolutionsschritt war die Entwicklung von Samen. Sporen sind Umwelteinflüssen gegenüber recht empfindlich. Samen verfügen über eine schützende Schale. Sie beinhalten Nährgewebe, das die neue Pflanze am Anfang ihres Wachstums versorgt. Eingebettet in den Samen ist ein Pflanzenembryo, der bereit ist, unter den richtigen Bedingungen zu keimen. Einige der Samenpflanzen haben Blüten und Früchte , in die die Samen eingebettet sind, entwickelt. Früchte sind für Tiere schmackhaft, so dass sie durch deren Verzehr und die Ausscheidung der Samen die Verbreitung der Pflanze übernehmen.
Abb. 2: Querschnitt des Stängels
Hülle
Gefäße Mark


Blätter
Wurzeln Sprossachse
Im Allgemeinen bestehen Blütenpflanzen aus den vier Abschnitten Wurzeln, Sprossachse, Blätter und Blüte. Jeder dieser Abschnitte hat ganz spezielle Aufgaben. Die einzelnen Abschnitte können sehr unterschiedlich ausgeformt sein, um den Lebensanforderungen einer Pflanze zu genügen. Trotzdem entstammen sie denselben Prinzipien und Ursprüngen.
Die Wurzeln: Aufnahme und Verankerung
Wurzeln bilden die Verbindung einer Pflanze zum Lebensraum Boden. Allen Wurzeln gemein ist die Erfüllung zweier wesentlicher Aufgaben:
1. Sie halten die Pflanze im Boden fest. Je größer die Pflanze wird, desto tiefer wachsen die Wurzeln in den Boden. So können selbst hohe Pflanzen wie Bäume auch bei Sturm nicht umfallen.
2. Sie nehmen Wasser und Mineralsalze aus dem Boden auf. Diese Stoffe benötigt die Pflanze zum Wachsen und um ihre Lebensvorgänge aufrecht zu halten. Von den Hauptwurzeln zweigen kleinere Wurzeln ab, die schließlich in feinen Wurzelhaaren auslaufen. In ihnen erfolgt die eigentliche Aufnahme. Die verzweigte Form der Wurzeln erlaubt es einen größeren Teil des umliegenden Bodens zu durchdringen.
Zwischen Wurzeln und Sprossachse: Speicherorgane
Manche Pflanzen bilden besondere Organe aus, in denen Nährstoffe gespeichert werden. Die Reserven benötigt die Pflanze, um nach dem Winter wieder neue Triebe bilden zu können.

Echte Schlüsselblume: Erdspross
Wiederhole den Aufbau von Pflanzen (1. Klasse)!
Spross, der: neu entwickelter Teil einer Pflanze
Grabe ein Grasbüschel aus! Befreie dann die Wurzeln vorsichtig von Erde! Wie sieht die Form aus? Vergleiche das mit einer Karotte, oder Zwiebel! Für welche Bedingungen haben sich Graswurzeln entwickelt?
Hat es Folgen, dass moderne Nutzpflanzen Wurzeln ausbilden, die weniger tief in den Boden ragen? Besprich deine Gedanken mit deinem Sitznachbarn!


Abb. 6: unterschiedliche Speicherorgane

Speicherorgane wachsen meist unterirdisch und können entweder von den Wurzeln oder von der Sprossachse gebildet werden. Knollen, die von der Wurzel gebildet werden, findet man beispielsweise bei Yams oder Maniok, die vor allem in den Tropen Südamerikas als Nahrungsmittel angebaut werden. Auch Rüben sind aus Wurzeln entstanden. Sie sind die verdickte Hauptwurzel mancher Pflanzen.
Trieb, der: andere Bezeichnung für Spross
Erkläre, bei welchen Pflanzen die Speicherorgane im Boden besonders wichtig sind! Denke dabei an Pflanzen, die erst im Frühling in Erscheinung treten!


Abb. 10: Die Kartoffel –eine Knolle: Sie bildet sich nicht aus einer Wurzel, sondern aus Ausläufern am unteren Ende der Sprossachse.
Analysiere, wie die Zwiebel aufgebaut ist! Zerteile vorsichtig eine Zwiebel und beschreibe, was du dabei siehst!
Gehe in einem Supermarkt in die Gemüseabteilung!
Wie viele Gemüsesorten findest du, die Speicherorgane von Pflanzen sind?


Die meisten Speicherorgane sind aus dem untersten Teil der Sprossachse entstanden. Zwiebeln werden zum Großteil aus umgewandelten verdickten Blättern rund um den untersten Teil des Stängels gebildet, die Nährstoffe speichern. Die äußere Zwiebelschale ist eine trockene Schutzhaut. Sie umschließt die Zwiebelblätter. Damit sie nicht von Tieren gefressen werden, schmecken die Zwiebelblätter scharf. Das sichert der Pflanze das Überleben.
Brutzwiebel
Stängel

Zwiebelschale Zwiebelblätter Ersatzzwiebel Zwiebelkuchen Wurzeln
Abb. 9: Aufbau der Zwiebel
Wenn die Pflanze wächst und blüht, verbraucht sie die in den Zwiebelblättern gespeicherten Nährstoffe. Die Zwiebel wird dadurch immer kleiner. Erst wenn die Laubblätter der Pflanze Nährstoffe herstellen, wächst die Ersatzzwiebel zu einer großen Zwiebel heran. Diese ist gefüllt mit Nährstoffen für das nächste Jahr. Viele Frühblüher nutzen Speicherorgane, um schon früh im Jahr austreiben zu können. Schneeglöckchen und Gelbe Narzisse haben Zwiebel. Krokusse bilden Knollen aus. Leberblümchen haben Überdauerknospen. Andere Frühblüher wie Primeln kommen ohne Speicherorgane aus.
Auch Brutzwiebeln werden zwischen den Zwiebelblättern gebildet. Sie lösen sich von der Hauptzwiebel ab und bilden neue Pflanzen. So können sich Pflanzen ohne Samen vermehren. Man spricht von ungeschlechtlicher Vermehrung. Die in den Speicherorganen von Pflanzen enthaltenen Nährstoffe nutzen auch die Menschen seit vielen Jahrtausenden. In Abb. 7 siehst du einige davon:
1 Karotte – Rübe | 2 Rettich – Rübe
Transport von Wasser
Transport von Nährstoffen

Abb. 13: Rüben und Knollen, die der Mensch nutzt

3 Kohlrabi – Sprossknolle | 4 Zuckerrübe – Rübe
5 Futterrübe – Rübe | 6 Rote Rübe – Rübe
7 Kartoffel – Sprossknolle
Die Hauptaufgabe der Sprossachse ist die Verbindung zwischen den Wurzeln und den Blättern. In ihr verlaufen die Leitbündel, in denen von den Wurzeln Wasser und Mineralsalze zu den Blättern gelangen. In die Gegenrichtung werden Nährstoffe transportiert, die in den Blättern gebildet werden. Sie halten die Wurzeln am Leben. In den Wurzeln dienen sie außerdem zur Bildung von neuem Wurzelgewebe.

Abb. 14: Leitbündel eines Farns unter dem Mikroskop
In der Sprossachse der meisten Pflanzen gibt es Zellen mit verdickten Wänden, welche die Pflanze stützen. Bei manchen Pflanzen ist in den Zellwänden Holz eingelagert. Dadurch können sie höher wachsen und sind widerstandsfähiger.





Der Stamm eines Baumes weist einen besonderen Aufbau auf:
A. Das KERNHOLZ ist der innerste Teil des Stammes. Es besteht aus abgestorbenem Holz und ist sehr hart. Das Kernholz macht den Baumstamm fest und widerstandsfähig.
†
Abb. 15: Betrachte den Querschnitt durch den Baumstamm und wende dein Wissen um den Borkenkäfer an! Stelle eine Vermutung auf, wo der Käfer Fraßgänge anlegen kann!
Welche Schädigungen erleidet der Baum dadurch?







B. Im SPLINTHOLZ, das aus noch lebenden Zellen besteht, werden Wasser und Mineralsalze von den Wurzeln in alle Teile des Baumes geleitet. Hier werden auch Zucker und Stärke gespeichert.
C. Die MARKSTRAHLEN verlaufen von innen nach außen und versorgen den Stamm mit Wasser und Nährstoffen.
D. Das KAMBIUM ist die Wachstumsschicht des Baumstammes. Nach innen bildet es jedes Jahr einen neuen Ring Splintholz. So nimmt der Stamm an Dicke und Stärke zu. Nach außen bildet das Kambium den Bast.
E. Der BAST ist die innere Schicht der Rinde. In dieser Schicht werden die in den Blättern gebildeten Nährstoffe in alle Teile des Baumes und damit auch in die Wurzeln geleitet.
F. Die BORKE ist die äußere, abgestorbene Schicht der Rinde. Sie schützt den Baum vor Sonne, Regen und Schädlingen.
Wie Pflanzen wachsen
Pflanzen wachsen, indem die Zellen sich teilen. Das geschieht vor allem an den Spitzen der Sprosse.
Wie du beim Baumstamm gehört hast, wachsen Pflanzen aber auch in die Dicke. Dieses Wachstum geht von einer kreisförmigen Wachstumsschicht aus, dem Kambium. Es bildet nach außen und nach innen neue Zellen. Da das Zellwachstum je nach Jahreszeit unterschiedlich ist, entstehen die typischen Jahresringe in Baumstämmen. Die Breite der Jahresringe hängt von den klimatischen Bedingungen eines Jahres ab. Bäume sind also Klimaarchive.


Die Rolle von Bildungsgewebe beim Wachsen
Bei Pflanzen bildet ein spezieller Gewebetyp neue Zellen. Diese Zellen sitzen an den Spitzen der Sprosse und der Wurzeln. Dadurch können sie in die Länge wachsen. Solches Gewebe findet sich aber auch an vielen anderen Stellen einer Pflanze. Sie kann dann an diesen Stellen neue Sprosse, Blätter oder Blüten bilden.

Abb. 16: Wachstum der Erbsenpflanze
Abb. 16: Betrachte die wachsende Erbsenpflanze und gib an, an welchen Stellen Bildungsgewebe für das Wachstum von seitlichen Sprossen oder Blättern sorgt!


Bildungsgewebe: für Spezialistinnen und Spezialisten
Der wissenschaftliche Name für Bildungsgewebe ist Meristem. Auch die Kambiumschicht des Baumstamms ist so ein Meristem.
Gib an, welche Funktion Pflanzen im Stoffkreislauf einnehmen!
Wiederhole den Stoffkreislauf!
Abb. 17: Beschreibe den Vorgang der Fotosynthese!


Fotosynthese und Fotovoltaik
Pflanzen können bei der Fotosynthese etwa 1% der Sonnenergie nutzen. Fotovoltaikanlagen wandeln ca. 20% der Sonnenenergie in elektrischen Strom um.

Abb. 18: Auch die Fotovoltaik nutzt die Energie der Sonne.
Vergleiche die Atmung eines Blattes mit der eines Tieres! Was ist ähnlich, wo gibt es Unterschiede?
Informiere dich über „erneuerbare Energie“! Wo überall steckt die Energie der Sonne dahinter?
Alle grünen Teile und besonders die Blätter von Pflanzen enthalten Blattgrün, das Chlorophyll. Mit Hilfe dieses grünen Farbstoffes können sie die Energie des Sonnenlichtes zur Herstellung von Nährstoffen nützen.
Pflanzen benötigen dazu Licht und Kohlenstoffdioxid aus der Luft sowie Wasser und Mineralsalze. Daraus wird Zucker hergestellt, der später in Stärke umgewandelt und als solche gespeichert wird.
SONNENLICHT
Verfasse eine kurze Zusammenfassung, in der du die Vor- und Nachteile der erneuerbaren Energie anführst!
Spaltöffnung, die: verschließbare Öffnungen, meist an der Blattunterseite
+ 6 O2 Kohlendioxid aus der Luft
CO2 + 6 H2O
aus dem Boden

Abb. 17: Fotosynthese
Den Vorgang, bei dem Pflanzen ihre Nährstoffe herstellen, nennt man Fotosynthese. Dabei wandeln sie Licht, Wasser (H2O) und Kohlendioxid (CO2) in Glucose (Zucker) und Sauerstoff (O2) um. Nur Pflanzen sind in der Lage, Fotosynthese zu betreiben. Die meisten anderen Lebewesen benötigen grüne Pflanzen als Grundlage ihrer Ernährung. Sie könnten ohne sie nicht überleben.
Bei der Fotosynthese geben alle Pflanzen Sauerstoff (O2) ab. Sie erzeugen den Sauerstoff, den die Pflanzen, wir Menschen, Tiere, Pilze usw. zum Atmen brauchen.
Alle Pflanzen atmen, um leben zu können. Das geschieht durch die Spaltöffnungen der Blätter. Durch diese gelangt Sauerstoff in das Blatt und Kohlenstoffdioxid (CO2) wird abgegeben. Die Laubblätter erzeugen bei der Fotosynthese aber viel mehr Sauerstoff, als sie bei der Atmung verbrauchen.
Durch die Spaltöffnungen verdunstet das Blatt Wasser (H2O). Je stärker die Sonne scheint und je wärmer es ist, desto mehr Wasserdampf gibt das Blatt ab. Es kühlt dadurch seine Oberfläche

Abb. 19: Atmung eines Blattes

Abb. 20: Verdunstung
Fruchtknoten
Samenanlagen
Staubblatt
Griffel
Narbe
Blütenblätter

Die Blüte von Blütenpflanzen und ihre Funktion hast du bereits in der 1. Klasse kennengelernt. In Abbildung 15 siehts du die Blüte eines Schneeglöckchens und deren Bestandteile.
Diese sind aus Blättern der Pflanze entstanden. Deshalb spricht man auch von „Blütenhülle“, „Staubblättern“ und „Fruchtblättern“. Die Staubblätter sind die männlichen Geschlechtsorgane der Pflanze, die Fruchtblätter die weiblichen
Die Fruchtblätter untergliedern sich in Narbe, Griffel sowie Fruchtknoten mit den Samenanlagen. Gemeinsam bilden sie den Stempel. Abb. 21: Blüte eines Schneeglöckchens Bestäubung und Befruchtung
Der Blütenstaub wird meist durch Insekten oder den Wind transportiert. So gelangt er auf die Narbe der Blüte. Dieser Vorgang ist die Bestäubung. Danach wächst aus dem Pollenkorn ein Schlauch bis zur Eizelle im Fruchtknoten. Am Ende des Pollenschlauchs befindet sich eine Spermienzelle, die bei der Befruchtung mit der Eizelle verschmilzt
Der Fruchtknoten wird bei vielen Pflanzen zur Frucht, aus den Samenanlagen entstehen die Samen. Aus ihnen können neue Pflanzen entstehen.
Der Samen – ein
„Speicherorgan“: Der Kreis schließt sich
Wenn du Abb. 18 betrachtest, siehst du die Entwicklung einer Bohnenpflanze aus einer Bohne sowie einer Kartoffelpflanze aus einer Kartoffel. Beide Vorgänge sehen ähnlich aus, sind aber doch sehr verschieden.




Bei der Bohnenpflanze wird die Blüte befruchtet. Dann entwickelt sich aus der Samenanlage ein Samen, die Bohne. Sie ist also aus dem Verschmelzen der Geschlechtszellen von zwei Pflanzen entstanden. Man spricht von „geschlechtlicher Vermehrung“. Die Nährstoffe in der Bohne dienen der neuen Bohnenpflanze als Nahrung, bis sie selbst welche erzeugen kann.
Bei der Kartoffelpflanze ist die Kartoffel ein unterirdisches Speicherorgan, das aus der Sprossachse einer einzelnen Pflanze entsteht und das Nährstoffe enthält. Aus ihr wächst eine neue Pflanze, die während des Wachstums mit den Nährstoffen versorgt wird. Man spricht von „ungeschlechtlicher Vermehrung“.

Pollenschlauch
Samenanlage
Fruchtknoten

Abb. 23: Stempel
Kennst du noch andere Lebewesen, die sich mit Hilfe einer Eizelle und einer Samenzelle fortpflanzen? Gibt es bei der Kartoffelpflanze auch noch eine andere Form der Vermehrung? Informiere dich!
Welche Vorteile und welche Nachteile haben Pflanzen bei der ungeschlechtlichen Vermehrung?
Was ist für sie günstiger? Bilde dir dazu eine Meinung und begründe sie!
Ist das Prinzip Eizelle und Spermienzelle ein pflanzliches oder ein allgemeines?
Welche Vorteile könnte geschlechtliche Fortpflanzung in Bezug auf Selektion und Entwicklung haben?
Entwicklung einer Kartoffelpflanze: Verfasse einen kurzen Informationstext zu dieser Abbildung in deinem Heft!

Familie Schober hat Kartoffeln gepflanzt. Ihre Tochter Ulli hat über ihr Wachsen Protokoll geführt. Es ist aber einiges durcheinandergekommen: Ordne die einzelnen Schritte der Reihe nach, indem du die Zahlen von 1 bis 4 einsetzt.
Bald treiben aus der Saatkartoffel - Mutterknolle im Boden helle, weiße Sprosse aus. An den Sprossen bilden sich nach oben ein Trieb und nach unten die Wurzeln.
Im Frühjahr werden auf den Äckern die Knollen der Kartoffel in flache Furchen gelegt und lockere Erde darüber gehäufelt.
An den Enden der Sprosse entstehen im Sommer Knollen, die neuen Kartoffeln. Diese werden im Herbst geerntet.
Später wachsen Triebe nach oben an die Erdoberfläche. Dort bilden sie grüne Stängel und Blätter sowie später auch Blüten, die weiß oder blau blühen.

Bei der Fotosynthese geben die grünen Teile der Pflanze Sauerstoff ab. Beschrifte die Abbildung!
















In der Natur erfüllen die einzelnen Teile der Pflanze verschiedene Aufgaben. Verbinde mit dem Lineal!
FRUCHT

BLATT

STÄNGEL

KNOLLE

WURZEL

6
nimmt Wasser und Nährstoffe aus dem Boden auf

stützt die Pflanze und leitet Wasser und Nährstoffe


stellt durch Fotosynthese Nahrung her dient der Fortpflanzung

speichert Reservestoffe

An den Jahresringen eines Baumstamms kann man das Alter des Baumes ablesen. Aber woher kommt die unterschiedliche Breite der Jahresringe? Kreuze die drei richtigen Antworten an!





Trockenheit
Licht und Schatten
Waldbesucher
Fütterung der Waldtiere
Insektenbefall

Aufgaben von Pflanzenorganen – Schreibe die Begriffe unter die passenden Pflanzenteile!
Verankerung © Fotosynthese © Pollen © Fruchtknoten © Stütze © Nährstoffherstellung © Wasserverdunstung © Fortpflanzung © Nährstofftransport © Sauerstoffabgabe © Wasseraufnahme
Wurzel Stängel



Blatt Blüte


Mit einigen einfachen Versuchen kannst du das Pflanzenwachstum beobachten und untersuchen.

Versuch: Messen des Pflanzenwachstums
Du brauchst: Samen einer Bohne % Glas % feuchte Erde % Filzstift (muss auf Glas schreiben) % Lineal
Fülle das Glas mit feuchter Erde! Stecke dann die Bohne seitlich in das Glas, sodass du sie durch das Glas sehen kannst!
Stelle das Glas an eine warme und helle Stelle! Achte auch darauf, dass die Erde feucht bleibt!
Sobald die Bohne zu wachsen beginnt, miss täglich die Länge des Stängels sowie der Wurzel! Durch Markierungen am Glas kannst du direkt vergleichen und genauer beobachten, wie sich die Wurzeln ausbreiten. Führe auch ein Protokoll, in dem du die täglichen Messungen einträgst!
Halte die Lichtverhältnisse im Raum fest. Wohin wendet sich der Spross? Formuliere eine Vermutung! Notiere deine Beobachtungen!
Beschreibe zum Schluss das Längenwachstum der Bohne!

Experiment: Pflanzen und Lichtquellen.

Du brauchst: kleiner Blumentopf mit gekeimter Bohne x2 % Schachtel aus Karton % Schere % Karton % Klebeband
Nach dem vorherigen Versuch kannst du vermuten, dass Sprossen dorthin wachsen, wo es hell ist. Notiere eine passende experimentelle Fragestellung zu dieser Vermutung und schreibe sie auf!
Folgender Versuch soll dir nun helfen, die Fragestellung zu beantworten.
DURCHFÜHRUNG A:
Schneide seitlich ein Loch in den Schuhkarton!
Schneide auch zwei Kartonstücke zu und klebe sie so in den Karton, wie es in der Abbildung zu sehen ist!
Stelle den Blumentopf mit der gekeimten Bohne in die Ecke des Kartons und markiere die Stelle!
Dann schließe den Karton und stelle ihn an einen hellen warmen Platz! Achte darauf, dass Licht durch das Loch fallen kann! Achte auch darauf, dass die Erde feucht bleibt!

Beschreibe nach einer Woche, wie die Bohne gewachsen ist und notiere deine Resultate.
Um unsere Vermutung auch tatsächlich zu überprüfen, verändern wir nun die Bedingungen für den Versuch.
DURCHFÜHRUNG B:
Klebe das Loch im Karton lichtdicht zu! Schneide ein neues Loch in eine andere Seite des Kartons! Positioniere auch die zwei Kartonstücke neu!
Stelle einen neuen Blumentopf mit einer zweiten gekeimten Bohne an die gleiche Stelle im Karton wie den ersten. Tipp: Du kannst auch gleich am Anfang zwei Kartons und zwei Pflanzen verwenden.
Beschreibe und notiere nach einer Woche, wie die Bohne gewachsen ist. Hat sich die Vermutung bestätigt? Welche Schlüsse kannst du daraus ziehen? Formuliere eine zusammenfassende Aussage über das Wachstum von Pflanzen und Lichtquellen!
Du hast schon gelernt, dass Pflanzen Wasserdampf durch Spaltöffnungen abgeben, um ihren Wasserhaushalt zu regeln und sich zu kühlen. Wie lässt sich überprüfen, ob Pflanzen tatsächlich Wasser verdunsten? Hier findest du einen geeigneten Versuchsaufbau zu dieser Frage.
Du brauchst: Plastikbeutel % Bohnenpflanze % Lampe
Verschließe die Laubblätter einer Bohnenpflanze luftdicht mit einem Plastikbeutel!
Dann bestrahle die Blätter der Pflanze mit einer Lampe!
Was ist zu sehen?
Erkläre, warum sich der Plastikbeutel beschlagen hat!


Lies dir die folgenden kurzen Infotexte durch!

Damit Menschen sich wohlfühlen, sollte die Luftfeuchtigkeit in ihrer Umgebung nicht zu gering sein. Eine zu geringe Luftfeuchtigkeit kann auch negative gesundheitliche Auswirkungen haben.

Die Hauptursache für niedrige Luftfeuchtigkeit in Räumen während des Winters ist Heizen und falsches Lüften. In beheizten Räumen kann die Luftfeuchtigkeit unter den empfohlenen Wert fallen.
Kombiniere die Information in den Texten mit deinem Versuchsergebnis. Leite daraus Schlussfolgerungen und Handlungsmöglichkeiten ab!
Formuliere eine Handlungsanweisung für den Umgang mit Pflanzen in der Heizsaison! Begründe die Anweisung!
Erstelle Protokolle zu deinen Untersuchungen! Besprecht eure Ergebnisse in der Klasse!


Was ist fossile Energie? Im organischen Material von Lebewesen ist Sonnenenergie gespeichert. Kohle, Erdöl oder Erdgas sind die Überreste von Lebewesen, die vor vielen Millionen Jahren lebten. In ihnen ist die Sonnenenergie gespeichert, die vor langer Zeit aufgenommen wurde. Diese Energie bezeichnet man als „fossile Energie“.
Fossil, das: Überreste eines Lebewesens, das vor langer Zeit lebte
Körpergewebe, das: Teil des Körpers oder eines Organs
Erörtere, was bei der Nutzung von fossiler Energie noch freigesetzt wird! Wie hängt diese Nutzung mit dem Klimawandel zusammen? Informiere dich!
Wie würde es sich auf die benötigte Energiemenge zur Herstellung unserer Nahrung auswirken, wenn möglichst viele Menschen nur mehr Lebewesen aus der untersten Stufe der Nahrungspyramide essen würden? Diskutiert in Kleingruppen! Welche Folgen könnt ihr ermitteln?
Bei der Fotosynthese wird etwa 1 % der einfallenden Sonnenenergie genutzt, um daraus Nährstoffe herzustellen. Dabei entsteht zunächst Zucker, der dann zu anderen Kohlenhydraten umgewandelt wird. In manchen Pflanzen werden auch Eiweiße oder Fette erzeugt.
In den Blättern von Bäumen, in den Gräsern und Blumen einer Wiese oder in den Früchten und Samen ist also Sonnenenergie gespeichert
Betrachte Abb. 1! Konsumenten 1. Ordnung benötigen Pflanzen, damit sie wachsen können. Erkläre, wie das beim erwachsenen Tier aussieht! Wozu braucht dieses die Pflanzennahrung?
Beim Fressen nimmt ein Pflanzenfresser Teile der Pflanze auf und verdaut sie. Dabei kann er die gespeicherte Energie nutzen, um sich zu bewegen, seinen Körper zu wärmen oder neues Körpergewebe aufzubauen. Vor allem beim Heranwachsen benötigen Tiere viel Nahrung, um an Körpergewicht zuzulegen.
Allerdings kann der Pflanzenfresser nur einen Bruchteil der Energie nutzen, die in der Pflanze gespeichert ist. Etwa 10 % stehen ihm zur Verfügung, der Rest geht in Form von Wärme verloren. Somit kann der Pflanzenfresser etwa ein Zehntel der aufgenommenen Energie in seinem eigenen Körper speichern.
Wird der Pflanzenfresser von einem Fleischfresser gefressen, wird ebenfalls nur etwa ein Zehntel dieser Energie genutzt und der Großteil geht in Form von Wärme verloren. In jeder Stufe einer Nahrungskette können also nur etwa 10 % der vorhandenen Energie genutzt werden.
Wärme

Abb. 1: Nahrungspyramide in einem Wald
Abb. 1 zeigt auf, dass die Anzahl an Tieren immer geringer wird, je weiter man zur Spitze kommt. Änderungen des Nahrungsangebots auf einer Stufe wirken sich auf alle darüber liegenden Stufen aus. Tiere an der Spitze sind davon abhängig, dass die Nahrungspyramide durchgehend intakt ist.
Ein Pflanzenfresser, beispielsweise ein Reh, braucht zum Überleben pflanzliche Nahrung. Damit das Reh auf Dauer leben kann, muss zumindest so viel Pflanzenmaterial nachwachsen, wie das Reh frisst. Daher braucht jedes einzelne Reh eine bestimmte Fläche. Da das Reh jedoch nicht allein in seinem Lebensraum ist und auch noch andere Pflanzenfresser satt werden müssen, ist diese Fläche ziemlich groß. Jedes Reh braucht eine Fläche von ca. 50 ha zum Überleben. Konkurrenz um Nahrung beschränkt also die Menge an Tieren einer Art, die in einem Gebiet überleben können.


Wölfe sind Räuber und überwiegend Fleischfresser. Sie ernähren sich unter anderem auch von Rehen. Es muss in dem Gebiet, in dem ein Wolf lebt, also genug Rehe geben, damit er satt wird und seine Jungen aufziehen kann. Die Fläche, die jeder einzelne Wolf braucht, beträgt etwa 25 km².
Abb. 3: Wolf mit seiner Beute
In einem Gebiet von dieser Größe können etwa 50 Rehe leben, aber nur ein Wolf. Da Wölfe Rudeltiere sind und daher in größeren Gruppen zusammenleben, muss das Revier eines Wolfsrudels hunderte km² groß sein, damit das Rudel überleben und die Jungen großziehen kann.
Auch zwischen Fleischfressern gelten Konkurrenzverhältnisse. Zusätzlich wirken Konkurrenten ihrer Beutetiere auf sie. Gibt es weniger Rehe, da Konkurrenten wie Wildschweine oder Hasen ihnen Nahrung streitig machen, können auch weniger Wölfe von den Rehen leben. Fressfeinde der Konkurrenten der Rehe wirken sich dann positiv auf die Wölfe aus. Fressen die Wölfe hingegen auch die Nahrungskonkurrenten der Rehe, erschließen sich ihnen neue Nahrungsquellen und sie werden weniger abhängig von den Rehen. Fressfeinde der Nahrungskonkurrenten sind dann allerdings Konkurrenten der Wölfe. Es entstehen vielfältige Nahrungsbeziehungen, die einander beeinflussen.
Die Reviergröße bestimmt die Population
Wenn sich die Umweltbedingungen ändern, ändert sich meist auch das Nahrungsangebot in einem Gebiet. Fällt zu wenig Regen, dann gibt es zu wenig Nahrung für die Pflanzenfresser. Jedes einzelne Tier benötigt dann ein größeres Gebiet, um satt zu werden. Gibt es keine Möglichkeit, in ein Gebiet auszuweichen, in dem noch keine Rehe leben, werden manche Tiere verhungern und die Population nimmt ab Geht die Anzahl an Rehen zurück, wird auch die Anzahl an Wölfen sinken.
Erkläre, wie groß 50 ha sind! Welche Seitenlängen hätte ein Rechteck mit dieser Fläche?
Revier, das: Gebiet, das jemand für sich beansprucht Vergleiche die Methoden, mit denen verschiedene Tierarten ihre Reviere festlegen und wie sie diese gegen Artgenossen, aber auch gegen Tiere anderer Arten verteidigen! Recherchiere dazu im Internet!
Erörtere, was es bedeutet, wenn die Population einer Tierart in einem Gebiet abnimmt! Was geschieht mit den Tieren?
Informiere dich darüber, welche Maßnahmen der Mensch setzen kann, um die Größe von Tierpopulationen zu regeln! Erstelle eine Tabelle mit Einzelmaßnahmen und vergleiche sie! Dann beziehe zu jeder dieser Maßnahmen Stellung! Welche empfindest du für gut, welche nicht? Begründe auch deine Meinung!
Der Mensch spielt hier eine bedeutende Rolle. Er beansprucht das meiste Gebiet für sich und möchte nur Tiere dort haben, die ihm Vorteile bringen. So sollen Rehe im Wald bleiben und möglichst nicht auf die Felder kommen, wo sie bessere Nahrung finden würden. Große Raubtiere wie Wölfe töten immer wieder Nutztiere wie Schafe, wenn sie Einzelgänger sind oder sich die Reviere des Rudels auf Weidegebiete ausdehnen. Daher versucht der Mensch, die Größe von Wildtierpopulationen zu regeln.
Gesunde Natur braucht Artenvielfalt. Viele Lebewesen, die uns keinen unmittelbaren Vorteil oder sogar vereinzelt Nachteile bringen, sind dafür sehr wichtig. Nenne drei Beispiele, wo aus Bedürfnissen des Menschen und jenen anderer Lebewesen ein Konflikt entsteht!
landwirtschaftliche Fläche pro Mensch: gemischte Ernährung: 2 000 m2

25 % für pflanzliche Nahrung
% für Tierfutter
Welche Fläche braucht ein Mensch? – Lies zunächst den Informationstext und kreuze dann an, ob die Aussagen wahr oder falsch sind! Wenn du richtigliegst, erhältst du ein Lösungswort aus diesem Kapitel. wahr falsch
vegetarische Ernährung: 1 000 m2


Die landwirtschaftliche Fläche, auf der die Nahrungsmittel für einen einzigen Menschen hergestellt werden, ist bei uns im Durchschnitt etwa 2 000 m² groß. Nur etwa 500 m² werden benötigt, um Getreide, Gemüse, Obst usw. herzustellen. Den Großteil der Fläche brauchen wir, um die Nahrung für Tiere anzubauen. Wir füttern sie, um dann ihr Fleisch, ihre Milch oder Milchprodukte zu konsumieren. Der Flächenbedarf eines Vegetariers, also eines Menschen, der kein Fleisch isst, ist nur etwa halb so groß.
Der Großteil der landwirtschaftlichen Fläche wird für Tierfutter benötigt.
R S Würden alle Menschen vegetarisch essen, könnten 3-mal so viele Menschen ernährt werden. O E Vegetarier brauchen mehr Fläche als Nicht-Vegetarier.
L V Pro Person sind etwa 1 500 m² für die Fleischproduktion notwendig.
I G Vegetarier essen kein Fleisch.
E P Für die Milchproduktion wird keine zusätzliche landwirtschaftliche Fläche benötigt. H R
Lösungswort: . . . . . .
Einige Rechenbeispiele: Lies die Angaben, führe die Berechnungen in deinem Heft durch und schreib die richtigen Antworten auf die Linien!
a) Am Sonntag kommt Huhn auf den Tisch. Das Stück, das dir deine Mutter auf den Teller legt, ist etwa 100 g schwer. Wieviel Futter musste das Huhn dafür zu sich nehmen?
b) Um 1 kg Kartoffeln zu erzeugen, ist eine Fläche von etwa 0,5 m2 Acker erforderlich. Auf der Tüte mit Kartoffelchips steht, dass der Inhalt eine Masse von 200 g hat. Welche Fläche war dafür erforderlich?
c) Heute gibt es etwas ganz Besonderes zu essen: Forelle! Dabei handelt es sich um einen Raubfisch. Deine Forelle hat etwa 0,2 kg. Welche Menge an Wasserpflanzen waren erforderlich, damit der Fisch so groß werden konnte?
Blütenpflanzen hast du schon kennengelernt. Sie werden befruchtet und bilden zur Vermehrung Samen. Das nennt man geschlechtliche Vermehrung. Dafür sind zwei Organismen notwendig, deren Erbgut sich vermischt. Ein Vorteil, denn es entsteht mehr Vielfalt. Im Wald wachsen neben den Blütenpflanzen auch Moose und Farne. Sie vermehren sich nicht durch Samen, sondern mittels Sporen. Die Fortpflanzung geschieht in zwei Schritten, ungeschlechtlich und geschlechtlich.
Moose sind Pionierpflanzen und besiedeln Plätze wie Baumrinden, Steine und Felsen, also Stellen, an denen keine Blütenpflanzen wachsen können. Moospflänzchen wachsen nach oben. Ihre unteren Teile sterben ab und werden zu Humus. So entsteht neuer Boden, auf dem andere Pflanzen wachsen können. Moospolster filtern darüber hinaus Flugstaub aus der Luft und nützen dabei Mineralsalze im Staub als Dünger.

Moose haben keine Wurzeln, sondern nehmen das Wasser und die Mineralsalze über ihre Blattoberfläche auf.
orientieren: sich zurechtfinden, den Weg finden

Führe folgenden Versuch durch! Nimm einen trockenen Moospolster und wiege ihn ab! Lege ihn ein paar Stunden ins Wasser! Anschließend nimm ihn heraus und wiege ihn nochmal! Vergleiche die Ergebnisse! Was hat sich verändert? Erkläre die Veränderung!
Besonders oft findest du Moose im Nadelwald. Dort kannst du dich sogar mit ihrer Hilfe orientieren, indem du darauf achtest, wo sie wachsen. Denn Moose bevorzugen Stellen, an denen sie Feuchtigkeit und Schatten finden. Sie wachsen daher häufig an Baumstämmen und Steinen, die nach Nordwesten gerichtet sind. Wind, der Regen mit sich bringt, kommt bei uns häufig von Westen. Die Sonne steht nie nördlich, also bietet die Nordseite den meisten Schatten. Aus diesen Gründen findet man an diesen Stellen häufig Moose.



Wie überstehen Moose Trockenheit? Moose können das 10-fache ihres Gewichtes an Wasser aufnehmen. Haben die Blättchen das Wasser abgegeben, rollen sie sich zusammen. So können Moose Trockenzeiten überstehen. Sogar im ausgetrockneten Zustand überleben Moose lange Zeit.

Abb. 3: Moosblättchen mit Wassertropfen
Ein Moospflänzchen besitzt ein Stämmchen, kleine Blättchen und Wurzelfäden. Diese Wurzelfäden dienen nicht zur Wasseraufnahme – wie bei anderen Pflanzen – sondern halten die Moospflanze im Untergrund fest. Wasser und Mineralsalze werden vor allem durch die Blättchen aufgenommen. Durch die Form der Pflänzchen wird zusätzlich Wasser zwischen den Blättchen festgehalten. Damit verhindern Moose, dass bei starkem Regen Erde weggeschwemmt wird. Bei Trockenheit verdunsten sie das zwischen den Blättchen gehaltene Wasser. Das verhindert ein Austrocknen des Waldbodens und lässt die Luftfeuchtigkeit im Wald ansteigen. So entsteht für die Lebewesen im Wald ein angenehmes Klima

Blättchen
Stämmchen Wurzelfäden
Abb. 4: Moospflänzchen
Vergleiche die Fortpflanzung der Moose mit anderen ungeschlechtlichen Fortpflanzungsmethoden!
Denke dabei an die Kartoffel, Brutzwiebel oder Stecklinge! Worin besteht der Unterschied?
Sieh dir Abbildung 1 aus diesem Kapitel an!
Findest du dort die ungeschlechtliche Generation?
Kannst du erklären, weshalb sie sich zu dieser Form entwickelt hat?
Suche im Wald nach unterschiedlichen Moosen. Mit dem QR-Code kommst du zu einer Seite, auf der viele Arten in Österreich beschrieben werden. Kannst du deine Funde zuordnen?
Das Haarmützenmoos trägt eine Sporenkapsel an einem Stiel. Diese Kapsel ist mit einer Mütze bedeckt, daher auch der Name Haarmützenmoos.
Sporenkapsel
Schwärmer befruchtet die Eizelle. Sporenkapsel wächst aus befruchteter Eizelle.
weibliches und männliches Moospflänzchen
Schwärmer schwimmen durchs Wasser zur Eizelle.

Vergleiche die Formen der Moose! Was haben sie gemeinsam? Hängt das mit der Fähigkeit, Wasser zu speichern zusammen?
Generation, die: Glieder einer Abstammungslinie

Abb. 6: Trügerisches Torfmoos

Mütze
Sporenkapsel öffnet sich und gibt die Sporen frei.
Schäden durch die Landwirtschaft gefährden Moose und die Natur allgemein: Wie stehst du dazu? Welche Bedürfnisse müssen hier ausgeglichen werden?
Begründe deine Meinung!
Aus der Spore wächst der Vorkeim mit Knospe.
Moospflänzchen wächst.
Abb. 5: Fortpflanzung des Mooses am Beispiel des Haarmützenmooses
Ungeschlechtliche Generation: Die Sporen im Inneren der Kapsel entstehen ungeschlechtlich durch Zellteilung. Sind sie reif, fällt die Mütze bei trockenem Wetter ab. Die Sporenkapsel öffnet sich, die Sporen fallen heraus und werden vom Wind vertragen Aus der Spore entwickelt sich der Vorkeim. Sporenkapsel und Sporen bezeichnet man als ungeschlechtliche Generation.
Geschlechtliche Generation: Fallen die Sporen zu Boden, so beginnen sie im feuchten Boden zu keimen. Jede Spore bildet einen Vorkeim, der wiederum Knospen bildet. Aus der Knospe wird ein Moospflänzchen. An der Spitze der Moospflänzchen wachsen im Frühling kleine Blattrosetten, die entweder männliche oder weibliche Organe enthalten. Zur geschlechtlichen Fortpflanzung benötigen die Moose Wasser. Bei Regen schwimmen die Schwärmer, die männlichen Zellen, im Wassertropfen zum weiblichen Organ und verschmelzen mit den Eizellen. Aus einer befruchteten Eizelle wächst ein Stiel mit einer Sporenkapsel an der Spitze.
Vorkeime, Knospen und Moospflänzchen mit den Geschlechtsorganen bezeichnet man als geschlechtliche Generation. Da die beiden Generationen abwechselnd auftreten, spricht man von einem Generationswechsel.
Manche Moosarten sind gefährdet. In Mitteleuropa geschieht das besonders durch die intensive Land- und Forstwirtschaft. Durch das Verbauen von Feuchtgebieten und das Absinken des Grundwasserspiegels wird ihr Lebensraum immer kleiner.
Farne wachsen in der Krautschicht in feuchten, schattigen Wäldern.



Farne haben große Blätter, die man Farnwedel nennt. Sie wachsen aus einem Erdspross, der zum großen Teil unter der Erde liegt.
Ungeschlechtliche Generation: An der Blattunterseite bilden sich bei manchen Farnen im Sommer kleine Erhebungen, die sogenannten Sporenbehälter. In diesen werden die Sporen gebildet. Wenn die Sporen reif sind, platzen die Sporenbehälter auf. Die zahlreichen Sporen fallen heraus und werden vom Wind vertragen.
An feuchten und schattigen Stellen beginnen die Sporen zu keimen. Aus einer Spore wird ein herzförmiger Vorkeim
Geschlechtliche Generation: Auf dem Vorkeim entwickeln sich weibliche und männliche Geschlechtsorgane. Während in den weiblichen Organen Eizellen entstehen, entwickeln sich in den männlichen Organen Schwärmer
Aus der befruchteten Eizelle wächst ein Farnpflänzchen.
Schwärmer schwimmen durchs Wasser zur Eizelle.
Abb. 8: Bau einer Farnpflanze

Betrachte die Unterseite eines Farnwedels mit einer Lupe! Dann beschreibe die Sporenbehälter! Vergleiche sie mit den Samen und Früchten anderer Pflanzen!
Unterseite der Farnwedel
Schnitt durch den Farnwedel mit den Sporenbehältern
aufgeplatzter Sporenbehälter keimende Spore herzförmiger Vorkeim mit weiblichen und männlichen Geschlechtsorganen
Wenn es regnet, fallen Wassertropfen auf den Vorkeim. Im Wasser schwimmen nun die Schwärmer zu den Eizellen und befruchten sie. Pro Vorkeim entsteht aber jeweils nur aus einer befruchteten Eizelle eine Farnpflanze.


Abb. 9: Fortpflanzung des Wurmfarns
Auch bei den Farnen gibt es einen Generationswechsel. Da sich auf den Vorkeimen die Geschlechtsorgane bilden, ist das die geschlechtliche Generation. Auf einem Farnwedel bilden sich die Sporen in den Sporenbehältern. Man spricht von der ungeschlechtlichen Generation
†
Farne nutzen Sporen zur Vermehrung. Denke an den Stammbaum der Pflanzen! Was denkst du? Sind Farne in der Entwicklung eher früh oder spät entstanden? Begründe deine Antwort!

Abb. 12: Hirschzungenfarn
Waldschlag, der: baumlose Stelle im Wald, nachdem die Bäume gefällt worden sind

Abb. 13: Bärlappe


Wälder der Urzeit
Vor etwa 400 Millionen Jahren gab es Farne, die so groß wie Bäume waren. Sie bildeten zusammen mit Schachtelhalmen und Bärlappen riesige Wälder. Als die abgestorbenen Pflanzenreste von Erde und Gestein bedeckt wurden, entstanden aus den Wäldern über Jahrmillionen die heutigen Steinkohlevorkommen.


Der Wurmfarn kommt in den heimischen Wäldern häufig vor. Die jungen Farnwedel sind – wie bei allen Farnen – eingerollt und haben Schuppen. So sind sie vor dem Austrocknen geschützt.
Der Adlerfarn braucht mehr Licht als andere Farne. Er wächst daher in lichteren Wäldern und Waldschlägen. Sein Erdspross wächst mehrere Meter lang unter der Erde. Jedes Jahr bildet sich aus dem Erdspross nur ein einziger Farnwedel, der aber über 1 m hoch werden kann.
Die Hirschzunge ist eine Farnpflanze, die sehr selten ist und daher unter Naturschutz steht. Sie wird als Heilpflanze in der Kräuterheilkunde verwendet.
Auch Bärlappe und Schachtelhalme gehören zu den Farnpflanzen. Der AckerSchachtelhalm ist bei den Bauern sehr unbeliebt, denn er gilt als Unkraut, das man nur schwer loswird. Sein Erdspross wächst bis zu 2 m tief in den Boden und bildet immer wieder neue Triebe.


Diese Bilder zur Fortpflanzung der Moose sind durcheinandergekommen. Bringe sie wieder in die richtige Reihenfolge, indem du die Abbildungen nummerierst! Die erste Nummer ist bereits ausgefüllt.










Finde heraus, welche Generation die geschlechtliche und welche die ungeschlechtliche ist! Kreuze dazu an!
Farne
Farnpflanze mit Sporenbehältern
Vorkeim mit weiblichen und männlichen Organen
Moose
Vorkeim, Knospe und Moospflänzchen
1 2 3
geschlechtliche Generation ungeschlechtliche Generation
Sporenkapsel und Sporen
Auch diese Bilder sind durcheinandergekommen. Bringe sie wieder in die richtige Reihenfolge, indem du die Abbildungen nummerierst! Die erste Nummer ist auch hier bereits ausgefüllt.
1 1











Vergleiche den Bauplan dieser beiden Pflanzen! Ordne die Begriffe aus dem Kästchen richtig zu und beschrifte damit die beiden Pflanzen!
Blüte








Blütenpflanze
Knolle mit Wurzeln Blätter Stängel





Blatt Stämmchen Wurzelfäden



Was trifft auf Blütenpflanzen zu und was auf Moose? Kreuze an!
Speicherung von Nährstoffen in Speicherorganen
Aufnahme von Mineralsalzen durch die Blättchen Vermehrung durch Samenproduktion
Aufnahme von Wasser durch die Wurzeln Vermehrung durch Sporen
Welche dieser Aussagen treffen auf Moose zu? Kreuze die fünf richtigen Aussagen an!


Wasser wird durch die Blättchen aufgenommen.

Moos
Wasser wird zwischen den Blättchen festgehalten.
Moose schützen den Boden vor dem Wegspülen.
Bei zu starkem Regen rollt sich die Moospflanze ein.
Bei Trockenheit wird wieder Wasser abgegeben.
Die Moospflanze braucht auch zur Fortpflanzung Wasser.
Moose brauchen zum Wachsen viel Licht.

Eine Gruppe von Moosen, die Torfmoose, bilden eine einzigartige Lebensgemeinschaft: Das Moor
Torfmoose kommen an sehr feuchten Orten vor. Ausreichend verfügbares Wasser ist also eine wichtige Voraussetzung zur Entstehung von Mooren. Wie du bereits gelernt hast, wachsen Moose nach oben, während die unteren Bereiche der Moospflanze absterben, wenn sie zu wenig Licht und Sauerstoff erhalten.
In der Regel werden solche Pflanzenreste von kleinen Tieren wie Insekten, Würmern aber auch Pilzen und Mikroorganismen zersetzt und abgebaut. Bleibt die sich bildende Schicht abgestorbener Pflanzenreste beständig wasserdurchtränkt, finden vor allem Mikroorganismen aufgrund von Sauerstoffmangel jedoch keine passenden Lebensbedingungen darin vor.
Da Moose aufgrund ihrer Form Wasser gut speichern können, wirkt auch die Schicht abgestorbener Pflanzen wie ein Schwamm. Ist genug Wasser vorhanden, ist sie daher ständig mit Wasser vollgesogen. Es leben also nur wenige Mikroorganismen darin und die Pflanzenreste werden nur unvollständig abgebaut. Wächst das Moos nun stärker, als die Schicht darunter zersetzt wird, dann wird die Schicht mit der Zeit dicker und dicker. Das Moor entsteht. Die Schicht aus vermoderten Pflanzenresten hat einen eigenen Namen, Torf.
Die Ausbildung einer Torfschicht ist ein wesentlicher Unterschied von Mooren zu anderen Ökosystemen. Da die Pflanzenreste nicht vollständig zersetzt werden, werden die darin enthaltenen Nährstoffe nicht frei.

Torf ist im Vergleich zu den nährstoffreichen Humusschichten anderer Lebensräume, wie beispielsweise dem Wald, ein sehr nährstoffarmer Boden. Werden durch die Wasserversorgung des Moores keine Nährstoffe zugeführt, bilden Moore nur karge, niedrige Vegetation aus. Entsprechend unterscheiden sich die Landschaftsmerkmale von Mooren untereinander und von jenen anderer Lebensräume.
vermodern: zersetzen, verfaulen
Humus, der: nährstoffreicher Teil des Bodens aus zersetzten organischen Substanzen.
Erkundigt euch und recherchiert, wo es in eurer Nähe ein Moor gibt! Besucht es und beschreibt Landschaft, Tier- und Pflanzenwelt, die ihr dort findet!
Tipp: Sucht online nach „Moore in Österreich“

Abb. 3: Torferde ist grobfasrig und die Pflanzenreste noch gut erkennbar.

Abb. 4: Humus ist feiner als Torf und in der Regel dunkler.
Überschwemmung, die: Das Land wird mit Wasser, Schlamm und Geröll bedeckt.
Woher der Wasserüberschuss in Mooren stammt, ist je nach Moortyp unterschiedlich. Quellenwasser aus dem Untergrund, Regen, in Senken gesammeltes Wasser, beispielsweise nach Überschwemmungen, oder Seen, die zuwachsen, sind einige Möglichkeiten. Je nach den örtlichen Bedingungen können sich Moore unterschiedlich entwickeln. Eine wichtige Unterscheidung ist jene zwischen Niedermoor und Hochmoor
Abb. 2: Sieh dir das Bild genau an. Kannst du den Torf erkennen? Ist die Vegetation eher üppig, oder karg?
Verlandung, die: Auffüllung stehender Gewässer mit organischem Material. Scanne den QR-Code für eine sehr schöne Erklärung!

Suche im Internet nach Bildern verschiedener Moore! Vergleiche diese und versuche, Gemeinsamkeiten und Unterschiede zu finden! In der Bildbeschreibung ist oft zu erfahren, um welchen Typ Moor es sich handelt. Besprecht eure Ergebnisse in Kleingruppen in der Klasse! Tipp: Suche erst nach „Moortypen“, oder „Moor Typen“ um herauszufinden, welche Arte an Mooren es gibt! Dann suche gezielt nach Bildern davon!


Was ist Mudde? Mudde ist ein Sammelbegriff für Bodenablagerungen in Seen. Torfmudde (Torfmoosreste) und Lebermudde (Algenreste) verfügen über einen hohen Anteil an organischen Substanzen. Kalkmudden haben einen geringeren organischen Anteil, dafür einen hohen Kalkanteil.
Niedermoore bilden sich vor allem in Gebieten, in denen ausreichend Wasser durch Grundwasserquellen oder Überschwemmungen zur Verfügung steht. Entsprechend finden sie sich in Senken, in Flussniederungen und Küstengebieten als auch auf verlandeten Seeflächen. Sie verfügen über eine niedrige Torfschicht, weshalb sie ein flaches Landschaftsbild vorweisen. Das Wasser aus den Quellen von Niedermooren ist in der Regel reich an Mineralien und Nährstoffen. Da die Torfschicht nicht dick ist, kann sie bis zur Oberfläche von dem nährstoffreichen Wasser durchdrungen werden und die Nährstoffe stehen den Pflanzen des Moores zur Verfügung.
Niedermoore verfügen deshalb über eine üppige Vegetation und eine Vielfalt an Tierarten.
Du hast schon einiges über die Entstehung von Mooren und welche Arten es gibt, gelernt. Sicher sind noch einige Fragen offengeblieben. Formuliere drei Forschungsfragen, deren Beantwortung dir Wissen über die Inhalte des Buchs hinaus liefern!
Besprecht eure Fragen in der Klasse und diskutiert, wie ihr durch Experimente und Recherche an Antworten kommen könnt!
Niedermoore wachsen meistens nur wenig in die Höhe. Unter den richtigen Bedingungen kann die Torfschicht jedoch so weit wachsen, dass ein Hochmoor entsteht.


Hochmoore
Hochmoore können aus Niedermooren entstehen, deren Torfschicht so weit wächst, dass die lebende Pflanzenschicht keinen Kontakt mehr zum Grundwasser hat. Für weiteren Wassernachschub muss dann Niederschlag sorgen.
In regenreichen Gebieten können Hochmoore auch direkt auf dem Untergrund wachsen, da der Regen für ausreichende Wasserzufuhr sorgt, ohne dass die für Niedermoore typischen Wasserquellen vorhanden sind. Hochmoore verfügen über eine hohe Torfschicht.
Da diese nun nicht mehr bis obenhin von nährstoffreichem Grundwasser durchtränkt ist, ist sie nährstoffarm. Neue Mineralsalze werden ausschließlich durch den Wind aus der Umgebung angeweht.
Aus diesem Grund können nur sehr gut angepasste Pflanzen und wenige Tiere im Hochmoor überleben. Hochmoore wachsen von der Mitte nach außen. Die jüngeren Teile am Rande sind demzufolge niedriger, wodurch das Moor seinen gewölbten Charakter erhält. Zwischen den kleinen, trockenen Erhebungen, den sog. Bulten, befindet sich häufig ein Netz feuchter Vertiefungen, die Schlenken.


Abb. 6: Querschnitt durch ein Hochmoor
Welche Tiere und Pflanzen in einem Moor leben hängt stark vom Typ des Moores und den Bedingungen, die es bietet, ab. Entsprechend haben sich mit der Zeit Tiere und Pflanzen entwickelt, die auf das Leben im Moor spezialisiert sind und teilweise nur dort zu finden sind.

Das höhere Nährstoffangebot in Niedermooren erlaubt es vielen Pflanzen und Tieren, darin zu leben. Die Vegetation ist meistens dicht und besteht auch aus hochwüchsigen Pflanzen. Schilfartige Pflanzen wachsen in und um stehendes Wasser. Daneben wachsen Gräser, Farne und häufig auch Erlenwälder und Gebüsche. Eine typische Pflanze der Niedermooren ist das Schmalblättrige Wollgras. Der Moorfrosch bewohnt Gebiete mit hohem Grundwasserstand oder staunasse Flächen. Sein Lebensraum sind die Nass-, Feuchtwiesen und Niedermoore. Auch Vögel und Insekten fühlen sich in Niedermooren wohl. Beispielsweise das Braunkehlchen, die Sumpfschrecke und verschiedene Libellenarten und Schmetterlinge.
Hochmoore bieten nur karge Lebensbedingungen. Der Torf des Hochmoores enthält wenig Nährstoffe und Gewässer in Hochmooren sind durch das Torfmoos sauer. Entsprechend können dort nur Pflanzen und Tierarten überleben, die sich im Laufe ihrer Entwicklung daran angepasst haben.
Die Vegetation ist niedrig und besteht aus Torfmoosteppichen, Zwergsträuchern und Gräsern. Mancherorts sind auch kleinwüchsige Varianten von Bäumen wie der Bergkiefer zu finden. Im Randbereich finden Bäume bessere Lebensbedingungen und es wachsen Moorbirke, Fichte und Kiefer. Manche Pflanzen, wie der Rundblättrige Sonnentau, haben eine besondere Methode entwickelt, den Nährstoffmangel auszugleichen. Sie fangen Insekten.


Die Moosbeere ist ein typischer Zwergstrauch der Hochmoore. Im sauren Wasser leben weder Fische noch Krebse, Muscheln, oder andere Tiere. Allerdings sind viele Insekten wie Libellen, Schmetterlinge und Käfer und auch Spinnen im Hochmoor beheimatet. Der Hochmoor-Perlmuttfalter ist ein prächtiges Beispiel dafür. Diese Insekten und ihre Larven sind die Nahrungsgrundlage für Amphibien und Reptilien. Der Moorfrosch beispielsweise ist auch im Hochmoor beheimatet. Neben ihm finden sich Eidechsen und verschiedene Vogelarten.
Vegetation, die: Gesamtheit der Pflanzen, Pflanzendecke



Wollgras blüht von März bis Mai und bildet dabei die typischen Büschel. Mache in dieser Zeit einen Ausflug in ein Moor und versuche, Wollgras zu finden (bleibe auf den Wegen!). Sie es dir genau an. Wächst es allein oder in Gruppen? Wie sehen die Blätter und der Stiel aus? Notiere und skizziere, was du siehst! Kannst du noch andere Pflanzen oder Tiere erkennen?
In Mooren leben viele hochspezialisierte Arten. Was bedeutet es für sie, wenn Moore verloren gehen? Frag Menschen in deinem Umfeld, was sie über Moore und deren Lebewesen wissen! Wie könntest du Bewusstsein für Moore und ihre Bewohner schaffen?

Perlmuttfalter
Bringe in Erfahrung, wozu Torf in Österreich heute am meisten verwendet wird! Gibt es Alternativen dazu? Was könnte der Grund sein, dass die Zerstörung ganzer Lebensräume in Kauf genommen wird?

Moore sind wichtiger denn je! Moore binden in ihrer Pflanzenmasse sehr viel Kohlendioxid (CO2) aus der Atmosphäre, welches sie als Kohlenstoff im Torf speichern. Die Erhöhung der CO2 Menge in der Atmosphäre ist einer der Hauptgründe für den Klimawandel. Unversehrte Moorflächen können also helfen den CO2 Gehalt der Atmosphäre zu reduzieren und dem Klimawandel entgegenzuwirken. Werden Moore allerdings zerstört wird das in ihnen gebundene CO2 wieder freigesetzt und trägt zum Klimawandel bei.

Recherchiert im Internet, wo auf der Welt es noch große Moorflächen gibt! Findet heraus, ob und wie sehr sie geschrumpft sind! Vergleiche: In Österreich sind mehr als 90 % der Moore trockengelegt oder anders geschädigt!
Es gibt tolle Videos zur Wiederherstellung von Mooren im Internet. Suche nach „Renaturieren von Mooren“! Sieh sie dir in der Klasse und mit Freundinnen und Freunden an! Sprecht darüber! Was denkt ihr?
Bedeutung und Bedrohung der Moore
Moore gibt es schon sehr lange und viele heute noch bestehende, sind uralte Lebensräume. Mit ihrer Fähigkeit, Wasser speichern zu können sind sie Teil des natürlichen Wasserkreislaufes. Sie schützen uns vor Hochwasser und sichern unser Trinkwasser. Moore bieten auch Brutplätze und wichtige Rückzugsgebiete für vom Aussterben bedrohte Vogelarten.
Schon seit der Frühgeschichte haben Menschen Moore genutzt und beeinflusst. Moore waren für die Menschen lange Zeit mystische Orte, die für Rituale genutzt wurden, wie von Archäologen gefundene Opfergaben beweisen.

Um sich in Mooren bewegen zu können, konstruierten Menschen ausgeklügelte Moorwege. Moore waren und sind immer noch die Quelle von Torf, den der Mensch früher vor allem als Heizmaterial nutzte. Der Abbau mittels Torfstechen erfolgte früher per Hand.

Durch den Einsatz von Maschinen hat sich die Abbaumenge vervielfacht und auch heute noch gehen beträchtliche Mengen an Moorlandschaft dadurch verloren.
Die größte Bedrohung von Mooren stammt allerdings woanders her. Im Zuge seiner Ausbreitung und immer intensiveren Nutzung von Land für seine Zwecke, hat der Mensch massiv in den Wasserkreislauf allgemein und direkt in Moore eingegriffen.
Um Raum für die Landwirtschaft zu gewinnen, wurden Moore schon seit langem entwässert, trockengelegt und damit zerstört. Seit der Neuzeit und insbesondere ab der Verwendung von Maschinen hat sich diese Zerstörung intensiviert. Dadurch sind in Europa der Großteil der Moorlandschaften verloren gegangen.
Heute weiß der Mensch, wie schädlich das Zerstören der Moore und von Lebensräumen allgemein ist. Es wird daher versucht, zerstörte und geschädigte Moore wieder herzustellen. Man nennt das renaturieren. Das ist oft sehr aufwendig und braucht viel Wissen.
Abb. 15 und 16: Sieh dir die Bilder genau an! Erkennst du Dinge wieder, über die du bereits gelernt hast? Tausche dich mit deiner Sitznachbarin, deinem Sitznachbarn aus!

Biologinnen und Biologen spielen dabei eine Schlüsselrolle. Ist ein Moor wieder intakt, zeigt sich eine rasche Erholung der Artenvielfalt und positive Auswirkungen auf das Umland.
Abb. 16: unversehrte Hochmoorlandschaft
Sieh dir die folgenden Bilder gut an! Notiere am Rahmen was genau du darauf siehst und schreibe auf, was du darüber alles schon weißt! Ergänze durch Recherche! Für leere Bilderrahmen entscheide selbst! Wähle einen Begriff aus dem Buch oder vielleicht hast du beim Bewältigen der vorherigen Aufgaben etwas Interessantes gefunden. Suche ein Bild dazu und fertige davon eine Skizze an! Ergänze Informationen durch Recherche! Tragt eure Ergebnisse zusammen, wenn alle recherchieren, wisst ihr danach gemeinsam viel mehr!















Du hast nun schon viel über Moore erfahren. Fasse zusammen, welche Rolle Moore für Umwelt, Mensch, sowie Pflanzen und Tiere spielen. Formuliere nun Gründe, warum Moore erhalten bleiben sollen! Denke dir Maßnahmen aus, die dem Schutz der Moore dienen können! Schreibe deine Gedanken auf und teile sie mit deiner Umgebung! Umweltzschutz geht nur gemeinsam!
Tipp: Schnapp dir eine Freundin oder einen Freund. Gemeinsam macht es mehr Spaß und ihr könnt Ideen und Gedanken austauschen! Warum sollten Moore erhalten bleiben:
Was können ich und andere dafür tun:
Moore sind wahre Bodenarchive. Da organisches Material im Torf wenig zersetzt wird, bleibt es sehr lange darin erhalten. Dadurch entstehen reichhaltige Fundstellen für archäologische und biologische Forschung Archäologinnen und Archäologen sind an Überresten früherer menschlicher Aktivitäten interessiert. Das kann von einfachen Gegenständen des Alltags, über Kultgegenstände bis hin zu ganzen menschlichen Körpern gehen. Biologinnen und Biologen sind an pflanzlichen Überresten, wie beispielsweise Pollen, oder Baumresten interessiert. Daraus lernen sie etwas über frühere Umweltbedingungen.
Was denkst du? Werden in Hochmooren oder Niedermooren mehr gut erhaltene Fundstücke zu finden sein? Begründe deine Antwort!
Ich denke in:
Weil:
Was denkst du? Liegen ältere Fundstücke tiefer oder höher im Torf? Weshalb ist das so?
Ich denke:
Weil:
4 3

Suche nun mit passenden Suchbegriffen (z.B. aus dem Aufgabentext) im Internet nach mehr Informationen zu Funden und Vorgehensweisen, die Aufschluss über die Vergangenheit geben! Schreib einen kleinen Bericht über deine Ergebnisse und teile sie in deinem Freundeskreis und in der Klasse! Tipp: Auch hier gilt, gemeinsam macht es mehr Spaß und ihr könnt gleich über eure Funde sprechen!
Starte deine eigene kleine Expedition ins Moor! Nimm am besten Freundinnen und Freunde mit! Du brauchst: Lupe % Lineal oder Maßband % einen Block % Stifte. Besucht einen Moorlehrpfad und wählt euch jeder eine Pflanze aus, die ihr interessant findet! Begutachtet sie genau! Messt, wie groß sie und ihre einzelnen Teile sind! Betrachtet sie auch unter der Lupe, um Details zu erkennen! Macht Skizzen und notiert alles, was ihr beobachtet! Dokumentiert alles gut, dann könnt ihr eure Pflanzen wahrscheinlich mit Hilfe des Internets identifizieren und mehr über sie herausfinden. Fasse deine Erkenntnisse im unteren Steck brief der untersuchten Pflanze zusammen! Tipp: mit einer Kamera ist das Dokumentieren leichter! Ihr könnt dann auch noch zu Hause die Pflanzen studieren. Macht trotzdem Skizzen! Achte auf die Pflanzen, die du untersuchst und verletze sie nicht!
Skizze:
Merkmal:

Größe: Art:
Standort:
Unter der Lupe:
Sonstiges:


Der Teil der Biologie, der sich mit Pflanzen beschäftigt, heißt Botanik. Botanikerinnen und Botaniker versuchen, die ungeheure Vielfalt an Pflanzen und deren Merkmale zu erfassen. Dafür interessieren sich auch Medikamentenhersteller. Viele Pflanzen tragen Wirkstoffe in sich und Fachkräfte der Botanik werden angeheuert, um solche Pflanzen zu finden.
Erfolgreiche Landwirtschaft braucht Wissen über die angebauten Pflanzen. Diese werden durch Züchtung und gezielte genetische Veränderungen mit erwünschten Eigenschaften ausgestattet. Auch für den Schutz der Pflanzen und die Vernichtung unerwünschter Pflanzen braucht es botanisches Wissen. Manche Technologien ahmen Pflanzen nach, wie beim Lotuseffekt. Überall dabei helfen Botanikerinnen und Botaniker. Sie beobachten auch wie sich Pflanzen in einem Lebensraum entwickeln, ob neue Arten hinzukommen und alte seltener werden. Das ist wichtig, um gezielten Umweltschutz zu betreiben. In Museen und botanischen Gärten vermitteln Botanikerinnen und Botaniker Wissen und betreuen die botanischen Sammlungen.
1
Geschichten der Bäume. Du weißt schon über Jahresringe Bescheid. Sie bestehen aus zwei Teilen. In der früheren Wachstumsphase eines Jahres ist das Holz weniger dicht und oft heller, in der späteren Wachstumsphase des Jahres dichter und oft dunkler. Wächst ein Baum in einem Jahr stark, ist der Ring dicker, wächst er weniger, dünner.
Suche in deiner Umgebung Baumstümpfe und studiere die Jahresringe! Versuche gute und schlechte Jahre für den Baum herauszufinden!
Hier hast du eine Legende für genauere Bestimmungen:
Trockenheit äußert sich in sehr dünnen, kaum ausgeprägten Jahresringen.
Schwarze Einschlüsse im Holz deuten auf einen Waldbrand hin.
Unterbrechungen der Ringe beziehungsweise neue Startlinien von Ringen deuten auf Wunden hin, die abgeheilt sind.
Wächst der Baum durch Wind oder Lichteinfall schräg, zeigen sich ungleichmäßig dicke Jahresringe innerhalb eines Jahres.
Wellige, gezackte Linien können auf einen Schädlingsbefall hindeuten.
Versuche die Geschichte eines Baumes zu schreiben!

5 OlympeVerlag


Auch Botanikerinnen und Botaniker können Jahresringe lesen und das sehr genau. Oft untersuchen sie sehr alte Bäume und Holz aus archäologischen Ausgrabungen.
Schreibe einen kurzen Text darüber, weshalb Bäume Information über die Vergangenheit in sich tragen und welche Ereignisse Forscherinnen und Forscher aus ihnen ablesen könnten?

So schätze ich mich nach dem Großkapitel AUFBAU UND FUNKTION VON PFLANZEN selbst ein: Kreuze jenen Daumen an, der für dich am ehesten zutreffend ist!
…die vier Abschnitte verschiedener Blütenpflanzen und ihren Aufbau vergleichen.
…Speicherorgane von Pflanzen nennen.
…analysieren, wie eine Zwiebel aufgebaut ist.
…den Aufbau eines Baumstammes erklären.
…über das Wachstum von Pflanzen sprechen.
…den Vorgang der Fotosynthese beschreiben.
…Atmung und Verdunstung in Blättern nachvollziehen.
…den Aufbau und die Funktion verschiedener Blüten miteinander vergleichen.
…die Nahrungspyramide im Wald erklären.
…das Räuber-Beute-Verhältnis analysieren.
…erörtern, wie viel Fläche Tiere benötigen und den Zusammenhang zwischen Revier- und Populationsgröße erläutern.
…den Einfluss des Lichteinfalls auf den Wuchs von Pflanzen erkennen und bewusst gestalten.
…eine Moorlandschaft und einige ihrer Bewohner erkennen, wenn ich mich darin befinde.
…Speicher und Fortpflanzungsorgane von Pflanzen, die ich sehe, unterscheiden und benennen.
…den Fortpflanzungszyklus von Moosen und Farnen miteinander vergleichen.
…zwischen geschlechtlicher und ungeschlechtlicher Fortpflanzung bei Sporenpflanzen unterscheiden.
Um deine Kompetenzen noch mehr zu steigern, hier unsere Buchtipps:



Johannes F. Brakel: Birken, Mohn und Baobab: Ein Streifzug durch die Pflanzenwelt (Freies Geistesleben, 2011).
Steffen Guido Fleischhauer, Roland Spiegelberger, Claudia Gassner: Blatt für Blatt: Über 800 Pflanzen nach Blattformen und Blüten einfach bestimmen (AT Verlag, 2022).
Rita Lüder: Grundkurs Pflanzenbestimmung: Eine Praxisanleitung für Anfänger und Fortgeschrittene (Quelle und Meyer, 2020)










Nach Regentagen im Sommer oder an warmen Herbsttagen findest du besonders viele Pilze im Wald oder auf der Wiese. Viele von ihnen wachsen innerhalb eines Tages aus dem Boden. Schwammerlsucherinnen und Schwammerlsucher kennen die Plätze, wo es ganz bestimmte Speisepilze gibt.
Das Reich der Pilze
Pilze werden in der Biologie weder zu den Tieren noch zu den Pflanzen gezählt. Sie haben vor sehr langer Zeit eine eigene Entwicklungslinie gebildet. Man spricht vom Reich der Pilze.
2 Pilze haben Zellwände – ähnlich den Pflanzen. Allerdings ist bei den Pilzen Chitin in den Zellwänden eingelagert.
2 Da Pilze kein Chlorophyll besitzen und daher keine Fotosynthese betreiben können, ernähren sie sich wie die Tiere von organischem Material.
Pilze vermehren sich durch Sporen

Abb. 2: Bau und Vermehrung eines Pilzes
Speisepilz, der: Pilz, den man essen kann


Pilze sind eine sehr große Gruppe von Lebewesen. Was von manchen Menschen als Pilz bezeichnet wird, ist nur der sichtbare Teil, der sogenannte Sporenträger oder Fruchtkörper, einer ganz bestimmten Pilzart. Umgangssprachlich wird er häufig auch „Schwammerl“ genannt. Der eigentliche Pilzorganismus wächst aber unter der Erdoberfläche
Nur ein kleiner Teil der Pilze bildet solche Sporenträger aus. Aber fast alle vermehren sich durch Sporen. Wenn diese auf einen geeigneten feuchten und nährstoffreichen Untergrund gelangen, wachsen sie zu Fäden oder Hyphen aus. Sie wachsen immer weiter und bilden ein dichtes Geflecht aus weißen Fäden. Dieses Pilzgeflecht wird Myzel genannt und durchzieht den Boden.
Das Myzel nimmt Wasser, Mineralsalze und Nährstoffe auf und kann viele Jahre im Boden leben. Es ist der eigentliche Pilz.
Ungeschlechtliche Vermehrung
Viele Pilze vermehren sich ausschließlich ungeschlechtlich. An den Enden des Myzels werden Sporen gebildet, die dann abgeschnürt werden.
Die meisten Pilze können sich auch dadurch vermehren, dass sich das Myzel teilt. Dann wachsen beide Teile des Myzels selbständig weiter.

4: Abschnüren von Sporen eines Pinselschimmels
Erinnere dich! Bei welchen Lebewesen hast du Chitin schon kennengelernt?

5μm
Abb. 3: Hefepilze bestehen aus nur einer Zelle. Sie vermehren sich durch Teilung.
abschnüren: an einer Stelle immer dünner werden
Besorge dir in einem Lebensmittelgeschäft Speisepilze, beispielsweise Champignons! Welchen Teil des Pilzes hast du da gekauft? Schneide einen der Länge nach durch und versuche, was du siehst, zu benennen! Danach kannst du ein leckeres Gericht zubereiten!
Lamellen

Abb. 5: a) Vergleiche den Pilz mit einer Pflanze! Welches Organ der Pflanze entspricht welchem Teil des Pilzes? Haben sie dieselben Aufgaben?
b) Erläutere, was das wesentliche Merkmal von geschlechtlicher Fortpflanzung ist!
Wodurch unterscheidet sie sich von der ungeschlechtlichen?

Abb. 7: Pilzmyzel im Boden
Überlegt, worauf man beim Sammeln von Pilzen achten muss, damit wieder neue Pilze wachsen! Verfasst eine Handlungsanweisung für Pilzsammler!
Was denkst du?
Weshalb haben Pilze im Laufe der Evolution Kappen ausgeformt, unter denen sie ihre Sporen ausbilden?
Diskutiere das mit einem Sitznachbarn, deiner Sitznachbarin! Notiert eure Gedanken!
Sporenständer
Sporen
Die Pilze, die wir als Schwammerl kennen, sind Ständerpilze. Bei diesen entstehen die Sporen an so genannten Sporenständern. Die meisten Ständerpilze bilden einen Stiel und einen Hut. Die Sporenständer sitzen an der Hutunterseite.
Abb. 5: Sporenständer an Ständerpilzen
Die geschlechtliche Vermehrung bei Pilzen verläuft in mehreren Schritten:


Sporen
reifer Fruchtkörper
Sporen werden gebildet

Myzelien verbinden sich Hyphen Lamellen
Sporen keimen Myzel wächst



Abb. 6: geschlechtliche Vermehrung von Pilzen
1. Sporen fallen auf den Boden.
2. Die Sporen beginnen zu keimen. Pilzmyzel entsteht und wächst.
3. Myzelien, die aus unterschiedlichen Sporen entstanden sind, können sich miteinander verbinden. Es kommt zu einem Austausch der Zellkerne beider Myzelien.
4. Aus den verschmolzenen Myzelien wächst der Fruchtkörper . Er besteht aus Pilzfäden, den Hyphen. Im Fruchtkörper verschmelzen die Zellkerne miteinander und es kommt zu einem Austausch der Erbinformation. An den Sporenständern entstehen Sporen, die Erbinformation von beiden Myzelien enthalten.
5. Sobald die Sporen reif sind, fallen sie zu Boden. Der Kreislauf beginnt erneut.
Das Myzel kann sehr lange im Boden leben und wachsen, ohne dass ein Fruchtkörper gebildet wird. Die Bildung geschieht im Allgemeinen sehr rasch und erfordert sehr viel Energie.
Das Pilzmyzel muss in kurzer Zeit sehr viel Material bilden. Daher geschieht dies nur, wenn die Bedingungen günstig sind, also genug Nährstoffe und Wasser zur Verfügung stehen.
5 1 2 3 4
Da fehlt ja einiges! Beschrifte die Abbildung und ergänze die Zeichnung!









Ordne die Begriffe richtig zu, indem du die Nummern in die richtigen Felder einträgst!
1 Ständerzelle Pilzfäden
2 Hyphen Pilzgeflecht unter der Erde
3 Lamellen oberirdischer Teil vieler Pilze
4 Fruchtkörper Form der Hutunterseite
5 Stiel hier werden die Sporen gebildet
6 Myzel Der Fruchtkörper besteht aus dem Hut und dem …
Beschreibe in deinem Heft mit eigenen Worten, wie sich Pilze geschlechtlich vermehren! Verwende dazu diese Fachwörter der Reihe nach!
Sporen D keimen D Pilzmyzel D Austausch Zellkerne D Fruchtkörper wächst D Hyphen D Austausch Erbinformation D Sporenständer D reif

Bei der geschlechtlichen Vermehrung von Pilzen fallen zuerst...
Frage für Schlaumeier: Hat ein Pilz Wurzeln? JA NEIN
Schimmelzucht! Nimm ein Stück Brot oder Obst und befeuchte es etwas! Lege es dann in einen abgeschlossenen Behälter und lasse einige Tage vergehen! Warte, bis sich ein pelziger Flaum gebildet hat! Tupfe mit dem Finger leicht darauf. Was kannst du beobachten? Was ist das, was da auf deinem Finger haftet? Kannst du damit den Versuch wiederholen, so dass alles schneller geht? Probiere es aus! Finde Gründe für das Beobachtete und schreibe sie auf!
Betrachte alles genau unter einer Lupe! Was kannst du erkennen? Notiere es!

Abb. 1: Die Hutunterseite des Parasols zeigt die Lamellen.


Abb. 4: Habichtspilz (Stachelpilz): Seine Sporen werden auf Stacheln gebildet.


Abb. 7: Schmetterlingsporling (Porling): Er baut das Holz abgestorbener Bäume ab. Die Sporen werden in Poren gebildet.

Weltweit haben sich etwa 30 000 unterschiedliche Arten von Ständerpilzen entwickelt. Sie werden in mehrere Gruppen eingeteilt, die sich voneinander durch ihre Sporen bildende Schicht unterscheiden.
Je nachdem, wie die Unterseite des Pilzhutes aussieht, sprechen wir von Blätterpilzen, Röhrenpilzen, Stachelpilzen, Porlingen und Leistenpilzen.
Blätterpilze
Der Parasol ist ein beliebter Speisepilz. Er hat eine zu Blättern (Lamellen) gefaltete Hutunterseite, welche die Oberfläche vergrößert. Hier werden die Sporen gebildet. Auch der Champignon bildet seine Sporen an den Lamellen.

2: Parasol

3: Wiesen-Champignon
Zu den Blätterpilzen gehören auch der giftige Fliegenpilz und der giftige Grüne Knollenblätterpilz.




10: Hutunterseite Herrenpilz giftig! giftig!



Notrufnummern: 144, 112

Bei dieser Gruppe von Pilzen werden die Sporen in kleinen Röhren an der Unterseite des Pilzhutes gebildet. Zu den Röhrenpilzen gehören z. B. der Maronenröhrling und der Herrenpilz. Beide sind sehr beliebte Speisepilze.

8: Maronenröhrling

9: Herrenpilz
Gefährliche Doppelgänger
Wer Pilze sammelt, weiß auch, dass viele Pilze giftige Doppelgänger haben. Es gibt aber sichere Unterscheidungsmerkmale, die man unbedingt kennen muss.
Die Verwechslung von Wiesen-Champignon und Knollenblätterpilz hat oft tödliche Folgen. Das Gift des Knollenblätterpilzes wirkt erst 8 bis 10 Stunden, nachdem der Pilz gegessen wurde. Oft kommt dann jede Hilfe zu spät. Man kann diese beiden Pilze aber gut unterscheiden.
Wiesen-Champignon: Nicht giftig

Grüner Knollenblätterpilz: Giftig

Er hat rosa oder dunkelbraune Lamellen. Der Wiesen-Champignon hat keine Knolle.

giftig!

Doppelgänger, der: sieht jemand anderem sehr ähnlich
Diese Pilze werden gerne gesammelt:



Er hat immer weiße Lamellen. Der Stiel des Knollenblätterpilzes ist am unteren Ende in der Erde zu einer Knolle verdickt, die auch noch von einer Hülle umgeben ist.
Auch der gut schmeckende Steinpilz hat einen giftigen Doppelgänger, den Satanspilz

Stein- oder Herrenpilz: Nicht giftig

Er hat eine weiße Unterseite. Ist er älter, wird seine Röhrenschicht gelb bis grün.
Satanspilz: Giftig



Abb. 12: Eierschwammerl (Pfifferling) gehören zu den Leistenpilzen

Er hat einen rötlichen Stiel und eine rötliche Hutunterseite


Giftig oder nicht? Manche Pilze können von einer Person jahrelang gegessen werden, ohne dass Vergiftungen auftreten. Eine andere Person jedoch kann bereits nach dem ersten Mal essen eine Vergiftung erleiden.
Bist du nicht sicher, ob ein Pilz essbar ist, lass ihn stehen! Auch giftige Pilze sind wichtige Glieder im Nahrungsnetz des Waldes. Sie dürfen daher nicht mutwillig zerstört werden.
Schlauchpilz, der: unterscheidet sich von den Ständerpilzen durch die Art der Fortpflanzung

Abb. 13: Die Trüffel ist ein Schlauchpilz und wächst unterirdisch im Boden.

Abb. 15: Schwein auf der Jagd nach Trüffel

Abb. 16: Shiitake-Pilze werden vor allem in der asiatischen Küche verwendet.
Besuche verschiedene Lebensmittelgeschäfte und notiere, welche Arten an Pilzen sie zum Kauf anbieten! Wird das von der Jahreszeit abhängen? Frage beim Personal! Wenn nicht, woran könnte das liegen?
Vergleiche die Zucht von Gemüsepflanzen und Pilzen! Was ist der wesentliche Unterschied?
Der Begriff „Speisepilz“ ist kein biologischer Begriff, sondern bezeichnet den Fruchtkörper eines Pilzes, der für den Menschen genießbar ist und zur Zubereitung von Speisen verwendet wird. Die meisten Speisepilze gehören zur Gruppe der Ständerpilze. Manche wie die Morchel oder die Trüffel gehören aber auch zu den Schlauchpilzen.
Pilze enthalten kaum Fett und Kohlenhydrate, daher haben sie nur einen geringen Nährwert. Sie enthalten jedoch viel Eiweiß, Vitamine und Mineralstoffe. Da sie als Stützgewebe Chitin enthalten, sind sie teilweise schwer verdaulich.
Die wenigsten Pilze können roh verzehrt werden. Sie müssen ausreichend erhitzt werden, damit sie genießbar werden. Pilze sollten auch rasch verarbeitet und gegessen werden, da sich ihr Eiweiß schnell zersetzt und ungenießbar oder sogar giftig werden kann.
Der Geschmack von Pilzen kann sehr unterschiedlich sein. Daher gibt es eine Unzahl an Pilzgerichten. Manche Pilze wie die Trüffel geben schon in kleinsten Mengen einer Speise ihren typischen Geschmack.
Die meisten Pilze bilden nur in ihrer natürlichen Umgebung Fruchtkörper aus und können daher nicht gezüchtet werden. Zu den Pilzen, die gezüchtet werden können, gehören der Champignon und der Shiitake-Pilz
Pilze sammeln

Die meisten Pilze können nur dort gesammelt werden, wo sie natürlich wachsen. Meist ist das in einem Wald. In Österreich dürfen überall Pilze gesammelt werden, wenn das vom Waldbesitzer nicht ausdrücklich verboten wird. Allerdings ist die Menge beschränkt. So darf man höchstens 2 kg pro Tag mitnehmen.
Manche Pilze zählen zu den bedrohten Arten und stehen auf der Roten Liste. Diese dürfen daher nicht gepflückt werden. Beim Pilze sammeln solltest du einige Regeln beachten:
D Sammle nur Pilze, die du wirklich kennst!
D Lasse deine gesammelten Pilze immer von einem erfahrenen Pilzsammler oder einer Pilzsammlerin kontrollieren, bevor du sie isst! Die Unterschiede sind oft schwer zu erkennen. Auch ist es schwierig, Pilze mit Hilfe eines Pilzbuches zu bestimmen.
D Fraßspuren von Tieren bedeuten nicht, dass auch der Mensch die Pilze verträgt.
D Pilze gehören in einen Korb! Transportiere sie nicht in einem Plastiksackerl. Da es dort warm und feucht ist, verderben sie rasch.
D Pilze müssen am selben oder spätestens am nächsten Tag verarbeitet werden!
Erinnere dich! Was ist die „Rote Liste“? Wie ist mit Lebewesen umzugehen, die auf so einer Liste stehen? Diskutiert, wie man das sicherstellen könnte!

D Pilzspeisen dürfen nicht aufgewärmt werden! Sie können giftig werden.
D Wird dir nach einem Pilzgericht schlecht – sofort ins nächste Krankenhaus!
Notrufnummern: österreichische Rettung 144 oder europäischer Notruf 112
Mache einen Waldspaziergang und notiere dabei die Namen der Pilze, die du siehst! Tipp: Der Informationstext hilft dir, die richtigen Pilznamen zu finden.




















Der Fliegenpilz lebt in Symbiose mit Bäumen. Manche Pilze wie der Parasol bilden einen Kreis. Man sagt dazu Hexenring. Der Hallimasch und der Schmetterlingsporling zersetzen Holz. Der Herrenpilz ist ein Röhrenpilz. Baumschwämme schaden dem Baum.
Achtung – Doppelgänger! Welche Pilze sind essbar und gehören tatsächlich in den Korb? Zeichne zuerst einen Pfeil zum Korb, wenn der Pilz genießbar ist! Dann ordne die Namen der Pilze richtig zu!



3 4















genießbar: nicht genießbar: verschiebbar fest






Lies zunächst den Informationstext, dann betrachte die beiden Pilze! INFO: Für die meisten tödlichen Pilzvergiftungen ist bei uns der Grüne Knollenblätterpilz verantwortlich. Mehrere Stunden nach dem Verzehr treten die ersten Symptome wie Brechdurchfälle auf. Der Parasol ist dagegen ein beliebter Speisepilz. Wenn dieser jedoch noch klein ist, kann man ihn leicht mit dem Grünen Knollenblätterpilz verwechseln.

Stelle nun fest, ob sich die Merkmale auf den Parasol oder den Grünen Knollenblätterpilz beziehen! Kreuze dazu an! ACHTUNG: Ein Merkmal findet sich bei beiden Pilzen.
Parasol Grüner Knollenblätterpilz
Der Pilz besitzt einen verschiebbaren Ring.
Der Hut ist mit bräunlichen Schuppen bedeckt.
Am Stiel befindet sich eine Manschette.
Die Knolle wird von einer Scheide wie von einer Schale umgeben.
Der lange Stiel endet in einer Knolle, die nicht von einer Scheide umgeben ist.
Beide Pilze gehören zu den B_______________- oder L_________________pilzen.
Pilze können sich nicht selbst ernähren



Wie du schon gehört hast, können Pilze keine Fotosynthese betreiben und daher die Nährstoffe, die sie benötigen, nicht selbst herstellen. Unterschiedliche Pilze nutzen unterschiedliche Methoden, um an ihre Nährstoffe zu kommen.
Symbionten: Fast alle Pilze, die du im Wald findest, brauchen zum Wachsen die Wurzeln der Bäume. Diese Pilze leben mit dem jeweiligen Baum in einer Symbiose. Auch Zwergsträucher in Mooren bilden mit Pilzen Symbiosen. Der Birkenpilz, der ein schmackhafter Speisepilz ist, ist ein solcher Symbiont. Mit den Wurzeln der Birke geht er eine Symbiose ein. Seine Pilzfäden liefern den Baumwurzeln Wasser und Mineralsalze aus dem Boden. Diese feinen Pilzfäden können in Hohlräume eindringen, die sonst dem Baum nicht zugänglich wären. Dafür liefert der Baum dem Pilz organische Nährstoffe.
Fäulnisbewohner und Destruenten: Andere Pilze ernähren sich von toten Tieren und abgestorbenen Pflanzen. Manche von ihnen lassen auch Nahrungsmittel verschimmeln. Da einige Schimmelpilze als krebserregend gelten, sollst du auf keinen Fall verschimmelte Nahrungsmittel essen.
Schmarotzer/Parasiten: Pilze wie die Baumschwämme holen sich ihre Nahrung von anderen Lebewesen. Der Hallimasch wächst in Büscheln an Baumstümpfen. Sein Myzel durchzieht die Wachstumsschicht von Baumstämmen und holt sich dort die Nahrung. Da er auch lebende Bäume befällt, kann er im Wald großen Schaden anrichten.
Im Boden wird organisches Material zersetzt. Das geschieht durch tierische Kleinlebewesen, Bakterien und Pilze. Vor allem der Abbau von Holz wäre ohne Beteiligung von Pilzen nicht möglich. Beim Abbau werden Mineralsalze frei, die Pflanzen wieder als Nährstoffe zur Verfügung stehen.
Die Mischung aus organischem Material, den Lebewesen, die dieses zersetzen und den Abbauprodukten nennt man Humus. Durch die Humusbildung schließt sich der Stoffkreislauf im Boden

Abb. 2: Pilzmyzel (rot) dringt in eine Baumwurzel.
Abb. 2: Begründe, warum man viele Pilze nicht züchten kann! Was fehlt bei der Zucht in einem geschlossenen Raum?
Erkläre, was eine Symbiose ist! Was ist der Unterschied zwischen einem Symbionten und einem Schmarotzer? Wo befinden sich Pilze in der Nahrungspyramide? Lässt sich das so einfach sagen, oder ist dieses Modell dafür nicht gut geeignet? Diskutiert in Kleingruppen!

Abb. 5: Pilze zersetzen totes Holz.
Antibiotikum, das: Medikament, welches das Wachstum von kleinsten Organismen hemmt oder diese abtötet
Erörtere die Bedeutung von Antibiotika für den Menschen! Schreib einen kurzen Blog-Beitrag darüber!

Abb. 7: Schimmelpilz an der Wand: Seine Sporen können auch Krankheiten hervorrufen.

Abb. 9: Schimmelkäse wird mit Hilfe von Pilzen hergestellt.
Stelle eine Vermutung an, woher die Flechte ihr Wasser bekommt! Weshalb hat sie keine andere Möglichkeit?
Beschreibe, wie Flechten einen Lebensraum neu besiedeln und ihn für andere Pflanzen bewohnbar machen können!

Erfahre hier mehr über Flechten als Nahrung!
Der unscheinbare Schimmelpilz in Abbildung 6 ist dafür verantwortlich, dass heute viele Krankheiten geheilt werden können. Er erzeugt einen Giftstoff, der Bakterien abtötet, damit er sich auf seinem Untergrund ungehindert ausbreiten kann. Dieser Giftstoff kann aus dem Pilz gewonnen werden. Als Antibiotikum tötet er Bakterien im Körper ab. Auch viele andere Medikamente werden aus Pilzen gewonnen.

Abb. 6: Der Schimmelpilz Penicillium chrysogneum.
Pilze spielen auch eine wichtige Rolle bei der Herstellung von Lebensmitteln
Hefepilze bringen zuckerhaltige Flüssigkeiten zum Gären und erzeugen Alkohol. Andere Pilze sind für die Herstellung von Milchprodukten erforderlich.
Vielleicht hast du schon einmal solche Flecken wie in Abbildung 8 auf Steinen gesehen. Dabei handelt es sich um Flechten

Flechten sind eine Symbiose zwischen Pilzen und Algen oder Bakterien. Algen sind Pflanzen und können daher Fotosynthese betreiben. Das Pilzmyzel kann die Algen berühren, umschließen, oder dringt in die Algen ein. Es schützt die Algen, beispielsweise vor dem Austrocknen. Die Algen erzeugen bei der Fotosynthese Nährstoffe, die der Pilz zum Wachsen benötigt.
Abb. 8: Krustenflechte auf Steinen
Flechten bilden Säuren, mit denen sie ihren Untergrund angreifen und langsam auflösen. So tragen Flechten zur Verwitterung von Gestein bei. Sie können neue Lebensräume als erste besiedeln und schaffen die Lebensgrundlage für andere Lebewesen, die sich danach einfinden. Da sie aber sehr langsam wachsen, werden sie meistens verdrängt, wenn neue Pflanzen in den neuen Lebensraum vordringen. Viele Flechten sind sehr empfindlich gegenüber Luftverschmutzung. Ihr Absterben kann als Warnzeichen dafür dienen, dass sich die Luftqualität in einer Gegend verschlechtert.
Wenn Flechten längere Zeit kein frisches Wasser erhalten, trocknen sie aus. Sie fallen in eine Trockenstarre, in der sie extreme Umweltbedingungen überdauern können. Fällt wieder Regen, nehmen sie ihren Stoffwechsel wieder auf.
Flechten haben Eigenschaften und Lebensweisen, die ganz anders sind als die der Algen und Pilze, aus denen sie bestehen. Sie bilden auch völlig neue Formen.
Abb. 10: Das Isländische Moos ist eine Flechte, die in Strauchform wächst.

Ordne die Begriffe einander richtig zu, indem du sie mit derselben Farbe anmalst!


Antibiotikum



Parasit Lebensgemeinschaft

Schmarotzer


Medikament

Flechte
Symbiose Pilz + Alge

Pilzgeflecht

Lies diesen Informationstext über Pilze aufmerksam! Dann kreuze richtig an!
INFO: Pilze reagieren sehr empfindlich auf biologische Veränderungen des Bodens und des Klimas. Abgase, Abwässer, Gifte in der Landwirtschaft und Kunstdünger gelangen in den Boden und schädigen das Pilzmyzel. Auch Veränderungen des Bodens durch Verbauung oder durch das Arbeiten mit schweren Maschinen, die den Boden verdichten, wirken sich auf das Pilzwachstum aus. Pilze speichern auch Schadstoffe wie Schwermetalle oder verschiedene radioaktive Stoffe, die wir zu uns nehmen, wenn wir Pilze essen. Allerdings sind die Mengen meist zu gering, um beim Menschen Schäden hervorzurufen. Pilze speichern... radioaktive Stoffe. Schwermetalle. Sauerstoff. Pilze werden geschädigt durch... Kohlenstoffdioxid. Abwässer. Bodenverdichtung. Pilze reagieren auf... Klimaveränderungen. Geräusche. Bodenveränderungen.
Wie entstehen Hexenringe? Lies die Erklärungen und kreuze jene an, die deiner Meinung nach richtig ist! Begründe zum Schluss auch noch deine Auswahl!

Manchmal wächst das Pilzmyzel nicht gerade, sondern hat eine geringfügige Verzerrung nach links oder nach rechts. Daher wächst es mit der Zeit im Kreis. Fällt dann Regen und passt die Temperatur, entstehen aus diesem Kreis die Fruchtkörper.

Das Pilzmyzel wächst von einem Punkt aus in alle Richtungen gleich schnell und bedeckt daher eine kreisförmige Fläche. Wenn im Inneren die Nährstoffe erschöpft sind, stirbt das Myzel dort ab und es bleibt ein Ring übrig. Bei günstigen Bedingungen wachsen dort Fruchtkörper.


Hexenringe sind das Ergebnis von Halloween-Scherzen. Werden in der Nacht die Pilzsporen kreisförmig ausgestreut, dann wachsen in der Folge auf diesen Kreisen Pilze. Man könnte die Sporen natürlich auch in anderer Form ausstreuen.

BEGRÜNDUNG:
Das Reich der Pilze ist ungeheuer faszinierend und Biologinnen und Biologen beginnen viele Dinge erst zu verstehen. Pilze bilden große Netzwerke, in die oft auch andere Lebewesen mit eingebunden sind. Dadurch entstehen vielseitige Wechselwirkungen in Lebensräumen, die intensiv erforscht werden müssen, um die Rolle von Pilzen vollständig zu verstehen.
Pilze stellen eine große Zahl von chemischen Stoffen her, die für den Menschen interessant sind, beispielsweise in der Medizin und zur Schädlingsbekämpfung. Aktuelle Forschung und Entwicklung beschäftigt sich mit dem Einsatz von Pilzen zur Herstellung von Biotreibstoff, Kunststoffen, Fleischersatzprodukten und Textilien. Vielseitige und zukunftsträchtige Betätigungsfelder für Biologinnen und Biologen.


Hefe beim Verdauen beobachten! Hefepilze müssen wie alle Lebewesen Nahrung aufnehmen. Beim Verwerten dieser Nahrung entsteht Kohlendioxid.
Du brauchst: Hefe aus dem Supermarkt, Zucker, eine Flasche, eine Schüssel, einen Luftballon, einen Teelöffel und warmes Wasser in einer Schüssel.
Führe folgenden Versuch durch!
Gib die Hefe und zwei bis drei Teelöffel Zucker in die Flasche! Gib dann ein paar Teelöffel warmes Wasser dazu! Stecke den Ballon auf die Flasche und stelle diese in die Schüssel! Lass Zeit vergehen und beobachte was geschieht!
Was kannst du beobachten? Finde eine Erklärung dafür! Wiederhole das Experiment mit kaltem und heißem Wasser, sowie ohne Zucker. Notiere deine Ergebnisse und Schlussfolgerungen, die du daraus ziehen kannst! Weshalb wird Hefe beim Backen verwendet?
2
Erstelle einen Sporenabdruck! Du kannst Pilzsporen selbst gewinnen. Wichtig ist, dass sich der Hut des Pilzes schon geöffnet hat, denn erst dann hat er schon Sporen gebildet.
Du brauchst: Einen Pilz mit geöffnetem Hut (z.B. aus dem Supermarkt), ein Stück Papier oder Alufolie, ein Glas oder eine Schüssel.
Führe folgenden Versuch durch!
Drehe, oder schneide den Stiel des Pilzes knapp unterhalb des Hutes ab! Lege den Hut auf das Papier, bzw. die Alufolie! Stelle das Glas oder die Schüssel darüber! Warte 6h – 24h! Hebe das Glas und den Pilzhut vorsichtig hoch! Die Sporen sollten aus dem Hut gefallen sein.
Tipp: Manche Pilze ergeben schöne Sporenbilder. Du kannst sie mit Haarspray fixieren!






So schätze ich mich nach dem Großkapitel DAS REICH DER PILZE selbst ein: Kreuze jenen Daumen an, der für dich am ehesten zutreffend ist!
…erklären, was Speispilze sind.
…begründen, warum Pilze weder Tiere noch Pflanzen sind.
…die Vermehrung von Pilzen durch Sporen beschreiben.
…wiedergeben, was ein Ständerpilz ist und diese erkennen.
…Pilzmyzel und Fruchtkörper voneinander unterscheiden.
…die unterschiedlichen Gruppen von Ständerpilzen aufzählen, beschreiben und miteinander vergleichen.
…die wichtigsten heimischen Schwammerlarten beschreiben.
…giftige von ungiftigen Pilzen unterscheiden.
…beschreiben, wie Pilze verarbeitet werden müssen, damit man sie essen kann.
…begründen, warum die Regeln beim Sammeln von Pilzen sinnvoll sind.
…die Vorteile der Symbiose von Pilzen und Pflanzenwurzeln analysieren.
…Pilze als Verursacher von Fäulnis erkennen.
…erklären, wie sich Pilze als Schmarotzer ernähren.
…die Funktion von Pilzen als Humusbildner erklären.
…beschreiben, was Flechten sind.
…die Bedeutung von Pilzen für die Produktion von Medikamenten und Lebensmitteln erörtern.
Um deine Kompetenzen noch mehr zu steigern, hier unsere Buchtipps:
Robert Hofrichter: Das geheimnisvolle Leben der Pilze: Die faszinierenden Wunder einer verborgenen Welt (Gütersloher Verlagshaus, 2017).
Bärbel Oftring, Tanja Böhning: Welcher Pilz ist das? Kindernaturführer: 85 heimische Pilzarten entdecken (Franck-Kosmos Verlags-GmbH, 2022).
Heike Hermann: WAS ist WAS: Pilze, Band 33 (Tessloff Verlag, 2006)










Abb. 1: Analysiere, wie die einzelnen Faktoren die Lebensverhältnisse in einem Ökosystem beeinflussen! Finde auch Beispiele für Tierund Pflanzenarten, die von diesen Faktoren abhängig sind!
Wählt zu zweit einen abiotischen Faktor aus! Dann erörtert, wie sich dieser Faktor durch den Einfluss des Menschen verändern könnte und welchen Einfluss diese Veränderung auf das Ökosystem hätte!

Abb. 2: Eule mit ihrer Beute – einer Maus

Der Wald ist Heimat für viele verschiedene Lebewesen. So bilden Tiere, Pflanzen und Pilze des Waldes – die belebte Natur – eine Lebensgemeinschaft. Sie wird in der Biologie auch Biozönose genannt. Aber auch die unbelebte Umwelt mit ihren Umweltfaktoren wie Temperatur, Klima, Wasser und Licht, die Biotop genannt wird, hat großen Einfluss auf die Tiere und Pflanzen des Waldes. Biozönose und Biotop bilden zusammen ein Ökosystem.
Abiotische und biotische Faktoren
Jedes Ökosystem ist einzigartig, weil die Faktoren, die es ausmachen, immer unterschiedlich sind. Es gibt...


Biologisches
Gleichgewicht – ein Beispiel
Du weißt – Eulen fressen Mäuse. Wenn die Mäuse genügend Nahrung finden, vermehren sie sich stark und ihre Anzahl wächst. Dadurch können auch die Eulen viele Junge ernähren. Viele Eulen fressen viele Mäuse, dadurch sinkt die Zahl der Mäuse. Dann können die Eulen nicht alle Jungen ernähren, sodass einige verhungern. So regeln die Gejagten die Zahl der Jäger. Das biologische Gleichgewicht ist wiederhergestellt.
Abb. 1: Ökosystem mit seinen Einflussfaktoren
Abiotische Faktoren: Das sind unbelebte Umweltfaktoren wie Lichteinfall, Feuchtigkeit und Niederschlagsmenge, Boden- und Lufttemperatur sowie Beschaffenheit des Bodens beziehungsweise sein Nährstoffgehalt.
Biotische Faktoren:
Das sind Umweltfaktoren, an denen Lebewesen beteiligt sind wie etwa Konkurrenz bei der Nahrungssuche, Fressfeinde, Symbiosen oder Parasitismus.
Ökologische Nischen und biologisches Gleichgewicht
Abiotische und Biotische Faktoren bestimmen ein Ökosystem. Aber auch innerhalb eines Ökosystems können einzelne Faktoren für ein Tier unterschiedlich wichtig sein. Denn jedes Tier hat unterschiedliche Bedürfnisse und Lebensgewohnheiten:
2 Sie suchen unterschiedliche Plätze auf, um zu schlafen und zu nisten.
2 Sie fressen unterschiedliche Nahrung oder suchen sie an unterschiedlichen Orten.
2 Manche sind am Tag, andere in der Nacht aktiv.
Daher können sie nebeneinander leben und behindern einander kaum. Innerhalb eines Ökosystems hat jede Tier- und Pflanzenart eine bestimmte Aufgabe, die sich von den Aufgaben anderer Arten unterscheidet. So können verschiedene Arten zusammenleben, da jede Art eine eigene ökologische Nische nutzt. Eine ökologische Nische ist die Funktion, also die Aufgabe oder Rolle, die eine Art in diesem Lebensraum hat. In einem Ökosystem wie z. B. einem Wald herrscht ein biologisches Gleichgewicht, wenn viele unterschiedliche Arten nebeneinander existieren können und sich der Zustand des Ökosystems ohne Störungen nicht verändert. Langfristige Schwankungen des biologischen Gleichgewichts werden ausgeglichen.
Du hast bereits einiges über den ökologischen Kreislauf in einem Ökosystem erfahren. Die Abbildung zeigt dir den Aufbau eines ökologischen Kreislaufs im Ökosystem Wald:
1. Pflanzen erzeugen mit Hilfe der Sonne Nährstoffe, die sie zum Leben brauchen (Produzenten). Dabei verbrauchen sie Kohlenstoffdioxid.
2. Sie sind Nahrung für Pflanzenfresser (Konsumenten).
3. Diese wiederum sind Nahrung für Fleischund Allesfresser (Konsumenten). Konsumenten und Destruenten geben CO2 an die Atmosphäre ab.
4. Die Destruenten fressen und zersetzen tierische Ausscheidungen, tote Tiere, Laub und Totholz. Es entstehen Wasser, Kohlenstoffdioxid und Mineralsalze.
5. Mineralsalze werden von den Pflanzen aufgenommen und zusammen mit Wasser, Sonnenlicht und Kohlenstoffdioxid zur Herstellung von Nährstoffen benötigt. Auf diese Art und Weise schließt sich der Stoffkreislauf. Dabei geht nichts verloren.

Sonnenlicht
Produzenten, Erzeuger
Fotosynthese (Aufnahme von CO2)


Pflanzenfresser
Mineralstoffe

Destruenten, Zersetzer: manche Insekten, Würmer, Pilze, Bakterien (Abgabe von CO2)
Laub und Totholz


Konsumenten, Verbraucher
Atmung (Abgabe von CO2)
Abb. 3: ökologischer Kreislauf
Jeder Eingriff des Menschen stört den ökologischen Kreislauf. In Österreich legt die moderne Forstwirtschaft besonderen Wert auf eine nachhaltige Bewirtschaftung von Waldflächen. Der Mensch versucht also, den Wald so zu nutzen, dass die biologische Vielfalt (Tiere, Pflanzen und Pilze) erhalten bleibt und der ökologische Kreislauf funktioniert.
In einem naturnahen Wald gilt:
2 Es werden Bäume gepflanzt, die auch tatsächlich in diesem Gebiet heimisch sind.
2 Es wird darauf geachtet, dass neben alten Baumbeständen auch wieder junge Bäume wachsen können. So kommt es zu einer Waldverjüngung.
2 Es wachsen unterschiedliche Baumarten nebeneinander, die unterschiedliche Bedürfnisse haben.
2 Ein naturnaher Wald bietet vielen verschiedenen Tier- und Pflanzenarten einen Lebensraum.
Wälder, die ganz ohne Eingriffe des Menschen wachsen, bezeichnet man als ursprüngliche Wälder oder Urwälder. In diesen Urwäldern bleiben umgestürzte Bäume (Totholz) liegen. Dieses Totholz verrottet und wird schließlich zu Humus, der Mineralsalze für andere Pflanzen liefert. Es herrscht ein natürlicher Stoffkreislauf.
In Österreich gibt es kaum noch naturbelassene Urwälder. Der Rothwald im südlichen Niederösterreich ist mit 400 ha der größte davon. Er ist streng geschützt und darf nur für Forschungszwecke betreten werden.
Fleischfresser

Diskutiert in der Klasse, was passiert, wenn der Mensch dem Stoffkreislauf beständig Stoffe entzieht! Wie ist das in der Landund der Forstwirtschaft? Wie versucht der Mensch das auszugleichen?
nachhaltig: ein natürliches System ausschließlich so nutzen, dass es in seinen wesentlichen Eigenschaften erhalten bleibt
Suche einen Wald in deiner Nähe auf! Beurteile anhand der beschriebenen Merkmale, ob dieser Wald nachhaltig bewirtschaftet wird!

Abb. 4: Lage des Rothwaldes in Niederösterreich
ha: Hektar, Flächenmaß: 100 m x 100 m
km²: Quadratkilometer, Flächenmaß:
1 000 m x 1 000 m
geografische Höhe, die: Höhe über dem Meeresspiegel
gedeihen: wachsen
Recherchiert im Internet, welche Lebensbedingungen folgende Bäume brauchen: Buche, Eiche, Ahorn, Esche, Erle, Birke, Pappel, Fichte, Tanne, Kiefer. In welchen Gegenden könnten diese Bäume in Österreich beheimatet sein?
Von welchen Quellen stammen die gefundenen Informationen?
Findet mehr über diese Quellen heraus! Tipp: Teilt euch die Recherche auf, Teamwork gewinnt!
Abb. 5: Gib an, welche Waldtypen es in deinem Bundesland hauptsächlich gibt!
Österreich hat eine Fläche von rund 84 000 km2. Davon sind 39 000 km² mit, meist forstwirtschaftlich genutztem, Wald bedeckt. Damit gehört Österreich zu den waldreichsten Ländern Europas.
Der Boden, Temperatur, Verfügbarkeit von Wasser und Licht sowie die geografische Höhe haben Einfluss darauf, welche Bäume in einem Wald gedeihen. So gibt es in Österreich verschiedene Waldtypen, die mit Ausnahme des Auwaldes nach den dort vorherrschenden Bäumen benannt werden. Kann man keine Baumart feststellen, die hauptsächlich in einem Wald vorkommt, so spricht man von einem Mischwald
Auwald
Eichenwald, Eichen-Hainbuchen-Wald
Rotbuchenwald, Buchen-Mischwald
Föhrenwald
Buchen-Tannen-Fichten-Wald
Fichtenwald, Fichten-Tannenwald

Abb. 5: in Österreich vorherrschende Waldtypen




Abb. 6: Borkenkäfer und seine Fraßgänge
Die Zusammensetzung eines Waldes hängt stark von den abiotischen Faktoren ab. Ein Auwald entsteht entlang eines Flusses, der immer wieder über die Ufer tritt und das Gebiet des Waldes überschwemmt. Die Bäume, die dort wachsen, brauchen also einerseits einen feuchten Lebensraum. Sie müssen es aber andererseits auch aushalten, dass sie hin und wieder unter Wasser stehen. In tiefen Lagen findet man vorwiegend Laubbäume. Doch mit zunehmender geografischer Höhe werden Nadelbäume immer häufiger. Denn sie kommen mit dem rauen Klima in höheren Lagen besser zurecht.
Die meisten Wälder, die man heute in Österreich findet, sind Forste. Darunter versteht man Wälder, die vom Menschen bearbeitet werden, um Holz zu gewinnen. Es werden Baumarten gezielt ausgewählt, die möglichst rasch möglichst viel Holz produzieren. So wurden seit vielen Jahrzehnten vor allem Fichten angepflanzt.

Seitdem das Klima immer wärmer wird, treten bei diesen Bäumen aber immer mehr Schäden auf. Bei warmem trockenem Klima vermehren sich Borkenkäfer sehr stark. Diese Insekten können sich in Wäldern, in denen fast nur Fichten vorkommen, sehr rasch ausbreiten. Sie fressen Gänge in die Borken der Fichten. Nach einiger Zeit sterben die Bäume ab. Es ist zu erwarten, dass in den nächsten Jahren die österreichischen Fichtenwälder verschwinden werden.
Abb. 7: Schäden an Fichten durch Borkenkäfer im Mühlviertel (OÖ)
Studiere diese Karte mit den österreichischen Großlandschaften und vergleiche sie mit der Karte auf S. 75! Kreise dann ein, ob die Aussagen richtig oder falsch sind! Wenn du richtigliegst, ergeben die Buchstaben von unten nach oben gelesen ein Lösungswort, das du auch in diesem Kapitel findest.





Granit- und Gneishochland
Alpen- und Karpatenvorland
Alpen
Wiener Becken
Vorland im Osten und Südosten
Abb. 8: Österreichs Großlandschaften.
Du wirst in der dritten Klasse mehr darüber erfahren.

richtig falsch Föhrenwälder finden sich vor allem im Vorland im Osten und Südosten. E D
Auwälder gibt es vor allem entlang der großen Flüsse.
T R
Im Granit- und Gneishochland wachsen vor allem Buchen-Tannen-Fichten-Wälder. M H
Im Alpenvorland stehen Eichen- oder Eichen-Hainbuchen-Wälder. C U
Je höher das Gebirge, desto mehr Laubbäume gibt es. S I
Im nördlichen Teil der Alpen stehen Buchen-Tannen-Fichten-Wälder. F A
Teste dein Wissen! – Ordne die Wortgruppen dem jeweiligen Wald richtig zu!
Rothwald © natürlicher Stoffkreislauf © Fichten werden gepflanzt © von Menschen verändert © wächst ohne Eingriffe des Menschen © die meisten Wälder in Österreich



Entwickle ein Beispiel für ein biologisches Gleichgewicht in deinem Heft! Stelle dazu die Beziehung zwischen zwei unterschiedlichen Lebewesen in einem Ökosystem im Detail dar! Tipp: Orientiere dich am Beispiel auf S. 73!
Starte deine Waldexpedition!
Besuche Wälder in deiner Umgebung! Betrachte die Bäume genau und mache Notizen sowie Fotos! Gehe eine größere Runde, um sicher zu sein, dass du möglichst die gesamte Vielfalt des Waldes zu Gesicht bekommst!
Versuche im Internet durch den Vergleich mit Bildern herauszufinden, welche Bäume in den besuchten Wäldern wachsen!
Tipps:


• Vergleiche Blätter, Rinde und Wuchs und wenn möglich Blüten oder Früchte! Manchmal liegen noch Schalen oder ganze Früchte vom Vorjahr unter dem Baum verstreut!
• Finde zuerst durch geeignete Suchworte heraus, welche Bäume in den Wäldern Österreichs wachsen. Dann suche detailliertere Bilder dazu.
Falls du nicht so recht weiter kommst hier mögliche Startpunkte:






Du hast schon einiges über Ökosysteme und wie sie funktionieren, gelernt. Lies dir die folgenden Aussagen durch! Verbinde sie mit dem Text zu „Schäden im Wald“ auf Seite 65! Verknüpfe die Aussagen nach Ursachen und Wirkungen und formuliere einen Text zu deinen Schlussfolgerungen! Diskutiert in der Klasse!
„Haben die Borkenkäfer leichtes Spiel, vermehren sie sich explosionsartig.“

„Fichten sind Flachwurzler, ihre Wurzeln reichen nicht sehr tief in die Erde.“


„Fichten wachsen schnell. Das bedeutet mehr Holz in weniger Jahren und das ist gut für das Geschäft.“

„Ein funktionierendes Ökosystem braucht ein Gleichgewicht der Arten.“

„Fressfeinde des Borkenkäfers brauchen artenreiche Wälder, um sich zu verbreiten.“

„Unter Hitzestress und Trockenheit sind Bäume besonders anfällig für Schädlinge. Fotosynthese und Wassertransport funktionieren nicht mehr gut und schwächen die Bäume.“


Ein Mischwald ist ein Wald, in dem verschiedene Baumarten gemeinsam vorkommen. Es gibt verschiedene Arten von Mischwäldern:
Laubmischwald Nadelmischwald Laub-Nadelmischwald
Er besteht aus unterschiedlichen Arten von Laubbäumen.
Er besteht aus unterschiedlichen Arten von Nadelbäumen.

Laub- und Nadelbäume wachsen nebeneinander.
In einem Mischwald wachsen Pflanzen, die unterschiedlich hoch werden können.
Auch die Kronen der Bäume stehen weniger dicht beieinander. Dadurch kann das Sonnenlicht bis in tiefere Schichten vordringen, sodass auch dort Pflanzen wachsen können.
Abb. 1: Mischwald in Tirol. Achte auf die Baumarten. In Österreichs Wäldern ist vor allem die Rotbuche als Laubbaum heimisch.
Die Wurzeln der verschiedenen Pflanzen reichen unterschiedlich tief in den Boden hinein. Das hat viele Vorteile:
2 Die Wurzeln der Bäume halten bei starken Regenfällen die einzelnen Erdschichten besser fest.
2 Bei einem Sturm schützen Bäume, die sich mit ihren langen Wurzeln im Boden gut festhalten können, Bäume mit flachen Wurzeln vor dem Umfallen.
2 Wasser und verschiedene Mineralsalze aus allen Bodenschichten können genutzt werden.
Was ist eine Monokultur?
In Österreich wurden in der Forstwirtschaft früher häufig Fichten gepflanzt. In diesen Monokulturen wurden alle Bäume gleichzeitig gesetzt und waren daher ungefähr gleich groß. Das hat viele Nachteile:
2 Alle Bäume verbrauchen dieselben Mineralsalze und das Wasser aus ein und derselben Bodenschicht.

2 Fichten sind Flachwurzler. Ihre Wurzeln können den Baum im Boden nur schlecht verankern. Deshalb sind Fichtenmonokulturen anfällig für Sturmschäden. Stürzt eine Fichte um, beschädigt sie oft die Nachbar-Fichten oder reißt diese mit zu Boden.
2 Schädlinge breiten sich leichter aus, weil sie reichlich Nahrung finden.


Abb. 2: Vergleich von Mischwald (oben) und Monokultur (unten).
Abb. 2: Vergleiche die Zeichnungen! Welche Unterschiede kannst du benennen?
Abb. 3: Kannst du die Linien erkennen, entlang derer die Bäume gepflanzt wurden?


Abb. 4: Nachteile von Monokulturen: Sturmschaden; höhere Anfälligkeit für Schädlinge
Baumschicht
Strauchschicht
Krautschicht
Moosschicht
Bodenschicht
Abb. 5: Achte bei deinem nächsten Waldspaziergang auf die unterschiedlichen Stockwerke! Vergleiche, wieviel Sonnenlicht in die einzelnen Schichten vordringt und beurteile, wie sich das auf die Lebensbedingungen in den einzelnen Schichten auswirkt!
derb: grob
krautige Pflanze, die: Ihr Stängel enthält kein Holz.
Laubausbruch, der: Wachsen der Blätter im Frühling
besiedeln: bewohnen Entwickle eine Hypothese, welche Tiere aufgrund ihrer Lebensgewohnheiten in welcher Schicht leben!
Vielleicht ist dir bei einem Waldspaziergang schon einmal aufgefallen, dass der Wald aus verschiedenen Stockwerken besteht. Hohe Bäume wachsen neben Sträuchern und jungen Bäumen. Am Boden wiederum wachsen Farne und Moose.


Beschreibe die Lichtverhältnisse in einem Wald!

Alle diese Pflanzen sind unterschiedlich hoch. Die Biologin oder der Biologe spricht von den Schichten des Waldes
Ein gesunder Mischwald besteht aus der Baumschicht, der Strauchschicht, der Krautschicht, der Moosschicht und der Bodenschicht. In allen Schichten hat das Sonnenlicht eine besondere Bedeutung.
BAUMSCHICHT: Die Bäume der Baumschicht wachsen unterschiedlich hoch. Sie bekommen das meiste Sonnenlicht, müssen aber auch Regen, Schnee, Kälte und Sturm aushalten. Oft sind die obersten Blätter dieser Bäume kleiner und derber Sie haben festere Ränder und eine sehr widerstandsfähige Haut.
STRAUCHSCHICHT: Die Sträucher und jungen Bäume der Strauch-schicht erhalten nur noch wenig Licht.
KRAUTSCHICHT: Die krautigen Pflanzen blühen meist im Frühling, wenn die Bäume und Sträucher noch keine Blätter haben. So nützen auch sie das Sonnenlicht. In die Krautschicht gelangt nach dem Laubausbruch nur wenig Licht.
MOOSSCHICHT: Moose brauchen wenig Licht und speichern viel Wasser. Die Moosschicht entwickelt sich in Nadelwäldern besonders gut.
BODENSCHICHT: In dieser Schicht befinden sich die Wurzeln der einzelnen Pflanzen.
Jeder Platz im Wald – von der obersten Baumkrone bis zur kleinsten Wurzelspitze –wird, wie du bereits in den vorigen Kapiteln erfahren hast, auch von vielen verschiedenen Tierarten besiedelt
Laub- und Nadelbäume
Laubbäume gehören zu den Blütenpflanzen und Bedecktsamern, da ihre Samen in Fruchtknoten eingeschlossen sind. Laubbäume werfen im Herbst ihre Blätter ab. Zuvor wird das grüne Chlorophyll aus dem Blatt in den Ast zurückgezogen. Dadurch werden andere Farbstoffe sichtbar. Die Blätter verfärben sich rot und braun, bevor sie schließlich abfallen. Im nächsten Jahr werden die Blätter neu gebildet. Die abgeworfenen Blätter werden am Boden mit der Zeit zersetzt und damit ein Teil der vom Baum aufgenommenen Nährstoffe wieder dem Nährstoffkreislauf zugeführt. Der häufigste Laubwaldtyp in Österreich ist ein Mischwald aus Eiche und Buche. Die häufigste Eichenart ist die Stiel-Eiche. Sie wird bis zu 40 m hoch und kann ein Alter von bis zu 1 000 Jahren erreichen. Ihre Früchte sind die Eicheln. Die Buchenart, die bei uns heimisch ist, ist die Rotbuche. Sie wird bis zu 50 m hoch und bis zu 300 Jahre alt. Ihre Früchte nennt man Bucheckern.

Die Früchte von Eiche und Buche (Produzent) sind vor allem im Winter wichtige Nahrung für Waldtiere wie das Wildschwein (Konsument). Freistehende Bäume bilden breite Kronen, wie auf Abb. 6 zu sehen ist. Stehen die Bäume im Wald dicht beieinander, bilden sich hohe Stämme aus. Äste mit Laub findet man erst in großer Höhe. Nadelbäume zählen zu den Nacktsamern. Ihre Samenanlagen sind nicht in einem Fruchtknoten eingeschlossen, sondern liegen nackt auf den Fruchtblättern. Die Blätter der Nadelbäume sind die Nadeln. Sie sind widerstandsfähig gegen Kälte, Wind und starke Sonneneinstrahlung. Die meisten Nadelbäume, mit Ausnahme der Lärche, werfen ihre Nadeln im Winter nicht ab.




10: verholzte Fruchtblätter eines Kiefernzapfens, auf denen die Samen „nackt“ liegen

Der häufigste Nadelbaum in unseren Wäldern ist die Fichte Da sie rasch wächst, wird sie als Holzlieferant angepflanzt. Auch Weiß-Tannen wachsen bei uns im Wald. Sie weisen mehrere Unterscheidungsmerkmale zu Fichten auf. Fichtennadeln sind hart und spitz, während Tannennadeln weicher und am Ende abgerundet sind. Die Rinde der Fichten ist schuppenartig, mit rötlichem bis graubraunem Ton. Die der Tannen ist glatter und im Alter fast weißlich. Die Zapfen von Fichte und Tanne sind beide länglich. Doch hängen sie bei der Fichte nach unten und werden abgeworfen, während sie bei der Tanne nach oben wachsen und nur die Schuppen abfallen. Andere bei uns heimische Nadelbäume sind Wald- und Schwarz-Kiefer, die Europäische Lärche oder die Zirbe.
Abb. 11: immergrüne Fichte im Winter



Suche auf der InternetSeite www.baumkunde.de nach Informationen über einige der hier erwähnten Bäume! Verfasse einen Steckbrief!
Bestimme in einem Wald in deiner Umgebung einige Bäume! Vergleiche sie mit deinem Steckbrief! Kannst du ihn nun genauer verfassen?
Abb. 12: Blätter der Rotbuche. Die Blätter stehen abwechselnd am Zweig, sie sind wechselständig. Die Blätter bilden eine durchgehende Fläche, man nennt dies einfachen Blattaufbau. Ihre Grundform ist eiförmig. Die Form des Blattrandes wird als gezähnt bezeichnet.









Abb. 13: Blätter des Spitz-Ahorns. Die Blätter stehen paarweise gegenüber am Zweig, sie sind gegenständig. Der Blattaufbau ist einfach. Die Einbuchtungen der Blätter sind recht groß, man nennt den Blattrand gelappt. Die vereinzelten Spitzen werden als bogig gezähnt bezeichnet.




Abb. 14: Blätter der Stiel-Eiche. Die Blätter sind wechselständig, der Blattaufbau einfach. Die Blattform ist eiförmig. Die Form des Blattrandes wird als gebuchtet bezeichnet.




Abb. 15: Blätter der Esche. Die Blätter sind gegenständig. Ein Blatt teilt sich in mehrere komplett getrennte Teile, der Blattaufbau ist zusammengesetzt. Die Blattform nennt man gefiedert. Der Blattrand besteht aus eng stehenden Spitzen, man sagt gesägt.





Abb. 16: Nadeln der Fichte
Abb. 17: Nadeln der Weiß-Tanne
Der Auwald – ein Laubmischwald

Abb. 18: Auwald entlang eines Flusses
Fließgewässer, das: Fluss, Bach
Diskutiert über die Bedeutung von Auwäldern! Welche Vorund welche Nachteile bietet dieser Lebensraum?
Auwälder sind Laubmischwälder in der Nähe von Fließgewässern. Hier wachsen Pflanzen, die gut an den feuchten Lebensraum angepasst sind. Typische Bäume sind Silber-Pappel und Silber-Weide. Sie halten Überschwemmungen und einen hohen Wasserstand über längere Zeit aus. Mit jeder Überschwemmung verändert sich aber dieser Lebensraum. So wird Land vom Fluss weggespült und Flussschlamm lagert sich an manchen Stellen ab.
Bereiche des Auwaldes
Je nachdem, wie häufig ein bestimmtes Gebiet überflutet wird, gliedert sich der Auwald in unterschiedliche Bereiche: gehölzfreie Au, Weichholz-Au und Hartholz-Au.
Weichholz-Au gehölzfreie Au
Spitzenhochwasser
Hochwasser
Mittelwasser Niedrigwasser Tiere im Auwald
Säugetiere Dachs, Reh, Hirsch, Biber
Vögel Stockente, Höckerschwan, Graureiher
Insekten verschiedene
Schmetterlingsund Käferarten

Abb. 19: Bereiche des Auwaldes
Die gehölzfreie Au wird so häufig überschwemmt, dass sich dort keine Bäume halten können. Hier lagert sich auch regelmäßig Schlamm ab. Die Hartholz-Au wird nur sehr selten überflutet.
Die Au ist ein wichtiger Feuchtigkeitsspender und Wasserspeicher. Durch die weit verzweigten und unterschiedlich tief in das Erdreich hineinreichenden Wurzeln werden für das Niederschlagswasser Hohlräume geschaffen, in denen es versickern kann. Der Auwald hat positive Auswirkungen auf das Klima der Umgebung, da er Schwankungen der Temperatur und der Luftfeuchtigkeit ausgleicht. Außerdem sind Auwälder wichtige Erholungsräume für den Menschen.

Hollabrunn Mistelbach
Stockerau Gänserndorf
Werden Auwälder gerodet, geht auch der Wasserspeicher verloren. Führt der Fluss dann Hochwasser, werden die Gebiete, auf denen zuvor der Auwald gestanden hat, überschwemmt. In den letzten Jahren wurden dadurch immer wieder Siedlungen überflutet, sodass Menschen ihr Haus und ihren Besitz verloren haben.
In Österreich hat man erkannt, wie wichtig Auwälder sind. Deshalb wurden sie zum Teil unter Naturschutz gestellt. Der Nationalpark Thayatal und der Nationalpark Donau Auen sind Beispiele dafür.
Abb. 20: Nationalpark Thayatal, Nationalpark Donau Auen, Obere March Auen
1
Woher kommt das Sonnenlicht? Licht ist ein besonders wichtiger Faktor für den Pflanzenwuchs. Es ist verantwortlich für den Stockwerkbau des Waldes. Studiere zuerst die beiden Skizzen!
Dieser Baum steht alleine und bekommt von allen Seiten Licht.

Hier siehst du Bäume, die in einem Wald stehen und hauptsächlich von oben Licht erhalten.
Stiel Eiche Rotbuchen

Zeichne nun in die Abbildungen mit Pfeilen ein, woher jeweils das Sonnenlicht kommt!
2

3



















Ordne die Zeichnungen den Texten zu! Verfasse auch für das fehlende Beispiel einen passenden Satz! Überprüfe dann diese Hypothesen an Bäumen/Pflanzen deiner Umgebung!
______: Da das Licht nur von oben kommt, wachsen die Bäume ihm entgegen. Sie haben lange, astarme Stämme.
______: Nur am Waldrand sind die Bäume auf der dem Licht zugewandten Seite voller Äste.
Knifflige Fragen – Versetze dich in eine Biologin oder einen Biologen! Was würdest du antworten?

a) Warum wachsen, blühen und fruchten viele Pflanzen der Krautschicht so zeitig im Frühling?
Weil die

b) Wozu brauchen die Pflanzen das Licht?
Sie brauchen es
Die Beschriftung des Schaubildes bei einem Waldlehrpfad ist verblasst. Verfasse eine neue!


Die Stockwerke des Waldes
Welcher Fachausdruck passt zu welcher Aussage? Ordne richtig zu!
Hier wachsen die Wurzeln der Pflanzen.
Sie entwickelt sich besonders gut in Nadelwäldern.
Die Pflanzen bekommen das meiste Sonnenlicht.
Hierher fällt im Sommer schon sehr wenig Licht ein.
Viele Pflanzen blühen hier zeitig im Frühling.
Moosschicht
Bodenschicht
Baumschicht
Krautschicht
Strauchschicht
Monokulturen – Diskutiert zu zweit die Vor- und Nachteile von Monokulturen und haltet sie fest! Gelten diese Vor- und Nachteile immer allgemein, oder für bestimmte Lebewesen?

Das Reh und sein Lebensraum
Rehe halten sich bei Tag im Unterholz des Waldes auf. Erst bei Dämmerung kommen sie auf Waldlichtungen oder Wiesen und Felder. Sie sind Kulturfolger und nutzen die von Menschen angelegten Felder als Nahrungsquelle.
Rehe äsen in den frühen Morgenstunden oder in der Abenddämmerung. Sie fressen junge Triebe, Kräuter und Blätter. Durch das Abfressen junger Triebe schädigen Rehe junge Bäume und stören so ihr Wachstum. Ist die Rehpopulation groß, hat das ernsthafte Auswirkungen auf die Verjüngung des Waldes und damit auf die Artenvielfalt. Natürliche Fressfeinde sind eine Möglichkeit, die Anzahl an Rehen zu begrenzen und ein Gleichgewicht im Ökosystem herzustellen. Rehe begrenzen ihr Revier mit Duftmarken.


Körperbau
Der Körperbau der Rehe ist sehr gut an ihren Lebensraum angepasst. Ihr Körper ist vorne niedriger und schmäler als hinten, deshalb können sie durch dichtes Gebüsch schlüpfen. Die Hinterbeine sind lang und schlank. So können sie bei Gefahr rasch aufspringen und flüchten. Rehe wittern ihre Feinde. Sie gehören – so wie die Hirsche – zu den Paarhufern und sind Wiederkäuer
Die Rehböcke tragen ein Geweih, das sie jedes Jahr im Herbst abwerfen. Das Geweih entsteht aus der Lederhaut des Tieres. Es wächst jedes Jahr neu auf einem Knochenzapfen, dem Rosenstock. Dort bricht es auch im Herbst ab. Das neue Geweih ist mit Bast überzogen. Ist das Geweih fertig gewachsen, vertrocknet der Bast. Der Rehbock fegt ihn an Bäumen und Sträuchern ab.
Fortpflanzung von Rehen
Das weibliche Reh, die Geiß, bekommt im Mai 1 bis 2 Junge. Sie säugt ihr Junges, das Kitz, und kümmert sich alleine um dieses. Häufig lässt sie es in einem Versteck eine Zeit lang allein.
Unterholz, das: Strauchschicht, Gebüsch
Waldlichtung, die: Platz im Wald, an dem keine Bäume und Sträucher wachsen
Sind die Tiere auf der Flucht, so folgen die Jungen der Mutter. Dabei laufen sie dem weißen Fleck am Hinterteil der Geiß – dem Spiegel –nach.
Abb. 2: Geiß mit Spiegel


äsen: fressen
Duftmarke, die: kleine Menge von Urin; hier Stoffe aus speziellen Duftdrüsen am Geweih

Beobachte ein Reh beim Bewegen!
Scanne den QR-Code und beobachte, wie sich Rehe fortbewegen!
Analysiere, wie ihr Körperbau den Rehen bei der Fortbewegung im Gebüsch hilft!
wittern: jemanden oder etwas am Geruch wahrnehmen
Bast, der: Haut, die das Geweih während des Wachsens schützt und mit Nährstoffen versorgt fegen: scheuern, abstreifen
Schau in dein Bio Buch des letzten Jahres und mache dir den Unterschied zwischen Geweih und Horn bewusst!


Reh und Mensch
Erwachsene Rehe haben in den meisten Regionen Österreichs keine Fressfeinde. Damit ihre Zahl nicht zu groß wird, müssen sie gejagt werden. Im Winter bei tiefem Schnee finden sie wenig Futter und werden daher von den Jägern gefüttert.
Der Rothirsch




Abb. 2 + 4: Studiere bei beiden Fotos das Hirschkalb und das Rehkitz! Finde eine Erklärung dafür, warum die Jungtiere weiße Punkte in ihrem Fell haben!
Auch der Hirsch ist ein Tier, das stark bejagt wird! Wie ist eure Einstellung zur Jagd? Wägt gemeinsam die Vor- und Nachteile der Jagd ab!
Kulturflüchter, der: Tier, das die Nähe von Menschen meidet

Höre nun einem Hirsch beim Röhren zu!
Benenne andere Tiere, deren Männchen durch laute Geräusche oder kraftvolle Gesten zeigen, wer hier das Sagen hat!
Abb. 4: Hirschkuh mit Hirschkalb. Achte auf die weißen Flecken im Fell des Kalbes.
Brunftzeit, die: Zeit, in der sich Tiere paaren
röhren: besondere Art zu brüllen
Rivale, der: Gegenspieler
Der Rothirsch, der im Wald lebt, ist im Gegensatz zum Reh ein Kulturflüchter. Er bevorzugt Lebensräume, in denen es Wälder, aber auch offene Flächen gibt. Er ist sehr anpassungsfähig und kommt sowohl in den Bergen der Alpen als auch in den Auwäldern entlang von Flüssen vor. Abgesehen von den Alpen ist er in Österreich sehr selten, da er in den dicht besiedelten Gebieten kaum geeignete Lebensräume findet. Der Hirsch frisst Gras, Kräuter, Pilze und Laub. Er hat einen guten Geruch-, Gehör- und Sehsinn. Der männliche Hirsch wirft im Februar oder März sein Geweih ab.
Die Hirschkühe leben mit ihren Kälbern das ganze Jahr über in Rudeln zusammen. Zur Brunftzeit beginnt der Hirsch zu röhren. Er zeigt damit einem möglichen Rivalen, dass dieses Rudel ihm gehört.
Manchmal muss ein Hirsch um seine Weibchen kämpfen. Nur selten kommt es dabei zu schweren Verletzungen, denn der Schwächere zieht sich meist rechtzeitig zurück.
Der Waldiltis ist in Europa weit verbreitet. Auch er ist sehr anpassungsfähig und bewohnt so unterschiedliche Lebensräume wie Auwälder, Siedlungsränder und Dörfer.
Er ist nachtaktiv und kann gut tauchen. Der Waldiltis bewohnt Kaninchenbaue oder selbst gegrabene Röhren. Bei Gefahr stößt er aus Drüsen, die neben dem After liegen, eine stinkende Flüssigkeit aus. Seine Nahrung sind Frösche, angespülte Fische, Nagetiere, Wasserschnecken, große Insekten, Vogeleier und Jungvögel. Da seine Hauptbeutetiere – die Frösche – immer seltener werden, geht auch die Zahl der Waldiltisse bei uns zurück.
Die Paarungszeit des Iltisses ist von März bis April. Sieben Wochen nach der Paarung bekommt das Weibchen 3 bis 7 Junge. Bei der Geburt haben die Jungen ein Gewicht von nur 10 g. Aber bereits mit drei Monaten sind sie selbstständig.


Fährten und Spuren 1 – Jäger bezeichnen Fußabdrücke von Paarhufern als Fährten und von anderen Säugern als Spuren. Zu welchen Tieren passen diese Fährten und Spuren? Vergleiche die Pfoten der Tiere und die Art ihrer Fortbewegung! Dann schreibe den richtigen Tiernamen in das Kästchen und kreuze den passenden Fachausdruck für die Fußabdrücke an! Tipp: Die Fotos helfen dir dabei!









2
… wird abgeworfen und wächst jedes Jahr neu.

NAME: .
C

NAME: R . .



Fährte Spur


Fährte Spur
NAME: . I . . . .


Fährte Spur

NAME: W . . . . C . . . . .

Fährte Spur

Was sind die Unterschiede zwischen einem Geweih und einem Horn? Bestimme die Merkmale, indem du entweder G (Geweih) oder H (Horn) in die Kreise schreibst!





… wird vom Rind getragen.




… wird vom Hirsch/Rehbock getragen.








… wächst beim Jungtier und wird nie abgeworfen.
Geweih Horn Stirnzapfen
… wird von der Lederhaut gebildet.
… ist ein Stirnzapfen, der mit einer Hornschicht überzogen ist.



Fährten und Spuren 2 – Das Beobachten und Dokumentieren von Wildtieren ist ein wichtiges und umfangreiches Betätigungsfeld für Biologinnen und Biologen. Aber auch ganz allgemein finden viele Menschen es faszinierend, Wildtiere zu beobachten.
Auf Foto oder Video festgehalten, können Begegnungen mit Wildtieren einem breiten Publikum zugänglich gemacht werden. In der Regel stecken da viel Arbeit und Geduld dahinter, bis solch tolle Aufnahmen entstehen, wie du sie aus Dokumentationen, Berichten über Tiere oder von Postern kennst.
Scanne den QR-Code und sieh dir das Video an.







Dort bekommst du von einer Wildtierfotografin ein paar Tipps, wie du Wildtieren nachspüren kannst. Versuche den Tipps im Video zu folgen und finde Spuren und Hinweise, die Wildtiere in der Natur deiner Umgebung hinterlassen haben! Schreibe eine Liste der Tiere und welche Spuren du ausfindig machen konntest! Vergleicht in der Klasse! Vielleicht kann dir jemand aus deinem Umfeld oder deine Lehrerin oder dein Lehrer Tipps für Spuren weiterer Tiere geben. Auch online findest du dazu viel!
Für besonders Aufmerksame: Weshalb ist es nicht ganz richtig, dass im Video allgemein von Fährten gesprochen wird? Tipp: siehe dazu Aufgabe 1.
Diskutiert in Kleingruppen:

Welche Auswirkungen sowie Vor- und Nachteile hat es, wenn Menschen ihrem Interesse an Wildtieren in der freien Natur nachgehen!
Auf was sollten Menschen achten?
Gibt es Gefahren für Tiere und Menschen?
Gibt es bestimmte Zeiten, zu denen es wichtig ist, besonders achtsam zu sein?
Verfasst Verhaltensregeln, die helfen, Menschen und Tiere zu schützen!





In einem ungestörten Ökosystem geht nichts verloren. Jedes Lebewesen benötigt Nahrung und ist gleichzeitig Nahrung für andere Lebewesen. So frisst zum Beispiel ein Kaninchen Löwenzahn und wird wiederum von einem Fuchs gefressen. Dadurch ergeben sich Nahrungsbeziehungen zwischen den Lebewesen eines Ökosystems.
Das oben beschriebene Beispiel ist eine Nahrungskette. In so einer Nahrungskette ist die Nahrungsbeziehung „wer frisst wen“ dargestellt.
Solche Nahrungsbeziehungen sind jedoch meist nicht eindeutig. So frisst das Kaninchen nicht nur Löwenzahn, sondern auch andere Pflanzen. Der Fuchs wiederum ernährt sich auch noch von Mäusen, Igeln und anderen Tieren.

Abb. 1: Beispiel für eine Nahrungskette
Aber auch der Fuchs ist nicht das Ende der Nahrungskette. Junge Füchse können beispielsweise von anderen räuberischen Säugetieren oder Vögeln gejagt werden. Stirbt ein Fuchs, so wird sein Körper von Aasfressern verzehrt und das, was übrigbleibt, wird von Destruenten zersetzt. Somit werden die Stoffe, aus denen jedes Lebewesen besteht, wieder verwertet – der ökologische Kreislauf in einem Ökosystem schließt sich.
Da es kaum Tiere gibt, die sich nur auf eine einzige Nahrungsquelle spezialisiert haben, sind die Nahrungsbeziehungen in einem Ökosystem sehr vielfältig. Die Darstellung in einer Nahrungskette ist daher nur eine mögliche Beziehung unter vielen. Alle möglichen Beziehungen zwischen Produzenten, Konsumenten und Destruenten in einem Ökosystem bezeichnet man als Nahrungsnetz.
Da in einem Ökosystem sehr viele unterschiedliche Tierarten leben und jede davon mehrere unterschiedliche Nahrungsquellen und Fressfeinde hat, geben die Pfeile in der vereinfachten Darstellung 2 nur einige der möglichen Nahrungsbeziehungen wieder.
Nahrungsbeziehung, die: gibt an, welches Lebewesen die Nahrung eines anderen ist
Du siehst also: Ökosysteme sind sehr kompliziert aufgebaut. Da die Nahrungsbeziehungen so vielfältig sind, hängt das Wohlergehen eines Lebewesens eines Ökosystems von dem vieler anderer ab. Deshalb ist es so wichtig, dass die Artenvielfalt in Ökosystemen erhalten bleibt. Ohne sie bricht das Nahrungsnetz zusammen.
Abb. 2: Ausschnitt aus dem Nahrungsnetz eines
Findet andere Beispiele für Nahrungsketten! Wer findet die längste Kette mit den meisten Kettengliedern?
„An der Spitze der Nahrungskette.“ Hast du diesen Ausdruck schon einmal gehört? Was ist damit gemeint? Welche Vorstellungen weckt er? Diskutiert in der Klasse: Weshalb ist die Nahrungskette kein so gutes Modell, wenn man ein Ökosystem möglichst genau verstehen möchte?
Erörtert folgende Inhalte: Welche Position hat der Mensch in der Nahrungskette? Wo steht er im ökologischen Kreislauf?

1
Wer frisst wen? Benenne zuerst die Lebewesen des Waldes, dann zeichne möglichst viele Nahrungsketten zwischen den Lebewesen ein! Verwende für jede Nahrungskette eine andere Farbe und bilde so ein Nahrungsnetz!
hazel leaves © bark beetle © oak © owl © spruce © fox © grass © goshawk © rabbit © marten © mouse © deer © woodpecker © boar © worm © squirrel

Tipp: Wenn du nicht weiterweißt, dann schau in deinem EnglischWörterbuch nach!

2
Betrachte die oben dargestellten Lebewesen! Was hast du über Lebewesen im Ökosystem Wald schon gelernt? Kreuze immer die zwei richtigen Antworten an!
Welche Tiere fressen gerne Früchte und Samen?




Eichhörnchen Habicht Wildschwein
Welche Tiere fangen und fressen andere Tiere?


Hase Eule Marder

Welche Tiere ziehen ihre Jungen in einer Erdhöhle auf?



Fuchs Buntspecht Waldmaus

Welche Tiere ziehen ihre Jungen in einer Baumhöhle auf?


Eichhörnchen Buntspecht Wildschwein

Welche Tiere verstecken ihre Jungen in der Kraut- und Strauchschicht?


Fuchs Reh Eule
Erörtere die Rolle des Menschen in Ökosystemen! Hat er eine Sonderstellung oder ist er nur ein Lebewesen unter vielen? Wie beeinflusst er die Nahrungsbeziehungen in einem Ökosystem?

Untersuchung 1: Früchte und Samen des Waldes
Führt diese Untersuchung im Spätsommer oder im Herbst durch! Zu diesem Zeitpunkt haben viele Pflanzen ihre Früchte und Samen ausgebildet.
Ihr braucht: Papiersäckchen % Stift zum Beschriften % Pflanzenbestimmungsbuch Sucht an den Ästen von Büschen und Bäumen nach Früchten oder Samen! Ihr könnt auch unter den Büschen und Bäumen danach suchen.
Steckt einige Früchte und Samen gemeinsam mit Blättern des Baumes oder Strauches in ein Papiersäckchen! Beschriftet es mit dem Standort! Ihr könnt auch Fotos der Pflanze machen.
Bestimmt mit dem Bestimmungsbuch, um welche Pflanze es sich jeweils handelt!
ACHTUNG: Manche Pflanzen haben giftige Früchte. Auch wenn sie noch so appetitlich aussehen: Esst niemals Früchte oder Samen, die ihr nicht kennt!






In einem Wald ist es selten vollständig ruhig. Um dies zu überprüfen, folgt der Anleitung!
Ihr braucht: Sitzkisten % Schreibblock % Stift % optional: Aufnahmegerät/Mobiltelefon Sucht euch einen trockenen Platz am Waldboden und setzt euch in einigem Abstand zueinander auf den Waldboden!
Schließt die Augen und konzentriert euch auf die Geräusche des Waldes (nehmt sie auf)!
Notiert, welche Geräusche ihr gehört habt! Beschreibt sie, so gut ihr könnt!
Dann versucht zu erklären, woher die Geräusche stammen!
Vergleicht eure Aufzeichnungen: Habt ihr die gleichen Geräusche gehört? Habt ihr die gleichen Ursachen dafür notiert?

Ein vermodernder Baumstumpf ist ein kleines Ökosystem für sich.
Untersucht ihn!
Ihr braucht: Schreibblock % Stift % Bestimmungsbuch % Lupe % Messer % verschließbares Glas % Pinsel % Fotoapparat/Mobiltelefon Teilt euch in Gruppen auf! Jede Gruppe sucht einen vermodernden Baumstumpf. Wenn möglich sollen die verschiedenen Baumstümpfe unterschiedlich alt sein.

Beschreibt zunächst den Baumstumpf von außen! Wie sieht er aus, welche Pflanzen und Pilze wachsen auf ihm? Macht er einen morschen Eindruck?
Fertigt eine Skizze an und macht Fotos aus unterschiedlichen Blickwinkeln!
Bestimmt die Pflanzen, die auf dem Baumstumpf wachsen!
Untersucht, welche Tiere auf ihm leben! Geht dabei von außen nach innen vor! Verwendet die Lupe, um auch kleine Tiere aufzuspüren! Löst mit dem Messer ein Stück der Rinde ab! Wie sieht es drunter aus?
Sammelt mit dem Pinsel kleine Tiere ein und gebt sie in das verschließbare Glas! Bestimmt die Tiere, bevor ihr sie wieder freilasst!
Verfasst zum Schluss einen Bericht darüber, was ihr alles gefunden und beobachtet habt!
Recherchiere in welchen Ländern
Regenwald abgeholzt wird. Welche Tiere und Pflanzen leben dort?
Zu welchem Zweck erfolgen die Abholzungen? Besprecht euch in der Klasse!

Abb. 2: Rinderherden auf ehemaligem Regenwaldgebiet

Abb. 4: Lifttrassen laufen oft durch Schneisen im Wald
Findet Gründe, weshalb es schonender für den Wald ist, einzelne Bäume über eine größere Fläche verteilt zu fällen, als eine kleinere Fläche komplett abzuholzen! Welche Vorund Nachteile ergeben sich jeweils für die Forstwirte?
Schädling, der: Lebewesen, das in der Land- und Forstwirtschaft Schaden anrichtet
Gib an, welches Insekt vor allem Fichtenmonokulturen schädigt!
Wie schädigt es diese Bäume?
Durch Eingriffe des Menschen kommt es in der belebten und unbelebten Natur zu Veränderungen. Dadurch sind Wälder weltweit in Bedrängnis. Jedes Jahr werden Waldflächen größer als die Fläche Österreichs durch den Menschen abgeholzt und gehen verloren. Der Großteil der verlorenen Waldgebiete sind naturbelassene Regenwälder, die sich von selbst nur sehr langsam regenerieren können.
Die frei gewordenen Flächen werden vor allem als Nutzflächen für die Land- und Viehwirtschaft genutzt. Die erzeugten Produkte gelangen auch bei uns in die Lebensmittelgeschäfte, so dass unsere Einkaufsgewohnheiten für das Abholzen der Wälder in weit entfernten Ländern mitverantwortlich sind.
Abb. 1: Abholzung im Regenwald

Doch auch in Europa und Österreich sind die Wälder in Bedrängnis. Die als Wald bezeichnete Fläche nimmt in Österreich zwar zu, doch die tatsächlich von Bäumen bedeckte Fläche nimmt seit geraumer Zeit ab. Ein Grund dafür ist, dass auch freistehende Flächen, wie beispielsweise Forststraßen und Holzlager oder Wiesen zur Waldfläche gezählt werden. In Österreich ist in der Forstwirtschaft dazu noch der Kahlschlag üblich, bei dem große Flächen auf einmal komplett abgeholzt und danach wieder aufgeforstet werden. Doch auch die allgemeine Gesundheit und Lebenserwartung der Bäume in Europas und Österreichs Wäldern nimmt ab.

Dabei gibt es Gefahren für den Wald, die direkt durch menschliche Eingriffe entstehen. Beispiele dafür sind Schäden durch Verbauung und touristische Einrichtungen, wie Pisten und Lifttrassen. Andere Gefahren entstehen indirekt, nachdem Eingriffe des Menschen die Bedingungen im Ökosystem verändert haben und so das Gleichgewicht stören. Im Folgenden lernst du etwas über einige davon.

Schädlinge
Um möglichst viel Holz möglichst günstig erzeugen zu können, werden große Waldflächen mit denselben, schnell wachsenden Bäumen bepflanzt. In solchen Monokulturen können Schädlinge sich ungehindert ausbreiten und so viel Schaden anrichten. Sie vernichten oft ganze Waldlandschaften. Abhilfe gegen Schädlinge schafft das Aufforsten von Mischwäldern. In diesen können sie sich nicht so gut vermehren, da die Pflanzen, die sie befallen, weniger dicht beieinanderstehen. Außerdem gibt es durch die höhere Artenvielfalt in Mischwäldern mehr Fressfeinde.
Wildschäden
Hirsch- und Rehfleisch wird als Spezialität von den Menschen geschätzt und lässt sich gut verkaufen. Die Jagd ist somit ein wichtiger Wirtschaftsfaktor. Daher legt der Mensch Wert auf hohe Wildbestände. Für das Wild gibt es aber nur einen relativ kleinen Lebensraum und begrenzt Nahrung. So fressen Hirsche und Rehe junge Wipfelknospen. Dies führt dazu, dass der Baum nicht mehr richtig wächst und klein bleibt. Er verbuscht

Abb. 6: verbuschte Fichten
Hirsche und Rehböcke reiben aber auch ihr Geweih an jungen Bäumen und streifen dadurch den Bast von ihrem Geweih ab. Fegeschäden kannst du vor allem an Lärchen, Föhren und Pappeln sehen. Sie sterben dadurch oft ab und so gehen verschiedene Baumarten im Wald verloren.

Da die Baumrinde viele Nährstoffe, Vitamine und Wasser enthält, hat sie für die Tiere einen hohen Futterwert. Beim Schälen ziehen die Tiere Stücke der Baumrinde ab und verletzen so die Wachstumsschicht. Pilze befallen den ungeschützten Stamm. Oft stirbt der Baum dann ab.
Abb. 7: Hirsch beim Fegen
Man verhindert Wildschäden, indem man Jungwälder einzäunt. Folienstreifen oder aufgetragene Schutzmittel an den Wipfeln junger Bäume verhindern den Wildverbiss Auch die Fütterung des Wildes hilft. Eine weitere Möglichkeit ist auch die Verringerung der Population.
Der natürliche Fressfeind von Rehen, Hirschen oder Wildschweinen, der Wolf, war in Österreich bis in das 19. Jahrhundert heimisch, wurde dann aber ausgerottet. Im Laufe der letzten zwei Jahrzehnte wurden erst wieder vereinzelt Wölfe, später auch ganze Rudel in Österreich nachgewiesen. Derzeit leben drei Wolfsrudel in Österreich. Eines in Kärnten und zwei in Niederösterreich.

Auf Wildtiere wirken sich große Beutegreifer auf verschiedene Weisen aus. Sie halten Wildpopulationen gesund, indem sie kranke und schwache Tiere fressen. Sie stressen das Wild aber auch, wodurch es sich anders verhält, auch in seiner Nahrungssuche. Das kann wiederum Wildverbiss reduzieren. Wie stark sich die Wölfe in Österreich auf die Zahl der Wildtiere auswirken, ist noch nicht bekannt.
Wild, das: Tier, das gejagt wird
Erörtert gemeinsam, ob es in unseren Wäldern noch ein ökologisches Gleichgewicht gibt! Wo muss der Mensch eingreifen?

Abb. 8: Fegeschäden
Riss, der: von Raubtieren erlegte Beute
Das erste österreichische Wolfsrudel hat sich 2016 am Truppenübungsplatz Allensteig (NÖ) gebildet. Überlege: Weshalb ausgerechnet dort?
Überlege, wie Wölfe in Geschichten und Märchen dargestellt werden! Besprecht in der Klasse, ob das Einfluss auf die Wahrnehmung der Menschen vom Wolf hat!
Wölfe reißen auch zunehmend Nutztiere, vor allem Schafe, selbst wenn diese nicht zur natürlichen Beute der Wölfe gehören. Einzelne Wölfe sind schwächer als im Rudel und darauf angewiesen leichter zu erlegende Beutetiere zu jagen. Für Viehwirte ist ein Wolfsriss ein großes Ärgernis, auch wenn ihnen der Schaden ersetzt wird. Es läuft eine lebhafte Debatte zum Umgang mit Wölfen, die oft sehr emotional geführt wird.

Abb. 10: Mit Wölfen einen Lebensraum zu teilen, ist für Menschen eine Herausforderung.
Analysiere, was alles das Klima beeinflussen kann! Überlege dann, wie du selbst dazu beitragen kannst, das Klima zu schützen!
Neophyt, der: eine gebietsfremde bzw. nicht heimische Pflanzenart
Neozoon, das: Eine gebietsfremde bzw. nicht heimische Tierart, wie z.B. Nutria oder Marderhunde.


Hast du schon von Neozoen in deiner Gegend gehört? Besprecht eure Erfahrungen in Kleingruppen! Mehr Infos zu Neobiota in Österreich findest du hier: neobiota-austria.at
Recherchiere, welche Pflanzen und Tiere in deiner Region als Neobiota eingestuft werden. Hast du unterwegs schon welche entdeckt? Wie sollte man deiner Meinung nach mit ihnen umgehen?

Bienentrachtpflanze, die: eine Pflanzenart, die von Bienen für die Erzeugung von Honig bevorzugt wird. Auch Bienenweide genannt.
Mach dich auf die Suche nach Neophyten in deiner Umgebung! Notiere, welche Art du wo gefunden hast! Sieh auch in Gärten und Parks nach! Wirst du dort öfters fündig?

Der Wald leidet sehr unter den Klimaveränderungen. Jede Baumart benötigt ein bestimmtes Klima, um gut zu wachsen und sich zu vermehren. Bäume können nicht weglaufen, sie müssen an ihrem Standort bleiben und mit den geänderten klimatischen Bedingungen fertig werden. Lange Zeit war das Klima in Österreich günstig für die Fichte. Sie wurde auf großen Flächen ausgesetzt, da sie rasch wächst und daher für die Forstwirtschaft viel Holz produziert. Das Klima wird jedoch immer ungünstiger für diesen Baum. Die Trockenheit und die höheren Temperaturen machen ihn anfällig für Schädlinge. In den nächsten Jahren werden daher die Fichtenwälder in vielen Gebieten Österreichs verschwinden und durch andere Baumarten ersetzt werden.
Der Klimawandel begünstigt die Ausbreitung wärmeliebender Neobiota. Das sind Pflanzen (Neophyten) und Tiere (Neozoen), die sich durch den Einfluss des Menschen neu in einem Gebiet verbreiten, in dem sie vorher nicht beheimatet waren. Die ökologischen Auswirkungen gebietsfremder Arten sind bereits bemerkbar. Sie verdrängen vorhandene Arten und gelten weltweit als eine der wichtigsten Ursachen für den Rückgang der Artenvielfalt. Auch verursachen sie große wirtschaftliche Schäden. Neophyten sind vor allem in naturnahen Lebensräumen wie Auwäldern, flussbegleitenden Hochstaudenfluren oder Pionierstandorten problematisch, wo der Mensch nicht regulierend eingreift. Sie sind anspruchslos, konkurrenzstark, wachsen sehr schnell und können sich sehr effizient ausbreiten, da sie meist keine natürlichen Feinde haben.
Das Drüsige Springkraut wurde erstmals 1839 aus Indien nach England eingeführt und von dort als Zier- und Bienentrachtpflanze in Gärten in ganz Europa verbreitet. Mittlerweile zeigt es eine Massenverbreitung in Gebirgslagen und dringt mit den wärmer werdenden Bedingungen weiter vor. Es bevorzugt nährstoffreiche, ausreichend wasserversorgte Standorte, Waldlichtungen, Austandorte und die staudenbewachsenen Übergänge zwischen Wald und offenem Land.


Für Waldökosysteme problematische Neophyten sind die Robinie, der Götterbaum und die Manna-Esche. Sie alle wurden als Zierpflanzen und zur wirtschaftlichen Nutzung vom Menschen nach Mitteleuropa gebracht. Verbreiten sie sich allerdings frei, werden ihre als Vorteile gesehenen Eigenschaften wie Genügsamkeit und schnelles Wachstum zu Nachteilen. In Konkurrenz zu heimischen Arten sind sie diesen oft überlegen und verdrängen sie.

Um Bäume wie die Fichte zu ersetzen und die Forstwirtschaft für den Klimawandel zu wappnen, pflanzt der Mensch auch heute noch gezielt Neophyten. Ein Beispiel dafür ist die aus Nordamerika stammende Douglasie. Sie wächst schnell, kommt mit wärmeren klimatischen Bedingungen gut klar und ist resistenter gegenüber dem Borkenkäfer und anderen Schädlingen als die heimische Fichte. Wirtschaftlich bringt das Vorteile, doch auch hier gilt, dass Douglasien heimische Arten verdrängen können, wenn sie sich frei verbreiten. Roteichen sind eine weitere vom Menschen eingeführte, in der Forstwirtschaft genutzte Art.
Auch Neozoen können eine Gefahr für Wälder darstellen, da sie an Bäumen Schäden verursachen. Beispiele sind die EdelkastanienGallwespe, die Kastanienminiermotte oder der Asiatische Laubholzbockkäfer.
Wichtige

Natur als Vorbild: Das Klima und der Boden lassen in jedem Gebiet ganz bestimmte Bäume wachsen. Genau diese werden auch gesetzt, wenn man einen naturnahen Wald anpflanzen will. Das heißt, weder fremdländische noch standortfremde Bäume werden gepflanzt. Werden heute Wälder neu aufgeforstet, muss man auch schon mitbedenken, wie sich das Klima in den nächsten Jahrzehnten entwickeln wird.

Naturverjüngung: Der junge Baum wächst aus einem Samen der in der Umgebung stehenden Altbäume.
Besprecht in Teams, ob zu erwarten ist, dass die höhere Widerstandskraft von Neophyten gegenüber Schädlingen dauerhaft anhalten wird. Welche wichtigen Konzepte müsst ihr dabei bedenken?
Baumpflege: Seltene, aber ökologisch wichtige Baumarten werden bewusst gepflegt wie Elsbeere und Speierling.
Schutz des Bodens: Zum Schutz des empfindlichen Bodenlebens werden Eingriffe möglichst schonend durchgeführt. Das bedeutet, dass man Holz nach dem Schlägern zu den Forststraßen transportiert, wenn der Boden gefroren ist. Im Gebirge werden Holzstämme oft mit mobilen Kleinseilbahnen befördert. So werden Bodenlebewesen am wenigsten gestört.
Keine Chemikalien: Der Einsatz von Pestiziden wird vermieden und ist in manchen Wäldern Österreichs wie im Wienerwald sogar verboten

Abb. 16: Robinien
Diskutiert, warum einzelne Pflanzenarten wie Elsbeere oder Speierling ökologisch wertvoll sind! Erörtert dabei auch, was es bedeutet, wenn ein Lebewesen „ökologisch wertvoll“ ist!
Beschafft euch Informationen über Elsbeere oder Speierling und fertigt Steckbriefe an!
mobil: beweglich, transportabel

Abb. 19: Speierling
Pestizid, das: chemische Substanz (Stoff), die vom Menschen unerwünschte Lebewesen tötet oder verhindert, dass diese keimen, wachsen oder sich vermehren
Diskutiert, weshalb Pestizide ein Problem für die Artenvielfalt sind!
Nenne andere Methoden, um gegen Schädlinge vorzugehen!

Abb. 20: Wölfe verbreiten sich langsam wieder in Mitteleuropa. Das geschieht nicht ohne Konflikte.
Informiere dich auf der Homepage des Wolf Science Center Ernstbrunn (NÖ) www.wolfscience.at über aktuelle Forschungsergebnisse über den Wolf!
In Österreich siedeln sich immer mehr Wölfe an. Informiere dich über die Probleme, die dabei entstehen! (Internet, Zeitungen, …). Nutze verschiedene Quellen! Vergleiche, welche Eindrücke vermittelt werden und welche Mittel (Bilder, Videos, Wortwahl, …) verwendet werden!
Soll die Wiederansiedlung von Wölfen in Österreich gefördert werden? Bilde dir eine eigene Meinung und diskutiere mit deinen Mitschülerinnen und Mitschülern über eure Standpunkte!
Eingriffe des Menschen in Ökosysteme
In Österreich gibt es nur ganz wenige Landschaften, die natürlich entstanden sind und in die der Mensch nicht eingreift. Aber auch wenn es keine unmittelbaren Eingriffe des Menschen in ein Ökosystem gibt, so haben die Handlungen des Menschen Auswirkungen:
2 Klimaveränderungen wirken sich weltweit aus und betreffen daher auch Ökosysteme, die nicht direkt vom Menschen verändert werden.
2 In Mitteleuropa kehren die großen Raubtiere wie Wölfe und Bären erst langsam zurück. Fehlende Fressfeinde haben auch einen Einfluss auf die Populationen von Pflanzenfressern in allen Lebensräumen.
Erkläre, was unter „Population“ zu verstehen ist!
Warum können in einem Wald die Veränderungen durch den Klimawandel nicht rasch genug ausgeglichen werden? Stelle dazu eine Hypothese auf!
2 Giftstoffe, die in die Luft, Gewässer oder das Grundwasser gelangen, verbreiten sich über große Flächen.
Viele Landlebensräume sind ausschließlich vom Menschen gestaltet. Die meisten Flächen, auf denen es keinen Wald gibt, werden für die Landwirtschaft genutzt. Auch Wiesen würden zum Großteil verschwinden und durch Wald ersetzt werden, wenn sie nicht regelmäßig gemäht werden würden oder Herden von Weidetieren vorhanden wären. Parks und Gärten sind gänzlich vom Menschen geschaffen. Lediglich an unzugänglichen Orten wie im Hochgebirge gibt es kaum menschliche Eingriffe.
Überall dort, wo der Mensch eingreift, geht die natürliche Vielfalt zurück. Die Anzahl an unterschiedlichen Tier- und Pflanzenarten nimmt ab. Für viele Arten bleiben nur wenige kleine Rückzugsgebiete übrig. So werden bei den meisten Arten auch die Populationen kleiner.

Im Vergleich dazu ist der Einfluss des Menschen im Wald geringer. Es wird zwar auch der Wald bewirtschaftet, allerdings gibt es Unterschiede zu anderen vom Menschen beeinflussten Lebensräumen, da Bäume nur langsam wachsen:



Ungestörte Entwicklung: Da es lange dauert, bis neu gesetzte Bäume gefällt werden können, bleiben große Teile eines Waldes lange Zeit ohne Störung des Menschen. Die Natur kann sich weitgehend ungestört entfalten.
Langsame Erholung: Es dauert lange, bis sich ein Wald nach einem schweren Schaden wie nach einem starken Sturm erholt.
Empfindlich auf Klimawandel: Veränderungen der Lebensbedingungen durch den Klimawandel können nicht rasch genug ausgeglichen werden.

In Österreich, aber auch in vielen anderen europäischen Ländern, hat man erkannt, wie wichtig Wälder für das Bestehen einer funktionierenden Natur sind. Daher werden umfangreiche Maßnahmen gesetzt, um die Störungen im Ökosystem Wald so gering wie möglich zu halten.
Abb. 22: Sturmschaden an einem Baum
Wie kann es bei einem Baum zu Verletzungen kommen und wie heilt ein Baum seine Wunden? Fülle die Lücken! Tipp: Die Silben helfen dir dabei.









Ursachen für Verletzungen
Hirsche schaben an Baumrinden, um den Bast von ihrem neuen ___________________ zu entfernen. Diese Schäden nennt man ____________________________. Eichhörnchen, Mäuse und Kaninchen schälen Stücke der Baumrinde ab, weil diese viele Nährstoffe, ____________________ und Wasser enthalten. Sie verletzen dabei die ______________________schicht des Baumes. Nun können Pilze den ungeschützten Baum befallen. Ihre ________________ fliegen durch die Luft und dringen durch die offenen Stellen ein. Der Pilz breitet sich im Baum aus. Wenn das ____________________ verrottet ist, stirbt der Baum ab.
Der Baum heilt seine Wunden
Wenn ein Ast mit einem glatten Schnitt entfernt wird, wächst das _____________________ vom Wundrand aus über die Wunde und bildet neue Rinde. Ist dieser __________________________ abgeschlossen, können weder Pilze noch _______________________eindringen. Es dauert allerdings Jahre, bis die Wunde ______________________ ist.
2 1
Kleine Dinge – große Wirkung: Hier findest du Vorschläge, wie jeder Haushalt zu einer gesunden Umwelt beitragen kann. Bildet Gruppen (3 – 4 Personen) und gestaltet zu einem Vorschlag ein Plakat! Entwerft auch eine Überschrift – z. B. „Danke!“, sagt die Umwelt!
2 Die Temperatur im Kühlschrank sollte 7 bis 8 °C betragen.
2 Häuser und Wohnungen brauchen eine gute Wärmedämmung.
2 Die Heizung muss regelmäßig überprüft werden.
2 Bei normal schmutziger Wäsche reicht Waschen mit 40 °C!
2 Geräte, die älter als 10 Jahre sind, brauchen deutlich mehr Strom und Wasser p austauschen!
2 Beim Kauf neuer Elektrogeräte (Waschmaschine, Kühlschrank, Geschirrspüler) stromsparende Geräte kaufen!
2 Zu Ökostrom wechseln! – Ökostrom wird auf umweltfreundliche Weise erzeugt (Sonne, Wind, Wasser, Biomasse).
2 Abfall vermeiden! Mehrwegsysteme und Recycling anwenden!
2 Wegwerfen – kein Thema! Reparaturservice nutzen!
2 Genug ist genug – Kaufen Sie weniger Textilien!
2 Kaufen Sie Baumwollprodukte aus kontrolliertem biologischem Anbau!
2 Kaufen Sie umweltverträgliche Kosmetika! Sie sind gekennzeichnet.
2 Sparen Sie Papier – nutzen Sie z. B. beide Seiten beim Computerausdruck!



2 Nutzen Sie auch Recycling-Papier, denn bei der Produktion wird nur 1/3 der Energie und 1/6 des Wassers benötigt!


Sucht euch ein Ökosystem in der Nähe eurer Schule aus. Es sollte ein kleineres abgeschlossenes Ökosystem sein. Ihr könnt das Gebiet, das ihr
Schritt 1: Überblick verschaffen
untersuchen wollt, auch markieren, indem ihr an den Eckpunkten Stöcke in den Boden steckt.
Stellt zunächst die wichtigsten Merkmale eures Ökosystems fest! Fasst sie in einem Kennblatt wie in Abb. 1 zusammen!
Beschafft euch auch eine Karte der Gegend mit möglichst kleinem Maßstab, sodass auch Details zu erkennen sind!
Macht Fotos eures Ökosystems! Darauf sollte nicht nur das Ökosystem selbst, sondern auch die Umgebung zu erkennen sein.
Messt Temperatur, Luftfeuchtigkeit, Windgeschwindigkeit und Intensität des einfallenden Lichtes! Führt die Messungen direkt am Boden und in etwa 1 Meter Höhe durch! Liegt euer Ökosystem im Schatten oder erhält es viel Sonnenlicht?
Bei einem Gewässer haltet fest, ob es ein stehendes oder ein fließendes Gewässer ist. Messt auch die Wassertemperatur und die Fließgeschwindigkeit!
Stellt fest, welches die typischen Pflanzen in eurem Ökosystem sind! Bei einer Wiese reicht ein kleines Stück von 1 m x 1 m, bei einem Wald müsst ihr eine größere Fläche auswählen, z. B. 10 m x 10 m.
Fertigt eine Skizze der Fläche an, die ihr genauer untersucht!
Bestimmt mit einem Bestimmungsbuch die typischen Pflanzen in eurem Ökosystem!

Bezeichnung des Ökosystems:
Typ des Ökosystems: Wiese Feld Wald Park Garten ......
Größe:
Länge: Breite:
Umgebung: nördlich liegt: östlich liegt: südlich liegt: westlich liegt:
Beschaffenheit des Untergrunds: steinig fest sumpfig
Nutzung des Ökosystems:
Abb. 1: Kennblatt eines Ökosystems

Untersucht auch die Tiere, die ihr in eurem abgesteckten Bereich findet! Erstellt dazu eine Tabelle mit Tiergruppen wie „Schnecken“, „Käfer“, „Spinnen“ oder „Ameisen“! Dann tragt ein, wie viele Exemplare ihr von jeder Gruppe findet!
Abb. 2: Schülerinnen untersuchen das
Macht Fotos von den Tieren, die ihr gefunden habt! So könnt ihr sie später besser bestimmen.
Schritt 4: Auswertung
Stellt die Messergebnisse der abiotischen Faktoren den Lebewesen, den Pflanzen und den Tieren in eurem Ökosystem gegenüber!
Beschreibt die vorherrschenden Umweltbedingungen und die Lebensgemeinschaft, die dort lebt! Stellt Vermutungen an, welche Tiere und welche Pflanzen welche Umweltbedingungen benötigen!
Schritt 5: Präsentation
A. Fasst eure Ergebnisse auf einem Plakat zusammen und gestaltet mit den anderen Plakaten eine Ausstellung mit dem Titel „Ökosystem Wald“ in eurer Schule (z. B. Aula).
B. Ihr könnt auch einen Artikel für die Schülerzeitung oder für die Homepage eurer Schule verfassen.
Abhängig von dessen Bedürfnissen übernimmt der Wald für jedes Lebewesen andere Funktionen, die ihn für dieses Lebewesen wichtigmachen. Die Funktionen, die er aus menschlicher Sicht für den Menschen übernehmen soll, sind im Forstgesetz von 1975 in Worte gefasst. Dadurch wird ein rechtlicher Rahmen, also so etwas wie eine gesellschaftliche Vereinbarung, für den Umgang mit dem Wald geschaffen. Das Österreichische Forstgesetz beschreibt die vier Hauptfunktionen des Waldes als die Schutzfunktion, die Nutzfunktion, die Erholungsfunktion und die Wohlfahrtsfunktion. 2023 wurde das Gesetz geändert, um die Nachhaltigkeit und die Anpassung der Wälder an den Klimawandel zu stärken.
Der Wald schützt uns
Bannwälder schützen vor Lawinen, Erdrutschen, Muren, und Felsstürzen
Die Wurzeln der Bäume halten die Erde fest. Sie verhindern dadurch, dass Wasser und Wind den Erdboden abtragen. Dieses Abtragen nennt man Erosion. Die Bäume verhindern auch, dass große Schnee- und Felsmassen ungebremst ins Tal stürzen.


3:
Überlege mit deiner Sitznachbarin, deinem Sitznachbarn, welche Funktionen der Wald für verschiedene Tiere übernimmt! Was sind Gemeinsamkeiten, was Unterschiede? Denkt auch an Tiere, die nicht dauerhaft im Wald wohnen, wie beispielsweise Zugvögel!
Mure, die: Schlammlawine
Abbildung 3 und Abbildung 4 zeigen dir deutlich, was bei Lawinenabgängen und Erdrutschen geschieht, wenn schützende Waldflächen fehlen.
Abb. 1: Bannwald, sie bilden schützende Barrieren.

Fehlt der Wald, so muss der Mensch versuchen, diese Gefahren durch künstliche Hindernisse wie teure Lawinenverbaue zu verringern.
Da durch den Klimawandel die Anzahl an Extremwetterereignissen und damit die Gefahr für Überschwemmungen, Erdrutsche und Felsstürze stetig zunimmt, gewinnt die Schutzfunktion des Waldes auch zunehmende Bedeutung.

Abb. 2: Lawinenwarnung

Abb. 5: Lawinenverbau
Recherchiert zu großen Lawinenabgängen, Erdrutschen, Felsstürzen und Überschwemmungen in Europa! Welche Schäden haben sich ereignet? Lässt sich herausfinden, ob Bannwälder, oder Schutzverbauungen vorhanden waren?
Grundwasser, das: Regenwasser, das durch den Erdboden sickert und auf einer wasserundurchlässigen Schicht gestaut wird
Quellwasser, das: Wasser, das aus natürlichen unterirdischen und vor Schadstoffen geschützten Speichern entspringt, nachdem es viele Meter durch Gestein gesickert ist
Ein lockerer Waldboden kann viel Wasser aufnehmen. Weshalb ist es problematisch, dass in der Forstwirtschaft immer größere und schwerere Maschinen zum Einsatz kommen?

Abb. 8: Die Bäume des Waldes geben Feuchtigkeit ab.
Was meinst du: Können auch baumbewachsene Flächen in Städten den Auswirkungen des Klimawandels entgegenwirken? Begründe deine Antwort!
Du hast bereits gelernt, dass Moore mit ihrer Fähigkeit, Wasser zu speichern wirksamen Schutz gegen Hochwasser bilden. Auch im Waldboden wird Wasser gespeichert. So werden Überschwemmungen und Hochwasser verhindert oder zumindest abgeschwächt.
Wenn es regnet, fangen die Blätter die Wassertropfen auf. Dadurch verdampft bis zur Hälfte des Niederschlags und die Menge an Wasser, die bis zum Boden gelangt, ist wesentlich geringer als ohne Blätterdach. Durch Baumwurzeln und Tierröhren gibt es zahlreiche Hohlräume im Waldboden. Sie nehmen Wasser auf und auch Moospflanzen speichern es. Waldboden kann bis zu sechsmal mehr Wasser aufnehmen als Wiesenboden. Wasser, das nicht gespeichert wird, versickert langsam im Boden und erreicht das Grundwasser

Grund- und Quellwasser haben in Österreich Trinkwasserqualität.
...verbessert die Luft
Der Wald schafft in seiner Umgebung ein angenehmes und gesundes Klima. Er ist ein Klimaregulator. Wie er das bewerkstelligt, zeigt dir die folgende Abbildung:
Abb. 7: Der Wald beeinflusst das Klima vor Ort.






1. Die erwärmte, verschmutzte Luft steigt über der Stadt auf.
2. Sie kühlt ab und sinkt dabei wieder zu Boden. Die Pflanzen des Waldes geben Feuchtigkeit an die Luft ab. Durch die Verdunstung wird die Luft weiter gekühlt.
3. Der Wald reinigt die Luft. Staub bleibt an den Blättern hängen. Pflanzen geben Sauerstoff ab und filtern manche Abgase aus der Luft. Der Wald verbessert die Luft.
4. Die feuchte, saubere und kühlere Luft wird an die Umgebung abgegeben.
Du hast vielleicht schon erlebt, dass es im Sommer in einem Wald auffallend kühler ist als außerhalb. Man nennt das Mikroklima, von mikro, klein – also das Klima in einem kleineren Bereich. Neben der Verdunstung von Feuchtigkeit hat das noch einen weiteren Grund. Das Blätterdach schirmt den Boden vor Sonneneinstrahlung ab. Dadurch erwärmt sich der Boden weniger stark als auf freien Flächen. Das verringert die Auswirkungen der Klimaerwärmungen für Lebewesen, die am Waldboden leben.
Erinnere dich daran, dass die tatsächlich laubbedeckte Fläche in Österreich seit geraumer Zeit abnimmt. Die kühlende Wirkung des Blätterdachs verliert so zunehmend an Wirkung.
Viele Menschen machen am Wochenende Ausflüge in den Wald. Der Wald ist zu einem wichtigen Erholungsraum für die Menschen geworden. In Österreich kann fast jeder Wald frei betreten werden. Im Wald kann man allerlei spannende Sachen erleben und entdecken.
Doch auch aus gesundheitlichen Gründen ist er wertvoll für den Menschen. Das kühlere Klima im Wald kommt nicht nur seinen Bewohnern zugute. Die frische und feuchte Luft tut auch Menschen gut. Besonders in den Sommermonaten finden Menschen, die unter der Hitze, oder auch Atemwegserkrankungen leiden, im Wald angenehmere Bedingungen vor.


Dass man nicht lärmt und auf den markierten Waldwegen bleibt, um das Wild nicht zu erschrecken, versteht sich von selbst. Auch Abfall hat keinen Platz im Wald.
Abfall muss mitgenommen und zu Hause richtig entsorgt werden!
...ist Rohstofflieferant
Der Wald liefert uns Holz. Verschiedene Holzarten werden als Brennstoff, Bauholz (Häuser, Dachstühle, Treppen usw.) und Möbelholz verwendet. Auch Papier wird aus Holz hergestellt.
Der Wald ist Arbeitsplatz für viele Menschen (Försterin und Förster, Forstarbeiterin und Forstarbeiter, Jägerin und Jäger usw.).
Auch in der Holzverarbeitenden Industrie finden Menschen Arbeit. Forstgesetze regeln, wie viel Wald geschlägert werden darf, und wo aufgeforstet werden muss.
Die wirtschaftliche Bedeutung des Holzes ist auch heute noch groß.
Durch das Fällen von Bäumen und anschließender Aufforstung wird der Wald verjüngt. Das Entfernen von Unterholz und Totholz schafft lichtere Bedingungen und hilft jungen Bäumen, schneller zu wachsen.
Kranke Bäume werden vom Förster entfernt und die Pflege des Waldes trägt dazu bei, dass er gesund bleibt. Auch in der Forstwirtschaft gilt es, ein Gleichgewicht zu finden, so dass sich der Wald immer ausreichend erholen kann und lange gesund erhalten bleibt. Entnommenes Holz kann die in ihm gebundenen Stoffe nicht an den Waldboden zurückgeben. Sie gehen dem Wald langfristig verloren.

Sammelt gemeinsam Argumente, warum der Wald geschützt werden muss!
Erörtert gemeinsam, wie man sich im Wald verhalten sollte! Begründet auch diese Verhaltensweisen!
Holzverarbeitende Industrie, die: Sägewerk, Papierfabrik, Möbelwerk, usw.
schlägern: Bäume fällen aufforsten: Bäume oder Sträucher auf einem nicht bewachsenen Stück Land pflanzen


Abb. 11:
Versuche in einem Wald deiner Umgebung Spuren von Forstarbeiten zu finden! Kannst du Stellen ausmachen, wo gerade aufgeforstet wird? Ein Tipp um Forstwälder zu erkennen ist, dass die Bäume in Reihen gepflanzt werden. Natürliche Wälder wachsen nicht so.
Der Wald – ein Wasserspeicher: Begründe mit Hilfe der Abbildung die Bedeutung des Waldes als Wasserspeicher! Verfasse dazu einen Informationstext, mit dem du den Vorgang beschreibst!

Regen

speichern, filtern, versickern
Grundwasser Boden
Luftfeuchtigkeit
Verdunstung, Blätter geben Wasser ab
Wurzeln nehmen Wasser auf
Diese Plakate zeigen dir, wie man sich im Wald verhalten soll. Was sagen sie aus? Gestalte einen einprägsamen Regeltext!



In der ersten Klasse hast du den Lebensraum Wiese kennengelernt. Heuer hast du Näheres über das Moor und den Wald erfahren. In den unterschiedlichen Lebensräumen herrschen unterschiedliche Lebensbedingungen , die ganz verschiedene Pflanzen und Tiere hervorbringen Aber nicht nur die natürlichen Lebensbedingungen sind unterschiedlich, auch der Eingriff durch den Menschen nimmt in unterschiedlichen Lebensräumen unterschiedliche Formen an. Es gibt noch viele andere Lebensräume auf der Erde und vermutlich auch darüber hinaus. Drei davon wirst du nun kurz kennen lernen.
Lebensraum Gebirge
Österreich besteht zu fast drei Viertel aus Bergland. Gebirge sind sehr vielfältige Lebensräume. Einerseits unterscheiden sich die Lebensbedingungen stark je nach Höhe. Andererseits wechseln sich in der Höhe die Bedingungen bezüglich Lichteinfalls, Niederschlagsmenge und Ausgesetztheit gegenüber Wind und Erosion, vor allem in den steilen Hängen und Felsformationen, oft ab.
Man unterscheidet Mittelgebirge mit eher gerundeten Gipfeln, sanfteren Hängen und nur stellenweise auftretendem offenen Fels und Hochgebirge mit schroffen Gipfeln und viel freiliegendem Fels. Die Unterscheidung zwischen Mittel- und Hochgebirge erfolgt nicht nach Höhe, da Landschaftsform und auch die allgemeinen klimatischen Bedingungen einer geografischen Region ausschlaggebend sind.
Abb. 1: Höhenstufen des Berges. Beachte die sich ändernde Vegetation und die starken Unterschiede im Lichteinfall


In Mittelgebirgen unterscheiden sich die Lebensbedingungen meist nicht allzu stark von denen in der Tiefebene. Es gibt eine ausreichend dicke Erdschicht, so dass auch Bäume und tief wurzelnde Pflanzen passende Bedingungen vorfinden. Die Hänge des Mittelgebirges in Österreich sind daher oft mit Wald bestanden. Mit zunehmender Höhe und schroffer werdenden Bedingungen ändert sich das Pflanzenbild.
Die Baumarten wechseln ab etwa 800m von Mischwald zu Nadelwald, bestehend aus Fichten, Lärchen und Zirben. Ab etwa 1800m finden auch Nadelbäume keine passenden Lebensbedingungen mehr vor. Diese Höhe nennt man Baumgrenze. Die Bäume werden erst kleiner im Wuchs, dann dominieren Krummhölzer wie Latsche und Grünerle. Sie werden mit steigender Höhe von Zwergsträuchern wie Rostblättrige Alpenrose, Krähenbeere, Rauschbeere, Heidelbeere, Preiselbeere, und Zwergwachholder und danach Gräsern abgelöst.
Lebst du in einer Region mit Bergen? Oder warst du schon einmal am Berg unterwegs? Tauscht euch in Kleingruppen über eure Erfahrungen aus! Notiert dabei, was ihr über die Tier- und Pflanzenwelt, sowie Besonderheiten des Wetters in Erinnerung habt!


2: Latschen (Bergkiefer) Bewuchs

3:

4: Preiselbeere

Abb. 5: Grasbewuchs im Hochgebirge. Beachte, wie dünn die Erdschicht ist.
Recherchiere, ob die Gesteinsart eines Berges darauf Einfluss hat, welche Pflanzen in hohen Regionen wachsen! Tragt eure Ergebnisse in der Klasse zusammen! Findet ihr auch heraus, wo in Österreich sich welche Gesteinsart im Gebirge findet? †


8: Faccinis


Abb. 9: Berganika (links) und Frühlingsenzian (rechts) –farbenprächtige Bergblumen.

Abb. 12: Steinadler
Recherchiert in der Klasse zu Tieren der Alpen! Was fressen sie? Wo und wie leben sie? Passt das zu den Höhenstufen? Lässt sich ein Nahrungsnetzwerk skizzieren?
Tipp: Bildet Teams, z.B. für Säuger, Vögel, Insekten, Reptilien/Amphibien.
Ab etwa 2700m tritt keine geschlossene Pflanzendecke mehr auf. In diesen Höhen kann oft ganzjährig Schnee vorgefunden werden. Meist dominiert in diesen Höhen blanker Fels. Auf steilen Hängen, die stark dem Wetter und Erosion ausgesetzt sind, kann sich keine geschlossene Erdschicht mehr bilden. Trotzdem gibt es auch hier noch Spezialisten, die unter diesen harschen Bedingungen gedeihen können. GletscherHahnenfuß, Besenheide und manche Steinbrech-Arten sind Beispiele, insbesondere allerdings auch Moose und Flechten.
Den Hochgebirgspflanzen gemein ist ihr Zwergwuchs. Diese Anpassung hilft ihnen, Bodenwärme zu nutzen und sich leichter in Nischen vor der Witterung zu schützen. Im Vergleich zu Niederlandpflanzen bilden viele auch sehr farbkräftige Blüten. Es besteht harte Konkurrenz, um Insekten zum Bestäuben anzulocken. Entsprechend setzen sich Pflanzen mit intensiver Färbung durch.

Abb. 6: Moose und Flechten kommen auch in sehr großer Höhe noch vor.

Diese Höhenstaffelung der Lebensräume im Gebirge nennt man Höhenstufen . In unterschiedlichen geografischen Breiten ändern sich die Höhen, in denen sie auftreten, da die allgemeinen klimatischen Bedingungen verschieden sind.
Die wohl bekanntesten Tiere des Gebirges sind Murmeltier, Steinbock und Gämse. Das Murmeltier lebt im Familienverband in Tunnelbauten unter Gebirgswiesen. Vielleicht hast du schon einmal das charakteristische Pfeifen gehört, dass sie als Warnruf ausstoßen. Steinbock und Gämse sind wahre Kletterkünstler. Sie bewegen sich zwischen Bergwald und Felsregion, um Nahrung, zumeist Triebe von Alpensträuchern, und geschützte Schlafplätze zu finden. Schneehasen und Schneemaus bekommt man seltener zu Gesicht.

10: Alpensteinbock
11: Alpenmurmeltier †
Für Alpendohle, Schneefink und andere Vögel sind Bergregionen wichtiger Lebensraum zur Nahrungssuche. Versteckreiche Fels- und Strauchzonen bieten sichere Brutplätze. Manche Waldbewohner, wie Ringdrossel und Birkenzeisig kommen zur Nahrungssuche und Balz auf die Bergwiesen. Der Steinadler ist mit etwa zwei Metern Flügelspannweite der imposanteste Vogel der Alpen. Er jagt vor allem Murmeltiere und andere Säuger, aber auch Vögel. Bergwiesen beheimaten viele Schmetterlingsarten, wie den Alpengelbling. Auch Hummeln und zahlreiche Fliegen- und Mückenarten finden sich beim eifrigen Herumschwirren. Gebirgspflanzen sind zur Fortpflanzung stark auf diese Insekten angewiesen. 2010 wurden erstmals Ameisen entdeckt, die sich evolutionär speziell an das alpine Hochgebirge angepasst haben.
Abb.13: Alpengelbling

An Amphibien und Reptilien finden sich oberhalb der Baumgrenze Alpensalamander, Kammmolch, Kreuzotter sowie Eidechsen und Vipern.
Steppen sind nahezu baumlose Gras- oder Buschlandschaften. Die Niederschlagsmengen sind eher gering und im Jahr herrscht mehrere Monate Trockenheit. Bäume finden hier keine passenden Lebensbedingungen. Niederschlagsmenge und Länge der Trockenzeit bestimmen das Vegetationsbild. In Feucht- und Hochgrassteppen wachsen Gräser bis zu zwei Meter und vielfältige Kräuter und Zwergbusche, während in Trockensteppen kurze Gräser vorherrschen. Herden von Weidetieren wie Antilopen- und Büffelarten sind typisch für Steppen, aber auch Nagetiere, die in unterirdischen Kolonien wohnen. Die Prärien Nordamerikas, oder die Outbacks Australiens sind Beispiele für Steppen. In Österreich findet sich im Burgenland, mit der Pustza, dem westlichen Ende der Eurasischen Steppe, diese Art Lebensraum.

Als Savanne bezeichnet man Landschaftsbereiche zwischen Wüste und tropischem Wald. Auch die Savanne ist eine Graslandschaft, die jedoch von vereinzelten Bäumen bis Baumgruppen durchsetzt ist. Die Niederschlagsmengen sind in der Regel höher als jene in Steppen und fallen vorwiegend in einem bestimmten Zeitraum, der Regenzeit.
Typische Pflanzenfresser der afrikanischen Savannen sind Gnu, Elefant, Zebra, Giraffe und Gazellen- sowie Antilopenarten. Sie ziehen in großen Herden dem Regen nach um ausreichend Nahrung zu finden. Wo es Pflanzenfresser gibt, gibt es auch Tiere, die diese jagen, um sich zu ernähren (denke an Nahrungsketten). In afrikanischen Savannen sind dies beispielsweise Löwen, Geparden, Hyänen und Leoparden.


Weniger sichtbar, dafür umso zahlreicher leben auch Insekten in Savannen. Termiten errichten eindrucksvolle Bauten und es findet sich eine Vielzahl an Ameisen, Grashüpfern und Käfern. Raubvögel wie Bussarde und Falken oder Bienenfresser und Webervögel sind Beispiele für den Artenreichtum an Vögeln der Savannen. Geier sind als Aasfresser wichtiger Teil des Nährstoffkreislaufes, da sie tote Tiere verwerten. Sie erfüllen damit auch als „Aufräumtrupps“ eine wichtige Aufgabe, da Tierreste, vor allem wenn sie in Trinkwasserstellen verwesen, Ursache für Krankheiten sein können. Strauße sind die größten Vögel der Erde. Als Laufvögel können sie nicht fliegen und bewegen sich nur auf ihren Beinen voran. Das dafür sehr schnell, sie können Geschwindigkeiten bis zu 70 km/h erreichen.
Informiere dich über die Pustza! Wo genau liegt sie? Wie sind die klimatischen Bedingungen und die Geländeform? Welche Tiere und Pflanzen gibt es dort? Wurde und wird sie vom Menschen genutzt? Verfasse einen Steckbrief und vergleicht in der Klasse, was ihr herausgefunden habt!


Abb. 18: Termitenhügel können bis zu 7 m hoch werden.
Aas, das: toter Tierkörper, der bereits verwest.




Der Gepard, ein wahrer Sprinter! Geparden können beim Jagen kurzzeitig Geschwindigkeiten von bis zu etwa 100 km/h. erreichen. Sie sind damit die schnellsten Landtiere der Erde.

Abb. 17: Rüppellgeier verzehren Reste eines Gnus.
Finde heraus, wo auf der Welt es Salzwüsten gibt und wie sie entstanden sind!



Was sind Oasen?
Oasen sind Bereiche üppiger Vegetation in der Wüste. Sie bilden sich, wo ausreichend Wasser zur Verfügung steht. Auf natürliche Weise dort, wo Grundwasser an die Oberfläche tritt, oder durch Eingriff des Menschen.

25: Sandfuchs

26: Pillendreher
Recherchiere, welche Reptilien in der Wüste vorkommen und wie sie sich an das Leben dort angepasst haben!
Wüsten – Leben unter schwierigsten Bedingungen
Mit Wüsten werden meist Hitze und Sand verbunden. Dabei gibt es auch Kies-, Geröllund Felswüsten, Salzwüsten und Eiswüsten. Ihnen allen ist gemein, dass sie nur sehr wenig Leben, meist auf kleine Flächen konzentriert, beherbergen. Der Grund kann Wassermangel und Hitze, aber auch der Mangel an Wärme, wie bei Eiswüsten sein. Salzwüsten sind Überreste ausgetrockneter salzhaltiger Seen. Es verbleiben salzige Böden, auf denen nur wenige, angepasste Pflanzen- und Tierarten überleben können.
Die größte Wüste der Erde ist die Sahara. Sie nimmt einen Großteil des Nordens Afrikas ein und ist neun Millionen Quadratkilometer groß. Nur etwa 20% der Gesamtfläche sind Sandwüste. Der Rest besteht vor allem aus Kies- und Geröllwüste. Das Klima der Sahara ist von extremen Temperaturunterschieden geprägt. Bei Tag können die Temperaturen 50°C übersteigen und bei Nacht unter den Gefrierpunkt fallen. Da es kaum Niederschlag gibt, herrscht extreme Trockenheit.
Trotz der harten Bedingungen haben es einige Pflanzen geschafft, sich an ein Leben in der Sahara anzupassen. Die Doumpalme und verschiedene Akazienarten haben sehr tief reichende Wurzeln entwickelt, um an Grundwasser zu gelangen. Dicke Stämme können außerdem große Mengen an Wasser speichern, um lange Trockenperioden zu überdauern. Liebesgräser speichern Wasser im Wurzelsystem und können immer wieder neu wachsen, solange dieses erhalten bleibt. Pflanzen, die Wasser in Pflanzenorganen speichern, nennt man Sukkulenten. Manche Pflanzen haben die Form ihrer Blätter so angepasst, dass sie kaum Wasser verlieren.

Wo Pflanzen Nahrung bieten, folgen auch Tiere. Das Dromedar ist ein wahrer Wüstenspezialist. Es kann viel Wasser in seinem Magen speichern, allerdings nicht in seinem Höcker. Dort legt es Fettreserven an. Dromedare zählen zwar zu den Paarhufern, doch haben sie im Laufe ihrer Evolution statt Hufen schwielige Polster ausgebildet, die für die Bewegung auf sandigem Untergrund besser geeignet sind.
Die Vierzehen-Springmaus ist ein kleines Nagetier, das einfache Erdhöhlen als Behausung gräbt, um der Tageshitze zu entgehen und sich von Pflanzen ernährt. Der Sandfuchs macht Jagd auf andere Tiere der Wüste. Auch er verbringt die heiße Tageszeit in seinem unterirdischen Bau und jagt nachts, wenn es kühl ist.
Der Heilige Pillendreher ist ein Käfer, der sich vom Kot pflanzenfressender Säugetiere ernährt. Nach der Paarung formt der männliche Käfer eine Dungkugel, in die das Weibchen seine Eier legt. So verfügt der Nachwuchs nach dem Schlüpfen über einen Nahrungsvorrat.

Für Biologinnen und Biologen ist es immer spannend, Gemeinsamkeiten und Unterschiede zu untersuchen. Dadurch lernt man meistens etwas.

















Du hast den Wald als sehr artenreichen Lebensraum kennen gelernt. In den einzelnen Stockwerken des Waldes herrschen unterschiedliche Lebensbedingungen, die ganz unterschiedliche Tier- und Pflanzenarten begünstigen. So gibt es sehr viele Nischen, die von Lebewesen besetzt werden können. Das gilt vor allem für Regenwälder, die die artenreichsten Gebiete der Erde sind. In kalten Regionen, wie Kanada, Skandinavien und Sibirien, gibt es allerdings auch Wälder, die weit weniger artenreich sind. In diesen borealen Nadelwäldern wachsen oft nur wenige Baumarten und Lebewesen müssen sich an Kälte und längere Zeiten mit wenig Licht anpassen.
Auch Graslandschaften wie Wiesen und Savannen bieten mit ihren Stockwerken unterschiedliche Lebensbedingungen. Diese unterscheiden sich jedoch weniger voneinander als im Wald. Entsprechend ist die Artenvielfalt geringer. Zusätzlich unterscheiden sich die unterschiedlichen Arten von Graslandschaften, wie Wiesen in den Niederungen Mitteleuropas, Bergwiesen, Savanne und Steppe untereinander teilweise sehr in ihrer Artenvielfalt. Sie reichen von üppigen Lebensräumen, bis hin zu sehr trockenen und kargen Lebensräumen in Übergangsregionen zu Wüsten.



Zähle Tier- und Pflanzenarten in den einzelnen Lebensräumen, die du kennen gelernt hast, auf!
Wüsten bieten nur sehr wenigen, hochspezialisierten Lebewesen Lebensraum und das in geringer Zahl. Hier kann sich im Vergleich zum Wald nur eine sehr geringe Artenvielfalt entwickeln.
Finde jeweils eine Tier- und Pflanzenart, die nur in einem der dir nun bekannten Lebensräume vorkommt! Dann begründe, warum sie dort geeignete Lebensbedingungen vorfinden!
Suche auf wikepedia.org nach „Artenvielfalt“ (du kannst den Begriff auch allgemein suchen und dir das Suchergebnis für Wikepedia herauspicken)! Dort gibt es eine Weltkarte, auf der die Anzahl der Arten pro km² dargestellt ist. Versuche, den einzelnen Bereichen Lebensräume zuzuordnen! Besprecht eure Ergebnisse in der Klasse!
Argumentiere mittels des Nahrungsnetzes, weshalb trockene Bedingungen sich ganz allgemein auf die Artenvielfalt auswirken!
Suche verschiedene Grasflächen in deiner Umgebung! Das können Natur-, Park-, oder Gartenflächen sein. Notiere dir, wie artenreich sie dir vorkommen und welche Bedingungen dort herrschen! Beobachte sie in Zeiten mit kaum Niederschlag! Wie entwickeln sie sich? Kannst du Gründe finden?

Abb. 29: Niedermoore unterscheiden sich teils gar nicht so sehr von Wäldern (Hohentauern Steiermark).
Die Lofoten – anderes Klima, andere Höhenstufen!


Die Lofoten sind eine Gruppe bergiger Inseln im Norden Norwegens und beherbergen viel unberührte Natur. Die Berge sind oft nur einige hundert Meter hoch. Doch aufgrund des harschen Klimas zeigen sie ein Pflanzenbild, wie es bei uns oft erst im hochalpinen Bereich zu finden ist.
Während in vielen Niedermooren ausreichend Nährstoffe zur Verfügung stehen, um eine breitere Artenvielfalt hervorzubringen, sind die Lebensbedingungen in Hochmooren gänzlich anders. Sie sind sehr arm an Mineralsalzen und gleichförmig in ihren Bedingungen. Daher können hier nur wenige Pflanzenarten existieren, die sich an diese Bedingungen angepasst haben und es gibt wenige Nischen. Die Tierwelt in diesem Lebensraum besteht zum Großteil aus gut angepassten Spezialisten. Im Vergleich zu Wäldern sind Hochmoore artenarm


Notiere die hauptsächlichen Ursachen dafür, dass in einem Lebensraum sehr schwere Lebensbedingungen vorherrschen! Begründe, weshalb sie das Leben schwer machen!
Hast du, oder jemand den du kennst Pflanzen zu Hause? Wie müssen diese gepflegt werden? In welcher Art Erde wachsen sie? Haben sie besondere Formen und Eigenschaften?
Versuche daraus auf ihren ursprünglichen Lebensraum zu schließen!
Erinnere dich! Wie nennt man die Faktoren eines Lebensraumes, die von der Umgebung vorgegeben sind?
Gebirge setzen sich meist aus unterschiedlichen Lebensräumen zusammen. Je nach Höhe, aber auch abhängig von ihrer geographischen Lage und wie schroff sich Hänge und Felsformationen darstellen, bieten sie unterschiedliche Lebensbedingungen. Diese reichen von artenreichen Wäldern an sanfteren und tiefer gelegenen Hängen bis hin zu eiswüstenartigen Bedingungen, die nur sehr wenigen Arten ein Leben ermöglichen, nahe der Gipfel.
Abb. 30: Typische Landschaft der Lofoten in Norwegen
Was lässt sich daraus lernen?
2 Je vielfältiger ein Lebensraum ist, desto mehr Nischen bietet er für verschiedene Arten. Sie können unterschiedlich leben und stehen so nicht in einem Konkurrenzverhältnis.
2 Niederschlagsmenge, Temperatur, Lichtverhältnisse, Nährstoffangebot und Bodenbeschaffenheit nehmen großen Einfluss auf die Artenvielfalt. Auch nach ihnen kann man Lebensräume (weiter) unterteilen.
2 Je spezieller die Bedingungen eines Lebensraums sind, desto besser müssen seine Lebewesen daran angepasst sein, um zu überleben. Es gibt wenige Nischen zu besetzen.
Beachte: Sehr artenreiche Lebensräume verfügen über ein sehr reichhaltiges, weit verzweigtes Nahrungsnetz. Gehen einzelne Arten verloren, wirkt sich das auf das gesamte Netz nicht so stark aus. In derartigen Lebensräumen führen Störungen eher langsam zu einem Ungleichgewicht.
In sehr kargen, artenarmen Lebensräumen ist das Nahrungsnetz dünn besetzt. Einzelne Arten, die verloren gehen, wirken sich stark auf das gesamte Netz aus. Organismus und Lebensweise sehr spezialisierter Arten sind ganz an die herrschenden Bedingungen angepasst. Diese Arten kommen nur schwer mit veränderten Lebensbedingungen zurecht. Störungen derartiger Lebensräume führen schnell zu einem Ungleichgewicht
Heute gibt es kaum einen Lebensraum, in den der Mensch nicht eingreift. Jedoch sind die Art der Eingriffe sowie ihre Auswirkungen sehr unterschiedlich.
Rohstoffe – der Mensch nimmt, was er braucht
In Wälder greift der Mensch besonders stark ein. Ein Grund dafür ist, dass wir Menschen Holz als Rohstoff für uns verwenden. Dies geschieht schon seit langer Zeit. Bereits die Kelten holzten vor etwa 2000 Jahren große Waldflächen im Burgenland ab, um Holzkohle zur Eisengewinnung herzustellen. In vielen Ländern werden abgeholzte Waldflächen wieder aufgeforstet. Das ist wirtschaftlich notwendig, sonst gäbe es bald kein Holz mehr. Aber auch der Erhalt des Waldes als gesundes Ökosystem spielt eine Rolle und gewinnt immer mehr an Bedeutung. Da das Wachstum neuer Bäume viele Jahre braucht, erhält der Wald längere Zeiten, in denen er weitgehend ungestört bleibt.

Da nur bestimmte Baumarten forstwirtschaftlich genutzt werden, entstehen durch Aufforstung meist Monokulturen. Dies wirkt sich auf die gesamte Artenvielfalt und damit auch auf die Widerstandskraft des Waldes gegenüber Störungen und Veränderungen aus. Gerade der Klimawandel und die Veränderungen, die er bringt, verdeutlicht dies drastisch, wie du am Beispiel der Fichte gelernt hast. Wird der Wald nicht aufgeforstet geht Waldfläche, oft auf lange Zeit, verloren. Das ist besonders in den tropischen Regenwäldern, teilweise aber auch in den alten Wäldern Europas, beispielweise in Rumänien durch illegale Holzfällertätigkeiten, der Fall.


Recherchiert in Kleingruppen über den Braunkohleabbau in Deutschland. Welche Auswirkungen hatte und hat dieser? Gab es Konflikte? Was wird getan, um die Auswirkungen des Bergbaus wieder rückgängig zu machen?
Zerstörung des Regenwaldes!
Rohstoffe sind auch in anderen Lebensräumen der Grund für Eingriffe des Menschen. In Mooren wird Torf abgebaut und dabei Moorland vernichtet. Bodenschätze wie Edelmetalle, seltene Erden, Erdöl und Erdgas werden oft ohne viel Rücksicht auf die Lebensräume, unter denen sie liegen, abgebaut. Oft werden für den Abbau giftige Chemikalien verwendet, die großen Schaden anrichten, wenn sie in die Umwelt gelangen.
In Europa herrschen für den Abbau von Rohstoffen strenge Bestimmungen. Anderswo auf der Welt ist das oft nicht so. Auch in Österreich nutzen wir Rohstoffe aus solchen Ländern. Ein schwieriges Abwägen zwischen Umweltschutz und wirtschaftlichen Bedürfnissen.
Der tropische Regenwald leidet stark unter Abholzung und Brandrodung. Das geschieht wegen seiner wertvollen Hölzer, aber auch um an andere Rohstoffe zu gelangen und Land zu gewinnen. Da die Artenvielfalt in Regenwäldern besonders groß ist, verlieren auch besonders viele Arten dadurch ihren Lebensraum.

Finde heraus, wie viel Regenwaldfläche in den letzten drei Jahren jeweils verloren ging! Das Wievielfache der Fläche von Österreich war das jeweils? Steigen oder sinken die Zahlen?

Teilt euch in der Klasse in Teams auf! Jedes Team versucht für einen Rohstoff ein Abbaugebiet auf der Welt zu finden! Notiert wo es liegt, welcher Lebensraum dort vorherrscht. Wie wurde der Lebensraum beeinflusst? Beispiele für Rohstoffe sind: Gold, Silber, Diamanten, Kohle, Lithium, Erdöl, Erdgas aber es gibt noch einige mehr.
Wie ließe sich das Mähen in Gärten gestalten, um den Lebensraum Wiese nicht zu stark zu stören?

Abb. 36: Englischer Rasen, Ideal vieler Gartenbesitzer.
Sieh dir Wiesenflächen in deiner Umgebung an! Wie werden sie gestaltet? Wie gut eignen sie sich in diesem Zustand als Lebensraum? Tauscht euch in der Klasse aus!
Argumentiere, weshalb Überweidung in unbesiedelten
Naturlandschaften nur zeitweise vorkommt! Denke dabei daran, wie sich Ökosysteme selbst im Gleichgewicht halten! Entwickle daraus eine Anleitung zur nachhaltigen Nutzung von Weideflächen!
Was denkst du?
Viehzucht – viel Vieh braucht viel Nahrung
Wiesen werden vom Menschen regelmäßig gemäht. So ändern sich die Lebensbedingungen immer wieder sehr rasch. Das stellt einen starken Eingriff in den Lebensraum dar und nur wenige Tier- und Pflanzenarten kommen damit klar.
Intensive Viehzucht hat einen ähnlichen Effekt nur ohne die Wachstumspausen dazwischen.
Eignen sich dieselben Rindersorten zur Viehhaltung auf der Alm wie im Flachland oder in reiner Stallhaltung? Begründe deine Antwort! Falls nicht, welche Unterschiede müsste es geben?

Wenn eine zu hohe Anzahl an Weidetieren die vorhandene Pflanzendecke abgrasen, können die Pflanzen nicht mehr schnell genug nachwachsen, um die gefressene Pflanzenmasse zu ersetzen. Man spricht von Überweidung. Geschieht dies über einen längeren Zeitraum nimmt die Zahl der Pflanzen stetig ab. War die Landschaft vorher schon karg kann das im Extremfall zur Bildung einer Wüste führen. So ist der Mensch in manchen Gebieten der Welt an der Entstehung von Wüsten direkt als Ursache beteiligt.
Geschieht Viehwirtschaft verantwortungsbewusst, hat sie jedoch positive Effekte. Man geht heute davon aus, dass sich viele Graslandschaften der Erde durch große Herden an natürlich vorkommenden Weidetieren gebildet und erhalten haben. Diese fraßen Triebe von neu sprießenden Büschen und Bäumen ab, so dass sie sich nicht durchsetzen konnten. In den Savannen passiert durch die großen Wildtierherden ähnliches. In Österreich hat die Bewirtschaftung von Almwiesen denselben Effekt. Ohne sie würden viele Almwiesen mit Büschen zuwachsen. So sorgt die Viehwirtschaft in den Bergen für den Erhalt des Naturraumes in seiner jetzigen Form.

Wo es keine großen wild lebenden Weidetierherden mehr gibt, können Nutztiere deren Rolle übernehmen. Dafür braucht es aber verantwortungsbewusste Viehwirtschaft im Gleichgewicht mit der Natur.

Abb. 37: Viehzucht in den Steppen der Mongolei.
Landnahme – der Mensch braucht Platz
Ein zweiter Grund, warum der Mensch besonders stark in Wälder eingreift, ist die Gewinnung von Land. Das Roden von Wäldern war seit jeher eine Möglichkeit für den Menschen, neue Flächen zu nutzen. Durch moderne Maschinen ist das heute mögliche Ausmaß jedoch um ein Vielfaches größer als früher. Gerodete Waldfläche wird hauptsächlich für die Land- und Viehwirtschaft genutzt. Besonders in tropischen Breiten, wo die klimatischen Bedingungen gut sind, weiden auf ehemaligen Regenwaldflächen Rinder und anderes Nutzvieh beziehungsweise werden vor allem Soja und Ölpalmen angebaut.

Abb. 38: Ölpalmenplantage in Indonesien, wo vorher Regenwald stand.
Viele Moore wurden Opfer von Landnahme. Der Mensch legte sie trocken, um auf diesen Flächen Landwirtschaft zu betreiben. In Europa ist dadurch ein Großteil der Moorflächen zerstört worden. Mittlerweile werden Moore jedoch gezielt wieder hergestellt.


Wir alle bestimmen mit!
Die auf gerodeten Waldgebieten wachsenden Rohstoffe und daraus hergestellte Produkte sind in allererster Linie für den Verkauf in andere Länder gedacht, auch nach Österreich und Europa. Was wir einkaufen, bestimmt so über das Schicksal von Lebensräumen weltweit mit.
Auch große Graslandschaften, wie die Steppen Zentralasiens und die Savannen Afrikas mussten unter Zerstörung zugunsten von Landwirtschaft leiden. Das Abwägen und Verhandeln von Ernährungsinteressen und Naturschutz ist eine schwierige Sache.
Berge und Wüsten sind naturgemäß weniger von Landnahme betroffen, da sie dem Menschen weniger Möglichkeiten bieten. Trotzdem wird für Siedlungs- und Nutzraum auch ihnen Fläche abgetrotzt.
Abb. 39: Maisfelder in den USA, wo einst Prärie vorherrschte

Tourismus und Erholung – der Mensch ist gern in der Natur
Berge und Wald sind in Österreich beliebte Ausflugsziele. Du hast bereits gelernt, dass sich das auf die Lebensräume dort auswirkt. Besonders im Gebirge sind Tourismus und Freizeitaktivitäten ein sehr wesentlicher Einflussfaktor des Menschen. Schöne Natur wird weltweit gerne aufgesucht. Tourismus braucht Infrastruktur, wie Straßen, Gastronomie und Unterbringung, die oft auf Kosten von Lebensraum errichtet wird.
Die Anwesenheit des Menschen ist für die Tier- und Pflanzenwelt in der Regel störend Oft hinterlassen Menschen Müll oder nehmen sich Andenken mit. All das sind Eingriffe, die vor allem empfindliche Lebensräume aus dem Gleichgewicht bringen können. Deshalb ist es sehr wichtig, sich in geschützten Gebieten an die Regeln zu halten und darauf zu achten, möglichst wenig auf die Lebewesen dort einzuwirken.
Recherchiere zu den Mooren Österreichs! Auf welchen früheren Moorflächen wird heute Landwirtschaft betrieben? Welche Maßnahmen werden ergriffen, um Moore wieder herzustellen?
Sieh dich in der Natur deiner Umgebung um! Welchen Einfluss hat der Mensch durch Freizeitaktivitäten darauf? Welche Aktivitäten sind das und wie wirken sie sich aus? Besprecht eure Beobachtungen in der Klasse! Schreibt einen Aktionsplan zur Verringerung dieser Einflüsse!
Abb. 40: Unberührte Berglandschaft?

Weshalb ist der Gedanke „Was macht es schon, wenn ich das tue.“ einzelner Menschen problematisch? Argumentiere und finde Beispiele dafür!

Lies dir folgende Beschreibungen zu Lebewesen durch! Ordne sie dann dem Bild jenes Lebensraums zu, in dem sich die beschriebenen Merkmale zur Anpassung entwickelt haben könnten!
1 Die großen Ohren des Tieres helfen ihm durch Wedeln, Körperwärme abzugeben. Bei den oft hohen Temperaturen seiner Umgebung ist das auch notwendig. Seine Nase ist zu einem geschickten Greifwerkzeug ausgeformt, mit dem es Blätter von den vereinzelt stehenden Bäumen pflückt. Starke Beine helfen dem Tier, große Distanzen zurückzulegen, um bei Trockenheit neue Nahrung zu finden.


2 Dieses Tier ist ein wendiger Flieger und kann in dicht bestandener Umgebung sicher und schnell manövrieren. Das ist wichtig, um in seinem reich strukturierten Lebensraum erfolgreich jagen zu können. Sein Speiseplan ist vielseitig, da der Lebensraum des Tieres eine breite Artenvielfalt bietet. Zum Brüten braucht das Tier kleine Hohlräume, wie sie in Baumbeständen zu finden sind.

3 Diese Pflanze braucht sich um Wasser nicht zu sorgen. Trotzdem ist ihr Leben nicht gerade üppig. Um genügend Nährstoffe zu bekommen, verbindet sie ihre Wurzeln mit unterirdischen Pilzgeflechten. Sie liefert dafür Kohlenhydrate aus der Photosynthese an den Pilz. Die Pflanze kann sich Lichthunger erlauben, Schatten gibt es in ihrem Lebensraum kaum.








4 Dieses Tier kann sich gut in sehr lockerem Untergrund eingraben und regelrecht hindurchschwimmen. Wenn der leichte Nebel kommt, der immer wieder in seinem Lebensraum auftritt, hebt es sein Hinterteil in die Höhe. Dabei kondensiert das Wasser am Hinterleib und rinnt dem Tier in den Mund. Andere Wasserquellen sind in seinem Lebensraum sehr schwer zu finden.
















Alpensalamander und Höllenotter sind in den Alpen vorkommende Varianten des Salamanders und der Kreuzotter. Sie sind dunkler gefärbt als ihre Artverwandten.


Abb. 41: Salamander und Viper sind in hohen Lagen schwarz gefärbt


Abb. 42: Färbung des Feuersalamanders und der Kreuzotter
a) Zieh an einem sonnigen Tag ein weißes T-Shirt an und stell dich damit für einige Zeit in die Sonne! Wiederhole das nun mit einem schwarzen T-Shirt!
b) Denke über deine Beobachtung nach. Begründe, weshalb sich in großen Höhen die schwarze Färbung des Alpensalamanders und der Höllenotter durchgesetzt haben!


Das Erfassen, Verstehen und Beobachten von Lebensräumen ist ein wichtiges Betätigungsfeld für Biologinnen und Biologen. Dabei braucht es Spezialisten, die Tiere, Pflanzen und Pilze zuordnen können, und deren Lebensweisen verstehen, aber auch Fachleute für die größeren Zusammenhänge.
Für den Naturschutz ist es wichtig, zu wissen, welche Arten in einem Lebensraum in welcher Zahl leben. Daher müssen die Populationen gezählt und beobachtet werden
Dafür stehen manchmal nur Spuren, Fellreste, oder Kot zur Verfügung. Veränderungen im Lebensraum müssen in einem größeren Zusammenhang wie Klima, Anwesenheit des Menschen oder Umweltbelastungen verstanden werden. Hier ergeben sich oft Berührungspunkte mit anderen Wissenschaften. Biologinnen und Biologen tragen viele Daten zusammen, um daraus Schlüsse zum Zustand und der möglichen Entwicklung eines Lebensraums zu ziehen. In Naturparks führen und informieren Biologinnen und Biologen Besucherinnen und Besucher. Auch übernehmen sie wichtige Aufgaben zur Pflege sowie dem Schutz und Erhalt der Naturparks und deren Bewohner.
2 1 3
Bestandsaufnahme im Wald! Du hast nun schon einige Übungen zum Auffinden und Bestimmen von Pflanzen und Tieren im Wald absolviert. Trage deine Erkenntnisse zusammen! Ergänze sie durch weitere Expeditionen in den Wald!
Erstelle eine Beschreibung, welche Pflanzen und Tiere du im Wald in deiner Umgebung gefunden hast! Führe jeweils an, was die wichtigsten Eigenschaften der Lebewesen sind und wo und wie häufig du sie angefunden hast! Vergleicht in der Klasse und erstellt ein Plakat „Unser Wald“, auf dem ihr die wichtigsten Informationen zusammenfasst!
Wie nutzen die Menschen den Wald in deiner Umgebung? Begib dich in den Wald und beobachte aktiv, wie Menschen ihn nutzen! Manchmal muss man die Menschen nicht dabei beobachten, sondern Spuren, die sie hinterlassen, geben Hinweise auf deren Aktivitäten! Denke über Unterschiede in den Jahreszeiten nach!
Verfasse einen kurzen Bericht zu den Aktivitäten der Menschen im Wald deiner Umgebung, welche Spuren sie dabei hinterlassen und welche Auswirkungen das auf den Wald hat! Vergleicht in der Klasse und entwickelt Ideen um die Auswirkungen zu verringern und den Wald zu schützen!
Lebensraum Vergleich! Untersuche andere Lebensräume deiner Umgebung! Beispielsweise die Stadt oder das Dorf, in dem du wohnst oder landwirtschaftliche Flächen in der Umgebung. Welche Tiere und Pflanzen kannst du beobachten?
Vergleiche die Lebensräume mit dem Wald und untereinander! Haben sie sich verändert, seit du sie kennst?



So schätze ich mich nach dem Großkapitel LEBENSRAUM WALD selbst ein: Kreuze jenen Daumen an, der für dich am ehesten zutreffend ist!
…abiotische und biotische Faktoren unterscheiden und aufzählen.
…erklären, was eine ökologische Nische ist.
…das ökologische Gleichgewicht diskutieren.
…den ökologischen Kreislauf in einem Wald analysieren.
…die Merkmale von naturnaher Waldwirtschaft diskutieren.
…erörtern, welche Gefahren es für die Fichtenbestände in Österreich gibt.
…die Stockwerke in einem Wald vergleichen.
…Vor- und Nachteile von Monokulturen diskutieren.
…die Besonderheiten von Auwäldern erörtern.
…erklären, wie Nahrungsketten und Nahrungsnetze zusammenhängen.
…einen Zusammenhang zwischen dem Wildbestand und Schäden an Bäumen herstellen und Wildschäden erkennen.
…Einige Baumarten in Österreichs Wäldern bestimmen.
…die Gefahren des Klimawandels für die Wälder beschreiben.
…über die Eingriffe des Menschen in das Ökosystem Wald diskutieren.
…begründen, warum Wälder als Schutz gegen Lawinen und Muren wichtig sind.
…erklären, welche Bedeutung der Wald als Wasserspeicher hat und beschreiben, wie der Wald zur Luftverbesserung beiträgt.
…zusammenfassen, welche wirtschaftliche Bedeutung der Wald hat.
Um deine Kompetenzen noch mehr zu steigern, hier unsere Buchtipps:
Michael König: Julius forscht – Im Wald: Forschen, Entdecken, Basteln (Olivia Verlag, 2021).



Rosa Wetscher: GEOlino extra 95/2022 –Unser Wald: Monothematisches Themenheft für kleine Abenteurer (Gruner + Jahr, 2022).
Frank und Kathrin Hecker: Der große Naturführer für Kinder (Verlag Eugen Ulmer, 2020).










Alle Lebewesen sind aus winzigen Bausteinen – den Zellen – aufgebaut. Wenn du ein Mikroskop verwendest, kannst du diese kleinsten Bausteine des Lebens sehen.



Blattgewebe

Zellen eines Blattquerschnittes




GEWEBE


ZELLE

Mund
Mensch und Tier


Mundschleimhaut

Zelle der Mundschleimhaut
Viele gleichartige und miteinander verbundene Zellen erfüllen bestimmte Aufgaben. Diese Zellverbände nennt man Gewebe.
Pflanzliche Gewebe
Leitungsgewebe
Festigungsgewebe
Abschlussgewebe


Wie wurden die Zellen entdeckt?
1665 entdeckte der englische Forscher Robert Hooke beim Mikroskopieren von „Korkstückchen“, dass sie aus sehr kleinen wabenförmigen Kammern zusammengesetzt sind. Diesen Kammern gab er den Namen Zellen.
Grundgewebe
Pflanzliche Organe
Sprossachsen
Blätter
Wurzel
Aufbau von Zellen
Menschliche oder tierische Gewebe
Muskelgewebe
Hautgewebe
Nervengewebe
Binde- und Stützgewebe
Menschliche oder tierische Organe
Herz Gehirn
Magen Augen
Haut Ohren
Jedes Lebewesen – also Pflanzen, Tiere und auch der Mensch – besteht aus einer oder vielen Zellen. Die Bestandteile der Zellen nennt man Organellen.

Sieh dir deinen Mund genau an! Welche Aufgabe hat er? Ist er dafür gut geformt? Welche unterschiedlichen Gewebetypen kannst du in ihm vermuten? Was ist ihre Aufgabe? Sind sie dafür passend geformt? Recherchiere falls nötig!


Zellen in Zahlen
Der menschliche Körper besteht aus ca. 220 verschiedenen Zell- und Gewebetypen. Man schätzt, dass der menschliche Körper eines Erwachsenen zwischen 10 und 100 Billionen Zellen hat.
Gehe zum Kapitel Sehsinn! Welche Gewebetypen sind beteiligt?
Finden sich alle im selben Organ? Nenne auch die Funktionen der Gewebe!

Abb. 1: Größenvergleich:
1. Fettzelle, 2. Muskelzelle, 3. Samenzelle, 4. Eizelle, 5. Knochenzelle
Zellmembran, die: Abgrenzung zwischen den Zellen, durch die der Stoffaustausch stattfinden kann
Erbinformation, die: Information über alle Merkmale, die ein Lebewesen ausmachen und die an die Nachkommen weitergegeben werden
Erstelle eine Bildlegende! Welche Abbildung stellt welche Zelle dar?

Bildet Gruppen und stellt jeweils ein Modell einer tierischen und einer pflanzlichen Zelle her! Überlegt zuerst, was ihr alles benutzen könnt! Kleine
Plastiksackerl, Schuhschachtel, …
Vergleiche, wie die Kennzeichen des Lebens bei verschiedenen Lebewesen erkennbar sind!
Wie können z. B. Pflanzen Bewegungen ausführen oder auf Umweltreize reagieren?
Recherchiere aktiv!
Pflanzliche Zellen und tierische Zellen...
... haben einen ähnlichen Bauplan:
2 Zellen werden nach außen durch die Zellmembran abgegrenzt.
2 Das Zellplasma besteht vorwiegend aus Wasser, aber auch Eiweißen, Kohlenhydraten, Fetten und Salzen.
2 Jede Zelle hat einen Zellkern. In ihm ist die Erbinformation gespeichert. Er ist für die Steuerung der Zelle verantwortlich. Eine Kernhülle umgibt den Zellkern.
2 Der Golgi-Apparat ist wichtig für den Stoffwechsel in der Zelle.
2 In den Ribosomen werden Proteine hergestellt.
2 Auch im endoplasmatischen Retikulum werden Proteine hergestellt und weitergeleitet.
2 In den Mitochondrien werden Nährstoffe verarbeitet und die Energie bereitgestellt, die die Zelle braucht.
...unterscheiden sich durch diese Merkmale:
2 Pflanzenzellen haben zusätzlich eine feste Zellwand, die für die Festigkeit der ganzen Pflanze sorgt.
2 Pflanzliche Zellen besitzen Vakuolen. Dies sind mit dünnflüssigem Zellsaft gefüllte Räume in der Zelle.
2 Pflanzenzellen haben außerdem noch Farbstoffträger, die für die Farbe zuständig sind. Wenn sie das für die Pflanzen sehr wichtige Chlorophyll enthalten, heißen sie Chloroplasten. Sie ermöglichen die Fotosynthese.
Golgi-Apparat Ribosomen Zellmembran
endoplasmatisches Retikulum
Zellkern Kernhülle Mitochondrien Zellplasma
Zellwand Farbstoffträger



Kennzeichen des Lebens
Jede Zelle und somit jeder Organismus hat bestimmte Merkmale, die beweisen, dass es sich um etwas Lebendiges handelt:
Lebewesen...
...werden größer, sie wachsen und entwickeln sich.
...pflanzen sich fort und vermehren sich.
...haben einen Stoffwechsel. Stoffe werden aufgenommen, umgebaut und die Reste werden wieder ausgeschieden. bewegen sich.
...Lebewesen können Informationen aus ihrer Umwelt wahrnehmen und darauf reagieren (z. B. auf Licht oder Geräusche).
Zellen teilen sich
Wenn ein Lebewesen wächst, nimmt die Anzahl der Körperzellen zu. Das geschieht, indem sich die Zellen teilen.
Eine Zellteilung beginnt im Zellkern. Dort ist die Erbinformation, also der Bauplan des Lebewesens und jeder seiner Zellen, gespeichert. Diese Erbinformation ist in den Chromosomen enthalten. Das sind lange, dünne, Fäden, die sich vor der Zellteilung zusammenziehen. Außerdem löst sich die Kernhülle auf.
1. Schritt: Die Chromosomen teilen sich. Aus jedem Chromosom entstehen zwei identische Chromosomen.
2. Schritt: An den entgegengesetzten Seiten der Zelle bilden sich Fasern zu den Chromosomen.
3. Schritt: Die Fasern ziehen die Chromosomen auseinander.
4. Schritt: die Zellmembran schnürt sich ein und es entstehen zwei identische Zellen.
Schließlich bildet sich in jeder Zelle eine neue Kernhülle, die die Chromosomen einschließt.


Wie viele Chromosomen haben wir?
In den Körperzellen kommen die Chromosomen paarweise vor. Jeder Mensch hat 22 Paare von identischen Chromosomen. Das 23. Paar ist je nach Geschlecht unterschiedlich. Frauen haben in diesem Paar zwei identische X-Chromosomen, Männer ein X- und ein YChromosom.

Veränderung findet im
Hin und wieder kann es in einem Chromosom zu einer Veränderung kommen, die man Mutation nennt. Das kann durch einen Fehler beim Verdoppeln des Chromosoms passieren oder durch äußere Einflüsse wie etwa Strahlung. Dann hat eine Zelle eine etwas andere Information als alle anderen Zellen im Körper.
Meist führt so eine Veränderung dazu, dass die Zelle abstirbt. Manchmal beginnen veränderte Zellen jedoch unkontrolliert zu wachsen: Ein Tumor entsteht.
Mutationen treiben die Evolution an
Auch die Ei- und Samenzellen enthalten Chromosomen. Allerdings treten sie dort nicht paarweise auf, sondern nur einfach. Bei der Befruchtung werden so die Erbinformationen der Eltern durchmischt. Eine Mutation in einer der Zellen kann dazu führen, dass die Nachkommen andere Eigenschaften als die Eltern haben. Sind die neuen Eigenschaften vorteilhaft, werden sie an die nächsten Generationen weitergegeben.
Tumor, der: Wucherung von Zellen. Wird dabei gesundes Gewebe zerstört, spricht man von Krebs
Beschreibe mit eigenen Worten, wie die beiden Mechanismen der Evolution – die Mutation und die Selektion – zusammen wirken und so zu einer Weiterentwicklung von Lebewesen führen!
Suche dir ein Lebewesen aus und nenne jeweils ein Beispiel!














Hier fehlt ja einiges! Finde Beispiele für die Kennzeichen des Lebens und schreibe sie in die freien Felder!
Bewegung
Wachstum und Entwicklung
Fortpflanzung und Vermehrung
Pubertät
Stoffwechsel
Verdauung von Nahrung
Ausrichten nach der Sonne

Reizbarkeit
Bilden von Samen
Blüten schließen sich in der Nacht.
Mit einem Mikroskop kannst du kleinste Dinge sehen, die du mit dem freien Auge nicht erkennen kannst. In der Biologie ist es ein wichtiges Hilfsmittel, um feine Strukturen von Lebewesen zu sehen und zu beschreiben.
Durch das OKULAR betrachtest du das Bild. Das Okular ist eine Linse und vergrößert das Objekt.
Am OBJEKTIVREVOLVER sind mehrere Objektive (Vergrößerungslinsen) drehbar angebracht.
Die OBJEKTIVE vergrößern das Bild: 5 x, 10 x oder 40 x.
Durch die BLENDE kann die Helligkeit reguliert werden.
Der OBJEKTHALTER hält den OBJEKTTRÄGER am OBJEKTTISCH fest. Der KONDENSOR bündelt die Lichtstrahlen.

1. SCHRITT: Vorbereitung
Der TUBUS ist die Röhre zwischen Okular und Objektiv.
Der GROBTRIEB und der FEINTRIEB verschieben den Objekttisch und dienen zum Scharfstellen des Objektes.
Wie berechnet sich die Vergrößerung?
Die BELEUCHTUNG leuchtet das Objekt von unten aus.


Mit einem Lichtmikroskop erreicht man eine bis zu 1 000-fache Vergrößerung. Die Vergrößerung eines Mikroskops errechnet sich aus der Vergrößerung des Okulars, multipliziert mit der Vergrößerung des Objektivs. Angenommen, das Okular vergrößert 10-fach und das Objektiv ebenso. Dann ist die Gesamtvergrößerung 10 x 10 = 100, also 100-fach.
Wähle das Objektiv mit der geringsten Vergrößerung, indem du den Objektivrevolver drehst!
2. SCHRITT: Auflegen des Objektträgers
Lege nun dein Präparat auf den Objekttisch und zwar in den Lichtstrahl über die Öffnung!
Anschließend schalte die Beleuchtung ein und schaue durch das Okular!
3. SCHRITT: Scharfstellen des Bildes
Bringe mit dem Grobtrieb den Objekttisch mit dem Objekt langsam nach oben zum Objektiv heran! Achte darauf, dass sich das Objekt und das Objektiv nicht berühren! Stoppe, wenn du das Objekt scharf sehen kannst!
Nun kannst du mit dem Feintrieb noch schärfer stellen. Eine stärkere Vergrößerung erreichst du, indem du den Revolver weiterdrehst und mit dem Feintrieb wieder scharf stellst.
4. SCHRITT: Helligkeit und Kontrast
Stelle mit der Blende die Helligkeit und den Kontrast ein!
5. SCHRITT: geeignete Stelle suchen
Schaue durch das Okular und verschiebe gleichzeitig den Objektträger! Verschiebe so lange, bis du einen geeigneten Objektbereich gefunden hast, den du dir genauer ansehen willst!
ACHTUNG: Wenn du durch das Okular schaust, pass auf! Drehe den Objekttisch nicht nach oben, ohne den Abstand zwischen Objekt und Objektiv zu kontrollieren! Überlege: Was könnte passieren?
Bei einem Durchlichtmikroskop, wie es auf S. 65 abgebildet ist, wird das Objekt von unten mit Licht bestrahlt. Daher muss das Objekt sehr dünn sein. Bevor du ein Objekt unter dem Mikroskop betrachten kannst, musst du es daher präparieren. Probiere es mit der Schuppenhaut einer Küchenzwiebel aus, denn sie lässt sich leicht präparieren.
Durchlichtmikroskop, das: durchleuchtet das Objekt von unten


Pipette



Deckgläschen

1



2
Du brauchst: Messer % Skalpell % Pipette % Pinzette % Deckgläschen % Objektträger
Viertle mit dem Messer eine Küchenzwiebel! Schneide sie dazu erst in der Mitte durch und dann der Länge nach! Auf der Innenseite der Zwiebelschuppe befindet sich ein dünnes, durchsichtiges Häutchen. Löse dann eine Schuppe heraus!

Bringe zuerst einen Tropfen Wasser mit dem Finger oder einer Pipette auf die Mitte des Objektträgers!

3

Ritze mit dem Skalpell in das dünne Häutchen auf der Innenseite einer Zwiebelschuppe ein 0,5 cm großes Quadrat! Dann ziehe das innere dünne Häutchen mit einer Pinzette ab und lege es auf den Objektträger!
Objektträger

1
Führe die Präparation nun selbst durch! Dann mikroskopiere das Präparat und zeichne zwei Zellen!
4


Lege nun vorsichtig ein Deckglas auf! Achte dabei darauf, dass keine Luftbläschen eingeschlossen werden!
5


Zum Schluss tupfe das Präparat trocken! Dann kannst du es auf den Objekttisch legen.
1. Verwende weißes A4-Papier und zeichne möglichst groß!
2. Zeichne nur mit Bleistift und ziehe klare Striche!
3. Zeichne nur das, was du wirklich siehst!
4. Beschrifte deine Zeichnung! Ziehe dazu Striche mit dem Lineal!
5. Verfasse eine Überschrift, in der du angibst:
- Name des Objekts - Vergrößerung - Datum - deinen Namen

Mikroorganismen, manchmal auch Mikroben genannt, sind Lebewesen, die aus einer einzelnen, oder wenigen Zellen bestehen. Sie sind so klein, dass sie nur unter dem Mikroskop zu sehen sind. Mikro kommt aus dem Griechischen und bedeutet klein. Es gibt eine passende Längeneinheit zu den Größenordnungen dieser „Kleinen Organismen“, nämlich das Mikrometer (μm). Es beträgt ein Tausendstel eines Millimeters.
Mikroorganismen sind keine einheitliche Gruppe. Der Begriff umfasst sehr unterschiedliche Lebewesen. Die meisten von ihnen vermehren sich durch Zellteilung. Algen sind Fotosynthese betreibende Lebewesen mit Zellkern, die zumeist im Wasser leben. Viele Algenarten, man nennt sie Mikroalgen, sind Einzeller oder leben in Zellkolonien.

0,1 mm
Abb. 2: Jochalgenart, wie sie in Hochmooren und sauren Gewässern vorkommt.

Lichtsensor Augenfleck Chloroplast
Abb. 3: Augentierchen zählen zu den Algen. Augenfleck und Lichtsensor erlauben ihnen die Richtung des Lichteinfalls wahrzunehmen.
Auch Pilze kommen als Einzeller vor. Ein Beispiel sind Hefen, wie sie auch zum Backen verwendet werden. Wimpertierchen, wie die Pantoffel- und Trompetentierchen, erhalten ihren Namen von wimperförmigen Auswüchsen ihrer Zellmembran. Diese dienen der Fortbewegung und zum Herbeistrudeln von Nahrung, welche aus anderen Mikroorganismen besteht. Bakterien unterscheiden sich von den bisher genannten Lebewesen dadurch, dass sie keinen Zellkern haben. Archaeen besitzen ebenfalls keinen Zellkern, ähneln in vielen Eigenschaften aber den Lebewesen mit Zellkern. Lebewesen mit Zellkern, Bakterien und Archaeen bilden die drei grundlegenden Domänen, in die das Leben auf der Erde eingeteilt wird. Auch Viren werden zu den Mikroorganismen gezählt.


Abb. 5: Pantoffeltierchen leben vor allem im Süßwasser.
Abb. 6: Trompetentierchen sind für Einzeller sehr groß.
Mikroorganismen sind zwar winzig klein, dennoch haben sie eine wichtige Funktion im weltweiten Stoffkreislauf. Sie zersetzen organisches Material und setzen Sauerstoff, Stickstoff, Kohlenstoff sowie zahlreiche andere für das Leben wichtige chemische Stoffe frei.
Abb. 1: Eine einzelne Bakterie ist mit freiem Auge nicht sichtbar. Sie können sich jedoch sehr rasch vermehren und bilden dann Bakterienkulturen.

Abb. 4: Augentierchen unter dem Mikroskop
Abb. 3: Welche Aufgaben übernehmen deiner Meinung nach die grünen Bestandeile in der Augentierchenzelle (man nennt sie Chloroplasten)?
Abb. 3: Kannst du Zellbestandteile erkennen und benennen?
Besuche die Wikipedia Seiten von Augen- und Pantoffeltierchen und sieh dir die Videos an! Tipp: In der englischen Version gibt es mehrere Videos.


Was sind Viren?
Sie sind winzig klein und bestehen nur aus Erbinformation in einer Hülle. Wenn sie in eine Wirtszelle eindringen, werden sie von dieser vervielfältigt. Sie haben keinen Stoffwechsel und können sich nicht selbst vermehren. Daher ist nicht geklärt, ob Viren Lebewesen sind oder nicht.
Gentransfer!


Mikroorganismen haben verschiedene Möglichkeiten entwickelt, Erbinformation untereinander auszutauschen oder aus der Umgebung aufzunehmen. Das erlaubt es ihnen, beschädigtes Erbgut zu reparieren, aber vor allem auch vorteilhafte
Veränderungen rascher in der Population zu verbreiten. Bakterien können auch über die Artgrenzen hinaus Erbinformation austauschen und sogar Erbgut toter Organismen aufnehmen, selbst wenn dieses viele tausende Jahre alt ist.
Individuum, das: hier ein bestimmtes einzelnes Lebewesen in der Population
Meinst du der Zeitpunkt der Entstehung einer neuen Art lässt sich eindeutig festmachen? Formuliere Argumente für deine Antwort!

9: Früchte sind in Fruchtgummis selten drin.
Niemand weiß, wie viele Arten von Mikroorganismen es auf der Welt gibt. Doch es wird geschätzt, dass es mehrere Milliarden Arten geben könnte, von denen allerdings erst wenige entdeckt und näher erforscht sind.

Finde heraus, wo in deiner Nahrung überall „natürliche Aromen“ drinnen sind! Lies dafür die Zutatenliste auf der Verpackung! Besprecht eure Funde in der Klasse! Welche Folgen könnte es haben, hauptsächlich derartige Nahrungsmittel zu essen?
Mikroorganismen können selbst dort überleben, wo das andere Lebewesen nicht können. Durch ihre rasche Vermehrung entstehen in kurzer Zeit neue Generationen, die Veränderungen (Mutationen) aufweisen können. Mikroorganismen erlauben es, Evolution in überschaubaren Zeiträumen direkt zu beobachten.
Bringen diese Veränderungen verbesserte Überlebenschancen mit sich, erlangen jene Individuen, die die Veränderungen in sich tragen, einen Vorteil gegenüber jenen die dies nicht tun. Beispielsweise bringt erhöhter Widerstand gegen hohe Temperaturen einen Vorteil in heißen Umgebungen, die Fähigkeit hohe Temperaturen für den Stoffwechsel zu nutzen einen noch größeren. Lebewesen mit diesen Eigenschaften sind in heißen Umgebungen jenen ohne diese Eigenschaften überlegen. Mit der Zeit wird daher die Zahl der Individuen mit vorteilhaften Veränderungen in der Population steigen und die Zahl jener ohne diese Veränderungen sinken. Nach einer gewissen Zeit ist dann die Veränderung der Normalfall, ein neues Merkmal hat sich durchgesetzt. Werden die Unterschiede zu den ursprünglichen Eigenschaften über die Zeit groß genug ist, eine neue Art entstanden.
Durch vorteilhafte Veränderungen, also Anpassungen, schaffen es Mikroorganismen, sehr hohe und sehr niedrige Temperaturen sowie salzige oder saure Bedingungen zu überdauern. Sie finden sich auch in mit giftigen Stoffen verseuchten Umgebungen. Sogar im Inneren von Kernkraftwerken hat man Mikroorganismen gefunden.
Mikroorganismen leben nicht nur in mit Giften belasteten Ökosystemen, sie können diese Gifte häufig auch abbauen. So können sie zahlreiche chemische Stoffe in ihre Bestandteile zerlegen und so unschädlich machen. Nach Verschmutzungen mit Erdöl, wie sie beispielsweise nach einem Tankerunfall auftreten, können sie das Erdöl zerlegen und so die Umwelt reinigen


8: mit Erdöl verschmutzter Strand nach einem Tankerunfall
Mikroorganismen sind sehr wichtig für die Lebensmittelindustrie. Mit ihrer Hilfe lassen sich Geschmacksstoffe herstellen. Aus Speiseölen wird mit Hilfe von Hefepilzen Pfirsicharoma und Apfelgeschmack. Bakterien helfen dabei Himbeer-, Johannisbeerund Vanillearoma zu erzeugen. Da die Aromastoffe durch Vorgänge in Lebewesen entstehen, dürfen diese Aromastoffe als „natürliche Aromen“ bezeichnet werden. Die Frucht selbst ist da aber nicht drinnen.
Auf den ersten Blick scheint es, als wäre ein Lebewesen eine abgeschlossene Einheit, die nach außen im Austausch mit anderen Lebewesen steht. Tatsächlich sind aber vielzellige Lebewesen ihrerseits Lebensraum für verschiedenste andere Lebewesen, meist Mikroorganismen. Ein wenig hast du das schon bei den Flechten kennengelernt, bei denen Pilze Algen Raum für eine Lebensgemeinschaft bieten, von der beide profitieren – eine Symbiose. Du hast auch schon gelernt, dass manche Lebewesen andere als reine Nutznießer besiedeln, als Parasiten. Manchmal lösen solche Nutznießer auch Vorgänge in ihrem Wirt aus, die diesen ernsthaft schädigen, oder sogar töten. Man spricht dann in der Regel von Krankheitserregern. Auch der Mensch ist Lebensraum für eine Vielzahl an Mikroorganismen, vor allem Bakterien und Pilze. Die Gesamtheit dieser Mikroorganismen nennt man Mikrobiom.
Das menschliche Mikrobiom
Schätzungen gehen jedoch davon aus, dass ein erwachsener Mensch im Durchschnitt von etwa 39 Billionen Mikroorganismen besiedelt wird. Das ist etwas mehr als die durchschnittlich 30 Billionen Zellen, aus denen ein Mensch besteht. Bereits während der Schwangerschaft gelangen die ersten Mikroorganismen in den Köper des Embryos. Nach der Geburt entwickeln sich in jedem Menschen andere Kleinstlebewesen, sodass deren Zusammensetzung bei jedem Menschen anders ist.

Der größte Teil unseres Mikrobioms lebt im Darm. Doch auch Haut, Organe und die Schleimhäute der Körperhöhlungen wie Mund und Nase sind besiedelt. Viele der Mikroorganismen erfüllen wichtige Funktionen, leben also in Symbiose mit uns.


„Gespräche“ zwischen Bakterien und Pilzen! Auch Pilze sind sehr wichtig, um unser Mikrobiom im Gleichgewicht zu halten. Leben sie gemeinsam mit Bakterien, reagieren bestimmte Pilze und Bakterien auf chemische Stoffe, die vom jeweils anderen produziert werden. Die dadurch entstehenden Wechselwirkungen sind noch wenig verstanden, doch sie scheinen großen Einfluss auf uns zu nehmen.
Auf Haut und Schleimhäuten bilden sie einen Schutzmantel, der uns hilft, Krankheitserreger abzuwehren. Im Mund sind sie der Beginn unseres Verdauungssystems, zersetzen Nahrungsmittelreste und bauen Säuren ab. Ein gesundes Mikrobiom des Darms ist ausschlaggebend für Verdauung sowie Stoffwechsel. Es schützt uns vor Erkrankungen des Darms und hat wesentlichen Einfluss auf unser Immunsystem. Das Mikrobiom des Darms ist auch mit unserem Zentralnervensystem verbunden und beeinflusst unsere Psyche und unser Gemüt.
Schlechte Ernährung, Stress und Medikamente können das Darm-Mikrobiom schädigen. Die Folgen sind weitreichend. Verdauungsprobleme, Stoffwechselerkrankungen, Erkrankungen des Immunsystems bis hin zu Depressionen und psychischen Erkrankungen werden durch ein gestörtes Mikrobiom im Darm begünstigt.

Billion, die: sehr große Zahl, eine 1 mit 12 Nullen

Abb. 2: Bakterien bilden einen Belag auf der Zunge.
Notiere eine Woche lang, was du isst! Dokumentiere jede Mahlzeit und jeden Snack. Auch was du trinkst! Vergleicht in Kleingruppen!
Eine abwechslungsreiche Ernährung mit viel rohem Obst und Gemüse fördert die Gesundheit des Mikrobioms im Darm. Viel Zucker, Fette und Fleisch schädigen es. Wie ernährst du dich? Erstellt in der Klasse einen Ernährungsplan, der dein Mikrobiom gesund hält! Probiere ihn auch aus!
Depression, die: Krankheit, bei der man traurig und verzweifelt ist

Abb. 1: Masken schützen vor Ansteckung
übertragen: an jemand anderen weitergeben
Malaria, die: lebensgefährliche Krankheit, die in den Tropen vorkommt und bei der hohes Fieber auftritt

Abb. 2: Zeckenbiss
Abb. 2: Hat dich schon einmal eine Zecke gebissen? Berichte davon!
Hast du Auswirkungen gespürt? Bist du geimpft?
grippaler Infekt, der: Erkältung
Symptom, das: äußeres Anzeichen einer Krankheit
Genesung, die: gesund werden
Abb. 3: Stelle eine Vermutung auf, in welcher Phase der Infektion du andere Menschen anstecken kannst!
Begründe die Maßnahmen, die du ergreifst, wenn du an einer Infektionskrankheit
erkrankst! Was unternimmst du, um andere vor einer Ansteckung zu schützen?
Krankheiten, die durch Mikroorganismen ausgelöst werden, nennt man Infektionskrankheiten. Diese Krankheiten werden „weitergegeben“, indem die Mikroben, welche die Krankheit verursachen, weitergegeben werden. Die Ansteckung mit so einer Krankheit erfolgt, indem die entsprechenden Mikroorganismen in den Körper gelangen und sich dort vermehren: Man infiziert sich.
Kontakt mit Krankheitserregern
Krankmachende Mikroorganismen sind überall. Sie schweben in der Luft, sie haften auf Türschnallen oder auch auf der Haut von Menschen. Schüttelst du jemandem die Hand, können sie übertragen werden.
Oft beginnt man zu husten und weiß gar nicht, wo man sich damit angesteckt hat. Häufig erfolgt die Ansteckung durch eine Tröpfcheninfektion. Jemand, der die Krankheit bereits hat, hustet oder niest und scheidet dabei winzig kleine Tröpfchen aus, die lange in der Luft schweben können. In diesen Tröpfchen sind Krankheitserreger enthalten. Sie werden von anderen Menschen eingeatmet
Kommt man mit Krankheitserregern in Kontakt, heißt das noch lange nicht, dass man auch krank wird. Die Haut und die Schleimhäute in Mund, Nase und Rachen sind mit wirkungsvollen Abwehrkräften ausgestattet und schützen uns so. Sie können Mikroorganismen unschädlich machen. Das Mikrobiom spielt hier eine wichtige Rolle. Ist die Zahl an Krankheitserregern jedoch zu groß, sind die Abwehrkräfte überfordert und man wird krank.
Gelangen Mikroorganismen direkt in den Körper, reichen schon kleine Mengen davon aus, um eine Krankheit hervorzurufen. Das kann bei einer offenen Wunde, aber auch beim Biss oder Stich eines Insekts der Fall sein. So kann der Stich einer Mücke Malaria hervorrufen oder der Biss einer Zecke FSME oder Borreliose hervorrufen.
Stell dir vor, du hättest dich mit einem grippalen Infekt angesteckt. Unmittelbar nach der Infektion beginnt die Inkubationszeit. In dieser Zeit vermehren sich die Krankheitserreger, du hast jedoch noch keine Symptome. Danach bricht die Krankheit aus. Du fühlst dich nicht wohl. Dein Körper reagiert mit erhöhter Temperatur – du bekommst Fieber. In dieser Zeit kämpft dein Körper gegen die Krankheitserreger an. Im Allgemeinen werden sie nach einigen Tagen besiegt und die Symptome klingen ab.

Abb. 3: Krankheitsverlauf eines grippalen Infekts
ACHTUNG – grippale Infektion: Bringe die einzelnen Schritte, in denen die Infektion verläuft, in die richtige Reihenfolge, indem du richtig nummerierst! Tipp: Die Buchstaben ergeben ein Lösungswort, das in diesem Kapitel eine wichtige Rolle spielt!

Die Körpertemperatur steigt an. (E)


Die Schleimhäute schwellen an. (T)


1 Du bist gesund. (I)


Die Schleimhäute der Atemwege versuchen, die Krankheitserreger abzuwehren. (F)


In der Folge treten Husten und Schnupfen auf. (I)

Die Symptome klingen ab und die Körpertemperatur sinkt. (O)


Tröpfchen mit Krankheitserregern werden eingeatmet. (N)


Die Krankheit ist ausgestanden. (N)



2
Kopf- und Gliederschmerzen sind häufig die ersten Symptome. (K)
Lösungswort: I .
Richtiges Verhalten bei einer Infektion – Setze die Sätze richtig fort, indem du die Satzteile aus dem Kästchen auswählst!
…halte ich die Hand vor den Mund. © …lege mich ins Bett. © …trage ich einen MundNasen-Schutz © …gehe ich wieder in die Schule. © …niese ich in ein Taschentuch.

Um andere nicht anzustecken,
Erst wenn die Krankheit völlig ausgeheilt ist,
Beim Husten
Wenn ich niesen muss,
Ich schone mich und
3 1
Erkläre mit eigenen Worten die folgenden Begriffe! Was heißt...
Inkubationszeit: Tröpfcheninfektion: Symptom:


Wissenswertes über Bakterien
In 1 g Gartenerde finden sich mehr als 100 Mio. Bakterien, in einem cm3 Abwasser ca. eine Mio. Bakterien. Man kann sie auch in der Tiefsee und in 75 °C heißem Wasser finden.
Abwasser, das: durch Gebrauch verunreinigtes Wasser
Argumentiere, warum der Bau von Kanalisationen in Städten die Zahl an Ausbrüchen von Seuchen stark reduziert hat!

nach 20 Minuten
Bakterien kommen überall vor. Es gibt sie in der Luft, im Wasser und im Boden, aber auch in Pflanzen, Tieren und Menschen. Bakterien gehören zu den ältesten Lebensformen auf der Erde. Sie alle sind sehr einfach gebaut.
Bau der Bakterie
Speicherstoffe (Fette, Kohlenhydrate)
Erbinformation

Zellwand
Plasmahaut
Geißel
Zellplasma
Abb. 1: Aufbau eines Bakteriums. Die meisten sind Einzeller.
Die meisten Bakterien sind einzelne Zellen, haben aber keinen abgegrenzten Zellkern. Die Erbinformation schwimmt im Zellplasma. Viele Arten bewegen sich mit Hilfe von Geißeln, ähnlich wie mit Propellern.
Meist vermehren sich Bakterien ungeschlechtlich durch Zellteilung. Weil sie sich unter günstigen Lebensbedingungen etwa alle 20 min teilen, treten sie in ungeheuren Mengen auf. Bakterien können sehr unterschiedliche Formen haben.

nach 40 Minuten
nach 1 Stunde

nach 1 Stunde und 20 Minuten
Abb. 2: Vermehrung von Bakterien. Sie verdoppeln sich alle 20 Minuten
Diskutiert über die Geschwindigkeit, mit der sich Krankheiten ausbreiten können! Stellt einen Zusammenhang mit der Vermehrung her!
Erklärt den Verlauf von Epidemien mit der Vermehrung!
Epidemie, die: ansteckende Krankheit, die sich in einer Region rasch verbreitet und an der viele Menschen erkranken

kugelförmige Bakterien (Kokken)


stäbchenförmige Bakterien (Bazillen)
kommaförmige Bakterien

begeißelte stäbchenförmige Bakterien
1 μm
schraubig gewundene Bakterien (Spirillen)
Abb. 3: Verschiedenartigkeit von Bakterien
Viele Bakterien können untereinander Erbmaterial austauschen und auch aus der Umgebung aufnehmen. Das hilft ihnen, sich schneller an neue Gegebenheiten anzupassen. Werden Bakterien Stoffen ausgesetzt, die sie schädigen, entwickeln sie mit der Zeit Abwehrmechanismen dagegen. Durch den Genaustausch und Überlebensvorteil der damit ausgestatteten Bakterien verbreiten sich die Abwehrmechanismen immer weiter. Bakterien können bei Nahrungsmangel, Trockenheit, Hitze oder Kälte widerstandsfähige Dauerformen bilden und so lange Zeit ohne Nahrung überleben. Dauerformen können eine Schleimschicht um die Zelle, also eine Kapsel, haben oder Sporen sein.
Wie du schon gehört hast, ist der menschliche Körper ständig Bakterien – aber auch anderen Krankheitserregern – ausgesetzt. Meist tritt keine Krankheit auf, da der Körper mit den Erregern fertig wird. Wenn die Widerstandskraft des Körpers aber z. B. durch Stress oder durch Erschöpfung herabgesetzt ist, steigt die Gefahr, dass eine Krankheit ausbricht.
Nur einige Bakterienarten lösen Krankheiten aus. Der Verlauf und die Symptome können sehr unterschiedlich sein.

Salmonelleninfektionen werden häufig durch den Verzehr von rohen Eiern oder nicht gar gekochtem Geflügel hervorgerufen. Bei älteren Menschen oder kleinen Kindern kann eine Salmonelleninfektion auch tödlich verlaufen. Dabei kommt es zu plötzlichem Durchfall, zu Übelkeit, zu Kopf- und zu Bauchschmerzen.
Salmonellen werden abgetötet, wenn Lebensmittel bei der Zubereitung ausreichend gegart werden. Nach dem Kontakt mit rohen Eiern oder rohem Fleisch ist es wichtig, sich gründlich die Hände zu waschen, da sonst die Salmonellen auf andere Speisen übertragen werden können. Außerdem ist auf eine saubere Küche sowie saubere Küchengeräte zu achten!
Die Mandelentzündung

Bei dieser setzen sich Bakterien wie etwa Streptokokken an den Gaumenmandeln fest. Werden sie dort nicht rechtzeitig abgetötet, vermehren sie sich rasch. Sie geben Gifte, sogenannte Toxine, aus ihrem Stoffwechsel ab. Dadurch kommt es zur Entzündung. Toxine werden mit dem Blut und der Lymphe im Körper verteilt, welcher auf diese Giftstoffe mit Fieber reagiert.
Abb. 5: bakteriell hervorgerufene Mandelentzündung
Es gibt aber noch andere durch Bakterien hervorgerufene Erkrankungen:
TUBERKULOSE: Diese ist eine schwere Infektion der Lunge. Eine Erkrankung an Tuberkulose muss den Gesundheitsbehörden gemeldet werden.
CHOLERA: Diese Infektionskrankheit wird meist durch verunreinigtes Trinkwasser verursacht und führt zu schwerem Durchfall.
TETANUS (Wundstarrkrampf): Meist dringen die Erreger durch Wunden ein und befallen die Nervenzellen, welche die Muskulatur steuern. Die Krankheit verläuft häufig tödlich. Daher ist es wichtig gegen Tetanus geimpft zu sein.
SYPHILIS: Bei dieser sexuell übertragbaren Krankheit wird, sofern sie nicht rechtzeitig behandelt wird, das zentrale Nervensystem zerstört.


Wie wirken Antibiotika? Sind Bakterien in den Körper eingedrungen, können sie mit Antibiotika bekämpft werden. Sie hemmen das Wachstum von Bakterien. Ein bekanntes Antibiotikum ist das Penicillin. Antibiotika haben als Nebenwirkung, dass sie auch die für ein gesundes Mikrobiom wichtigen Bakterien im Darm töten. Da es immer mehr Bakterien gibt, die gegen Antibiotika resistent sind, soll der Einsatz von Antibiotika immer von einer Ärztin oder einem Arzt entschieden werden. ACHTUNG: Antibiotika müssen genau nach Anweisung eingenommen werden! Sie dürfen auch nicht früher abgesetzt werden.
resistent: widerstandsfähig
†
Begründe, warum man Antibiotika nicht zu früh absetzen darf!
gar gekocht: so lange gekocht, bis das Fleisch nirgends mehr roh ist

Abb. 6: Salmonellen
Entzündung, die: gerötete und angeschwollene Stelle am Körper sexuell übertragbar: kann beim Geschlechtsverkehr weitergegeben werden
Informiere dich über die hier erwähnten Krankheiten!
Recherchiere dazu im Internet und schreibe kurze Steckbriefe!
Zähle die Kennzeichen des Lebens auf!
Erkläre, welche auf Viren zutreffen und welche nicht!
† Viren sind keine echten Lebewesen. Vielmehr sind sie stark rückgebildete Parasiten Sie können nicht wachsen, sich nicht bewegen, sich auch nicht selbst vermehren und haben keinen eigenen Stoffwechsel. Viren nutzen lebende Zellen als Wirtszellen. Sie schleusen ihre Erbsubstanz, die von einer Eiweißhülle umgeben ist, in die Wirtszelle ein und bringen diese dazu, neue Viren zu produzieren.

Der Kampf gegen Viren Viren sind nur sehr schwer zu bekämpfen, da dabei auch die Wirtszelle zerstört werden kann. Dies kann zu einer Schädigung der Patientin oder des Patienten führen. Da Viren keinen Stoffwechsel haben, helfen auch Antibiotika nicht. Viren verändern sehr rasch ihre Oberflächenstruktur, weshalb Impfstoffe immer wieder dieser veränderten Struktur angepasst werden müssen. Medikamente lindern zumeist nur die Symptome der Erkrankung, bekämpfen aber nicht die Ursache –das Virus – selbst.

Abb. 1: „Red Ribbon“ (Rotes Band) als Symbol für die Solidarität mit HIVInfizierten und AIDS-Kranken

Solidarität, die: Verbundenheit bzw. Zusammenhalt zwischen Gleichgesinnten oder Gleichgestellten
Diskutiert, wie eine Virusinfektion geheilt wird, wenn die Medikamente die Viren selbst nicht bekämpfen!
Zu den viral bedingten Erkrankungen zählen z. B. Grippe, Masern, Mumps, Röteln, Fieberblase und Gürtelrose. Auch AIDS und Corona (COVID-19) sind virale Erkrankungen.
Grippeviren gehören zwar zu den harmloseren Erregern, trotzdem sterben weltweit ca. 6 % der infizierten Personen. Vor allem ältere Menschen sowie Babys und Kleinkinder, deren Immunsystem nicht mehr oder noch nicht stark genug ist, können zu den Todesopfern zählen.
AIDS – eine spezielle Viruserkrankung
AIDS ist eine erworbene Immunschwächekrankheit und wird durch das HI-Virus hervorgerufen. AIDS steht für Acquired immune deficiency syndrome.
Das Virus wird durch Körperflüssigkeiten wie Blut oder Samenflüssigkeit, die in den Körper gelangen, übertragen. Es befällt dann spezielle Zellen des Immunsystems oder des Nervengewebes. Dabei schleust es seine Erbsubstanz in die Zelle ein, während die Eiweißhülle außerhalb der Zelle verbleibt.
Die Reaktion auf eine Erstansteckung verläuft vorerst relativ harmlos. Die ersten Symptome, die etwa 4 bis 6 Wochen nach der Infektion auftreten, sind ähnlich wie bei einer Grippe. Infizierte klagen über Übelkeit oder erhöhte Körpertemperatur.
Von nun an kann ein infizierter Mensch andere Personen anstecken. Ist jemand mit dem HI-Virus infiziert, spricht man von „HIV-positiv“. Die HI-Viren sind in Körperflüssigkeiten wie Sperma, Blut oder auch Scheidenflüssigkeit nachweisbar. Die Konzentration ist so hoch, dass ein hohes Ansteckungsrisiko gegeben ist.

Wobei kann man sich NICHT infizieren?
2 beim Händeschütteln oder Umarmen
2 Küsse auf die Wange
2 gemeinsames Benutzen von Essbesteck, Schreibzeug oder Kleidung, WC, Bad
2 Arztbesuche
2 Mückenstiche





Wie kann man sich mit HI-Viren infizieren?
2 Sexualkontakt ohne Kondom
2 Verwenden gebrauchtenvon Injektionsnadeln
2 Kontakt mit Blut
2 verseuchte
Blutkonserven Bluttransfusionenbei
Das Virus kann bis zu 15 Jahre ruhen, bevor die Krankheit AIDS ausbricht. Bei AIDS ist das Immunsystem so sehr geschwächt, dass es Krankheitserreger nicht mehr bekämpfen kann. Es kann zu Lungenentzündung, Durchfall, Gewichtsverlust, Herpesinfektionen, Pilzbefall, Krebserkrankungen und zu Erkrankungen des Nervensystems kommen. Bei sehr geschwächten AIDS-Patienten führen diese Erkrankungen zum Tod.
Die COVID-19-Pandemie

Viren sind im Allgemeinen an ihren Wirt angepasst. Daher können Viren, die in Tieren vorkommen, beim Menschen meist keine Erkrankung hervorrufen. Verändert sich das Erbmaterial der Viren, können diese jedoch auch für den Menschen gefährlich werden.
WICHTIG:
Wenn du Erste Hilfe leistest, verwende Einmalhandschuhe und ein Beatmungstuch!
Abb. 2: Kondome schützen vor einer Ansteckung mit dem HV-Virus.
Ende 2019 dürfte so eine Veränderung in China geschehen sein. Man vermutet, dass ein Virus von Fledermäusen auf Schuppentiere, oder Marderhunde übergesprungen ist. Die Schuppen des Schuppentiers werden in der traditionellen chinesischen Medizin verwendet und sein Fleisch gilt als Delikatesse. Marderhundfelle werden zu Kleidung verarbeitet. Das Virus hat sich in seinem neuen Wirt erneut verändert und ist vermutlich auf einem Tiermarkt in der chinesischen Stadt Wuhan schließlich auf Menschen übergegangen.


Das Virus befällt vor allem die Lunge und die Atemwege. Die neue Krankheit COVID-19 – kurz Corona genannt – trat innerhalb weniger Wochen in der ganzen Welt auf. Vom ersten Auftreten der Krankheit bis Ende 2022 starben etwa 6 Mio. Menschen daran.
Abb. 4: Detailgetreue Nachbildung des COVID-19 Virus. Die abstehenden Moleküle ermöglichen es dem Virus an Wirtszellen anzudocken.
Zuerst wurde versucht, durch Lockdowns die Ausbreitung der Krankheit zu verhindern. Doch erst, als wirksame Impfstoffe dagegen entwickelt worden waren, konnten die Menschen nach und nach ihr normales Leben wiederaufnehmen.
Die meisten Viren sind nicht tödlich. Würde jedes Virus seinen Wirt töten, würde es sich selbst die Grundlage für seine Verbreitung zerstören. Daher passen Viren sich mit der Zeit an ihre Wirte an. Sie infizieren möglichst viele Menschen, die aber dadurch kaum behindert werden.


Wofür steht COVID-19? COVID ist die Abkürzung für Corona Virus Disease (engl. für Krankheit). Das Virus, das die Krankheit auslöst, gehört zur Gruppe der Corona-Viren. Die Zahl 19 steht für das Jahr 2019, in dem die Krankheit das erste Mal aufgetreten ist.
Pandemie, die: weltweites Auftreten einer Infektionskrankheit
Lockdown, der: engl.: Abriegelung; Menschen dürfen nur in dringenden Fällen ihre Wohnung verlassen und viele Unternehmen und Geschäfte werden gesperrt.
Stelle dar, ob du für oder gegen eine Impfung gegen Krankheiten bist! Begründe auch deine Meinung!

Springen Viren von Tieren auf Menschen über, ist diese Anpassung jedoch noch nicht erfolgt. Ein Beispiel dafür ist das Ebola-Virus, das in Westafrika immer wieder auftritt. Es dürfte ebenfalls ursprünglich von Fledermäusen verbreitet worden sein. Durch Kontakt mit infizierten Wildtieren kann das Virus auf den Menschen übertragen werden. Erkranken jedoch Menschen an diesem Virus, so sterben neun von zehn Infizierten. Durch Körperflüssigkeiten kann es auf andere Menschen übertragen werden.
Abb. 5: Ebola-Virus unter dem Elektronenmikroskop
† 0,1 μm
Stelle eine Vermutung auf, was geschieht, wenn sich ein Virus an seinen Wirt anpasst! Denke dabei an das, was du in der 1. Klasse über die Evolution gelernt hast!


Die Schlafkrankheit
Bei dieser Krankheit, die in Afrika vorkommt, fallen die Betroffenen vor ihrem Tod in einen Dämmerzustand. Sie wird von Einzellern hervorgerufen, die durch die Tsetsefliege übertragen werden.
Milieu, das: hier – ein bestimmtes Umfeld
Überlegt zu zweit, wie man sich vor Pilzinfektionen schützen kann! Entwerft dazu ein Plakat mit dem Titel „Schutz vor Pilzinfektionen“!
Beurteilt die Wirksamkeit einzelner Maßnahmen!
Neben Bakterien und Viren gibt es auch noch andere Ursachen für Infektionskrankheiten.
Manche Amöbenarten gelangen durch verunreinigtes Trinkwasser oder Nahrung in das Verdauungssystem. Sie verursachen schwere Durchfälle. Ein Beispiel für so eine Erkrankung ist die Amöbenruhr. Sie tritt sehr häufig in tropischen Gebieten auf. Deshalb sollte man bei einer Reise in solche Länder nur Mineralwasser aus Flaschen oder abgekochtes Wasser trinken.
Auch die Malaria wird durch tierische Einzeller hervorgerufen. An dieser Krankheit, bei der hohes Fieber auftritt, sterben jährlich weltweit etwa 500 000 Menschen. Auch sie tritt vor allem in tropischen Gegenden auf. Sie wird von Stechmücken übertragen.
Pilze

Abb. 1: Die Anopheles-Mücke kann mit ihrem Stich Malaria übertragen.



Wie ernähren sich
Pilze auf Haut und Nägeln von Menschen?
Pilze ernähren sich von einem Eiweiß, nämlich dem Keratin. Dieses wird von der Hornschicht der Oberhaut bzw. von Nägeln gebildet. Von der Oberhaut wachsen die Pilzfäden in die Unterhaut hinein.
Typische Pilzerkrankungen sind Hautpilz, Nagelpilz oder Pilzinfektionen der Scheide. Eine Infektion mit einem Pilz ist in öffentlichen Bädern, Dusch- oder Waschräumen oder auch in der Sauna möglich, denn Pilze können sich besonders gut im feuchtwarmen Milieu vermehren. Die Sporen bleiben auf Hautschüppchen oder auch Kleidungsstücken haften.


Prionen sind Eiweiße, die bei anderen Eiweißen Veränderungen hervorrufen können. So verändern sie bei der Seuche BSE, die bei Rindern auftritt, Eiweißstoffe im Gehirn. Mit der Zeit nimmt es eine schwammartige Struktur an. Die Tiere können ihre Bewegungen nicht mehr steuern und stolpern über ihre eigenen Beine. Deshalb wird diese Seuche auch „Rinderwahn“ genannt.
Essen Menschen BSE-verseuchtes Rindfleisch, so kann bei Ihnen die Creutzfeldt-JacobErkrankung auftreten. Auch beim Menschen verändert sich das Gehirn und es kommt zu Störungen der Bewegungen, der Sinnesorgane und des Gedächtnisses. Diese Krankheit verläuft tödlich.
Erkrankungen mit Prionen haben eine sehr lange Inkubationszeit. So vergehen bei BSE vier bis fünf Jahr von der Infektion bis zum Ausbruch der Krankheit.
Großes Rätsel der Infektionskrankheiten – Löse das Kreuzworträtsel!

senkrecht:
1. Medikamente, die gegen bakterielle Erkrankungen helfen
2. Krankheitserreger, die durch den Verzehr von rohen Eiern in den Körper gelangen können
3. keine echten Lebewesen, können aber Erkrankungen hervorrufen
4. Viren brauchen sie, um sich zu vermehren.
6. Pilzsporen bleiben an ihnen haften.
7. bakterielle Lungenkrankheit
10. Ältere Menschen und Babys können an diesem viralen Infekt sterben.

waagrecht:
5. Körperflüssigkeit, in der das HI-Virus nachweisbar ist
8. mögliche Verursacher für BSE
9. Tiere, die manche Tropenkrankheiten übertragen
11. Stoffe, die eine übersteigerte Abwehrreaktion des Immunsystems hervorrufen können
12. tierische Einzeller, die z. B. Malaria verursachen
13. Milieu, das von Pilzen bevorzugt wird

Was ist was? – Handelt es sich hier um eine bakterielle Krankheit, eine virale Krankheit, oder eine, die von Einzellern hervorgerufen wird? Male die Kästchen in der richtigen Farbe an!






























Hier erfährst du, wie du dich vor Infektionen schützen kannst. Lies diese Informationen zuerst genau durch!

Aktive Immunisierung („Schutzimpfung“):
Der Körper wird vorbeugend mit Krankheitserregern geimpft. Eine Infektion wird nachgeahmt. Das Immunsystem reagiert aktiv aufgrund der Infektion mit körpereigenen Abwehrstoffen (Antikörpern) und bildet Gedächtniszellen, die bei erneutem Kontakt mit dem Erreger Antikörper nachbilden können.
• muss in bestimmten Zeitabständen wiederholt werden
• völlige Immunisierung tritt erst nach allen Teilimpfungen bzw. Auffrischungsimpfungen ein
• Beispiele: FSME, Masern, Mumps, Röteln

Impfpass:
Alle Impfungen sollte man immer in diesen eintragen lassen. Bei Verlust des Impfpasses kann eine Titerbestimmung durchgeführt werden. Sie zeigt, ob die Konzentration bestimmter Antikörper im Blut ausreichend hoch ist. Ist der TiterWert zu niedrig, sollte eine erneute Impfung erfolgen.

Passive Immunisierung:
Dem Körper wird ein Konzentrat dieser Antikörper geimpft. Dieses wurde von Menschen oder Tieren gewonnen, welche mit bestimmten Erregern infiziert wurden und bereits Antikörper gebildet hatten. Es kann sich um Antikörper gegen Bakterien, Viren oder tierische Gifte handeln. Das Immunsystem bleibt unbeteiligt, also passiv.
• bewirkt einen sofortigen Schutz
• hält maximal 3 Monate an, da Antikörper abgebaut werden
• wird angewendet, wenn der Körper bereits infiziert wurde oder Infektionsgefahr droht (z. B. Reisen in exotische Länder)
• Beispiele: Tollwut, Malaria, Schlangenbiss


Impfplan:
Er gibt in tabellarischer Form an, welche Impfungen zu welchem Zeitpunkt durchgeführt werden sollen. Du kannst dir diesen z. B. im Internet unter http://www.apotheker.or.at ansehen. Er ist auch bei Ärzten/Ärztinnen erhältlich. A B
Interpretiere die Texte in Übung 3 und entscheide selbst, ob es sich bei diesen Abbildungen um eine aktive oder passive Immunisierung handelt und kreuze an!


aktive Immunisierung
passive Immunisierung
aktive Immunisierung
passive Immunisierung
Unter Hygiene versteht man alle Maßnahmen, die Infektionskrankheiten verhindern sollen. Somit ist Hygiene auch wichtig, wenn man gesund bleiben will.
Hygiene beginnt bei dir selbst. Du kommst ständig mit Krankheitserregern in Berührung, das kannst du gar nicht verhindern. An vorderster Stelle steht dabei die Körperpflege:
Wasche dir regelmäßig die Hände! Das ist besonders wichtig, wenn du mit Keimen in Berührung gekommen bist (WC-Besuch, Arbeiten mit Tieren, usw.).
Verwende beim Waschen eine Seife und warmes Wasser! Wenn du Essen zubereitest, solltest du dir zwischen den einzelnen Tätigkeiten die Hände waschen, um zu verhindern, dass Keime von einer Speise zur anderen gelangen.
Achte auf die Mundpflege! Putze dir zweimal täglich die Zähne! Bakterien im Mund können deine Zähne angreifen.
Dusche regelmäßig und wasche deine Haare! Dabei bekämpfst du Krankheitserreger, die sich auf deiner Haut befinden.
Wechsle regelmäßig deine Wäsche, vor allem die Unterwäsche!
Achte beim Essen auf Sauberkeit! Verwende nur sauberes Geschirr und wasche rohe Speisen wie Obst oder Gemüse, bevor du sie verzehrst!
Hygiene im Gesundheitswesen
Besonders wichtig ist Hygiene dort, wo häufig Krankheitserreger auftreten. In Krankenhäusern sowie bei der Ärztin oder beim Arzt sind Maßnahmen gegen krankmachende Keime besonders wichtig.


Abb. 1: Händewaschen mit Seife
Überlege, was du täglich für deine persönliche Hygiene tust! Anschließend finde drei Maßnahmen, wie du dich dabei verbessern könntest!
Das Personal im Gesundheitswesen trägt meist einen Mund-Nasen-Schutz und schützt sich selbst sowie die Patientinnen und Patienten durch Schutzhandschuhe. Bei Operationen wird auch Schutzkleidung getragen, um die Übertragung von Krankheitserregern zu vermeiden. Geräte, Material und Medikamente müssen steril sein.
Abb. 2: Hygienemaßnahmen bei einer Operation
Hygiene in der Lebensmittelproduktion
Auch in Fabriken, in denen Lebensmittel hergestellt werden, müssen besondere Vorschriften eingehalten werden. Die Maschinen müssen regelmäßig gereinigt und desinfiziert werden. Außerdem gibt es regelmäßige Kontrollen. So wird sichergestellt, dass die Lebensmittel, die du kaufst, keine Krankheitserreger enthalten.
Abb. 3: Hygiene in einer Großbäckerei


Geschichte der Hygiene Früher wusste man nicht, warum Menschen erkrankten. Erst im Jahr 1840 fand der Wiener Arzt Ignaz Semmelweis heraus, dass im Krankenhaus die Übertragung von Krankheiten durch Hygienemaßnahmen verhindert werden kann. Nach und nach erkannte man, wie wichtig Sauberkeit und Händewaschen ist.
Vergleiche Abb. 2 mit dem, was du über Hygienemaßnahmen weißt! Was wird dargestellt?

steril: ohne Keime desinfizieren: Etwas so behandeln, dass es keine Keime mehr enthält.

Abb. 4: Desinfektion der Hände
Handdesinfektionsmittel, das: Flüssigkeit, die Viren und Bakterien abtötet
Während den Jahren der Corona Pandemie blieb die jährliche Grippewelle aus. Finde eine Erklärung dafür!
trainieren: durch ständiges Üben eine besondere Fähigkeit erlangen
Allergie, die: Überempfindlichkeit gegen gewisse Stoffe
Diskutiert mögliche Gründe, weshalb Kinder, die am Land mit Tieren und viel Naturkontakt aufwachsen, seltener unter Allergien leiden! Erstellt Tipps für Kinder, die in der Stadt leben!

Zwischen Oktober und Mai kommt es regelmäßig zu einer verstärkten Ausbreitung von Grippeviren (Grippewellen). In diesen Zeiten ist die Gefahr besonders groß, sich mit Grippe anzustecken. Um das zu vermeiden, solltest du folgende Maßnahmen ergreifen:
Meide größere Menschenansammlungen in geschlossenen Räumen!
Trage einen Mund-Nasen-Schutz!
Hygiene im Ausland

Wenn du in ein fernes Land reist, solltest du dich erkundigen, wie dort die hygienischen Bedingungen sind. Häufig braucht man bestimmte Impfungen, um sich vor Krankheiten zu schützen, die dort vorkommen. Du solltest dich auch erkundigen, wie es dort mit der Nahrung und mit Trinkwasser aussieht.
Wasche regelmäßig deine Hände! Benutze auch Handdesinfektionsmittel, wenn du ein Restaurant oder einen Laden betrittst!
Auch bei der COVID-19-Pandemie wurden solche Maßnahmen empfohlen, oft sogar gesetzlich vorgeschrieben. So sollte die Ausbreitung dieser Infektionskrankheit verhindert werden.
Jeder Mensch hat ein Immunsystem. Es bekämpft Krankheitserreger, die in unseren Körper eindringen. Das Immunsystem muss jedoch trainiert werden, damit es gut arbeitet. Es muss dabei immer wieder mit Bakterien und Viren in Kontakt kommen, damit es sie kennen und abwehren lernt und uns schützen kann. Wird das durch Hygienemaßnahmen verhindert, kann der Köper keine Abwehrkräfte aufbauen. Tritt dann dennoch eine Infektionskrankheit auf, kann der Körper nicht richtig reagieren und der Krankheitsverlauf ist umso schwerer.
Wissenschafterinnen und Wissenschafter vermuten, dass übertriebene Hygiene auch zu Allergien führen kann. Sie sind der Ansicht, dass eine Allergie auf ein Immunsystem zurückzuführen ist, das nicht ausreichend oder falsch trainiert ist.
Es gibt Würmer, die Trichinen, deren Eier oder Larven mit der Nahrung aufgenommen werden, und die sich im Darm vermehren können. Sie kommen vor allem in Schweinefleisch vor. Wird das Fleisch vor dem Essen nicht ausreichend gegart, überleben die Larven. Im Darm des Menschen entwickeln sie sich zu erwachsenen Würmern, die sich paaren und vermehren. Anschließend bohren sie sich durch die Darmwand und nisten sich im Muskelgewebe ein. Um die Ausbreitung von Trichinen zu vermeiden, müssen Schweine nach dem Schlachten genau untersucht werden.
Auch Bandwürmer leben im Darm ihrer Wirte. Dort ernähren sie sich vom Darminhalt. Ihre Eier werden mit dem Kot ausgeschieden und können von anderen Wirten mit der Nahrung wieder aufgenommen werden. Manche Bandwurmarten können auch den Menschen befallen.
Durch Hygienemaßnahmen bei der Herstellung und bei der Verarbeitung von Lebensmitteln ist die Gefahr, von solchen Parasiten befallen zu werden, bei uns aber sehr gering.
Abb. 5: Kopf eines Bandwurms

Hefepilze spielen bei der Herstellung mancher Lebensmittel eine wichtige Rolle. Sie erzeugen durch die Gärung Alkohol und Kohlenstoffdioxid (CO2), welches den Teig auflockert. Manche Pilzarten sind auch für die Käseherstellung wichtig. Andere Pilze wiederum erzeugen Giftstoffe, die als Antibiotika in der Medizin zur Anwendung kommen. Auch wichtige medizinische Wirkstoffe wie beispielsweise das Insulin werden mit Hilfe von Pilzen hergestellt.


Wein, Bier und Käse werden seit vielen Jahrtausenden mit Hilfe von Mikroorganismen hergestellt. Heute sind Wissenschafterinnen und Wissenschafter jedoch in der Lage, Mikroorganismen zur Produktion vieler anderer Stoffe einzusetzen. Alle diese Verfahren zusammen nennt man „Biotechnologie“, da Methoden aus der Biologie für technische Anwendungen genutzt werden.
Biotechnologie in der Medizin …
Heute ist man in der Lage, Mikroorganismen so zu verändern, dass Arzneimittel oder Impfstoffe hergestellt werden können. Sie werden auch dazu eingesetzt, um als „Gentests“ Krankheiten zu erkennen.
… und in der Industrie
Durch den Einsatz von Mikroorganismen können zahlreiche chemische Stoffe einfacher und billiger hergestellt werden. Milchsäure und Essigsäure, die durch Mikroorganismen produziert werden, sind wichtige Grundstoffe für die Industrie. Verschiedene Alkohole werden als Grundstoff für viele Chemikalien benötigt. Sie werden auch Treibstoffen beigemischt und reduzieren so den Verbrauch von Erdöl.
Auch Wasserstoff und Biogas können aus organischen Materialien gewonnen werden. Diese Gase werden in der Zukunft immer mehr fossile Energieträger ersetzen.
Mikroorganismen
Bakterien, Pilze und andere Mikroorganismen sind Destruenten. In einem natürlichen Ökosystem bauen sie organische Stoffe ab. In Kläranlagen wird genau diese Fähigkeit genutzt, um Abwässer zu reinigen.
In Klärbecken wird das Abwasser umgerührt und Luft eingeblasen. So haben die Organismen die besten Bedingungen, um sich rasch zu vermehren und dabei die organischen Abfälle zu zersetzen. Auch Böden, die durch Erdöl, Benzin oder Diesel verunreinigt sind, können durch Bakterien wieder gesäubert werden.

Aktuelle Forschung beschäftigt sich intensiv mit kunststoffzersetzenden Mikroorganismen. Noch steht nicht fest, ob sie von Erfolg gekrönt sein wird.
Abb. 2: Der Teig von Germknödeln wird durch Hefepilze so locker.
Insulin, das: senkt den Blutzuckerspiegel; muss bei Diabetes („Zuckerkrankheit“) als Medikament verabreicht werden
Energieträger, der: Stoff, der Energie enthält, die man nutzen kann

Abb. 3: In einem Komposthaufen wandeln Mikroorganismen Gartenabfälle in Erde um.
Abb. 3: Erkundige dich, was alles auf den Komposthaufen kommt! Erstelle eine Liste! Zähle darin Abfälle auf, die du auf den Komposthaufen geben kannst und solche, die dafür nicht geeignet sind!
Begründe, warum manche Abfälle kompostiert werden können und andere nicht! Was passiert mit nicht kompostierbaren Abfällen? Welche Probleme ergeben sich daraus?

Abb. 1: gefaulter Apfel
Abb. 2: Begründe, warum gewisse Lebensmittel im Kühlschrank aufbewahrt werden! Welche Lebensmittel werden nicht im Kühlschrank gelagert? Warum?
konservieren: haltbar machen

Das Räuchern
Beim Räuchern werden Fisch, Fleisch oder Wurst nach dem Pökeln noch über eine längere Zeit im Rauch eines Holzfeuers gelagert. Der Rauch tötet Mikroorganismen ab und konserviert so die Fleischwaren zusätzlich.

Hast du dich schon einmal gefragt, woran es liegt, dass Lebensmittel mit der Zeit schlecht werden? Der Apfel z. B. beginnt zu verfaulen, wenn Mikroorganismen das Fruchtfleisch zersetzen.
Auch wenn andere Lebensmittel verderben, sind meist Mikroorganismen schuld daran. Um Nahrungsmittel zu konservieren, muss man also verhindern, dass Mikroorganismen auf die Lebensmittel gelangen und sich dort vermehren.

Abb. 4: Räuchern von Fleisch und Wurst
Recherchiere im Internet über „Soleier“!
Erkläre, wie auf diese Weise Eier über lange Zeit konserviert werden!
Um das zu erreichen, gibt es viele Methoden. Manche davon kannst du auch bei dir zu Hause anwenden.
Wie alle Lebewesen brauchen Mikroorganismen die richtige „Betriebstemperatur“. Wird es kälter, vermehren sie sich langsamer. Daher halten sich Lebensmittel im Kühlschrank länger frisch. Werden sie eingefroren, kommt die Vermehrung ganz zum Stillstand. Erst nach dem Auftauen, nehmen die Mikroorganismen ihre Tätigkeit wieder auf. Deshalb halten Lebensmittel im Tiefkühlschrank viel länger als im Kühlschrank.
Neben der richtigen Temperatur brauchen Mikroorganismen auch Wasser. Wird dieses den Lebensmitteln entzogen, so können sich diese Lebewesen nicht mehr vermehren. Obst, Gemüse, Kräuter, Getreide, Pilze, aber auch Fleisch und Fisch können so haltbar gemacht werden.

Abb. 2: Konservieren bei tiefen Temperaturen

Abb. 3: Getrocknetes Obst bleibt lange genießbar.
Vor allem Fleisch wird durch Salzen und Pökeln haltbar gemacht. Speisesalz entzieht dem Fleisch Wasser und trocknet es aus. Diesen Effekt kannst du beobachten, wenn du Salz über frisch geschnittenes Gemüse streust. Salz entzieht auch Mikroorganismen Wasser, wodurch ihre Lebensfunktionen gehemmt werden. Speisesalz verzögert so das Wachstum von Mikroorganismen. Beim „Pökeln“ wird zusätzlich anderes Salz verwendet, das diese Organismen auch abtötet. Dadurch wird Fleisch länger haltbar.
Abb. 5: Schinken wird durch Pökeln konserviert.


Abb. 6: in Essig eingelegtes Gemüse
Vielleicht hast du schon einmal Mixed Pickles oder Essiggurken gegessen. Dabei handelt es sich um Gemüse, das in Essig eingelegt worden ist. Essig enthält eine Säure, die Mikroorganismen abtötet und so das Gemüse konserviert.
Die meisten Mikroorganismen benötigen den Sauerstoff in der Luft zum Leben und zum Vermehren. Lebensmittel können haltbar gemacht werden, indem man sie vakuumverpackt. Dazu werden sie in Kunststofffolie verpackt, aus der die Luft abgesaugt wird. Die Folie wird anschließend verschweißt, sodass keine neue Luft eindringen kann.
Beim Abpumpen der Luft werden jedoch auch Flüssigkeiten aus den Lebensmitteln gesaugt. Dadurch können sich diese verändern. Daher werden Fleisch oder Fisch häufig unter Schutzgas verpackt. Dabei handelt es sich meist um Stickstoff. Dieses Gas ist Bestandteil der Luft und ist ungiftig. In Schutzgas können sich Mikroorganismen jedoch nicht vermehren, da ihnen der Sauerstoff fehlt.


Um Lebensmittel unter Luftabschluss zu halten, können sie auch in Speiseöl eingelegt werden.
Eine weit verbreitete Methode, Lebensmittel haltbar zu machen, ist das Einkochen. Durch das Erhitzen der Lebensmittel, werden die Mikroorganismen abgetötet. Das zu konservierende Gut wird in heißem Zustand in Gläser oder Dosen gefüllt und luftdicht verschlossen. So können keine neuen Keime hineingelangen. Beim Abkühlen entsteht im Gefäß ein Unterdruck. Beim Öffnen hörst du dann ein typisches „Plopp“.
Vakuum, das: luftleerer Raum
verschweißen: fest miteinander verbinden
Finde mindestens drei Lebensmittel, die nicht durch Sauerstoffentzug konserviert werden können! Stelle eine Vermutung auf, warum das nicht geht und gib andere Methoden zum Haltbarmachen an!

Welche Methode der Konservierung gewählt wird, hängt immer davon ab, um welches Lebensmittel es sich handelt.

Abb. 8: Ölsardinen –durch Speiseöl haltbar gemacht
Suche in einem Supermarkt zu jeder hier beschriebenen Konservierungsmethode mindestens fünf Lebensmittel! Vergleiche deine Ergebnisse mit deiner Sitznachbarin, mit deinem Sitznachbarn!


Auch Zucker konserviert.
Beim Kandieren wird Obst mit einer Zuckerlösung übergossen. Dadurch wird dem Obst Wasser entzogen. Früchte können so lange Zeit gelagert werden.
Beschreibe fünf Maßnahmen, mit denen du für deine persönliche Hygiene sorgen kannst!
Viele Fremdworte – Ergänze die Fachbegriffe zu diesen Erklärungen!
keimfrei luftleerer Raum haltbar machen
Überempfindlichkeit gegen gewisse Stoffe
fest miteinander verbinden
Medikament, das bei Diabetes verabreicht wird
Etwas so behandeln, dass es keine Keime aufweist
Richtig konservieren – Kreuze an, wie diese Lebensmittel haltbar gemacht werden können!
ACHTUNG: Es gibt immer mehrere Möglichkeiten.





SauerstoffKühlen Trocknen Pökeln entzug Einkochen





































Untersuche die Wirkung von Konservierungsmethoden! Du brauchst: drei Stück vom selben Obst, oder zuckerhaltigen Gemüse (z.B. rote Paprika), 3 Schraubgläser.
Gib etwas Wasser in einen Topf und erhitze eines der drei Stücke! Eines der drei Stücke bestreue mit reichlich Salz! Eines der Stücke lasse unbehandelt.
Tauche 3 Schraubgläser und deren Deckel für etwa 10 Minuten in kochendes Wasser! Nun lege je eines der Stücke in eines der Gläser und verschließe sie! Beobachte die Stücke über mehrere Tage! Dokumentiere deine Beobachtungen genau, am besten tageweise! Formuliere Erklärungen für deine Beobachtungen! Beantworte auch folgende Fragen:
2 Wovon werden deine Ergebnisse abhängen?

2 Weshalb ist es wichtig, drei Stück vom selben Obst bzw. Gemüse zu verwenden?
2 Weshalb hast du die Gläser in kochendes Wasser getaucht?




Formuliere eine passende Forschungsfrage zu deinem Versuch und eine Vermutung zur Erklärung deiner Ergebnisse! Denke an alles, was du über Konservieren gelernt hast.
Finde Möglichkeiten, die Versuchsbedingungen zu verändern und das Ergebnis gezielt zu beeinflussen und probiere sie aus! Schreibe ein Protokoll und vergleiche es in der Klasse!
Besprecht eure Ergebnisse! Experimentiere auch mit anderen Konservierungsmethoden!
Extrafrage: Wie nennt man den wissenschaftlichen Vorgang, wenn du Versuche zu einer klar formulierten Forschungsfrage unter kontrolliert veränderten Bedingungen wiederholt durchführst?
Tanja und Mehmet grübeln über ein paar Dinge. Hilf ihnen, zu entscheiden, welche ihrer Aussagen zutreffen und welche nicht! Formuliere Begründungen. Lässt sich immer eindeutig sagen wer recht hat? Diskutiert in kleinen Teams!

Mehmet erzählt: „Wenn ein Lebensmittel schimmlig ist, dann schneidet mein Onkel einfach das Stück, auf dem man den Schimmel sieht, weg. Der Rest ist noch gut.“ sagt er. Tanja erwidert: „Hmmm meine Mama sagt, da muss man alles wegschmeißen, sonst ist das ungesund.“
Tanja berichtet: „Also meine Oma hat immer geschimpft, wenn ich als kleines Kind beim Spielen voller Erde und Schmutz war. Sie sagt, das ist Dreck und da sind total viele Keime drinnen, was ungesund ist.“ Mehmet lacht: „Ha, also mein Opa hat immer gemeint, ein Kind, das nach dem Spielen nicht schmutzig ist, hat keinen Spaß gehabt! Und er hat gesagt, er war als Kind immer ziemlich schmutzig nach dem Spielen und deswegen wird er bis heute selten krank.“
„Hast du das mitbekommen?“, fährt er fort „Die Frau Professor Zotlöterer hat den Geo Lehrer von der 2B letztens am Gang zusammengestaucht, weil er ohne Handvorhalten gehustet hat, als sie vorbeigegangen ist.“ „Na die ist aber auch echt komisch geworden seit Corona.“, antwortet Tanja. „Die hat immer ihr Desinfektionsmittel mit und gibt das dauernd auf die Hände und überall drauf, wo sie gerade ist.“ „Das stimmt.“, überlegt Mehmet. „Weißt du, was ihr der Geo Lehrer gesagt hat? Wenn sie ein paar Mikroben überlassen würde, würden die sie auch vor dem bisserl Husten schützen.“ Da hat sie bös geschaut.

Wenn du mit Mikroorganismen arbeitest, musst du einige Regeln beachten:
Regel 1: Arbeite sauber! Achte darauf, dass keine Verunreinigungen in dein Experiment gelangen! Desinfiziere deine Arbeitsgeräte vor und nach dem Experiment gründlich!
Regel 2: Schütze dich selbst! Trage Schutzhandschuhe und – falls erforderlich – Mundschutz und eine Schutzbrille!
Regel 3: Entsorge fachgerecht! Nach deinem Experiment musst du darauf achten, dass die Mikroorganismen nicht dich oder andere Personen gefährden.

Wir stellen nun zwei Forschungsfragen und führen dazu jeweils ein Experiment durch.
2 Formuliere je eine Vermutung bezüglich der Ergebnisse und überlege eine Begründung dafür!
2 Versuche zu erkennen, wodurch wir die Versuchsbedingungen jeweils ändern, so dass aus einem reinen Versuch ein Experiment wird!
2 Dokumentiere alles ordentlich und schreibe deine Schlussfolgerungen in einem Protokoll auf!

Du brauchst: 2 Petrischalen mit Nährboden für Mikroorganismen wie z.B. Ager % Seife % Warmwasser
FRAGE: Ändert sich durch gründliches Händewaschen das Mikrobiom auf meiner Hand?
VERMUTUNG:
VERSUCH: DURCHFÜHRUNG A. Öffne eine Petrischale und berühre mit der Spitze deines Zeigefingers kurz den Nährboden! Dann verschließe die Petrischale wieder luftdicht!
VERSUCH: DURCHFÜHRUNG B. Wasche deine Hände gründlich mit Seife und warmem Wasser! Berühre nun mit deinem gewaschenen Zeigefinger den Nährboden in der anderen Petrischale! Verschließe auch diese Petrischale! Beschrifte beide Petrischalen und stelle sie nebeneinander an einen warmen Ort!
DOKUMENTATION: Beobachte dann einige Tage lang, was geschieht! Mache täglich mit deinem Handy ein Foto von den beiden Petrischalen!
Protokoll: Stelle die Fotos einander gegenüber! Beschreibe auch, wie sich die beiden Petrischalen entwickeln! Erkläre, was geschieht und gib die Ursache dafür an!
Vergleicht eure Ergebnisse und diskutiert in der Klasse:
Lebt auf jedem Menschen das gleiche Mikrobiom?
Welche Folgen hat es, wenn jemand in seine Hand hustet oder niest und sie dann nicht gleich wäscht?
Gibt es eine Alternative zum „in die Hand husten“?
Händeschütteln ist in Europa eine übliche Form der Begrüßung und stellt persönlichen Bezug her. Was würdet ihr einer Ärztin, einem Arzt raten, der Patienten begrüßen möchte?


Du brauchst: mehrere Petrischalen mit Nährboden für Mikroorganismen wie z.B. Ager % genauso viele sterile Wattestäbchen
FRAGE: Unterscheidet sich das Mikrobiom unterschiedlicher Orte?
VERMUTUNG:

VERSUCHS DURCHFÜHRUNGEN: Nimm mit mehreren Wattestäbchen Proben von verschiedenen Orten!
Streiche dazu mit dem Wattestäbchen z. B. über eine Türschnalle, eine Münze aus deiner Geldbörse, die Innenseite eines Kühlschrankes oder die Fliesen im Badezimmer!
Streiche mit jedem Wattestäbchen direkt nach dem Nehmen der Probe über den Nährboden in einer der Petrischalen! Gehe dabei bei jeder Probe gleich vor, damit die Ergebnisse vergleichbar sind! Streiche also immer gleich lang und in dieselbe Richtung über den Nährboden! Verschließe die Petrischale und beschrifte sie!
Beschrifte die Petrischalen und stelle alle Petrischalen nebeneinander an einen warmen Platz
DOKUMENTATION: Beobachte wie bei Experiment 1 einige Tage lang, was geschieht! Mache täglich mit deinem Handy ein Foto von jeder Petrischale!
Protokoll: Erstelle ein Protokoll, in dem du die Ergebnisse vergleichst und Erklärungen für deine Beobachtungen findest!
Vergleicht eure Ergebnisse und diskutiert in der Klasse:
Was denkt ihr über essen mit den Fingern nach einer Fahrt in den öffentlichen Verkehrsmitteln?
Weshalb solltet ihr Obst und Gemüse aus dem Geschäft vor dem Verzehr waschen?
Wer von euch hat ein Smartphone? Wie oft am Tag berührt ihr den Bildschirm? Wie oft reinigt ihr es? Was folgert ihr daraus?
Lass deinen Forscherdrang raus!

Du kannst auch Proben von deiner Zunge und anderen Stellen an deinem Körper nehmen. Versuche daraus zu schließen, wo besonders viele Mikroorganismen siedeln.
Versuche zu unterscheiden, ob in deinen Petrischalen Bakterien oder Pilze wachsen! Wie könnte der Unterschied aussehen?
Hast du die Möglichkeit, ein Mikroskop zu nutzen? Dann kannst du deine gezüchteten Mikroorganismen ganz genau betrachten und unterscheiden!
Sei kreativ…

Die Welt der ganz kleinen Lebewesen beschäftigt eine große Zahl an Biologinnen und Biologen. Einerseits weil sie wesentlicher Bestandteil von Lebensräumen und für deren Verständnis unerlässlich sind. Andererseits aber auch, weil Mikroorganismen es Forschern erlauben, näher an die Ursprünge des Lebens zu kommen.
Die Mechanismen, die Mikroorganismen entwickelt haben, um Herausforderungen ihrer Umwelt zu bewältigen, inspirieren Forscher verschiedenster Fachrichtungen dazu, sie zu verstehen und oft auch nachahmen zu wollen. Mirkoorganismen sind Bestandteil vieler technischer Prozesse und es werden beständig neue Anwendungen entwickelt. Nicht zuletzt für die Medizin sind Mikroorganismen äußerst wichtig. Als Krankheitserreger aber auch als Lieferanten von Mitteln und Methoden zur Heilung. Biologinnen und Biologen sind in all diesen Bereichen beschäftigt.


Antrieb von Bakterien! Ingenieure ahmen oft die Natur nach, um sich die Resultate von vielen Millionen Jahren Anpassung zunutze zu machen. So auch, wenn sie Antriebe für kleinste Maschinen entwickeln, die sich einmal durch den menschlichen Körper bewegen sollen.
Du brauchst: Einen Mixer mit Knethaken (einer reicht) % eine große Schüssel mit Wasser.
Führe folgenden Versuch durch!

Halte den Knethaken in das Wasser und schalte den Mixer auf niedriger Stufe ein! Beobachte genau was passiert! Verknüpfe deine Beobachtungen damit, was du über die Fortbewegung von Bakterien gelernt hast! Schreibe einen kurzen Text darüber, wie diese funktioniert!
Vermehrung von Mikroorganismen! Viele Mikroorganismen vermehren sich durch Zellteilung. Aus einem Organismus werden zwei, aus jedem davon wieder zwei und so weiter.
Du brauchst: Ein Schachbrett % eine Packung Reis
Führe folgenden Versuch durch!

Lege ein Reiskorn auf das Feld in einer Ecke des Schachbretts. In jedes benachbarte Feld legst du nun doppelt so viele Reiskörner wie in das zuvor. Falls es eng wird, lege sie ruhig auf Stellen neben dem Schachbrett.
Was beobachtest du? Schlussfolgere, ob es wichtig ist, rasch zu reagieren, wenn Mikroorganismen wo hingelangen, wo sie nicht sein sollten!
Denke daran, wo Mikroorganismen in anderen Lebewesen siedeln! Weshalb sind Tierbisse auf jeden Fall von einem Arzt zu untersuchen?






So schätze ich mich nach dem Großkapitel DIE KLEINSTEN LEBEWESEN selbst ein: Kreuze jenen Daumen an, der für dich am ehesten zutreffend ist!
…erklären, was Mikroorganismen sind.
…begründen, warum Mikroorganismen im menschlichen Körper eine große Bedeutung haben.
…wiedergeben, was Infektionskrankheiten sind.
…die Übertragungswege von Infektionskrankheiten analysieren.
…den Verlauf von Infektionskrankheiten nachvollziehen.
…den Aufbau von Bakterien wiedergeben.
…einige durch Bakterien verursachte Infektionskrankheiten benennen.
…erklären, wie Antibiotika bei Bakterieninfektionen wirken.
…analysieren, wie Viren ihrem Wirt schaden.
…einige durch Viren verursachte Infektionskrankheiten beschreiben.
…über Pilze, Prionen und Einzeller als Krankheitserreger sprechen.
…die Bedeutung von Hygiene als wirksame Maßnahme gegen Infektionen erörtern.
…begründen, warum Mikroorganismen in der Medizin und in der Industrie wichtig sind.
…angeben, wie Lebensmittel haltbar gemacht werden können.
…Proben von Mikroorganismen nehmen und sie unter Beachtung notwendiger Sicherheitsvorkehrungen vermehren.
Um deine Kompetenzen noch mehr zu steigern, hier unsere Buchtipps:
Katrin Linke, Nikolai Renger: Die spannende Welt der Viren und Bakterien (Loewe, 2021).



Manfred Baur, Annelie Stenzel: WAS IST WAS Naturwissenschaften easy! Biologie. Die Viren und wir (Tessloff Verlag, 2021).
Susan Schädlich: Winziges Leben: alles über Corona, Viren und Bakterien und wie wir uns schützen können (Carlsen 2020).








Abb. 2: Nervensystem, lila: Zentralnervensystem
Nenne einige der Leistungen deines Gehirns!
motorisch: die Bewegung betreffend
sensorisch: die Sinnesorgane betreffend
Großhirn Zwischenhirn
Unser Körper ist von einem dichten Geflecht von Nervenfasern durchzogen. Ihre Aufgabe besteht darin, Signale von den Sinnesorganen an unser Gehirn und vom Gehirn zur Muskulatur und zu den Organen zu übermitteln.
Dein Nervensystem besteht aus vielen Nervenzellen Nervenzelle besteht aus einem Zellkörper zahlreichen Fortsätzen. Es gibt zwei Arten von Fortsätzen:
Dendriten: Diese kurzen Fortsätze nehmen Informationen von den Sinneszellen oder von anderen Nervenzellen auf und leiten sie zum Zellkörper weiter.
Axone: Das sind lange Fortsätze. Ihre Aufgabe besteht darin, die aufgenommenen Informationen an die nächste Nervenzelle weiterzuleiten. Im Axon einer Nervenzelle werden Informationen als elektrische Impulse weitergeleitet.
An den Verbindungsstellen zwischen zwei Nervenstellen befindet sich ein Spalt. Dort sorgen chemische Verbindungen, sogenannte Botenstoffe, für die Signalübertragung. Die Freisetzung der Botenstoffe wird durch die elektrischen Impulse der Axone gesteuert.
Das Gehirn und das Rückenmark bilden das Zentralnervensystem. Beide sind durch Knochen geschützt. So liegt das Gehirn in der knöchernen Schädelkapsel, das Rückenmark im Wirbelkanal.

Kleinhirn Nachhirn Balken Mittelhirn
Abb. 3: die Teile des Gehirns
Dendriten
Zellkern

Zellkörper
Axon Synapse
Neurotransmitter
Leitung: chemisch elektrisch
Abb. 1: Nervenzelle und Signalweiterleitung
Das Gehirn eines Menschen besteht aus etwa 100 Milliarden Nervenzellen, die untereinander verbunden sind. Gemeinsam ermöglicht diese große Anzahl an Nervenzellen und deren Verknüpfungen die Ausübung aller Fähigkeiten, zu denen dein Gehirn in der Lage ist.
Das Gehirn ist in fünf Abschnitte eingeteilt, die jeweils unterschiedliche Aufgaben erfüllen: Großhirn, Zwischenhirn, Mittelhirn, Kleinhirn und Nachhirn.
GROSSHIRN: Es ist der größte Teil des Gehirns und kann aufgrund seines Aufbaus in die „graue Substanz“ und „weiße Substanz“ unterteilt werden. Die Großhirnrinde wird hauptsächlich aus der „grauen Substanz“ gebildet. Diese besteht vorwiegend aus Zellkörpern. Darunter befindet sich die „weiße Substanz“. Sie setzt sich größtenteils aus Fortsätzen der Nervenzellen zusammen, welche die einzelnen Bereiche des Gehirns miteinander verbinden.
Die in der Großhirnrinde liegenden Nervenzellen werden in größere Abschnitte, die Rindenfelder, zusammengefasst. Man unterscheidet zwischen motorischen und sensorischen Rindenfeldern sowie den Rindenfeldern der Sinnesorgane.
Sehrinde

Hörrinde
Steuern die Nervenzellen des motorischen Rindenfeldes hauptsächlich Bewegungen der Skelettmuskulatur, sind jene des sensorischen Rindenfeldes für die Aufnahme bewusster Empfindungen zuständig (z. B. der Haut). Zu den Rindenfeldern der Sinnesorgane gehören die Seh- und die Hörrinde.

Das Großhirn besteht aus der rechten und der linken Gehirnhälfte, die durch den Balken verbunden sind. Bei den meisten Menschen ist die linke Hälfte des Gehirns eher auf Sprache und Verallgemeinerung von Erfahrungen spezialisiert. Räumliches Denken und die Verarbeitung von Bildeindrücken übernimmt eher die rechte Gehirnhälfte . Es gibt jedoch keine strikte Trennung und die Verteilung ist bei jedem Menschen anders.
linke Gehirnhälfte rechte Gehirnhälfte
Sinneswahrnehmungen und Bewegungen werden überkreuz verarbeitet. Die rechte Körperseite von der Linken Gehirnhälfte und umgekehrt.
Alle bewussten Handlungen werden vom Großhirn gesteuert.
ZWISCHENHIRN: Dieses liegt unterhalb des Balkens. Es verknüpft die Empfindungen von den Sinnesorganen mit den entsprechenden Rindenfeldern des Großhirns. Ebenso reguliert es den Stoffwechsel, den Wasserhaushalt und die Körpertemperatur.
MITTELHIRN: In diesem werden hauptsächlich die eingehenden Informationen der Sinnesorgane bearbeitet und Informationen an Muskeln weitergegeben.
KLEINHIRN: Es reguliert das Bewegungszusammenspiel und das Gleichgewicht.
NACHHIRN: Dieses verbindet das Rückenmark mit dem Gehirn. Es steuert automatisch ablaufende Körperfunktionen wie Atmung oder Herzschlag.
Das Gehirn


Die Oberfläche des Großhirns hat Falten! Diese Falten vergrößern die Oberfläche des Großhirns. Die Verknüpfung der Hirnzellen ist genauso wichtig für die Hirntätigkeit wie ihre Anzahl. Die Struktur dieser Verknüpfungen beeinflusst die Funktion der Gehirnteile. Lernen lebt von der Wiederholung. Denn dadurch werden Verknüpfungen zwischen den Nervenzellen gestärkt, oder neu hergestellt.
Nenne Vorgänge und Bewegungen, die du bewusst steuern kannst!
Nach Schlaganfällen sind oft Teile einer Gesichtshälfte gelähmt. Wie lässt sich daraus schließen, in welcher Gehirnhälfte der Schlaganfall stattgefunden hat?
Im Gehirn entstehen auch unsere Gefühle. Höre dir unterschiedliche Musikstücke an und betrachte unterschiedliche Bilder! Notiere, welche Gefühle dadurch bei dir entstehen! Rufen dieselben Eindrücke bei jedem Menschen dieselben Gefühle hervor?
Die von den Sinnesorganen aufgenommenen Signale werden von Nerven zum Gehirn weitergeleitet. In den Rindenfeldern des Großhirns werden sie dann verarbeitet.
Somit entsteht unsere Wahrnehmung der Sinneseindrücke erst im Gehirn. Dort werden die Sinneseindrücke auch bewertet. So erkennt das Gehirn bekannte Gesichter wieder oder stellt fest, ob uns ein Musikstück gefällt oder nicht. Hier ist auch die Erinnerung an Bilder, Geräusche oder Gerüche angesiedelt. Und nicht zuletzt entscheidet das Gehirn, was wir mit diesen Sinneseindrücken anstellen. Die gemeinsame Erforschung dieser Zusammenhänge mit Wissenschaftern anderer Fachbereiche ist ein wichtiges Betätigungsfeld für Biologinnen und Biologen weltweit.
Überlege, wo Musik und Bilder gezielt Gefühle erzeugen sollen! Besprecht in der Klasse positive und negative Folgen davon! Beispiele für Musik:



Gib an, welche Beschreibung zu welchem Teil deines Gehirns passt! Setze dazu die Buchstaben richtig ein! Tipp: Das Lösungswort, das du so von unten nach oben gelesen erhältst, passt zu diesem Thema.




Es verknüpft die Empfindungen von den Sinnesorganen mit den entsprechenden Rindenfeldern.
D Großhirn Zwischenhirn T


Er verbindet die beiden Gehirnhälften miteinander.




Es reguliert das Bewegungszusammenspiel und das Gleichgewicht.



Es wird in mehrere Rindenfelder eingeteilt, besteht aus zwei Hälften und steuert alle bewussten Handlungen.



In ihm werden die Signale des Gehirns zu den Muskeln und von Sinnesorganen ins Gehirn geleitet.

Mittelhirn E


Es bearbeitet die eingehenden Informationen der Sinnesorgane und gibt Informationen an die Muskeln weiter.

N Rückenmark

Nachhirn D
I


2 3 4

Es verbindet das Rückenmark mit dem Gehirn und steuert automatisch ablaufende Körperfunktionen
LÖSUNGSWORT: . . . . . . .
Gib an, aus welchen beiden Teilen das Zentralnervensystem besteht!
Es besteht aus dem und dem .
Unser Gehirn hat sich über viele Millionen Jahre entwickelt. Hinzugekommene Teile haben neue Fähigkeiten ermöglicht. Sie dir die Lage der unterschiedlichen Teile im Gehirn in Abbildung 6 genau an. Welche Teile könnten sich früher, welche später entwickelt haben? Schreibe deine Begründung auf!
Weshalb muss man einen Handstand sehr oft üben, bevor es einem leicht fällt, stehen zu bleiben? Hat sich in der Zeit des Übens etwas im Hirn verändert? Tipp: Lies das Info Post-it.
Überlege gut und finde eine Erklärung, weshalb in dem alten Sprichwort „Übung macht den Meister“
auch aus biologischer Sicht ein wahrer Kern steckt!

Modelle sollen die Wirklichkeit vereinfacht und anschaulich darstellen. Durch sie kannst du den Aufbau und die Funktion lebender Systeme gut erfassen. Es können aber auch Eigenschaften
Strukturmodell
Es ist eine künstliche Nachbildung eines natürlichen Objekts, die nur zum Betrachten dient.

1. SCHRITT: betrachten
Studiere das Modell genau!
Welche Bauteile kannst du unterscheiden?
2. SCHRITT: Fachbegriffe und Funktionen zuordnen
Bestimme durch Fachbegriffe die einzelnen
Bauteile des Modells! Verwende dazu dein Lehrbuch!
Dann ordne den von dir benannten Bauteilen auch die entsprechenden Funktionen zu!
3. SCHRITT: vergleichen und festigen
Vergleiche das Modell mit dem Original! Schaut es z. B. so aus, wie auf einer Zeichnung abgebildet? Was fehlt? Ist das, was fehlt für das, was untersucht werden soll, wichtig?
fehlen, die zum Erkennen und Verstehen von Zusammenhängen wichtig sind. In der Biologie verwendet man zwei Arten von Modellen: Strukturmodelle und Funktionsmodelle.
Funktionsmodell
Mit ihm lassen sich biologische Vorgänge sehr gut darstellen. So kannst du z. B. mit Hilfe dieses Augenmodells nachvollziehen, wie das Bild im Auge entsteht. D D D D D D D D D D D
Um die Fachbegriffe zu festigen, zeige abwechselnd mit einer Lernpartnerin oder einem Lernpartner auf die Bauteile des Modells und benennt diese ebenso wie die Funktion!

1. SCHRITT: Anleitung lesen
Lies zuerst die Anleitung und verschaffe dir so einen Überblick!
Wie sieht der Aufbau des Modells aus? Was kann man am Modell erkennen?
Wie muss man es bedienen?
2. SCHRITT: zuordnen und ausprobieren
Vergleiche das Modell mit dem Original und ordne die einzelnen Teile des Modells den entsprechenden Teilen des Originals zu! Tipp: Wenn du nicht weiterweißt, sieh in deinem Biologiebuch nach!
Probiere es nach der Anleitung aus und beobachte, was passiert!
3. SCHRITT: beschreiben, erläutern und beurteilen
Beschreibe genau, was du beobachtet hast! Erkläre den beobachten Vorgang!
Tipp: Wenn du dabei Schwierigkeiten hast, lies in deinem Biologiebuch nach, wie der Vorgang ablaufen sollte! Wie ähnlich verhält sich das Modell zur Wirklichkeit? Lassen sich Abweichungen erklären?
Beurteile, ob dir das Modell geholfen hat, die Funktionsweise des Originals besser zu verstehen! Besprich das auch mit deinen Mitschülerinnen und Mitschülern!
Tränenkanal
Tränendrüse

Abb. 2: Tränendrüse und Tränenkanal
Partikelchen, das: sehr kleines Teil
Erkläre, warum du dir die Nase putzen musst, wenn du weinst!
Mio: Millionen

Wie wird das Auge bewegt?
Das Auge wird mit Hilfe von sechs Muskeln in alle Richtungen bewegt. Auch unbewusst führen die Muskeln ständig winzige Bewegungen durch. Deshalb trifft das einfallende Licht nicht immer auf dieselben Sehsinneszellen der Netzhaut.

Das Auge ist für uns ein sehr wichtiges Sinnesorgan, da es Lichtreize aufnimmt und verarbeitet. Nerven leiten die Information an das Gehirn weiter, wo in der Sehrinde die Wahrnehmung erfolgt. Funktioniert ein Teil dieses Sinnessystems nicht, entsteht keine Wahrnehmung.
Unsere Augen liegen gut geschützt in der knöchernen Augenhöhle. Augenbrauen, Wimpern und die beiden Lider schützen die Augen vor Schweiß und kleinen Partikelchen, die ins Auge eindringen können. Von den Tränendrüsen wird Tränenflüssigkeit abgegeben und mit dem Lidschlag am Auge verteilt, um das Auge zu reinigen und zu befeuchten. Dann fließt die Tränenflüssigkeit durch den Tränenkanal zur Nase ab.
Sehnerv
Blutgefäße
blinder Fleck
Netzhaut gelber Fleck
Aderhaut
Abb. 1: wichtigste Teile des Auges

Abb. 3: Augenmuskeln
gallertartig: zähflüssig
Glaskörper
Linse

Hornhaut
Pupille
Regenbogenhaut weiße Augenhaut
Die Hülle des Auges besteht aus drei Häuten: der weißen Augenhaut, der Aderhaut und der Netzhaut.
Weiße Augenhaut (Lederhaut): Sie liegt ganz außen und besteht aus festem Bindegewebe. An ihr setzen die Augenmuskeln an. Die durchsichtige und berührungsempfindliche Hornhaut ist mit der Augenhaut verwachsen. Hinter der Hornhaut liegen die Pupille, welche schwarz erscheint, und die farbige Iris (Regenbogenhaut). Die Pupille regelt die einfallende Lichtmenge durch Veränderungen ihrer Weite mithilfe von Muskeln in der Regenbogenhaut.
Aderhaut: Sie liegt in der hinteren Hälfte der Augenwand. Die Aderhaut ist der blutreichste Teil des Auges, da sie von zahlreichen feinen Blutgefäßen durchzogen ist.
Netzhaut: Sie ist die innere Schicht und jener Teil des Auges, der mit 150 Mio. Sehsinneszellen die Lichtreize aufnimmt.
Im Innenraum des Auges – zwischen Linse und Netzhaut – liegt der Glaskörper. Er besteht aus einer durchsichtigen, gallertartigen Flüssigkeit.
Der Sehnerv leitet die Erregungen der Sehsinneszellen vom Auge an das Gehirn weiter. Er besteht aus zahlreichen Fasern, welche die Axone der Sehsinneszellen sind. Jene Stelle, an der der Sehnerv aus dem Glaskörper austritt, nennt man blinder Fleck, weil sich an dieser Stelle keine Sehsinneszellen befinden. Als gelben Fleck wird die Stelle an der Netzhaut bezeichnet, an der sich die meisten Sehsinneszellen befinden.
Ohne Licht könnten wir nicht sehen. Licht, das von einem Gegenstand reflektiert wird, gelangt durch die Hornhaut, die Linse und den Glaskörper auf die Netzhaut. Die verformbare Linse bündelt dabei das durch die Pupille eintretende Licht so, dass es exakt auf die Sehsinneszellen der Netzhaut trifft. Dort entsteht ein auf dem Kopf stehendes Bild.

Abb. 4: Bildentstehung im Auge
Von den Sehsinneszellen werden die Erregungen ins Gehirn geleitet. Erst dort wird die Information so verarbeitet, dass ein aufrechtes Bild wahrgenommen wird.
Um in der Nähe Dinge scharf zu sehen, braucht unser Auge eine andere Einstellung als für Dinge, die weiter entfernt sind. Diese Entfernungseinstellung nennt man Akkommodation.


Abb. 6: Nahakkommodation
angespannter Ringmuskel raschere Ermüdung
entspannte Fasern gewölbte Linsenform
Stellt sich das Auge auf einen Gegenstand in der Nähe ein, spannt sich der Ringmuskel um die Linse. Dabei werden die Fasern, an denen die Linse aufgehängt ist, locker und die elastische Linse wölbt sich stärker. Durch die stärkere Lichtbrechung werden Gegenstände in der Nähe scharf gesehen. Mit angespanntem Ringmuskel ermüdet das Auge rascher.

entspannter Ringmuskel langsamere Ermüdung

angespannte Fasern
flache Linsenform
Abb. 7: Fernakkommodation
Stellt sich das Auge hingegen auf einen Gegenstand in der Ferne ein, entspannt sich der Ringmuskel. Dabei ziehen die Fasern die Linse auseinander und ihre Form wird flacher. Die Lichtstrahlen werden weniger stark gebrochen und entfernte Gegenstände auf der Netzhaut scharf abgebildet. Der Ringmuskel wird bei der Fernakkommodation weniger beansprucht als bei der Nahakkommodation. Deswegen ist das Sehen in die Ferne weniger anstrengend, als Lesen oder konzentriertes Betrachten eines Bildschirms.


Warum ist die Pupille nicht immer gleich groß? Die Regenbogenhaut umgibt eine kleine Öffnung, die Pupille. Die Größe der Pupille wird durch die Muskelfasern der Regenbogenhaut verändert.

reflektieren: spiegeln verkleinerte Pupille: In einer hellen Umgebung verkleinert sich die Pupille.

vergrößerte Pupille: Im Dunkeln öffnet sich die Pupille, sodass möglichst viel Licht einfallen kann.
Abb. 5: Anpassung der Pupille

Abb. 6 + 7: Führe folgenden Versuch durch: Halte einen Stift knapp vor deine Augen, sodass du ihn scharf sehen kannst! Wie siehst du den Hintergrund? Fixiere nun einen Gegenstand im Hintergrund! Was passiert mit dem Stift? Stelle eine Vermutung an, was bei diesem Versuch in deinen Augen geschehen ist!

Erfahre hier mehr über das Auge!
Was ist Farbenblindheit?
Bei manchen Menschen sind die Zapfen, die für rotes und grünes Licht empfindlich sind, nicht voll funktionsfähig. Deshalb können sie rote und grüne Farben nicht unterscheiden. Sie leiden an einer „Rot-GrünFarbenblindheit“.




Abb. 9: Wahrnehmung bei Rot-Grün-Farbenblindheit

Abb. 10: Farbentafel zum Erkennen einer Rot-GrünFarbenblindheit: Solltest du keine Zahl erkennen, suche eine Augenärztin oder einen Augenarzt auf.
Sicherlich kennst du das Sprichwort „nachts sind alle Katzen grau“. Betrachte farbige Gegenstände, bei Dämmerung, oder in einem abgedunkelten Raum. Ist das Sprichwort richtig? Erkläre deine Beobachtung!
Mit unseren Augen können wir einerseits zwischen Farbreizen und andererseits zwischen Hell und Dunkel unterscheiden. Dafür haben wir auf der Netzhaut zwei unterschiedliche Typen von Sehsinneszellen: Stäbchen und Zapfen. Diese, so wie das Auge selbst, haben sich über viele Millionen Jahre aus einfachen lichtempfindlichen Zellen entwickelt. Unser Sehsinn ist durch evolutionäre Anpassung optimal an die Verarbeitung des Lichts der Sonne angepasst.
Es gibt drei unterschiedliche Arten von Zapfen , jeweils eine für den Farbbereich Rot, Grün oder Blau. Im Gehirn werden die Signale der Zapfen zu Farbeindrücken verarbeitet. Sie ermöglichen also die Wahrnehmung aller Farben, die wir unterscheiden können. Damit die Zapfen reagieren, benötigen sie eine gewisse Lichtmenge. Ist nicht genügend Licht vorhanden, können wir daher keine Farben wahrnehmen.
Licht

Nervenzellen
Schaltzellen
Stäbchen
Zapfen
Stäbchen reagieren schon bei geringen Lichtmengen. Sie erlauben es uns also, auch bei Nacht zu sehen, wenn auch nicht besonders gut. Stäbchen erlauben auch kein Farbsehen, sondern nur das Unterscheiden von Hell und Dunkel . Deswegen erscheinen uns in der Dämmerung Farben nur noch als grau.
Fällt Licht auf die Stäbchen, oder Zapfen, werden sie erregt. Die Signale mehrerer Sehsinneszellen werden von Schaltzellen gesammelt und zu einer ersten Verarbeitung miteinander verschaltet. Das Signal wird dann zu den Nervenzellen weitergeleitet. Deren Axone, die gemeinsam den Sehnerv bilden, übertragen das Signal zur weiteren Verarbeitung an das Gehirn.
Unsere beiden Augen haben einen bestimmten Abstand zueinander. Das bedeutet, jedes Auge nimmt dasselbe Bild aus einer etwas anderen Richtung auf. Das Gehirn erschafft aus dieser Abweichung ein einzelnes räumliches Bild. Je weiter ein Gegenstand entfernt ist, desto kleiner ist die Abweichung in den Richtungen. So können wir die Entfernung und die Größe von Gegenständen abschätzen.


Führe den Versuch mit dem Zeigefinger und dem Türstock durch! Was passiert, wenn du abwechselnd ein Auge schließt?
Abb. 11: Bild des linken Auges
Abb. 12: Bild des rechten Auges Es ist möglich, die beiden Einzelbilder wahrzunehmen. Dafür brauchen wir eine senkrechte Referenzlinie, beispielsweise einen Türstock. Wir stellen uns ein Stück weit davon entfernt hin, so dass er in der Mitte unseres Blickfeldes ist. Nun halten wir den ausgestreckten Zeigefinger vor unsere Nase. Eines von beiden können wir scharf sehen, das andere unscharf und doppelt. Das sind die beiden Bilder, die durch unsere beiden Augen entstehen.
Unser Gehirn verarbeitet Bilder aufgrund der Erfahrung, die wir im Verlauf unseres Lebens machen. Mit der Zeit lernt es die Information, die wir über unsere Augen aufnehmen passend zur Welt, die wir erfahren, einzuordnen. Kleine Kinder nehmen beispielsweise räumliche Tiefe anders war als Erwachsene. Durch die gemachte Erfahrung wissen wir, dass Gegenstände, die weiter entfernt sind, kleiner erscheinen. Oder dass sich ein Gegenstand, der einen anderen verdeckt, vor diesem befindet.

Unser Gehirn erzeugt, erlernte Deutungen der Bilder, die wir über unsere beiden Augen aufnehmen. Diese Deutungen helfen uns, schnell und ohne nachzudenken die Welt um uns mit unserem Sehsinn einzuordnen.
Abb. 13: Die Kinder hinten erscheinen kleiner.
Das ist sehr praktisch, doch was passiert, wenn unserem Gehirn Informationen gegeben werden, die nicht mit diesen erlernten Deutungen verträglich sind? Dann kann es das Gesehene nicht richtig einordnen und es entstehen optische Täuschungen. Was wir sehen, stimmt nicht mehr mit den tatsächlichen Gegebenheiten überein.
In Abbildung 13 ist eine seltsam anmutende Szene abgebildet. Scheinbar gehen hier Nonnen in sehr unterschiedlichen Größen spazieren. Unser Gehirn ist sich sicher, die Nonnen weiter hinten im Säulengang sind im Bild viel größer als jene weiter vorne. Diese optische Täuschung spielt mit der Perspektive. Perspektive bezeichnet wie Dinge, die im Raum verteilt sind, von einem bestimmten Standpunkt aus gesehen werden.
Abb. 14: Unterschiedlich groß?

Ordne verschiedene Gegenstände unterschiedlich an und betrachte sie aus verschiedenen Richtungen! Beleuchte sie auf verschiedene Art und Weise! Sieh genau hin und vergleiche! Welche Eindrücke verraten dir etwas über die Lage und Beschaffenheit der Gegenstände? Notiere deine Beobachtungen!
Bei Bildern wie in Abbilddung 15 tut sich unser Gehirn schwer die räumlichen Zusammenhänge einzuschätzen. Das Probieren die richtige Ordnung zu finden, sehen wir als Bewegung. Blicke eher an den Rand, oder lass den Blick schweifen.
Abb. 15: Bewegt sich hier etwas?



Denke darüber nach wie es wäre, wenn unser Gehirn Eindrücke nur durch bewusstes Wahrnehmen und aktives Nachdenken einordnen könnte! Welche Konsequenzen hätte das für uns im Alltag? Besprecht eure Gedanken in Teams!

Abb. 14: Überprüfe mit einem Lineal, wie groß die Frauen auf dem Foto sind! Dann erörtere gemeinsam mit deiner Sitznachbarin oder deinem Sitznachbarn, wie die optische Täuschung zustande kommt!
Suche online nach Bildern und Videos zu optischen Täuschungen! Besprecht diese in Kleingruppen! Kannst du vermuten, oder stand beschrieben, wie der Effekt zustande kommt? Tipp: du kannst gezielter nach optischen Täuschungen suchen, indem du Stichwörter wie Größe, Proportion, Farbe, oder Bewegung zu deinem Suchtext hinzufügst. Lasse dir auch weitere Stichwörter einfallen und sieh nach, wie deren Verwendung deine Suchergebnisse beeinflusst!
Brechkraft, die: gibt an, wie stark ein Lichtstrahl in einer Linse abgelenkt wird
Viele Menschen leiden an Weitsichtigkeit oder an Kurzsichtigkeit. In beiden Fällen entsteht das Bild eines Gegenstandes nicht direkt auf der Netzhaut. Das kann daran liegen, dass die Brechkraft der Linse zu groß oder zu klein ist, oder dass der Augapfel zu kurz oder zu lang ist. Die Brechkraft wird in Dioptrien (dpt) gemessen.


konkave Linse (Zerstreuungslinse)
Wenn Menschen kurzsichtig sind, entsteht das Bild beim Betrachten ferner Gegenstände vor der Netzhaut. Eine Brille/Kontaktlinse mit einer Zerstreuungslinse, die eine konkave Form hat, sammelt die Lichtstrahlen so, dass sie auf der Netzhaut auftreffen.
Elastizität, die: Verformbarkeit

Abb. 16: Bindehautentzündung

Abb. 17: Gerstenkorn

Nenne Maßnahmen, die du treffen kannst, um deine Augen zu schützen!
Stelle eine Vermutung an, welcher Augenfehler auftreten kann, wenn jemand ständig auf einen nahen Gegenstand (z. B. Handy) schaut, während das Auge noch wächst!

konvexe Linse (Sammellinse)
Bei Menschen mit einer Weitsichtigkeit entsteht das scharfe Bild hinter der Netzhaut. Eine Brille/Kontaktlinse mit einer Sammellinse, die eine konvexe Form hat, kann diesen Augenfehler korrigieren. Der Brennpunkt und damit das scharfe Bild wird nach vorne verschoben.
ALTERSSICHTIGKEIT: Diese trifft einen Großteil der Menschen ab dem 40. Lebensjahr, die dann in der Nähe nicht mehr scharf sehen können. Zurückzuführen ist es darauf, dass die Elastizität der Linse mit zunehmendem Alter abnimmt und sie sich bei der Naheinstellung nicht mehr ausreichend verformen lässt. Auch hier können Brillen mit Sammellinsen Abhilfe schaffen.
BINDEHAUTENTZÜNDUNG: Das Auge ist gerötet und glasig, weil die Bindehaut anschwillt und stärker durchblutet ist. Ursachen für diese Erkrankung können allergische Reaktionen sein, aber auch Fremdkörper im Auge oder Entzündungen, die durch Bakterien oder Viren verursacht worden sind. Als Reaktion sondern die Augen vermehrt Flüssigkeit ab. Im Falle einer Bindehautentzündung muss unbedingt eine Ärztin oder ein Arzt aufgesucht werden.
GERSTENKORN: Ein Gerstenkorn ist eine Entzündung am Lidrand. Meist ist eine Infektion der Schweiß- oder Talgdrüsen die Ursache. In schwierigeren Fällen muss die Ärztin oder der Arzt die Schweißdrüse öffnen und mit einer Salbe behandeln.
GRAUER STAR: Beim Grauen Star handelt es sich um eine Trübung der Linse. Davon sind häufig Menschen über 65 Jahren betroffen, in seltenen Fällen kann sie auch angeboren sein. Durch die Trübung verliert das wahrgenommene Bild an Schärfe. Der Graue Star kann operativ behandelt werden. Dabei wird die getrübte Linse entfernt und durch eine Kunstlinse ersetzt.
GRÜNER STAR: Ist der Augeninnendruck dauerhaft stark erhöht, kommt es zu einer Schädigung des Sehnervs. Wird diese Erkrankung nicht behandelt, kann sie zur Erblindung führen. Deshalb ist es insbesondere ab dem 40. Lebensjahr wichtig, regelmäßige Kontrolluntersuchungen bei der Augenärztin oder beim Augenarzt machen zu lassen.
Tanja und Mehmet sind sich uneinig über den Sehsinn. Hilf ihnen zu entscheiden, welche ihrer Aussagen zutreffen und welche nicht! Formuliere Begründungen. Lässt sich immer eindeutig sagen, wer recht hat? Diskutiere in der Klasse!

Tanja sagt „Schau, das mit dem Auge ist ganz einfach. Es funktioniert genau wie eine Kamera. Da kommt Licht hinein und so wie das Licht hinein kommt, wird ein Bild aufgenommen. Eine Kamera ist also ein super Modell für das Auge“
„Ich brauche keine Brille.“, schnaubt Mehmet. „Ich habe im Internet gelesen, dass das Auge wie ein Muskel ist. Wenn man kurzsichtig ist, muss man es nur trainieren. Da gibt’s so einen Doktor, der Übungen dafür entwickelt hat.“
Tanja schüttelt ungläubig den Kopf. „Warum laufen dann so viele Leute mit Brille rum?“ „Was ich aber gehört habe ist, dass man im Alter weitsichtig wird.“ Mehmet erwidert „Ist ja eh logisch. Wenn man alt wird, dann funktionieren die Muskeln nicht so gut. Außerdem wird das Gewebe steifer. Da kann das mit dem in die Weite Sehen gar nicht gut funktionieren.“
1 2

Kurz- und Weitsichtigkeit! Zeichne zuerst bei den Abbildungen 1A und 2 A den Strahlengang ein! Dann ergänze bei beiden Abbildungen B jene Linsen, die Abhilfe schaffen können! Tipp: Sieh auf S. 8 bzw. S. 10 nach!




Lies die zwei Zeilen und sage, so schnell es geht, immer die Farbe und nicht das Wort! Wie
Wissenswertes über unser Ohr!


Ohrenschmalz … ist eine fettige gelbliche
Flüssigkeit, die im äußeren Gehörgang produziert wird und das Trommelfell geschmeidig hält. Feine Härchen transportieren sie gemeinsam mit Staub und abgestorbenen Hautzellen nach außen. Der Gehörgang wird dabei vor Austrocknung und Schmutz geschützt. Ohrtrompete oder Eustachische Röhre … verbindet das Mittelohr mit dem Rachenraum und ermöglicht einen Druckausgleich mit der Umgebung zum Schutz des Trommelfells.
Abb. 1: Ordne die Zahlen im Text der Abbildung richtig zu!
Führe
folgenden Versuch durch: Drücke die Nase zu und schlucke! Beschreib, was du fühlst! Dann finde eine Erklärung dafür!

Du kennst vielleicht auch den Trick beim Tauchen, oder im Flugzeug in die zugehaltene Nase zu blasen. Probiere es aus! Was passiert hier und warum?
ohne Reiz
Vorhofgang
Deckmembran Schneckengang
Mit dem Ohr können wir nicht nur Töne und Geräusche als Reize aus der Umwelt aufnehmen. Mit ihm können wir auch die Lage und die Bewegung unseres Körpers feststellen.
Der Aufbau des Ohres und der Gehörsinn
Schallwellen, die von uns als Geräusche wahrgenommen werden, werden mit der Ohrmuschel (1) des äußeren Ohres aufgenommen. Ihre Form leitet den Schall zum Gehörgang, verändert aber auch richtungsabhängig seinen Klang. Das ermöglicht es uns, Schallquellen zu orten. Die Schallwellen werden dann in den äußeren Gehörgang (2) und weiter zum Trommelfell (3) geleitet. Dieses wird in Schwingungen versetzt. Die drei Gehörknöchelchen Hammer (4), Amboss (5) und Steigbügel (6) nehmen im Mittelohr diese Schwingungen auf, verstärken sie und übertragen sie auf eine dünne Membran, das ovale Fenster (7).
Trommelfell
äußerer Gehörgang Ohrmuschel
Abb. 1: Aufbau des Ohrs

Bogengänge Steigbügel Amboss Hammer
Vorhofsäckchen
Hörnerv Schnecke
ovales Fenster Ohrtrompete
Im Innenohr befindet sich die Schnecke, die wie alle Hohlräume des Innenohrs mit einer Flüssigkeit, der Ohrlymphe, gefüllt ist. Die Schwingungen werden durch das ovale Fenster auf die Ohrlymphe in der Schnecke übertragen, durchlaufen zunächst den Vorhofgang und danach den Paukengang.
Vorhofgang Deckmembran ovales Fenster Steigbügel
Schneckengang Paukengang
Cortisches Organ

Haarsinneszellen Paukengang mit Reiz
Abb. 3: Querschnitt
durch die Schnecke

Abb. 2: Schallausbreitung in der Schnecke Zwischen diesen beiden Gängen liegt der Schneckengang. In diesem sitzt das eigentliche Hörorgan, das Cortische Organ. Dieses besteht beim Menschen aus ca. 15 000 Haarsinneszellen, über denen sich die Deckmembran befindet. Die Schwingungen innerhalb der Ohrlymphe im Schneckengang werden auf die Deckmembran übertragen und regen die feinen Härchen der Haarsinneszellen an. Die so entstehenden Erregungen werden durch den Hörnerv zum Gehirn geleitet, wo sie als akustische Wahrnehmung verarbeitet werden.
Der Gleichgewichtssinn
Mit dem Gleichgewichtssinn, der sich aus dem Lagesinn und dem Drehsinn zusammensetzt, können wir Bewegungen unseres Körpers wahrnehmen und uns im Raum orientieren.
LAGESINN: Die Lagesinnesorgane liegen in den beiden Vorhofsäckchen zwischen den Bogengängen und der Schnecke. Wenn der Kopf aufrecht gehalten wird, drücken Kalkkristalle gleichmäßig von oben auf die Spitze der Sinneshärchen. Diese stecken in einer Gallerthülle. Bewegen wir den Kopf, verlagern sich die Kristalle und die Sinneshärchen bewegen sich. Die Sinneszellen leiten die Erregung zum Gehirn weiter, wo die Lageveränderung wahrgenommen wird.

Abb. 4: Lagesinnesorgan
Führe folgenden Versuch durch: Drehe dich mehrmals sehr schnell um die eigene Achse und halte dann plötzlich an! Beschreibe nun, was du spürst! Finde auch eine Erklärung dafür!

Gallerthülle
Kalkkristalle
Sinneshärchen
Sinneszellen

DREHSINN: Die drei Bogengänge bilden das Drehsinnesorgan. An der Basis jedes Bogenganges befindet sich jeweils eine blasenförmige Erweiterung, eine Ampulle. Die Sinneszellen in den Ampullen besitzen haarförmige Fortsätze.
Bewegen wir unseren Körper, beginnt die Flüssigkeit in den Bogengängen zu strömen. Dadurch biegen sich die Fortsätze und erregen die Nervenzellen. Diese leiten die Erregung über Nervenfasern an das Gehirn weiter, wo die Bewegung des Körpers wahrgenommen wird. Wird die Bewegung plötzlich gestoppt, strömt die Flüssigkeit aufgrund ihrer Trägheit noch kurz weiter. Die Erregungsinformation an das Gehirn stimmt mit der tatsächlichen Bewegung dann nicht überein. Schwindelgefühl entsteht.
Ampulle
Zähle auf, wo du überall mit lauten Geräuschen zu tun hast!
Überlege, was du tun kannst, um zu verhindern, dass Geräusche dein Ohr schädigen!

Sinneszellen haarförmige Fortsätze
Abb. 5: Ampulle mit Sinneszellen und Sinneshärchen
MITTELOHRENTZÜNDUNG: Wenn Bakterien aus dem Nasen-Rachenraum in das Mittelohr eindringen, können sie eine Mittelohrentzündung verursachen. Starke Ohrenschmerzen und hohes Fieber können die Folge sein. Auch das Trommelfell kann geschädigt werden, deshalb immer eine Ärztin oder einen Arzt aufsuchen, damit es zu keinem dauerhaften Hörverlust kommen kann. Leidet jemand häufig an Mittelohrentzündungen, kann ein Paukenröhrchen helfen. Es wird als „Belüftungsröhrchen“ in das Trommelfell eingesetzt, damit sich im Mittelohr keine Flüssigkeiten ansammeln können.
ALTERSSCHWERHÖRIGKEIT: Da bei älteren Menschen die Elastizität der Membrane des Schneckenganges zurückgeht, nimmt die Übertragung von Schwingungen auf die Sinneszellen ab. Vor allem hohe Töne können nicht mehr deutlich wahrgenommen werden. In diesem Fall helfen spezielle Hörgeräte, welche die Töne verstärken.
SCHWERHÖRIGKEIT: Durch zu starke Schallbelastung wie durch laute Musik oder durch Durchblutungsstörungen im Innenohr kann eine Schwerhörigkeit auch bei jungen Menschen auftreten.
„Schwerhörigkeit“ macht einsam! Erörtert gemeinsam, wie es Menschen geht, die wenig oder gar nichts hören können! Wie kann man ihnen helfen?

Zeit für ein Spiel? Macht in eurem Klassenzimmer das Fenster auf und stellt den Timer auf 1 Minute. Niemand darf reden. Was hörst du in dieser Zeit?
Wie breitet sich der Schall im Ohr aus? Bringe die Begriffe in die richtige Reihenfolge, indem du sie nummerierst! Schreibe dann den Weg des Schalls richtig in dein Biologieheft!



































Paukengang Vorhofgang äußerer Gehörgang 1















Ein wichtiges Betätigungsfeld in der Biologie ist die Erforschung von Gemeinsamkeiten und Unterschieden zwischen Lebewesen. Vergleiche Form und Position menschlicher Ohren mit denen von Tieren wie Wolf, Fuchs und Katze! Finde Unterschiede und Gemeinsamkeiten! Kannst du einen Zusammenhang zur natürlichen Art der Nahrungsbeschaffung herstellen?
Immer dieser Lärm! Unsere Ohren haben 24 Stunden am Tag geöffnet. Lies den Informationstext und übertrage dann die enthaltenen Fakten und Angaben über Lärmquellen in die Tabelle!
Lärm ist nicht messbar, nur Schall ist dies. Er wird in Dezibel (dB) gemessen. Im Lärmbereich A, der sicheren Zone, misst man bei einem raschelnden Blatt 10 dB, bei Tritten auf Teppichböden doppelt so viel und beim Flüstern nochmals 10 dB mehr. Im Lärmbereich B (mögliche Lärmbelästigung) misst man bei einem leisen Gespräch 50 dB, in einem Büroraum mit 50 Personen muss man hingegen schon 20 dB mehr aushalten. An der obersten Grenze dieses Lärmbereichs steht die verkehrsreiche Straße. Der Lärmbereich C beginnt mit 85 dB an der Drehbank und endet mit 111 bei Computerspielen. Dazwischen liegen mit bis zu 100 dB die Stereo-Kopfhörer. Im Lärmbereich D geht man schon bei kurzer Einwirkung von Gesundheitsschäden aus. Hier einige Fakten: Rockkonzert 120 dB, Spielzeuggewehre 155 und Knallkörper 166.
Gesundheitsschäden bei kurzer Einwirkung
Gesundheitsgefahr bei Dauereinwirkung mögliche Lärmbelästigung
Worum geht es hier? Formuliere zu jedem Informationstext eine Frage, die als Überschrift dient
INFORMATION FRAGESTELLUNG
Je tiefer eine Haarsinneszelle in der Schnecke liegt, desto tiefere Töne nimmt sie wahr. Da die Schwingungen tiefer Töne weiter in die Schnecke eindringen als die hoher Töne, können wir so unterschiedliche Tonhöhen wahrnehmen.
In der Kriminalistik wird auch der Abdruck der Ohren zur Identifizierung einer Person herangezogen. So kann man aufgrund hinterlassener Ohrabdrücke (Lauschen an Fenstern und Haustüren) Straftäter überführen. Ein Ohrabdruck hat sogar eine ähnlich hohe Beweiskraft wie ein Fingerabdruck, da er am Tatort nicht zufällig entstehen kann.
Eine wichtige Aufgabe der Ohren ist die Lokalisierung von Schallquellen, um damit Richtung und Entfernung zu bestimmen. Ein seitlich einfallender Schall erreicht ein Ohr eher, als das andere.
Außerdem wird er in dem Ohr, das nicht durch den Kopf abgeschattet wird, als lauter empfunden. Diese Laufzeitdifferenzen werden vom Gehirn ausgewertet und dienen der Orientierung im Raum. 4
Vervollständige die Tabelle zu den wichtigsten Sinnen des Ohrs!
Sinn Welche Aufgabe hat er? Wo liegt er? Wie funktioniert er?
Lagesinn
Drehsinn
Duftmolekül, das: in der Luft gelöste chemische Substanz
Erinnere dich an typische Gerüche!
Wie riecht
Weihnachten?
Wie riecht ein Schwimmbad?
Nenne Gerüche, die für bestimmte Ereignisse typisch sind!
Nasenhöhle
Nimm bewusst den Geruch unterschiedlicher Dinge wahr. Notiere, welche Gerüche angenehm, welche unangenehm, oder sogar abstoßend waren. Erkennst du Muster?
Besprecht in der Klasse, wie sich Gerüche auf euer Verhalten und eure Meinung zu Dingen und Menschen auswirken! Recherchiere, welche Berufe mit Gerüchen zu tun haben!
Rezeptor, der: Nervenzelle, die Reize aufnimmt

Erfahre hier mehr über das Riechen!
Der Geruchs- und der Geschmackssinn ermöglichen es uns, Stoffe aus unserer Umwelt wahrzunehmen.
Wenn du Luft einatmest, gelangen mit ihr Duftmoleküle in den oberen Bereich der Nasenhöhle zum Riechfeld. Dort befinden sich in der Riechschleimhaut Nervenzellen, die Riechsinneszellen. Sie sind für den Geruchssinn zuständig und laufen in sogenannte Riechhärchen aus. Wenn an diesen Riechhärchen Duftmoleküle haften bleiben, werden die Nervenzellen erregt. Nervenfasern leiten dann die Erregungen an das Gehirn weiter. Dort werden Gerüche wahrgenommen.
Riechfeld

Abb. 1: Riechorgan mit Riechschleimhaut

Nervenfasern
Duftmoleküle
Schleimschicht
Riechsinneszellen
Riechhärchen
Beim Riechen gibt es 2 unterschiedliche Schwellen:
Wahrnehmungsschwelle:
Sobald 10 bis 100 Mio. Duftmoleküle auf die Riechschleimhaut gelangen, riechst du etwas.


Erkennungsschwelle:
Es sind etwa 50 x mehr Duftmoleküle als bei der Wahrnehmungsschwelle erforderlich, damit wir den Geruch auch erkennen.
Gerüche werden im Gedächtnis sehr lange gespeichert. Man erkennt sie oft nach vielen Jahren wieder. Sie können auch eine Auswirkung auf die Gefühlslage eines Menschen haben, weil mit ihnen etwas Angenehmes oder Unangenehmes verbunden wird.
Jeder Mensch besitzt 20 bis 30 Millionen Riechsinneszellen. Allerdings gibt es nur etwa 350 unterschiedliche Geruchsrezeptoren, die jeweils nur auf eine bestimmte Gruppe von Duftmolekülen ansprechen. Die Kombination mehrerer Rezeptoren, die gemeinsam angesprochen werden, macht es möglich, dass wir viele tausend unterschiedliche Gerüche unterscheiden können.
Der Geruchssinn schützt den Menschen bei der Nahrungsaufnahme, beim Trinken und beim Atmen vor schädlichen Stoffen. Er warnt ihn aber auch vor gefährlichen Situationen wie einem Brand.
Der Geschmackssinn ist eng mit dem Geruchssinn verbunden. Auch die Geschmacksrezeptoren der Zunge reagieren auf jeweils einen bestimmten chemischen Reiz. Der Mensch kann fünf verschiedene Geschmacksrichtungen unterscheiden: süß, salzig, bitter, sauer und umami. Jede Geschmackssinneszelle besitzt Rezeptoren für alle fünf Geschmacksrichtungen.
Geschmackspapillen und Geschmacksknospen

Wallpapillen
Pilzförmige Papillen
Wenn du dir deine Zunge im Spiegel anschaust, siehst du, dass sie eine raue Oberfläche hat. Die Erhebungen werden Geschmackspapillen genannt. Sie vergrößern die Oberfläche der Zunge um ein Vielfaches und sorgen dafür, dass die einzelnen Geschmacksrichtungen verstärkt wahrgenommen werden.
Am vorderen Teil der Zunge liegen pilzförmige Papillen. Diese können nicht nur einen Geschmack erkennen, sondern enthalten auch Sinneszellen für den Tast- und Temperatursinn.
Am hinteren Drittel der Zunge sitzen die Wallpapillen. Sie sind von einem Graben mit vielen Drüsen umgeben, die eine wässrige Flüssigkeit abgeben. Sie spült die Geschmacksstoffe zu den Sinneszellen.
In den Seitenwänden der Geschmackspapillen befinden sich die Geschmacksknospen. Sie sind mit ihren Geschmackssinneszellen die eigentlichen Geschmacksorgane. Die im Speichel gelösten chemischen Stoffe binden sich an die Rezeptoren der Sinneszellen und erregen dadurch die nachgeschalteten Nervenzellen. Diese leiten die Erregung über die Nerven ins Gehirn weiter, wo der Geschmack wahrgenommen wird.
Mit zunehmendem Alter sinkt die Fähigkeit, unterschiedliche Geschmacksrichtungen wahrzunehmen. Ein Baby hat etwa 10 000 Geschmacksknospen, ein Erwachsener aber nur noch 2 000. Luftverschmutzung, virale oder bakterielle Erkrankungen oder auch das Rauchen beeinträchtigen die Leistungskraft des Geschmackssinns zusätzlich.

umami: würzige, fleischige Geschmacksempfindung
Rezeptoren
Abb. 3: Geschmackspapille mit Geschmacksknospe

Beschreibe den Geschmack einer bestimmten Speise, indem du einzelne Teile des Geschmacks mit andern vergleichst! Beschreibe auch, welche Gefühle und Stimmungen die Speise hervorruft!


Was ist „umami“?
Der Begriff „umami“ ist japanisch und bedeutet „fleischig und herzhaft“. Der Auslöser für diesen Geschmacksreiz ist Glutamat. Dieses kommt in fast allen eiweißhaltigen Lebensmitteln wie Fleisch und Käse vor.
Geschmacksknospen
† †
Der Geschmacksund der Geruchssinn schützen vor Gefahren. Erörtert gemeinsam, wie dieser Schutz funktioniert! Vor welchen Gefahren könnten die beiden Sinne warnen?
Was ist wichtig? Lies den Informationstext zuerst aufmerksam durch! Dann markiere Signalwörter im Text und schreibe sie als Merkhilfen auf den Zettel daneben!

2 3
Der Geschmackssinn ist nicht nur dazu da, damit wir besonders gut schmeckende Speisen zu uns nehmen. Er hilft uns auch, Nahrung auf ihre Genießbarkeit hin zu überprüfen. Außerdem wird mit dem Schmecken die Produktion der Magensäfte angeregt, da das Gehirn bzw. der Parasympathikus die dafür notwendigen Signale an den Magen sendet. Geschmacks- und Geruchssinn wirken zusammen und ermöglichen erst gemeinsam komplexe Geschmackseindrücke. Dies merkt man dann, wenn man eine verstopfte Nase hat und nur mehr eingeschränkt, Geschmackseindrücke wahrnehmen kann. Neben den Geschmacksrichtungen süß, salzig, bitter, sauer und umami wird auch oft scharf als Geschmacksempfindung wahrgenommen. Scharf ist aber genaugenommen ein Schmerzsignal der Nerven bei Speisen, die mit scharfen Gewürzen (z. B. Chili) gewürzt sind.

Decke den Text von Aufgabe 1 ab und verfasse mit Hilfe deiner gewonnenen Schlagwörter eine kurze Zusammenfassung in deinem Heft!
Hier fehlt je einiges! Beschrifte folgende Abbildung!

Riechsinneszellen
Lies diese Informationstext und formuliere anschließend eine passende Überschrift!
Wissenschafterinnen und Wissenschafter haben herausgefunden, dass Glutamat selbst einen Geschmack hat. Umami wird das pikante, würzige Aroma in Japan genannt. Man findet es in Fertig- und Tiefkühlgerichten, Packerlsuppen, Gewürzmischungen, Salat- und Würzsoßen. Sogar naturbelassene Lebensmittel enthalten diesen Geschmacksverstärker. Seit knapp 100 Jahren verwendet man Glutamat in der chinesischen Küche. Bei uns kam Glutamat in den 1970er-Jahren in Verruf, als das sogenannte „Chinarestaurant-Syndrom“ auftrat. Nach dem Verzehr von chinesischen Essen zeigten Europäern und Amerikanern eine Unverträglichkeit auf Glutamat. Sie bekamen Kribbeln oder Taubheit im Nacken, Armen und Rücken sowie ein Schwächegefühl und Herzklopfen. Langzeitstudien belegen aber, dass nur eine hohe Menge zwischen 3 und 6 Gramm auf nüchternen Magen vereinzelt Unverträglichkeitsreaktionen auslösen kann.
Die Haut ist mit ca. 2 m² das größte Organ des Menschen. Sie bedeckt die gesamte Oberfläche unseres Körpers und erfüllt mehrere wichtige Funktionen:
Schutzfunktion: Sie schützt vor Infektionen, Verletzungen, Austrocknung und UVStrahlung.
Sinnesfunktion: Sie vermittelt Eindrücke aus der Umwelt, z. B. Temperaturunterschiede, Beschaffenheit von Oberflächen (rau, feucht, heiß usw.), aber auch Schmerzempfindungen.
Ausscheidungsfunktion: Sie scheidet Salze, Talg und Wasser aus.
Temperaturregulierung: Sie reguliert die Körpertemperatur durch Schwitzen sowie durch das Erweitern und Verengen der Gefäße in der Haut.
Hornschicht
Keimschicht
Nervenendigungen
Blutgefäße
Pigmentzellen
Haarmuskel
Talgdrüse

Abb. 1: Querschnitt der Haut
Oberhaut
Lederhaut

Führt folgenden Versuch durch: Nehmt drei Gefäße! Füllt eines mit kaltem Wasser, eines mit heißem Wasser (nicht zu heiß, ihr sollt eure Hand hineinstecken können, ohne euch zu verbrennen) und eines mit lauwarmem Wasser! Einer Mitschülerin oder einem Mitschüler werden die Augen verbunden. Dann soll sie oder er einige Minuten lang eine Hand in das kalte und die andere in das heiße Wasser halten.
Unterhaut
Haarwurzel
Sinneszelle
Schweißdrüse
Unsere Haut besteht aus drei Schichten: der Oberhaut, der Lederhaut und der Unterhaut.
OBERHAUT: Diese bildet die äußere Grenzschicht unseres Körpers. Sie besteht aus der Hornschicht und der Keimschicht
Die Hornschicht setzt sich aus abgestorbenen Zellen zusammen und wirkt als Schutz gegen Bakterien oder Pilze. Talg und Schweiß aus den Drüsen der Lederhaut halten sie geschmeidig. In der Keimschicht sind Pigmentzellen eingelagert, die bei Sonnenbestrahlung dunkle Farbstoffe bilden. Diese geben sie an andere Hautzellen ab und schützen so vor UV-Strahlung. Die Keimschicht produziert ständig neue Hautzellen. Abgestorbene Zellen wandern in die Hornschicht.
Anschließend soll sie oder er beide Hände in das lauwarme Wasser tauchen. Was empfindet sie oder er? Findet eine Erklärung dafür!


Welche Sinnesorgane gibt es in der Haut?
• Vater-Pacini-Körperchen reagieren auf Vibrationen und Erschütterungen.
• Ruffini-Körperchen erkennen, wenn die Haut gedehnt wird.
• Meissner-Körperchen sind druckempfindlich und stellen den Tastsinn dar.
Horn, das: hartes Material, das von der Haut gebildet wird
Talg, der: fettähnliche Masse
LEDERHAUT: In der darunterliegenden Lederhaut liegen zahlreiche Talgdrüsen, die Talg absondern und die Haut geschmeidig halten. Die Schweißdrüsen der Lederhaut geben den Schweiß an die Hautoberfläche ab. Schweiß besteht zum Großteil aus Wasser, das beim Verdunsten für die Kühlung des Körpers sorgt. Mit ihm werden aber auch Abfallstoffe wie Harnstoffe ausgeschieden. Schweiß bildet den Säureschutzmantel der Haut.

Erfahre hier mehr über die Haut!
Zähle auf, welche Wahrnehmungen aus der Umgebung du mit deiner Haut machen kannst!
An den Lippen und im Bereich des Mundes gibt es besonders viele Kälteund Wärmerezeptoren. Stelle eine Vermutung auf, warum das so ist!

Wie empfinden wir Schmerzen?

Schmerzrezeptoren sind freie Nervenendigungen, die in der Haut, aber auch in anderen Geweben, vorkommen. Verletzt man sich, werden die freien Nervenendigungen gereizt. Sie geben Schmerzimpulse über Schmerzbahnen, die im Rückenmark verlaufen, in Richtung Hirnstamm ab. Auch die Temperatur fühlen wir über freie Nervenendigungen.

Abb. 3: scheinbare Vergrößerung durch Aufrichten der Fellhaare
Finde eine Erklärung für die „Gänsehaut“! Welchen Sinn hatte sie bei unseren Vorfahren im Tierreich!
Blutgefäße in der Lederhaut versorgen die Haut mit Nährstoffen und Sauerstoff. Haare, Finger- und Zehennägel werden in der Lederhaut gebildet.
Auch die meisten Sinneseindrücke, die uns die Haut vermittelt, entstehen in dieser Schicht: So liegen in ihr mehrzellige Rezeptoren für den Tastsinn, die sich durch ihre Form, ihre Lage und ihre Empfindlichkeit unterscheiden. Kälte und Wärme werden hingegen durch freie Nervenendigungen wahrgenommen. Es gibt ca. 10-mal mehr Rezeptoren für Kälte als für Wärme.
UNTERHAUT: Diese bildet die unterste Schicht und besteht hauptsächlich aus Fettgeweben, die als Energiespeicher und als Schutz vor Kälte und Stößen dienen. Die Unterhaut stellt eine lockere Verbindung mit Muskeln und Sehnen her.




Abb. 2: 1. Akne auf der Stirn; 2. Sonnenbrand; 3. Fieberblase


AKNE: Viele Pubertierende leiden unter dieser Erkrankung. Dabei verengen und verschließen sich die Ausfuhrgänge der Talgdrüsen, sodass der Talg nicht an die Hautoberfläche abgegeben werden kann. Die Ausfuhrgänge entzünden sich und beginnen zu eitern. Akne kann unterschiedliche Ursachen haben wie Entzündungen durch Bakterien, Hormoneinwirkung, Stress usw. Bei Akne sollte ärztliche Hilfe eingeholt werden.
SONNENBRAND: Setzt man die Haut zu lange einer zu intensiven Sonneneinstrahlung aus, kann sie stark geschädigt werden. Sie rötet sich und wird extrem berührungsempfindlich. Blasen bilden sich und die Haut löst sich ab. Spätfolgen wie Hautkrebs sind möglich. Als Schutz sollte man Sonnencremen mit hohem Lichtschutzfaktor verwenden.
FIEBERBLASEN: Diese entstehen durch eine Virusinfektion. Sie sind zwar harmlos, aber unangenehm. Es bilden sich kleine Bläschen im Lippenbereich, die nach einigen Tagen aufplatzen oder sich wieder rückbilden. Bis heute gibt es kein Mittel dagegen. Salben oder Tinkturen können lediglich die Symptome lindern.
Haare bestehen aus verhornten Zellen und wachsen täglich ca. 0,4 mm. An den Haarwurzeln sitzen Muskeln, die sich manchmal bei Gefühlen wie Zorn oder Angst zusammenziehen und damit das Haar aufrichten. Bei Tieren mit Fell entwickelte sich dieses Verhalten, um im Falle einer Bedrohung durch Feinde durch „Aufplustern“ größer zu wirken (Imponier- und Drohfunktion).
Stelle eine Hypothese auf, wie die „Gänsehaut“ im Laufe der Evolution entstanden ist! Wann tritt sie auf?
Auch bei Kälte kommt es zu einem Zusammenziehen des Haarmuskels. Dabei wird die Haarwurzel etwas nach oben gedrückt, wir spüren das als „Gänsehaut“.
Finger- und Zehennägel bestehen ebenfalls aus Horn und bieten Schutz vor Druck und Stoß. Sie wachsen ca. 1 mm pro Woche.
Wortschneckenrätsel – In der Schnecke sind 9 wichtige Begriffe zum Thema Haut enthalten. Suche sie heraus und schreibe sie jeweils zur passenden Worterklärung!
Sie stellen die Haare auf.
In ihr ist Fettgewebe eingelagert.
Sie reagieren z. B. auf Druck.
Sie ist die mittlere der drei Hautschichten.
Diese Drüsen sorgen für Abkühlung und für das Ausscheiden von Abfallstoffen.
Sie besteht aus Horn- und Keimschicht.
Sie sorgen für geschmeidige Haut.
Bei vermehrter Sonneneinstrahlung bilden sie dunkle Farbstoffe.
Sie versorgen die Haut mit Sauerstoff und Nährstoffen.

Weißt du noch? – Erinnere dich an die vier Funktionen der Haut! Welcher der Begriffe passt zu welcher Funktion? Male die Rahmen der Kästchen laut Angabe an!
Überhitzung

Schutzfunktion

Sinnesfunktion

Ausscheidungsfunktion

Temperaturregelung
TATTOOS – Ornamente auf der Haut: Lies zuerst den Text über Tattoos aufmerksam durch und markiere beim zweiten Mal Lesen Stichwörter!
Bei einer Tätowierung (Tattoo) handelt es sich um ein Bild, das mit Tinte oder anderen Farbmitteln in die Haut eingeritzt wird. Dabei wird mit einer Nadel in die Lederhaut gestochen und die Farbe eingebracht. Da sich in der Lederhaut Blutgefäße befinden, müssen beim Tätowieren strenge Hygienevorschriften eingehalten werden, damit es dabei nicht zu einer Infektion kommen kann.

Gänzlich unbedenklich sind Tattoos nicht, da man herausgefunden hat, dass Teile der verwendeten Farbstoffe in andere Bereiche des Körpers transportiert werden können. Problematisch wird es besonders dann, wenn die Farben Schwermetalle enthalten. Außerdem beinhalten manche Farben krebserregende Substanzen. Inzwischen gibt es in der EU eine eigene Tätowiermittelverordnung, welche die Gefahren der Farbmittel im Körper bannen soll. Eine Tätowierung ist sehr schwer zu entfernen, weil die Farbpigmente von körpereigenen Zellen eingekapselt werden. Die Farbpigmente können dann nicht mehr abgebaut werden und die Tätowierung bleibt erhalten.

Um Tattoos zu entfernen, gibt es viele Möglichkeiten. Die gängigsten sind Laserbehandlung, flüssige Tattoo-Entferner, chirurgische Eingriffe und Mikrowellen. Der Erfolg hängt vom Tattoo ab, ist aber in jedem Fall mit Risiken verbunden. So können Farbrückstände und Narben zurückbleiben, oder allergische Reaktionen auftreten. Die Laserbehandlung steht im Verdacht, krebserregende Stoffe im Körper zu hinterlassen. Methoden zur Selbstanwendung wirken oft wenig.


Gründe, warum sich Menschen tätowieren lassen, gibt es viele: Die meisten Tätowierten sehen ihre Tätowierung als Schmuckstück oder sogar als Kunstwerk. Für manche Personen ist es wiederum eine Möglichkeit, in einer Massengesellschaft individuell zu bleiben, während andere damit ihre Zugehörigkeit zu einer bestimmten Gruppe zeigen wollen. Andere wiederum sehen eine Tätowierung auch als Mutprobe, während einige sogar den Schmerz beim Tätowieren genießen.
Beantworte nun in deinem Heft die Fragen in ganzen Sätzen!
1. Was versteht man unter einem Tattoo?
2. Warum kann man sich beim Tätowieren Virusinfektionen zuziehen?
3. Worin bestehen die Probleme der Tattoo-Farben?
4. Warum ist es sehr schwer, eine Tätowierung zu entfernen?
5. Welche Möglichkeiten zur Entfernung gibt es und wie steht es um deren Erfolg?
6. Warum lassen sich Menschen tätowieren?
Würdest du ein Tattoo haben wollen? – Diskutiert in Kleingruppen, wie ihr dazu steht!
Achte auf deine Haut! Versuche zuerst, die Tipps zu lesen! Kreuze dann an, welche du schon befolgst!
Kalt–warme Wechselduschen sorgen aufgrund der kalten und warmen Reize für eine gute Durchblutung der Haut. Genügend Schlaf ermöglicht Zellerneuerung und Geweberegeneration Bewegung an der frischen Luft tut der Haut gut , weil dadurch der Stoffwechsel gefo¨rdert wird. Täglich die Haut mit Wasser und ph-neutralen Seifen pflegen, um Verunreinigungen von außen vorzubeugen. Frisches Obst und Gemüse unterstützen die Haut , weil sie mit wichtigen Stoffen versorgt wird Scharfe Gewürze, fette Speisen, Kochsalz, Süßigkeiten und Alkohol belasten die Haut. Meide lange Sonnenbäder, vor allem in der Mittagszeit! Sonnencremen verwenden, weil sie die UV-Strahlen filtern.

Wie du in den vorangegangenen Kapiteln gelernt hast, nehmen die Sinnesorgane Reize aus der Umwelt auf und wandeln sie in Nervensignale um, die dann durch die Nerven an das Gehirn weitergeleitet werden.
Stell dir vor, du machst einen Spaziergang im Wald. Du siehst die Bäume und hörst die Vögel zwitschern. Gleichzeitig riechst du das Laub, spürst den unebenen Waldboden unter deinen Füßen und schmeckst die Himbeere, die du gerade gepflückt hast. Alle diese Sinneseindrücke gelangen gleichzeitig in dein Gehirn und werden dort zum Gesamtbild des Waldspazierganges zusammengesetzt. Das Erlebnis „Waldspaziergang“ entsteht also erst in deinem Kopf.

Abb. 1: Zusammenspiel der Sinnesorgane
Das Reiz-Reaktions-Schema
Dein Gehirn fügt aber nicht nur die Signale der Sinnesorgane zu einem Gesamteindruck zusammen. Es verbindet diese Signale auch mit anderen Bereichen deines Gehirns. Wenn du dich an ein schlechtes Erlebnis in einem Wald erinnerst, wird dir der Spaziergang vielleicht keinen Spaß machen. Das Gehirn wird auch deine momentane Stimmung – ob du schlecht oder gut „drauf bist“ – beachten.
All diese Faktoren wird dein Gehirn – also eigentlich du selbst – berücksichtigen. Dann entscheidest du dich, was du tun willst. Drehst du den Kopf, um einen bunten Vogel zu beobachten oder steigst du über einen Ast am Boden hinweg?
Ganz allgemein gilt: Die Informationen der Sinnesorgane werden im Gehirn verarbeitet und führen zu einer Reaktion. Man nennt das Reiz-ReaktionsSchema.
Abb. 2: Reiz-Reaktions-Schema
Nenne Sinneseindrücke, die du aufnimmst, wenn du in der Klasse sitzt!
Stelle eine Vermutung an, wie diese einzelnen Sinneseindrücke dein Gesamtbild der Klasse beeinflussen!


Was geschieht im Gehirn?
Die Signale der Sinnesorgane gelangen in die sensorischen Rindenfelder. Sobald die Signale verarbeitet sind und du eine Reaktion setzen willst, werden die motorischen Rindenfelder aktiv. Von dort werden über Nerven Signale an die Muskeln geschickt und du bewegst dich.
Schließe die Augen und stelle dir vor, wie du dich durch die Klasse bewegst! Analysiere, worauf du achtest!
Beobachte und notiere eine Woche lang, wie Stimmungen oder Erinnerungen deine Handlungen beeinflussen!
Geht es anderen Menschen ähnlich? Hast du Tipps für einen guten Umgang miteinander?

Stelle einen Gegenstand vor dir auf den Tisch! Sieh ihn kurz an!
Drehe dich weg und versuche, den Gegenstand zu greifen!
Verändere nun die Position des Gegenstandes! Blicke ihn wieder kurz an! Dreh dich weg und lenke dich ab! Singe ein Lied, lies etwas, zähle, wie viele kreisförmige Gegenstände um dich herum sind, … Versuche, den Gegenstand wieder zu greifen! Was beobachtest du? Hattest du kurz vor dem Zugreifen den Gegenstand vor Augen?
Notiere deine Beobachtungen und finde Erklärungen dafür!
motorisch: Bewegungen betreffend

Früh übt sich…

Die Entwicklung grundlegender motorischer Fähigkeiten findet schon in der frühen Kindheit statt. Darauf aufbauend können wir ein Leben lang neue Bewegungsmuster erlernen und verfeinern. Findet diese Phase frühen Lernens nicht statt, ist es schwierig dies auszugleichen.
Notiere, welche Informationen notwendig sind, um eine Bewegung der Situation anzupassen! Wie gelangt unser Gehirn an diese Informationen?
Das Reiz-Reaktions-Schema beschreibt deine bewussten Entscheidungen. Du entscheidest dich, etwas zu tun. Dazu muss dein Körper Bewegungen ausführen. Jede Bewegung erfordert, dass einzelne Muskeln aktiviert werden. Du musst dich aber nicht darum kümmern, jeden Muskel einzeln zu bewegen. Das erledigt dein Gehirn für dich. Du entscheidest dich, über einen Ast am Boden zu steigen. Alles Weitere erledigt dein Gehirn für dich.
Damit du dich an eine Situation angepasst bewegen kannst, laufen in Sekundenbruchteilen eine Menge Prozesse und Rückmeldungsmechanismen genau aufeinander abgestimmt ab. Als erstes braucht es eine Planung der Bewegung. Diese läuft in der Regel automatisch und unbewusst und baut auf den Eindrücken unserer Sinne auf.
Lies das Info Post-it!
Denke daran, durch was unser Gehirn lernt. Erstelle eine Liste an Tipps, die dabei helfen könnten, dass Kleinkinder gute Bewegungsfähigkeiten entwickeln
Für Planung verantwortlich ist die prä- (vor) motorische Rinde, eines der motorischen Rindenfelder, die du schon kennen gelernt hast. Die motorische Rinde steuert die Ausführung der Bewegung.
Über den Hirnstamm und das Rückenmark gelangen die Befehle durch Nervenbahnen an die Muskeln. Die Kommunikation läuft allerdings nicht nur in eine Richtung. Nervenzellen in den Muskeln senden Information über die tatsächlich ausgeführten Bewegungen zurück an das Gehirn. Dort vergleicht das Kleinhirn die geplante und tatsächlich ausgeführte Bewegung. Dadurch können korrigierende Bewegungsbefehle geplant und ausgeführt werden, falls das geplante Ergebnis noch nicht erreicht wurde.
BEWUSST BEWEGEN WOLLEN PLANUNG (prämotorische Rinde)

BEWEGUNGSBEFEHL (motorische Rinde)
WEITERLEITUNG (Hirnstamm/ Rückenmark)
RÜCKMELDUNG
BEWEGUNGSAUSFÜHRUNG (Muskulatur)
Abb. 3: Ablaufschema bewusst durchgeführter Bewegungen.
Viele Bewegungsmuster werden mit der Zeit von uns verinnerlicht, so dass unser Gehirn sie von selbst, man nennt das automatisiert, abrufen kann. Das ist auch wichtig, sonst wären dir wohl als einfach erscheinende Bewegungen, wie das Fangen eines Balles, ganz schön kompliziert. Du müsstest dich nicht nur auf den Ball konzentrieren, sondern auch bewusst darauf achten, deine Balance zu halten, deine Arme zu heben, deine Finger zu schließen usw.
Bei körperlicher Anstrengung werden im Gehirn Stoffe freigesetzt, die die Bildung neuer Verknüpfungen zwischen Nervenzellen fördern. Das bedeutet, dass körperliche Ertüchtigung nicht nur deinen Körper, sondern auch dein Gehirn fit hält.

weiße Substanz graue Substanz

Abb. 4: Querschnitt durch die Wirbelsäule mit Rückenmark
Das Rückenmark liegt gut geschützt in der Wirbelsäule. Es leitet einerseits Information von den Sinnesorganen zum Gehirn und vom Gehirn zu den Muskeln. Andererseits werden im Rückenmark auch Reize verarbeitet, ohne dass dabei das Gehirn beteiligt ist.
Wenn du mit der Hand auf eine heiße Herdplatte greifst, ziehst du deine Hand unwillkürlich zurück. Dies bezeichnet man als Reflex. Reflexe sind Bewegungen, die sehr rasch erfolgen müssen, da sonst die Gefahr einer Verletzung besteht. Daher werden sie nicht von unserem Willen, also von unserem Gehirn, gesteuert. Die Reize der sensorischen Nerven werden im Rückenmark direkt in Signale der motorischen Nerven an die Muskeln umgewandelt.

Rückenmark Verarbeitung
sensorische Neuronen
Sinneszelle
Was passiert, wenn du stolperst?

Neuronen Muskeln & Organe
…Sinneszelle …Weiterleitung …Verarbeitung
äußerer Reiz Reaktion
Abb. 5: Reiz-Reaktions-Schema beim Reflex
NERVEN: Sie durchziehen unseren gesamten Körper und leiten Reize vom und zum Gehirn. Die Übertragung von Informationen durch die Nerven erfolgt elektrisch und sehr schnell. Die Übertragung von Informationen zwischen Nerven erfolgt chemisch. Dabei kann ein Nerv einen anderen aktivieren, oder deaktivieren.
HORMONE: Sie sind Botenstoffe, die in bestimmten Organen des Körpers gebildet und ins Blut abgegeben werden. Sie werden so im ganzen Körper verteilt und rufen in anderen Organen eine bestimmte Wirkung hervor. Hormone spielen eine große Rolle beim Stoffwechsel und bei der Entwicklung des Körpers. So bewirkt das Hormon Adrenalin zum Beispiel, dass in Gefahrensituationen im Körper Energiereserven mobilisiert werden. Ein anderes Hormon, das Dopamin, ist sehr wichtig für die Bewegungssteuerung, spielt aber auch für eine Vielzahl anderer Prozesse eine große Rolle. Dopamin wirkt beispielsweise im Gehirn und löst angenehme Gefühle bei freudiger Erwartung aus. Es ist somit sehr wichtig für Motivation und Antrieb.

Bist du schon einmal gestolpert? Dein Bein bleibt hängen, dann schnellt es nach vorne, um den Körper aufzufangen. Du reißt die Arme hoch, um das Gleichgewicht zu halten. All das geschieht automatisch, ohne dass du nachdenken musst. Was geschieht dabei in deinem Körper? Im Oberschenkel sitzen Sinneszellen, die über Nerven die Information an das Rückenmark leiten, dass dein Bein sich nicht nach vorne bewegen lässt. Das Rückenmark löst sofort ein Signal aus, das die Muskeln in den Beinen und den Armen aktiviert. So wurde ein Reflex ausgelöst, der dich vor dem Sturz bewahrt hat.
Erzähle von einer anderen Situation in deinem Alltag, in der ein Reflex eine Rolle spielte! mobilisieren: rasch zur Verfügung stellen


Überlege, wie man das Reiz-ReaktionsSchema in Situationen sichtbar machen könnte! Dann drehe mit deinem Smartphone einen kurzen Film, der es beim Reflex erläutert!
Was geschieht beim Fangen eines Balles? Welche Sinnes- und Steuerungsorgane sind dabei beteiligt? Bring die Stichwörter im Kästchen in die richtige Reihenfolge!

2 3 1





sensorische Nervenbahnen © Gehirn © Armmuskeln © Bewegungsnerven © Rückenmark


Führe verschiedene Bewegungen durch! Sei ruhig kreativ und probiere auch ungewöhnliche Bewegungen aus. Überlege gut, was alles dazu beiträgt, dass die Bewegung auch klappt! Beobachte genau und notiere, was davon automatisiert abläuft und auf was du bewusst achten musst! Tipp: In der Gruppe macht das viel mehr Spaß!
Viele alte Menschen, aber auch Menschen mit Einschränkungen fühlen sich bei Bewegungen unsicher. Mache dir Gedanken welche Gründe es dafür geben könnte und schreibe sie auf! Fallen dir Möglichkeiten ein, die Unsicherheiten zu vermindern oder ihnen vorzubeugen? Schreibe eine entsprechende Anleitung! Tipp: Wenn du zuerst Aufgabe 2 machst, wird es leichter.

























Reflexe schützen und helfen uns! Ordne die Beschreibung der Reflexe ihren Funktionen zu, indem du sie mit einem Lineal verbindest!
Pupillenlichtreflex: Wenn plötzlich mehr Licht in das Auge fällt, verengen sich die Pupillen.

Lidschlussreflex: Die Augenlider schließen sich bei einer plötzlichen Reizung.

Hustenreflex: Fremdkörper in den Atemwegen lösen Husten aus.

Beugereflex: Ein schmerzhafter Reiz in einem Körperteil führt zu einer Betätigung der Beugemuskulatur.

Saugreflex: Werden die Lippen eines Säuglings berührt, beginnt er zu saugen.

Greifreflex: Wird die Handfläche eines Neugeborenen berührt, schließt sich die Hand.

Reflexbewegung – Du berührst einen Kaktus und spürst einen Schmerz. Die Reflexbewegung ermöglicht ein rasches Reagieren und verhindert so schwerere Verletzungen. Bringe die Sätze in die richtige Reihenfolge! Nummeriere zunächst von 1 bis 7! Wenn du richtig liegst, ergeben die Buchstaben am Ende der Zeile ein Lösungswort, das du schon kennengelernt hast.













Schutz des Auges vor Schäden durch Fremdkörper

Schutz eines Körperteils vor Verletzung

Automatische Nahrungsaufnahme

Schutz vor Schädigung des Auges durch zu hohe Lichtintensität

Dient zum Festhalten an der Mutter

Schutz der Lunge vor dem Eindringen von Fremdkörpern


Abb.7: Schmerzreiz und Bewegungsreflex
Der Reiz wird in ein elektrisches Signal (Erregung) umgewandelt. Y
Eine Sinneszelle in der Haut nimmt den Reiz wahr. S
Der Muskel führt durch den Reiz eine Reaktion aus, wodurch der Reflex entsteht. S
Im Rückenmark liegt das Reflexzentrum. Das Signal wird verarbeitet. A
Sensorische Nervenbahnen leiten das Signal zum Rückenmark. N
Motorische Nervenbahnen leiten das Signal zum Muskel in deinem Arm. P
Du ziehst deine Hand zurück, bevor der Stachel dich verletzt. E
LÖSUNGSWORT: . . . . . . .

Abb. 1: Bewegung ist gesund.
Überprüfe eine Woche lang mit Hilfe eines Protokolls, wie viel Bewegung du macht!
Schätze dich selbst ein:
Machst du ausreichend Bewegung oder findest du, dass du mehr machen solltest? Nimm kritisch Stellung zu dieser Frage! Vergleicht in der Klasse!
Selbstbewusstsein, das: Überzeugung von den eigenen Fähigkeiten
Selbstwertgefühl, das: Bewertung über sich selbst
Begründe, warum regelmäßige Bewegung das Selbstwertgefühl und das Selbstbewusstsein steigern!
profitieren: einen Vorteil von etwas haben
Wie du gehört hast, ist das Gehirn das zentrale Organ für deine Bewegungen, da es alle Muskeln steuert. Dein Körper ist dazu geschaffen, sich zu bewegen. Er braucht die regelmäßige Bewegung, um gesund zu bleiben.
...die Sauerstoffversorgung
Alzheimer-Krankheit, die: Unheilbare Störung des Gehirns. Durch das Absterben von Nervenzellen werden die Menschen zunehmend vergesslich, verwirrt und orientierungslos.
Wenn du deine Muskeln bewegst, werden mehr Nährstoffe verbrannt, um die nötige Energie bereitzustellen. Dafür ist auch mehr Sauerstoff erforderlich. Du atmest häufiger und tiefer ein und versorgst so deinen ganzen Körper mit mehr Sauerstoff
...den Herz-Kreislauf
Bei Bewegung schlägt dein Herz stärker. Dadurch wird dein Herzmuskel trainiert und mit der Zeit auch kräftiger. Aber auch die Muskulatur, die du zum Atmen brauchst, wird gestärkt.
...den Bewegungsapparat
Muskeln, Sehnen und Bänder werden bei regelmäßiger Bewegung gestärkt. Aber auch deine Knochen werden fester. Das verringert die Gefahr, dass du dich bei einem Sturz verletzt.
... das Immunsystem
Regelmäßige Bewegung stärkt auch deine Abwehr gegen Infektionskrankheiten.
...das allgemeine Wohlbefinden
Bei Bewegung werden Hormone freigesetzt, die deine Stimmung positiv beeinflussen. Menschen, die sich regelmäßig bewegen, haben weniger Depressionen als solche, die das nicht tun.
Wenn du also regelmäßig Sport betreibst, bist du besser drauf! Du fühlst dich besser, dein Selbstbewusstsein und dein Selbstwertgefühl steigern sich und du wirst tiefer und besser schlafen.
...das Gehirn
Auch das Gehirn selbst profitiert von der Bewegung. Es wird stärker durchblutet und bildet mehr neue Nervenzellen. Bei Menschen, die sich bis ins hohe Alter regelmäßig bewegen, bleiben die Verbindungen zwischen den Nervenzellen länger bestehen.
So bleibt auch die Gedächtnisleistung erhalten und das Risiko von Erkrankungen wie der AlzheimerKrankheit ist geringer.
Abb. 2: gesund bis ins hohe Alter


Bewegungsmangel kann krankmachen
Regelmäßige Bewegung ist wichtig für unsere Gesundheit. Umgekehrt kann Bewegungsmangel zahlreiche Erkrankungen hervorrufen.
Wenig Bewegung bewirkt, dass die Muskulatur, die Bänder und die Sehnen schwächer werden. Dadurch sind sie nicht mehr in der Lage, den Körper zu stützen. Haltungsschäden sind die Folge. Das kann dazu führen, dass auch manche inneren Organe nicht mehr richtig funktionieren.
Auch viele andere Erkrankungen können durch Bewegungsmangel hervorgerufen werden oder entwickeln sich dadurch rascher.
...Herzerkrankungen
Die Gefahr eines Herzinfarktes steigt. Das ist eine Durchblutungsstörung des Herzens, bei dem ein Blutgefäß, das den Herzmuskel versorgt, blockiert wird.
...Bluthochdruck
Ein zu hoher Blutdruck kann die Blutgefäße schädigen. In der Folge können auch andere Organe des Körpers in ihrer Funktion gestört werden.
...Diabetes („Zuckerkrankheit“)
Bei dieser Erkrankung ist der Zuckergehalt im Blut zu hoch, da der Zucker von den Zellen des Köpers nicht mehr richtig aufgenommen und verarbeitet werden kann. Die Folge können Erkrankungen der Augen, der Nieren und der Nerven sein.
...Osteoporose Knochensubstanz wird abgebaut. Die Knochen verlieren an Festigkeit und das Risiko von Knochenbrüchen steigt.
...Erhöhung des Cholesterinspiegels
Cholesterin ist ein fettähnlicher Stoff, der im Blut und im Körpergewebe zu finden ist. Zu viel Cholesterin kann zu vielen Störungen im Körper bis hin zu einem Schlaganfall führen.
...Fettleibigkeit (Adipositas)
Der Anteil an Körperfett steigt, was zu Übergewicht führt. Dieses belastet den gesamten Körper. Schäden an den Gelenken können die Folge sein.
...Krebs
Forschungen haben gezeigt, dass Menschen, die sich wenig bewegen, ein höheres Risiko haben, an verschiedenen Krebsarten wie Darmkrebs oder Brustkrebs zu erkranken.
Haltungsschaden, der: körperlicher Schaden, der durch schlechte Haltung und falsche Bewegung entsteht.
Beschreibe einige Haltungsschäden und stelle Vermutungen dazu an, welche Bewegungen oder Gewohnheiten sie hervorgerufen haben könnten!
Suche Aktivitäten des täglichen Lebens, die dich daran hindern, dich zu bewegen! Überlege dir, was du tun kannst, um das zu ändern! Tu es auch!

Abb. 3: Ablesen des Blutzuckerspiegels mit dem Handy

Die meisten dieser Erkrankungen treten bei erwachsenen oder älteren Menschen in Erscheinung. Die Entwicklung beginnt jedoch schon im Kindesalter. Kinder und Jugendliche, die sich nicht bewegen, haben ein hohes Risiko, später unter einer dieser Krankheiten zu leiden. Personen mit einer erblichen Veranlagung haben ein höheres Risiko an bestimmten Krebsarten zu erkranken. Ungesunde Ernährung erhöht dieses Risiko zusätzlich.
Bedenke: Gesund zu sein bedeutet nicht, nicht krank zu sein!
Abb. 4: Bewegungsmangel und ungesunde Ernährung
Schlaganfall, der: Aufgrund einer Durchblutungsstörung fällt ein Teil des Gehirns aus.
Nimm zu dem rot markierten Ausspruch kritisch Stellung!
Grafiken lesen: Dieses Säulendiagramm zeigt dir, wieviel Energie du bei welcher Tätigkeit verbrauchst. Betrachte es und bearbeite anschließend die anderen Aufgaben auf dieser Seite!
Energieverbrauch bei verschiedenen Tätigkeiten in 10 min

Zeige durch Ausmalen der Felder an, welche Tätigkeiten für dich leicht umsetzbar sind (je mehr Felder, desto leichter)! Ergänze die Liste, wenn dir noch etwas einfällt!
Laufen
Schwimmen
Rad fahren
Spazieren gehen
Wandern im Haushalt helfen
Notiere in deinem Heft zielführende Vorschläge für sportliche Aktivitäten, welche du ausführen könntest!
Was ist für dich Gesundheit? Verfasse eine kurze Definition!
ist,

Die Erforschung der Wahrnehmung von Lebewesen ist ein wichtiger Bestandteil der Arbeit von Biologinnen und Biologen. Dazu gehört es zum einen die Sinnesorgane und das Nervensystem verschiedener Lebewesen zu untersuchen, aber auch Reaktionen und das Verhalten von Lebewesen zu betrachten. Viel von dieser Arbeit geschieht im Labor , wo Organe und ihre Funktionsweise bis hin zur einzelnen Zelle genauestens studiert werden. Aber auch Versuche mit lebenden Tieren vermitteln Einblicke. Oft steht die Forschung im Zusammenhang mit medizinischen Fragestellungen. Die Beobachtung von Lebewesen, um Erklärungen dafür zu finden, warum sie tun, was sie tun, ist ein spannender Teil der Biologie. Hier werden Lebewesen auch in ihren natürlichen Lebensräumen beobachtet.
1
2 3
4 OlympeVerlag

Recherchiere Bilder der Augen folgender Tiere: Reh, Wolf, Taube, Falke, Fliege, Makrele! Betrachte Form und Struktur und wo am Kopf des Tieres sie sich befinden! Halte Gemeinsamkeiten und Unterschiede fest und formuliere mögliche Begründungen dafür! Tipp: Denke an Anpassung und Evolution sowie an die Nahrungskette.
Scanne den QR-Code und sie dir das Video an! Die Aufgabe ist, ganz genau zu zählen, wie oft das Team mit den weißen T-Shirts den Ball hin und her passt. Ganz einfach, oder? Was denkst du darüber? Lässt sich hier etwas für andere Situationen lernen, beispielsweise den Straßenverkehr?

Hierfür brauchst du einen „Ersatzarm“ aus Kunststoff, oder einen Handschuh. Es funktioniert auch der Arm einer anderen Person. Platziere den Ersatzarm vor dir auf dem Tisch und decke den Bereich zwischen deiner Schulter und ihm mit einem Tuch ab! Es sollte so aussehen, als entspringe er deiner Schulter. Deinen tatsächlichen Arm (links oder rechts, so wie der Ersatzarm) legst du daneben und deckst ihn mit einem Tuch ab. Du kannst auch einen Schirm davorstellen. Wichtig ist, dass du ihn nicht siehst! Eine zweite Person streicht nun einige Zeit gleichzeitig mit zwei Pinseln oder weichen Bürsten über die gleiche Stelle deines Arms und des Ersatzarms. Nach einer Zeit nur noch über den Ersatzarm. Was beobachtest du? Was passiert, wenn der Ersatzarm gezwickt wird?
Oft werden Experimente mit Tieren durchgeführt, um neue Dinge herauszufinden. Verfasse einen kurzen Text über die Vor- und Nachteile von Tierversuchen! Füge eine Überschrift ein!



So schätze ich mich nach dem Großkapitel DER MENSCH – WAHRNEHMEN UND BEWEGEN selbst ein: Kreuze jenen Daumen an, der für dich am ehesten zutreffend ist!
die fünf Abschnitte des Gehirns und ihre Aufgaben beschreiben.
… erklären, wie die Reizleitung in Nerven erfolgt.
… den Zusammenhang zwischen den Sinnesorganen und dem Gehirn analysieren.
den Aufbau des Auges wiedergeben.
die Entstehung des Bildes im Auge veranschaulichen.
… Zapfen und Stäbchen sowie deren Funktion unterscheiden.
… die Ursachen von Augenerkrankungen analysieren.
… den Weg des Schalls im Ohr nachvollziehen.
… beschreiben, wie der Schall in Nervenimpulse umgewandelt wird. erklären, wie der Gleichgewichtssinn funktioniert.
die Wirkungsweise des Geruchssinns beschreiben. wiedergeben, wie der Geschmackssinn funktioniert.
die Schichten der Haut sowie deren Aufgaben beschreiben.
nachvollziehen, wie im Gehirn ein Bild unserer Umgebung entsteht.
…das Reiz-Reaktions-Schema nachvollziehen.
… Sinn und Funktion von Reflexen erklären und sie in Versuchen zeigen.
…die verschiedenen Arten der Informationsweitergabe in unserem Körper vergleichen.
die Bedeutung von Bewegung für unseren Köper begründen.
Um deine Kompetenzen noch mehr zu steigern, hier unsere Buchtipps für dich:



Barbara Fischer, Michael Preschitz: Faszination Auge: Alles über unser komplexes Sinnesorgan einfach erklärt (Athesia-Tappeiner Verlag, 2021).
Alexander Rösler, Philipp Sterzer: 29 Fenster zum Gehirn. Genial einfach erklärt, was in unserem Kopf passiert (Arena Verlag, 2018).




Abgase: 116
abiotische Faktoren: 90
Abwasser: 142, 151
Acker-Schachtelhalm: 66
Aderhaut: 164
Adlerfarn: 66
Akne: 178
Algen: 86
Allergie: 150
Allesfresser: 42, 91
Alterssichtigkeit: 168
Alzheimer-Krankheit: 186
Ameise: 28, 42, 120
Ameisenstaat: 28
Amsel: 12
Antibiotika: 86, 143, 151, Arbeiterin: 27
Atmung: 11, 25, 33, 44, 54, 91, 161
Auge: 164, 165, 166, 167, 168
Augenmuskel: 164
Außenskelett: 8, 14, 24, 37
Auwald: 92, 98
Bakterien: 137, 138, 139, 142, 143, 146, 148, 149, 151, 156, 158, 168, 171, 177, 178
Bannwald: 115
Bast: 53, 101, 109
Baumpflege: 111
Baumschicht: 96
Bewirtschaftung: 91, 111, 126
Biene: 24, 25, 27, 28, 30, 42
Bienenstaat: 27
Bienenstock: 25, 27
Bienentrachtpflanze: 110
Bindehautentzündung: 168
Bioindikator: 37
biotische Faktoren: 90
Biotop: 90
Biozönose: 90
Blätterpilz: 80, 81
Blütenstaub: 55
Boden: 11, 12, 19, 28, 34, 38, 50, 51, 63, 64, 66, 69, 70, 77, 78, 85, 90, 92, 95, 96, 97, 111
Bodenschicht: 11, 38, 39, 95, 96
Borreliose: 38
Borke: 34, 53, 92
Champignon: 77, 80, 81, 82
Chitin: 24, 25, 32, 33, 34, 37, 44, 77, 82
Chitinpanzer: 34
Chlorophyll: 54, 77, 97
Chloroplasten: 132
Covid-19-Pandemie: 145, 150
Dauerstaat: 27, 28
Depression: 139, 186
Destruent: 85, 91, 105, 151
Diabetes: 151, 187
Doppelgänger: 81
Drohne: 27
Duftmarken: 101
Eierschwammerl: 81
Eingeweidesack: 19
Einzeller: 137, 142, 146
Elsbeere: 111
Entzündung: 140, 143, 145, 168, 171, 178
Erbinformation: 78, 132, 133, 137, 138, 142
Erdrutsch: 115
Erholungsraum: 117
Erosion: 115, 119, 120
Falter: 32
Farbenblindheit: 166
Farbstoffträger: 132
Farn: 52, 63, 65, 66, 96
Fassettenauge: 24, 25, 32
Fäulnisbewohner: 85
Feintrieb: 135
Fichtenwald: 92
Fieberblase: 178
Flechten: 86, 120, 139
Fliegenpilz: 80
Flosse: 41
Flügel: 24, 28, 32, 41
Föhre: 92, 109
Forst: 92
Fressfeind: 18, 61, 90, 101, 105, 108, 109, 112
FSME: 38, 140
Geschmackspapillen: 175
Gewebe: 50, 60, 82, 131
Geweih: 101, 102, 109
Gewöhnliche Moosbeere: 71
Giftklauen: 37, 38
Giftstachel: 24, 39
Glaskörper: 164, 165
Gliederfüßer: 8, 37, 39, 42
Grauer Star: 168
Grünalge: 50
Grüner Knollenblätterpilz: 80, 81
Grüner Star: 168
Grundwasser: 70, 112, 116, 122
Haarmützenmoos: 63, 64
Habichtspilz: 80
Hallimasch: 85
Hartholz–Au: 98
Herbarium: 49
Herrenpilz: 80, 81
Hirschkäfer: 34
Hirschzungenfarn: 66
Hochmoore: 70, 71, 124
Honigbiene: 27
Hormone: 183, 186
Hornhaut: 164, 165
Humus: 12, 38, 63, 69, 85, 91
Imkerin/Imker: 27
Immunsystem: 139, 144, 145, 150, 186
Innenohr: 170, 171
Käfer: 34, 42, 71, 121, 122
Kellerassel: 39
Kernhülle: 132, 133
Kernholz: 53
Kiefernspanner: 33
Kiemen: 19, 39, 44
Kitz: 102
Kläranlage: 151
Kokon: 12
Kondensor: 135
Königin: 25, 27, 28
Lamellen: 77, 78, 80, 81
Landwirtschaft: 33, 72, 75, 112, 127
Lärche: 97, 109, 119
Laubmischwald: 95, 98
Lawine: 115
Lederhaut: 164, 177, 178
Leuchtqualle: 9
Libelle: 71
Ligusterschwärmer: 33
Linse: 25, 135, 164, 165, 168
Made: 25, 28
Maikäfer: 8, 34, 43
Mantel: 14, 19
Markstrahlen: 53
Maronenröhrling: 80
Miesmuscheln: 8
Mikrobiom: 139, 140, 143
Mikroskop: 131, 135, 136, 137, 157
Milbe: 37, 38
Mistkäfer: 34
Monokultur: 95, 108, 125
Moorfrosch: 71
Moose: 50, 63, 64, 69, 96, 120
Moosschicht: 96
Mudde: 70
Mure: 115
Funktionsmodell: 163
Gehäuse: 18, 19, 41
gehölzfreie Au: 98
Borkenkäfer: 34, 53, 92, 111
Borreliose: 38, 140
Botanik: 75
Braunkehlchen: 71
Brunftzeit: 102
Geiß: 101
Geißel: 137, 142
gemeiner Totengräber: 34
Generationswechsel: 64
geografische Höhe: 92
Gerstenkorn: 168
Geschmacksknospen: 175
Konsument: 60, 91, 97, 105
Kopfbruststück: 37, 38
Korallenbleiche: 9
Korallenriff: 9
Krautschicht: 65, 96
Kreuzspinne: 37, 38
Kulturflüchter: 102
Kurzsichtigkeit: 168
Myzel: 77, 78, 85, 86
Nachhaltigkeit: 115
Nacktschnecke: 18
Nadelmischwald: 95
Nadelwald: 28, 63, 119
Nahrungskette: 12, 60, 105, 121
Nahrungsnetz: 37, 81, 105, 124,
Nase: 139, 140
Nationalpark: 98
Naturverjüngung: 111
Neobiota: 110
Neophyten: 110, 111
Neozoen: 110, 111
Nesseltiere: 8, 9, 41
Netzhaut: 164, 165, 166, 168
Niedermoore: 70, 71, 124
Niederschlag: 70, 116, 121, 122
Nutria: 110
Oberhaut: 146, 177
Objektiv: 135
Objekttisch: 135, 136
Objektträger: 135, 136
Ohr: 170, 171
ökologische Nische: 90
Ökosystem: 19, 37, 69, 90, 91, 101, 105, 108, 111, 112, 114, 125, 138, 151
Oktopus: 8
Okular: 135
Optische Täuschungen: 167
Organellen: 131
Organismus: 85, 124, 131, 132
Osteoporose: 187
Pantoffeltierchen: 137
Parasit: 9, 38, 85, 139, 145, 150
Parasol: 77, 80
Pestizid: 111
Pflanzenwachstum: 58
Pinzette: 7, 136
Pionierpflanze: 63
Präparieren: 136
Produzent: 60, 91, 97, 105
Punktaugen: 24, 37, 38
Pupille: 164, 165
Puppe: 25, 28, 32, 33, 42
Raspelzunge: 19
Räuber: 28, 61
Raupe: 32, 33
Regenbogenhaut: 164, 165
Regenwald: 108, 125, 127
Regenwurm: 9, 11, 12
Reh: 61, 98, 101, 102, 109
Reiz-Reaktions-Schema: 181, 182, 183
Ringelwürmer: 8, 9, 11, 44
Rohstoffe: 125, 127
Rohstofflieferant: 117
Rotes Ordensband: 33
Rothirsch: 102
Rothwald: 91
Rundblättriger Sonnentau: 71
Rüssel: 32
Sahara: 122
Savanne: 121, 123, 126, 127
Schädling: 53, 95, 108, 110, 111
Schädlingsbekämpfung: 88
Schleimdrüse: 18
Schmalblättriges Wollgras: 71
Schmarotzer: 85
Schmetterlinge: 32, 33, 71
Schmetterlingsporling: 80
Schneckengang: 170, 171
Schneckenhaus: 18
Schuppen: 32, 66, 97, 145
Schwämme: 8, 9, 85
Seegurke: 8
Seeigel: 8
Sehnerv: 25, 164, 166, 168
Seestern: 8, 43
Silber-Weide: 98
Skelett: 8, 24, 41
Skorpion: 39
Sonnenbrand: 178
Speierling: 111
Spindelmuskel: 18
Spinndrüse: 38
Spinnentier: 8, 37, 38, 39, 42,
Spinner:33
Splintholz: 53
Sporen: 39, 50, 63, 64, 65, 77, 78, 80, 86, 142, 146
Sporenbehälter: 65
Sporenträger: 77
Stechmücke: 42, 146
Steppe: 121, 123, 127
Stiel-Eiche: 97
Stigmen: 25
Stockwerk des Waldes: 96
Stoffkreislauf: 28, 34, 54, 85, 91, 121, 137
Stoffwechsel: 86, 132, 137, 138, 139, 143, 144, 161
Strauchschicht: 96, 101
Strukturmodell: 163
Symbiont: 85
Symbiose: 9, 28, 85, 86, 90, 139
Tagfalter: 32, 33
Tagpfauenauge: 32
Torfmoos: 69, 70, 71
Torfmoosteppich: 71
Torfschicht: 69, 70
Tourismus: 127
Tracheen: 25, 33, 44
Tracheensystem: 25, 33, 44
Tränenkanal: 164
Trockenstarre: 18, 86
Tubus: 135
Überschwemmung: 69, 70, 98, 115, 116
Umweltschutz: 75, 125
Unterhaut: 146, 177, 178
Unterholz: 101, 117
Vakuole: 132
Verdauungssaft: 37
Vermehrung: 12, 43, 52, 55, 63, 77, 78, 138, 142, 152
Viehzucht: 28, 126
Vorkeim: 64, 65
Wabe: 25, 27
Wachstum: 12, 50, 53, 55, 58, 75, 101, 111, 125, 143, 152
Waldameise: 28
Waldiltis: 102
Waldlichtung: 101, 110
Waldtypen: 92
Waldzecke: 38
Wasserspeicher: 63, 98
Wassertropfen: 64, 116
Wasserversorgung: 69
Weberknecht: 37, 38, 39
Webspinne: 37
Weichholz–Au: 98
Weichtier: 8, 18, 19
Weiß-Tanne: 97
Weitsichtigkeit: 168
Wespe: 27
Wildtiere: 109, 145
Wildverbiss: 109
Wimpern: 164
Zapfen: 97, 166,
Zellkern: 78, 132, 133, 137, 142, 160
Zellmembran: 132, 133, 137
Zellplasma: 132, 142
Zellteilung: 64, 133, 137, 142
Zellwand: 132, 142
Zitronenfalter: 33
Zwitter: 12, 18
Windung: 18
Wurmfarn: 66
Wüsten: 122, 124, 126, 127
Adobe Stock: 40/1, 137/6
Aimée Blaskovic: 59/1, 59/2
Arena Verlag 2018: 191/3
AT-Verlag 2022: 76/3
Athesia-Tappeiner Verlag 2021: 191/2
Birgit Kozak, Hellbunt-Design: 50/1-4, 62/1, 70/1, 70/2, 74/2, Bundesministerium für Land- und Forstwirtschaft, Regionen und Wasserwirtschaft: 118/2, 118/3, 118/4
Carlsen 2020: 159/4
Christian Monyk: 4/3, 35/9, 38/3, 41/4, 41/5, 43/2, 50/5, 52/4, 53/1, 54/1, 54/2, 54/3, 56/3, 57/1, 58/2, 58/4, 60/1, 64/1, 65/4, 67/1, 67/2, 77/2, 78/1, 78/2, 84/9, 84/10, 90/1, 91/1, 91/2, 92/1, 93/1, 98/3, 99/3, 103/5, 103/6, 103/7, 105/1, 105/2, 106/1, 116/2, 118/1, 132/2, 133/1, 136/2, 136/3, 136/4, 136/5, 138/12, 140/3, 142/2, 142/3, 143/1, 144/2, 160/3, 162/2, 163/1, 165/1, 165/3, 165/5, 166/1, 169/3, 169/4, 170/3, 171/1, 171/2
Dorling Kindersley/Rob Shone: 13/1
Eidgenössische Forschungsanstalt für Wald, Schnee und Landschaft / Peter Longatti: 109/1
fotolia.com: Alexander Kaludov: 167/2, Alila: 164/2, Heiko Barth: 168/4, Peter Hermes Furian: 168/1, 168/2 Frank-Kosmos-Verlags-GmbH 2022: 89/3 Freies Geistesleben 2011: 76/2 Gruner + Jahr 2022: 130/3
Gütersloher Verlagshaus 2017: 89/2
Internet: 4/1, 15/2, 69/3, 69/4, 97/7, 97/9, 97/11, 97/13, 97/15, 97/16, 138/9, 138/10, 137/3, 143/2, 145/3, 146/2, 146/3, 146/4, 167/4, 180/1, 180/2
Istockphotos.com: 2199_de: 92/4, 13-Smile: 49/6, 40/7, abadonian: 31/2, Adam88xx: 107/5, AGAMI stock: 122/4, agustavop: 42/2, 95/1, ajansen: 85/5, Akabei: 126/2, alanphillips: 86/2,AlasdairJames: 14/13, 34/3, 152/3, AlbyDeTweede: 120/1, Aldona: 25/4, AleksandarDickov: 20/1, AlexPro9500: 152/4, AlexRaths: 154/2, Alina555: 157/3, AlonzoDesign: 104/3, alptraum: 155/4, Anastasiia Shavshyna: 124/2, Andreas Goettlinger: 110/2, Andreas Häuslbetz: 18/2, AndreasReh: 137/1, aNdreas Schindl: 112/1, Andrei310: 42/10, andresr: 149/3, 188/2, 155/6,Andrey Danilovich: 80/9, 119/1, Andrey Elkin: 155/3, ands456: 32/2, Andyworks: 14/1, 14/11, Anest: 22/5, 23/2, angelima: 155/ 7, 169/2, Animaflora: 50/2, :Ankorlight: 52/6, Antagain: 30/2, AnthiaCumming: 107/1, 107/2, 107/9, 107/10, 107/11, 107/12, Anton Lutsenko: 155/5, Antrey: 30/3, arlindo71: 3/1, 29/2, 30/1, 40/1, ArminStautBerlin: 17/1, Artem Peretiatko: 127/4, 157/2, 162/1, artproem: 152/1, AscentXmedia: 108/3, Astrid860: 120/7, Avalon_Studio: 107/7, AVTG: 107/8, Azat_ajphotos: 49/1, Backiris: 40/3, bad81: 42/8, Bim: 151/4, Binnerstam: 33/3, bluestocking: 154/4, borchee: 30/6, boryak: 27/1, brunorbs: 138/11, Cabezonication: 31/1, cat_arch_angel: 10/3, cdbrphotography: 120/6, Cecile Gambin: 42/3, cgdeaw: 51/5, cglade: 114/1, ChristiLaLiberte: 82/3, Christopher Moswitzer: 119/4, clu: 92/3, ClubhouseArts: 109/3, Coprid: 155/2, CreativeNature_nl: 35/7, cynoclub: 106/2, DaLiu: 115/1, Damocean: 9/3, Dave Collins: 72/3, davidnay: 5/2, 14/14, 15/1, 16/1, 17/2, delray77: 126/3, designer29: 7/2, 75/3, DieterMeyrl: 104/1, dima_sidelnikov: 94/3, 94/5, dmitriymoroz: 23/1, Dr_Microbe: 77/3, 77/4, 139/1, DrPAS: 10/2, Drypsiak: 49/4, DS70: 127/2, DuchesseArt: 42/4, ekolara: 104/2, emer1940: 107/6, evgenyatamanenko: 94/1, EzumeImages: 50/1, FatCamera: 186/1, 187/1, fcafotodigita: 154/5, :Fertnig: 187/2, filmfoto: 97/8, 97/12, FitchyImages: 72/2, Flavio Treppner: 109/5,florintt: 82/1, Floortje: 82/4, FotoGablitz: 73/5, franckreporter: 116/1, Frank Buchter: 39/1, FRANKHILDEBRAND: 109/2, FrankRamspott: 14/10, 39/2, FrankvandenBergh: 120/5, Frank Wagner: 123/9,Freder: 121/6, fstop123: 157/4, GabrielaNavarro: 125/2, georgeclerk: 112/2, Gilnature: 143/3, GlobalP: 20/3, 32/5, 35/5, 40/5, 73/2, Global_Pics: 9/4, 10/5, Grace Maina: 6/1, 18/7, 21/2, 22/1, 22/3, 36/2, 58/1, 58/3, 63/4, 65/3, 132/3, 156/2, 167/3, 183/3, Hafid Firman Syarif: 31/3, Floortje: 138/2, halbergman: 108/4, hdagli: 154/1, Helen Davies: 86/4, helovi: 12072, HHelene: 40/3, 71/2, 71/7, 73/6, Hennadii: 104/4,
104/5, 104/7, Henrik_L: 92/2, hopsalka: 151/3, hsvrs: 50/4, Ian_Redding: 33/7, IBorisoff: 9/1, IconicBestiary: 184/3, ifish: 8/6, IGraDesign: 55/7, Ilja Enger-Tsizikov: 8/5, Imgorthand: 117/1, 117/2, Inside Creative House: 163/1, Iryna Kharkova: 49/3ltos: 10/1, Iurii Garmash: 42/1, Ivan Mattioli: 42/7, jacobeukman: 121/4, JamesAchard: 73/1, JamesBrey: 40/4, Janny2: 34/2, 35/4, Jasonfang: 123/2, 123/8, 128/2, jimd_stock: 30/4, JimmyLung: 124/1, JJ van Ginkel: 97/2, JMrocek: 101/1, johny007pan: 127/3, juergen2008: 97/3, jxfzsy: 7/1, 47/1, 75/1, 88/1, 129/1, 158/1, 190/1, K1tyara: 16/2, kaanates: 55/6, kajakiki: 153/5, KenCanning: 121/2, 121/7, KeremYucel: 15372, kerkla: 26/2, Kharlamova: 190/3, Kichigin: 78/3, kickers: 40/2, kingfisher101: 73/4, koosen: 155/1, Kuzenkova_Yuliya: 9/5, kwanchaichaiudom: 156/1, kwasny221: 61/1, Ladislav Kubeš: 140/2, Lena_Zajchikova: 52/2, Leonsbox: 112/3, Lepro: 10/4, 21/1, Liderina: 113/2, Liliboas: 41/3, Linas Toleikis: 42/5, Lisitsa: 23/3, 31/4,Liudmila Chernetska: 10/6, Ljupco: 152/2, LockieCurrie: 53/2, L_POP: 149/1, Lordn: 186/2, luoman: 108/1, Luc Pouliot: 42/6, LUNAMARINA: 41/1, Ma_co: 21/3, maerzkind: 20/4, Maica: 73/7, 156/4, 157/1, malerapaso: 50/8, Mangata: 49/5, Mantonature: 64/2, 71/1, Martin Keiler: 107/4, Matthew H Irvin: 111/1, Mathias Möller: 128/5, Maxian: 95/3, MediaProduction: 10/7, Medical Art Inc.: 164/1, memoangeles: 47/2, mgfoto: 51/6, micro_photo: 137/5, middelveld: 72/1, MikeLane45: 71/5, mikulas1: 125/3, mkurtbas: 8/4, moramalin: 128/6, mrPliskin: 35/2, Mypurgatoryyears: 188/4, myrrha: 18/4, Nadezhda Kurbatova; 184/4, narvikk: 121/5, Nataba: 41/1, 41/2, Natalia Spiridonova: 52/5, Naya Nurindra: 127/1, nito100: 36/3, nndanko: 97/10, 144/1, NNehring: 4/2, 137/2, 138/1, Noctiluxx: 122/2, 123/4, 128/3, Olga Buntovskih: 119/2, ollikainen: 119/3, ONYXprj: 7/4, Ooriya Ron: 119/5, orinoco-art: 154/6, oxinoxi: 110/4, ozgurdonmaz: 150/1, ozgurkeser: 153/4, Paralaxis: 108/2, paulafrench: 121/8, Pavliha: 122/3, Pavol Klimek: 126/1, peakSTOCK: 97/6, 172/2, PeopleImages: 151/2, 167/1, photohomepage: 153/1, phototrip: 14/9, pictafolio: 40/4, PicturePartners: 50/6, 107/3, pidjoe: 136/6, PitiyaO: 146/1, portishead1: 184/2, pressdigital: 151/1, prill: 18/5, prophoto: 152/5, Prostock-Studio: 169/1, quickshooting: 123/6, Rachel Poirot: 126/4, Rainer von Brandis: 9/2, rarrarorro: 145/1, Red fox studio: 188/3, redmal: 55/4, 55/5, Richard Villalonundefined undefined: 154/3, rightdx: 14/7, Rosifan19: 48/1, 76/1, 89/1, 13071, 159/1, 191/1, Rudolf Ernst: 123/3, Rudzhan Nagiev: 139/3, rusm: 42/9, satori13: 35/8, Savany: 14/5, schnuddel: 14/3, scisettialfio: 50/3, 97/14, sduben: 110/3, seamartini: 22/2, 47/3, 104/6, 158/2, 158/3, 158/4, 158/5, 158/6, selvanegra: 150/2, setory: 94/2, Sinhyu: 86/1, Sharath V Jois: 14/12, Shelly Still: 40/2, Sinhyu: 86/1, shironosov: 162/3, Sjo: 154/7, SL_Photography: 122/1, slowmotiongli: 61/2, st_lux: 136/7, Studio-Annika: 43/1, subjug: 86/3, Svitlana Ozirna: 108/5, SylviePM: 8/2, Tammy616: 8/3, Tanya Zielke: 36/1, tassel78: 75/5, TatianaMagoyan: 86/2, taviphoto: 128/8, Terryfic3D: 121/1, theasis: 73/3, Tim Hall: 188/1, t_kimura: 7/2, 22/4, 35/1, 75/2, Tom Meaker: 120/4, Tomasz Klejdysz: 36/4, 39/3, 111/3, Thomas Marx: 46/1, treetstreet: 14/4, 14/6, ttsz: 137/3, tytyeu: 14/2, Ugur Karakoc: 184/1, Ulrike Leone: 54/4, UroshPetrovic: 5/1, uzhursky: 140/1, Valdas Jarutis: 14/8, VanReeel: 94/6, varbenov: 86/5, vav63: 136/8,vavlt: 3/2, 51/1, 57/2, 57/3, 57/4, 57/5, vendys: 122/5, Vicky_Chauhan: 145/2, Viktor_Kitaykin: 8/1, Vitalii Dumma: 142/1, Vitalina: 49/2, VitalisG: 128/7, VladimirDavydov: 28/2, vovashevchuk: 123/5, 128/4, wakila: 82/2, Whirler: 138/3, Wirestock: 42/11, 139/2, 156/3, witsawat sananrum: 121/3, 90/2, wowomnom: 182/2, xalanx: 111/2, xamtiw: 50/7, xmee: 149/2, yasuhiroamano: 153/3, YinYang: 102/2, Zabavna: 7/3, 47/4, 75/4, 88/2, 129/2, 158/7, 190/2, zanskar: 120/3, Zhanna Kavaliova: 125/1, zuperia: 88/3
Loewe 2021: 159/2
Nitzsche R. 2013: 48/3
Olivia Verlag 2021: 130/2
Planet Wissen: 69/1
Pixelio: Thorben Wengert: 103/1
Peter Newrkla: 11/2, 11/3, 18/1, 19/1, 19/2, 19/3, 24/1, 24/3, 26/1, 33/1, 38/1, 52/1, 52/3, 55/1, 55/2, 55/3, 56/1, 83/1, 95/2, 98/2 photos.com: 3/3, 11/1, 11/4, 18/6, 24/2, 25/1, 25/2, 25/3, 25/5, 27/2, 27/3, 27/4, 27/5, 28/1, 29/1, 30/5, 32/1, 32/3, 32/4, 33/2, 33/5, 34/1, 34/4, 34/5, 35/3, 35/6, 37/1, 37/2, 37/3, 38/2, 56/2, 63/1, 63/2, 63/3, 63/5, 65/1, 65/2, 66/1, 66/2, 66/3, 66/4, 66/5, 66/6, 68/2, 68/3, 71/4, 77/1, 79/1, 80/1, 80/2, 80/3, 80/4, 80/5, 80/6, 80/7, 80/8, 80/10, 81/1, 81/2, 81/3, 81/4, 81/5, 81/6, 83/2, 84/1, 84/2, 84/3, 84/4, 84/5, 84/6, 84/7, 84/8, 85/1, 85/3, 85/4, 94/4, 95/4, 95/5, 96/1, 98/1, 99/1, 99/2, 100/1, 100/2, 102/1, 102/3, 103/2, 103/3, 103/4, 103/6, 103/8, 113/1, 115/2, 115/3, 115/4, 115/5, 116/3, 117/3, 123/1, 128/1, 131/1, 131/2, 131/3, 131/4, 131/5, 131/6, 131/7, 132/1, 134/1, 135/1, 147/1, 147/2, 148/1, 148/2, 160/1, 160/2, 161/1, 164/3, 165/2, 165/4, 166/2, 166/3, 166/4, 166/5, 170/1, 170/2, 172/1, 173/1, 175/1, 175/2, 176, 177/1, 178/1, 178/2, 178/3, 178/4, 180/3 Franz Schlögl: 11/5, Kurhan: 168/4, Natalia Lukiyanova: 13/2
Quelle und Meyer 2020: 76/4
Raoul Krischanitz: 25/6, 29/3, 59/1, 85/2, 136/1, 161/2, 181/1, 181/2, 182/1, 183/1, 183/2, 185/1, 189/1
Ravensburger Verlag 2015: 48/2
Tessloff Verlag 2006: 89/4
Tessloff Verlag 2021: 159/3
thinkstockphotos.com: gabriel12: 69/2
Verlag Eugen Ulmer 2020: 130/4
wikimedia commons: 28/3, 30/7, 51/2, 51/3, 51/4, 68/1, 97/4, 97/5, 109/4, 120/8, 120/9, BotBin: 111/4, Christian Fischer: 71/6, Clive A. Edwards: 12/2, Dr. Frederick A. Murphy: 145/4, Gernot Schreiber: 101/2, Greyson Orlando: 165/6, 165/7, H. Hofmeister: 131/9, Hopefully Acceptable Username: 97/1, M. Linnenbach: 71/3, Mrs skippy: 87/1, Olaf Leillinger: 33/4, Opuntia: 33/6, Robert Nordsieck (Rnordsieck): 19/4, Rosenzweig: 111/5, T137: 20/2, Wolfgang Pehlemann: 18/3
VERZEICHNIS DER VIDEOS:
Istockphotos.com: bo1982: S. 24, DamianKuzdak: S. 101, ntek1: S. 25, okvideo: S. 11, pomarinus: S. 19, rogkov: S. 34, Smileus: S.96,
